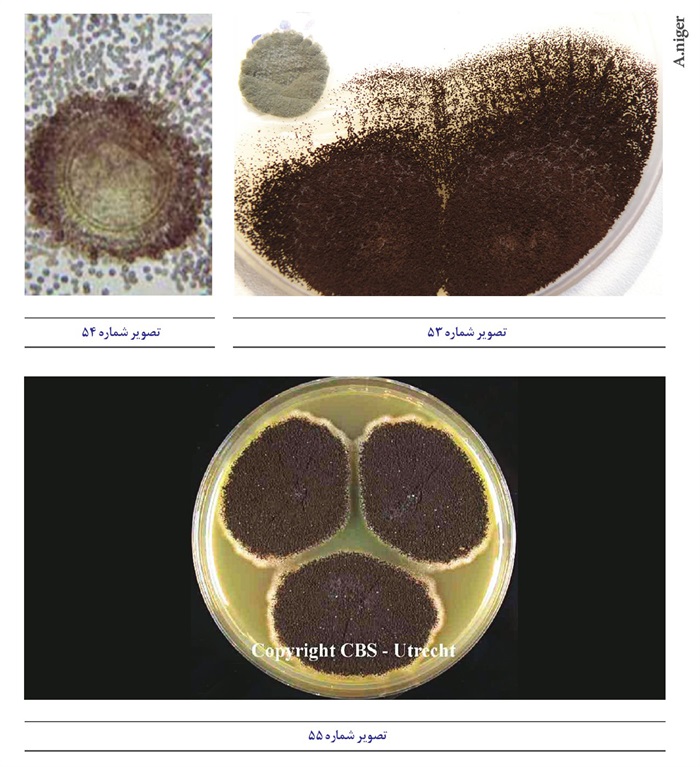
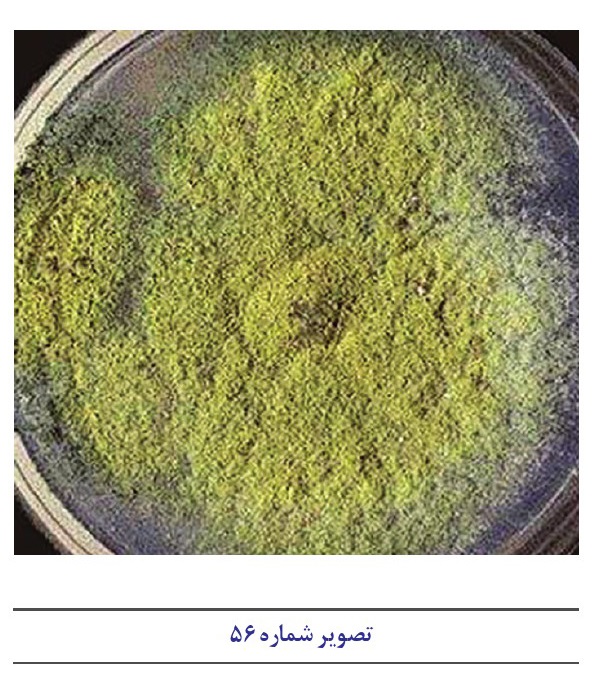
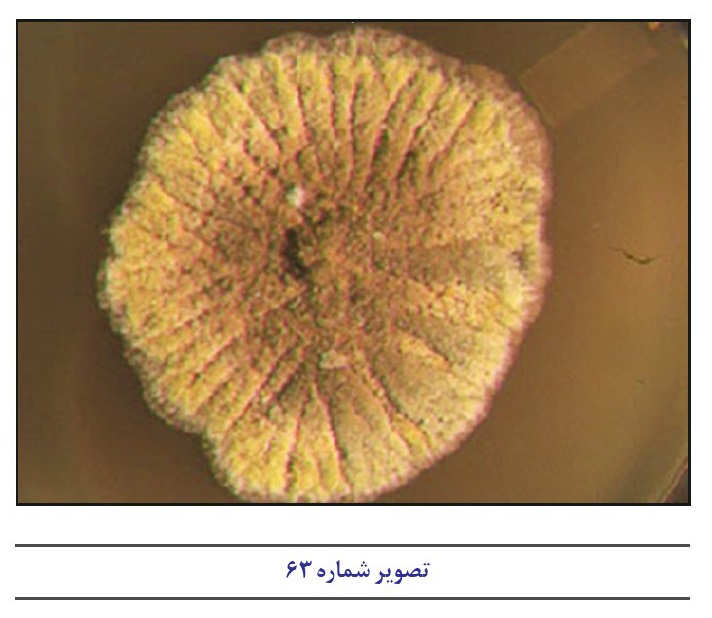
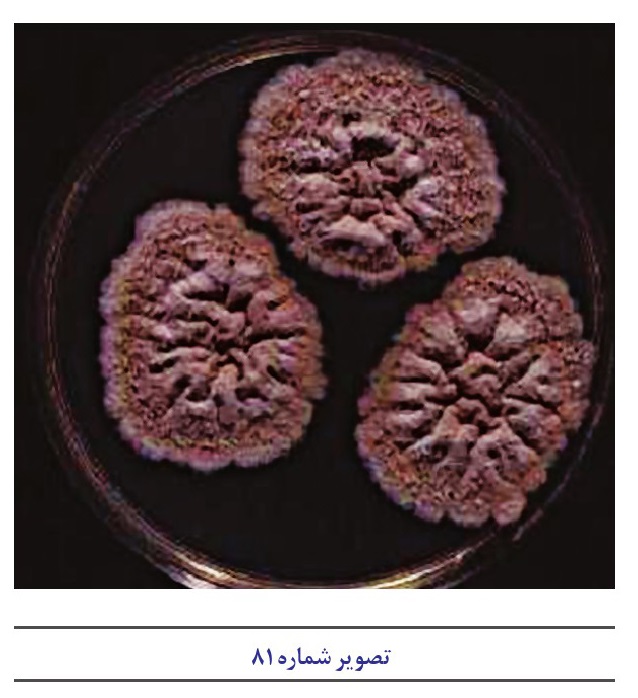
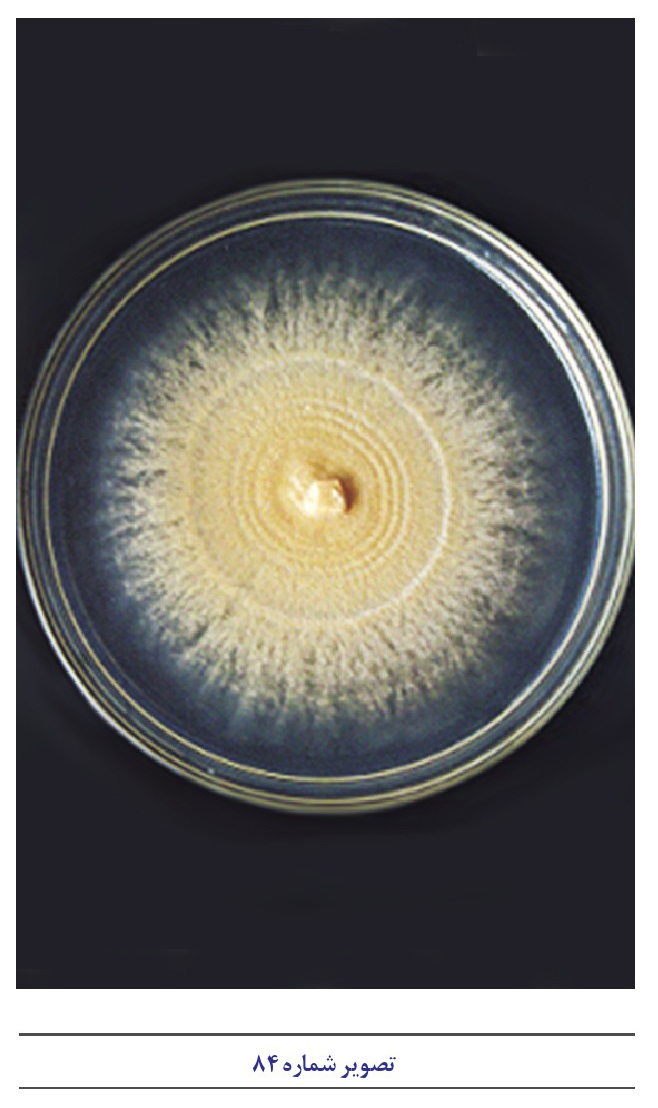
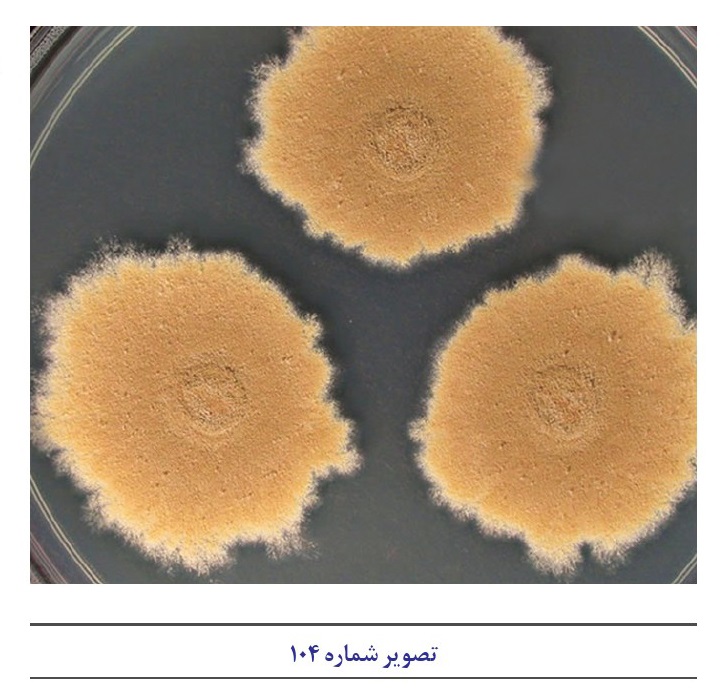
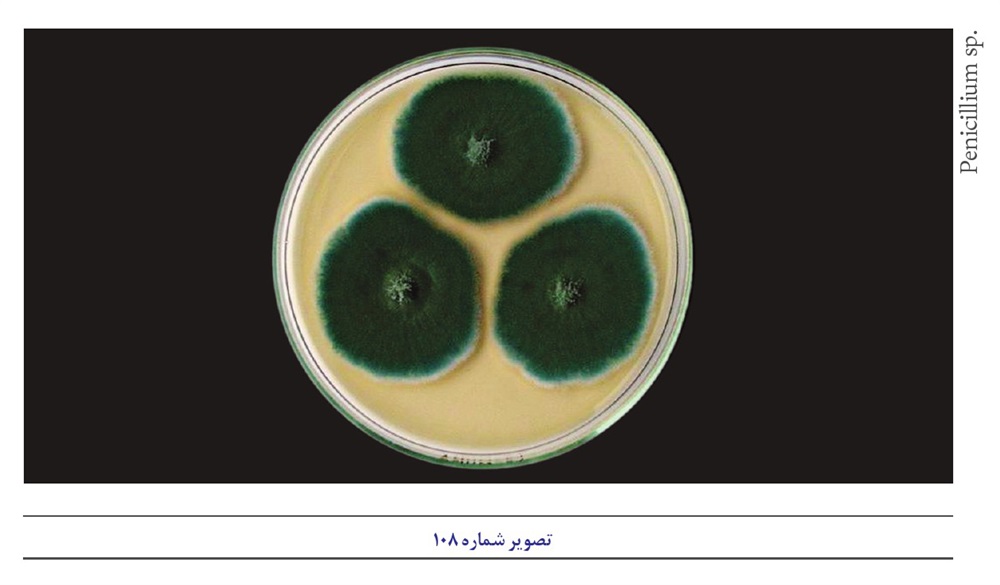
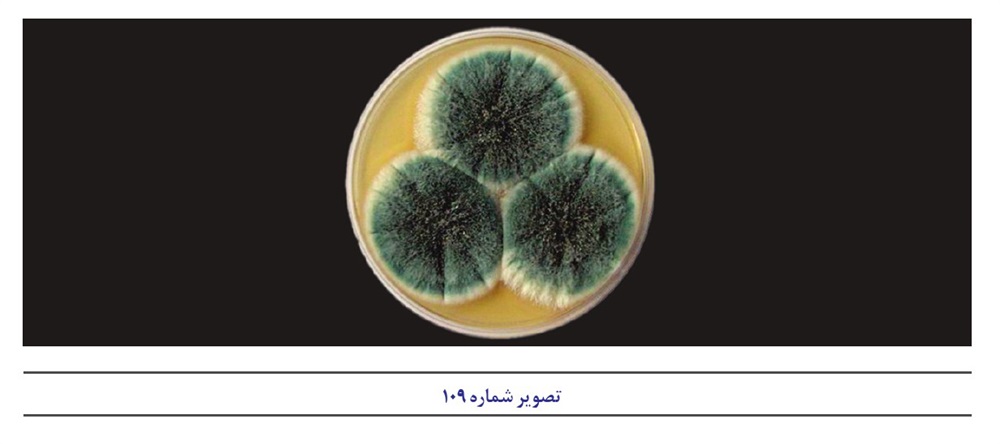
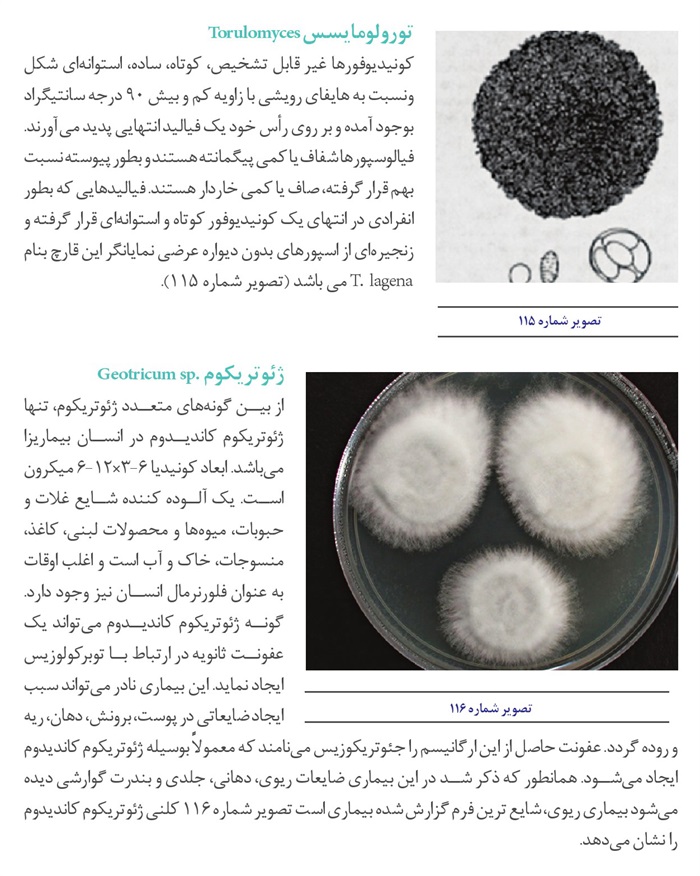
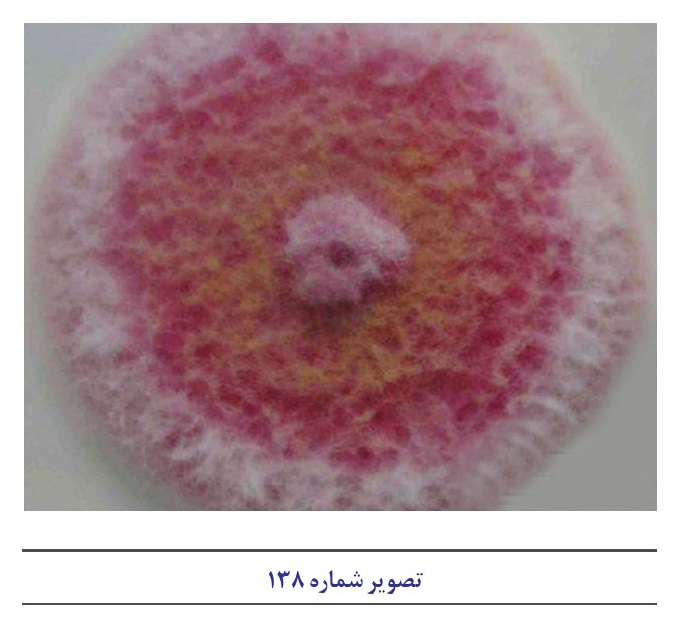
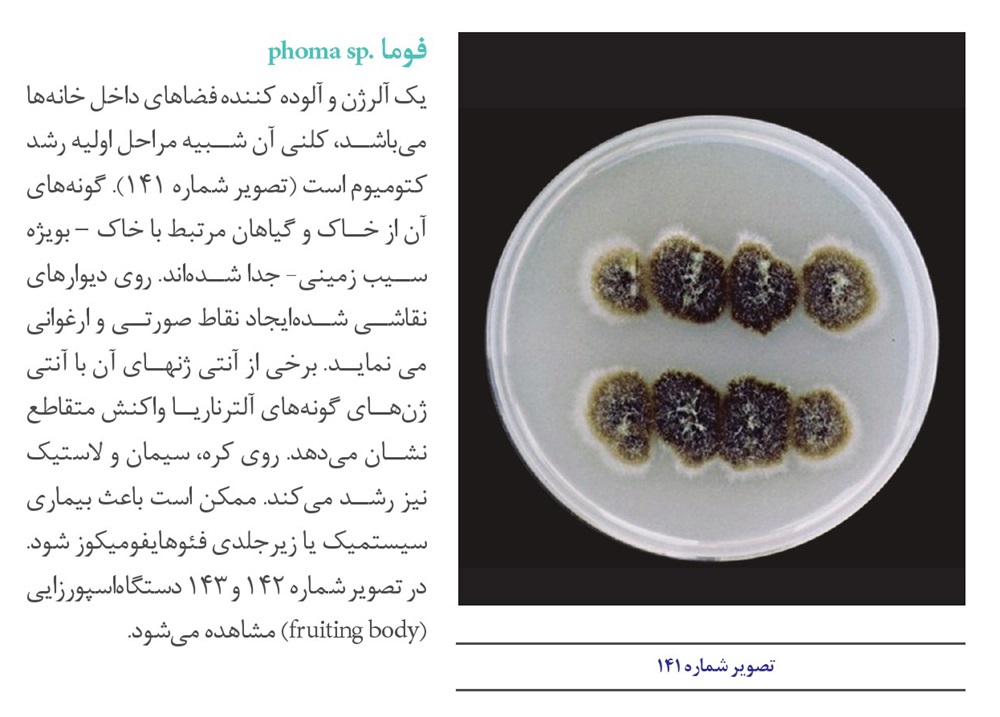
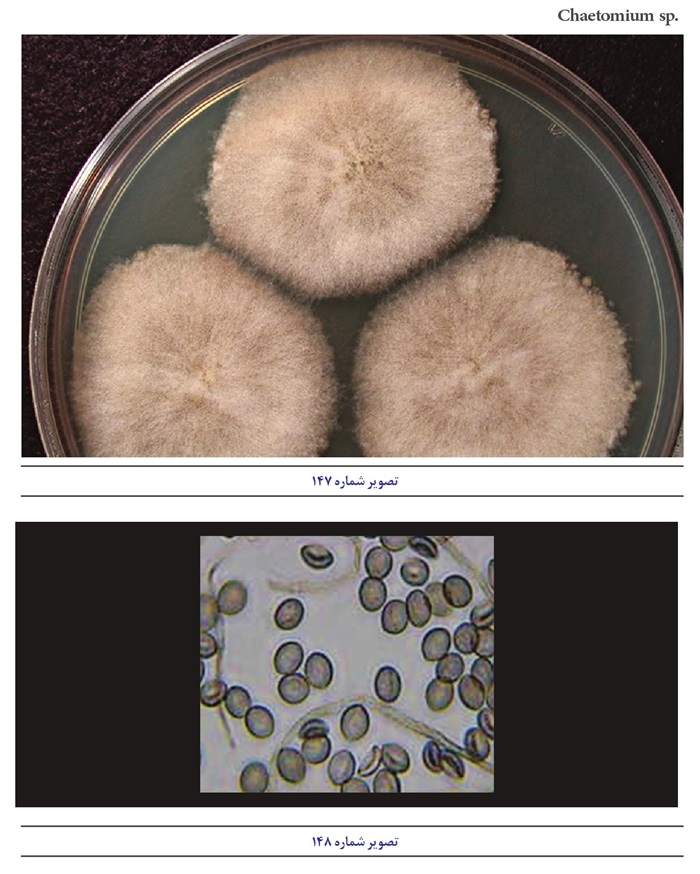
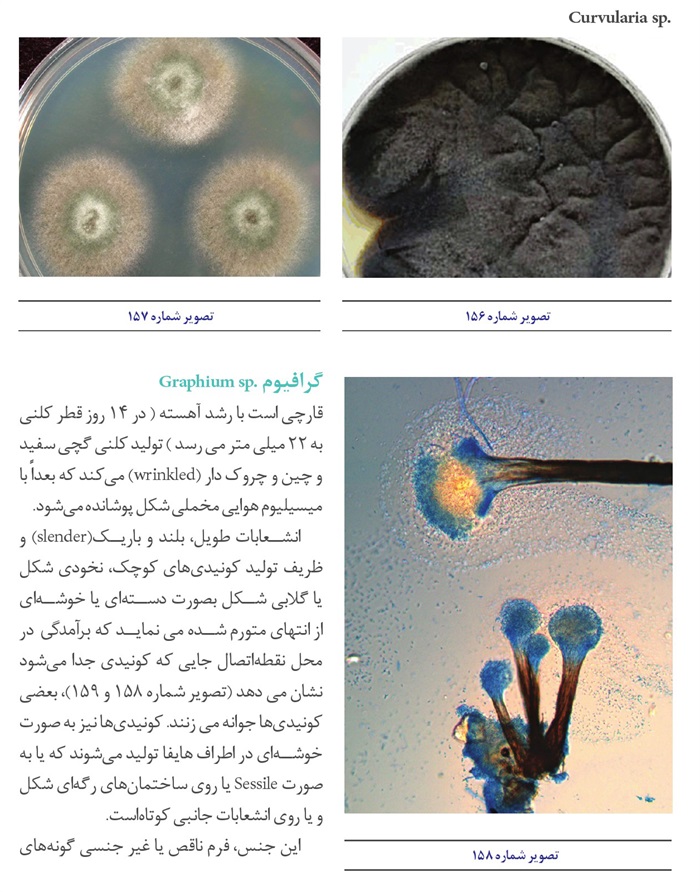

سرشناسه:قهری، محمد، 1338 -
عنوان و نام پديدآور:عوامل میکروبی آسیب رسان به مواد آرشیوی و کتابخانه ای [کتاب]/ به کوشش محمد قهری، با همکاری صدیقه روحی.
مشخصات نشر:تهران : سازمان اسناد و کتابخانه ملی جمهوری اسلامی ایران، 1391.
مشخصات ظاهری:225 ص.: مصور (رنگی).
فروست:آموزش های آرشیوی؛ 2.
شابک:150000 ریال:978-964-446-307-5
وضعیت فهرست نویسی:فاپا
يادداشت:پشت جلد به انگلیسی: Mohammad Ghahrim, Sedighe Rouhi dehboneh. Microbial damages on archive ...
یادداشت:کتابنامه.
یادداشت:نمایه.
موضوع:مواد کتابخانه ای -- نگهداری و مرمت
موضوع:Library materials -- Conservation and restoration
موضوع:مواد آرشیوی -- نگهداری و مرمت
موضوع:Archival materials -- Conservation and restoration
موضوع:کتاب -- نگهداری و مرمت
موضوع:Books -- Conservation and restoration
شناسه افزوده:روحی، صدیقه
شناسه افزوده:سازمان اسناد و کتابخانه ملی جمهوری اسلامی ایران
رده بندی کنگره:Z701/ق9ع9 1391
رده بندی دیویی:025/84
شماره کتابشناسی ملی:2614403
دسترسی و محل الکترونیکی:آدرس الکترونیکی منبع
خیراندیش دیجیتالی : انجمن مددکاری امام زمان (عج) اصفهان
ویراستار کتاب : خانم نرگس قمی
ص: 1
فهرستنویسی پیش از انتشار کتابخانه ملی جمهوری اسلامی ایران
سرشناسه:قهری، محمد، 1338 -
عنوان و نام پديدآور:عوامل میکروبی آسیب رسان به مواد آرشیوی و کتابخانه ای [کتاب]/ به کوشش محمد قهری، با همکاری صدیقه روحی.
مشخصات نشر:تهران : سازمان اسناد و کتابخانه ملی جمهوری اسلامی ایران، 1391.
مشخصات ظاهری:225 ص.: مصور (رنگی).
فروست:آموزش های آرشیوی؛ 2.
شابک:150000 ریال:978-964-446-307-5
وضعیت فهرست نویسی:فاپا
يادداشت:پشت جلد به انگلیسی: Mohammad Ghahrim, Sedighe Rouhi dehboneh. Microbial damages on archive ...
یادداشت:کتابنامه.
یادداشت:نمایه.
موضوع:مواد کتابخانه ای -- نگهداری و مرمت
موضوع:Library materials -- Conservation and restoration
موضوع:مواد آرشیوی -- نگهداری و مرمت
موضوع:Archival materials -- Conservation and restoration
موضوع:کتاب -- نگهداری و مرمت
موضوع:Books -- Conservation and restoration
شناسه افزوده:روحی، صدیقه
شناسه افزوده:سازمان اسناد و کتابخانه ملی جمهوری اسلامی ایران
رده بندی کنگره:Z701/ق9ع9 1391
رده بندی دیویی:025/84
شماره کتابشناسی ملی:2614403
ص: 1
7 سخن نخست
9 مقدمه
11 تعریف واژه ها و اصطلاحات
بخش اول جنبه های عمومی آسیب شناسی عوامل بیولوژیک
فصل اول: کلیات
16 عوامل بیولوژیک
17 فساد بیولوژیکی
19 طبقه بندی انواع آسیبهای بیولوژیکی
19 دگرگونی فیزیکی یا مکانیکی
19 فاسد شدن یا آلوده شدن دگرگونی مربوط به زیبایی شناختی
20 تجزیه بیولوژیکی ناشی از فعالیت مستقیم بیوشیمیایی
20 تجزیه بیولوژیکی ناشی از فعالیت غیر مستقیم بیوشیمیایی
21 طیف تجزیه کننده ها، دامنه مواد فاسد کننده
21 چرخه عناصر
21 تشخیص و برآورد هزینه مشکلات دگرگونی بیولوژیکی
22 هزینه جلوگیری
22 مواد طبیعی
23 مواد سلولزی
28 سموم قارچی (مایکوتوکسین
30 حشرات و مایت ها در محصولات ذخیره شده
30 راسته بید (شب پره ها
30 بید انبار
30 بید آسیاب یا بید آرد مدیترانه ای
30 بید غذای هندی بید) بلغور (هندی
31 راسته کولئوپترا
31 سوسک عنکبوتی شکل استرالیایی
32 سوسک بیسکویت
32 سوسک آرد
33 راسته آکارینا
33 مایت های غذا و دیگر مایتها
35 تخریب بیولوژیکی کاغذ
36چرا قارچ ها و دیگر میکروارگانیسم ها باعث فساد و تجزیه اشیای کاغذی می شوند؟
38 تجزیه سلولز بوسیله باکتری ها
39 تجزیه سلولز بوسیله قارچ ها
ص: 2
فصل دوم: ویژگی های قارچ ها
42 قارچ ها چگونه موجوداتی هستند؟
43 فعالیتهای بیولوژیکی قارچ ها
44 فاکتورهای مؤثر بر روی رشد کپکها
45 رطوبت نسبی
45 دما
46 جریان هوا
46 عوامل قارچی مخرب ،کاغذ آسیب شناسی و راههای پیشگیری و مقابله
47 شناسایی اثرات و آسیبهای قارچی در کاغذ
48 قارچهای کاغذ خوار
فصل سوم: مقابله با آسیبهای ناشی از قارچها
54 عوامل مساعد کننده رشد و تکثیر عوامل قارچی در کتابخانه
55 چگونگی جلوگیری از ایجاد آسیبهای بیولوژیک توسط میکروارگانیسم ها در کاغذ
55 راه های ورود قارچها به داخل ساختمان
56 اقدامات پیشگیرانه در ارتباط با محل احداث کتابخانه و آرشیو
57 رفع آلودگی قارچی از کتابها و اسناد آلوده
59 روشهای سنجش و آشکار سازی برای میکروارگانیسمهای مسبب فساد بیولوژیکی
60 سنجش و شمارش میزان آلودگی با میکروارگانیسم ها
61 کنترل فساد بیولوژیکی
63 روشهای مختلف ضدعفونی آثار آلوده و آسیب دیده
63 اکسید اتیلن
64 پارادی کلرو بنزن
65 اشعه گاما
65 پلی هگز امتیلن گوانیدین
66 اشعه فرابنفش
66 تيمول
67 ارتوفنيل فنل
67 سالیسیلا نیلید
67 مخلوط کلرید جیوه و تیمول
67 پنتا کلروفنل
68 ترکیبات چهار ظرفیتی آمونیم
68 ديكلروفن
68 فرمالین یا آلدئید فرمیک
68 انجماد در شرایط خلاء
72راه های مبارزه با اثر رطوبت, موجودات ذره بینی تخمیر و تغییر رنگ
ص: 3
فصل چهارم اشیاء غیر کاغذی تاریخی و فرهنگی
74 اشیاء و آثار غیر کاغذی و فرهنگی
74 یارشمن
74 اشیای موزه ای
74 آثار نقاشی
75 چرم و پوست
76 فلاپی دیسک ها و نوارهای ویدیوئی
فصل پنجم : جنبه های بهداشت و سلامت کارکنان بخشهای حفاظت و مرمت
78 آلودگی قارچی اشیای فرهنگی و مسئله سلامت کارکنان بخشهای حفاظت و مرمت
78 شایع ترین علائم مربوط به آلودگی با کپک ها
79 ارتباط بین و فراوانی کپکها با برخی علائم بیماریها
81 تهدیدات از طریق هوای داخل ساختمان
82 بیو آئروسل های موجود در فضاهای داخلی
83 مروری بر اجزای شیمیایی دیواره سلولی فارچها با تاکید بر آثار بیولوژیک آن در بدن انسان
83 1 و 3 بتا دی گلوکان
84 هیدروفوبین ها
85 ملانین قارچی
85 ترکیبات فرار آلی میکروبی
86 مايكوتوكسين ها
87 بیماریهای آلرژیک و مسمومیتهای ناشی از قارچها
89 بیماریهای آلرژیک
89 آسم و آلرژی
90 سینوزیت
91 آسپر جیلوزیس
بخش دوم خصوصیات زیستی عوامل میکروبی مسبب فساد کاغذ و مواد سلولزی
فصل :اول آشنایی با خصوصیات باکتریهای تجزیه کننده مواد سلولزی
96 نقش و اهمیت میکروارگانیسم ها در زندگی بشر
97 خصوصیات کلی باکتریهای تجزیه کننده مواد سلولزی
97 باکتریهای سلولیتیک هوازی
97 اسید و ترموس
97 اکتینومیست ها
98 استرپتومایسس
99 میکروبیسپورا
ص: 4
99 ترمومنوسپورا
100 باسیلوس
100 سلولوموناس
101 سل ويبريو
101 سودوموناس
102 باکتریهای سلولیتیک بی هوازی
102 استوويبريو
102 باکتروئیدها
103 كلدو سلوم
103 کلستریدیوم
104 رومینوکوکوس
106نگاهی اجمالی به گونه های مختلف جنس باسیلوس
106 باسیلوس سوبتيليس
108 باسيلوس ليكنيفورميس
108باسیلوس پومیلوس
108باسیلوس استثار و ترموفيلوس
108 باسیلوس کو آگولانس
109 نقش باسیلوسها در تجزیه سلولز
فصل دوم آشنایی با خصوصیات ظاهری و میکروسکپی قارچهای آسیب رساننده
114 اختلاف باکتریها و قارچها
114 طبیعت و ماهیت قارچها
115 خصوصیات قارچ ها
116 ساختمان رویشی
119 قارچهای ساپروب
119 طبقه بندی قارچهای ساپروب
123 احتیاط و مراقبت های لازم در آزمایشگاه قارچ شناسی
124 روشهای آزمایشگاهی در مطالعات قارچ شناسی
124 روش مطالعه کشت قارچ
126 تعیین مشخصات ساختمان میکروسکپی قارچ
130 آشنایی با خصوصیات ظاهری و میکروسکپی قارچهای آسیب رساننده
130 جنس آبسیدیا
132 اپیکو کوم
133 جنس آسپر جیلوس
134 آسپرجیلوس فومیگاتوس
135 آسپر جیلوس نیجر
137 آسپرجیلوس فلاوس
139 آسپرجیلوس ترئوس
ص: 5
140 آسپر جیلوس كلاواتوس
141 آسپرجیلوس گلوکوس
143 اسپر جیلوس کاندیدوس
143 آسپر جیلوس نیدولانس
145 آسپر جیلوس اوکراسئوس
145 آسپر جیلوس پارازیتیکوس
146 آسپر جیلوس پنی سیلوئیدس
147 آسپر جیلوس ورسیکالر
148 استاکی بوتریس
148 استمفيليوم
149 اسکوپولاریوپسیس
151 اسکوپولاریوپسیس برویکالیس
151 جنس آکرومونیوم یا سفالوسپوریوم
154 تشخیص افتراقی جنس آکرومونيوم از جنس فيالوفورا
154 تشخیص افتراقی جنس آکرومونیوم از جنس فوزاریوم
154 جنس آلترناریا
156 اورٹوبازیدیوم پولولانس
158 اولو كلاديوم
159 بایپولاریس
160 بوتريتيس
161 بيوريا باسیانا
162 جنس پسیلومایسس
165 جنس پنیسیلیوم
167 پنیسیلیوم فرکوئنتنس
168 پنیسیلیوم کازی کولوم
168 پنیسیلیوم نوتاتوم
169 پنیسیلیوم اکسپنسوم
169 پنیسیلیوم وروکولوزوم
169 پنیسیلیوم سیکلوپیوم
170 پنیسیلیوم پورپوروژنوم
170 پیتومایسس
171 تريكوتشيوم
172 جنس تریکودرما
173 تریکودرما هارزیانوم
174 تريكو درما ويريده
175 تورولومايسس
175 ژئوتریکوم
176 جئومایسس پانوروس
ص: 6
176 درکسلرا
178 رایز وپوس
180 رايز وموكور
181 سپدونیوم
182 سرپولا لاکریمنس
182 سود آلشر یا بویدی ای
184 سیر سینلا
185 سین سفالاستروم
186 جنس فوزاریوم
187 فوزاریوم سولانی
188 تشخیص افتراقی جنس فوزاریوم از جنس آکرومونیوم
188 فوما
190 کانینگهاملا
191 کتوکونیدیوم یا چتو کونیدیوم
191 کتومیوم
193 جنس کرایزوسپوریوم
194 جنس کلادوسپوریوم
196 کلادوسپوریوم فولووم
196 کلا د وسپوریوم هرباریوم
196 کلاد وسپوریوم ماکروکارپوم
197 کلادوسپوریوم اسفرو اسپرموم
197 كورو ولاريا
198 گرافیوم
199 گلیو کلادیوم
200 مونوسپورا
201 مونيليا
201 مونيليا سيتو فيلا
202 جنس موکور
204 موکور سیرسینه لوئيدس
204 موکور راموسیسیموس
205 جنس نیگروسپورا
206 ورتيسيليوم
207 هلمنتوسپوریوم
208 همی سپورا
209 هو ميكولا
211 نمایه فارسی
221 نمایه انگلیسی
ص: 7
میراث مستند ایران اسلامی در بناهای تاریخی سراسر کشور همچنین در نسخ خطی اسناد و پیشینه های فراوان موجود در موزه ها آرشیوها کتابخانه ها و حتی مجموعه های شخصی چشم نوازی میکند که نشانگر غنای فرهنگی تمدنی عظیم است که در بطن خود هزاران راز نهفته را جای داده است. گستردگی آثار و تنوع زیاد در نوع عناصر ساختاری و تکنیک های بکار رفته در خلق آنها توسط هنرمندان ایرانی در طی قرون متمادی، سبب شده است که این آثار همواره به دلایل مختلف در معرض خطر نابودی قرار داشته باشند. لذا توسعه واقعی فرهنگی زمانی محقق میشود که با تحقیقات بنیادی در بقای آنها بکوشیم از سوی دیگر تبادل اطلاعات در این راستا میتواند نقش ارزنده ای را در حفظ و نگهداری آثار گرانسنگ کشور داشته باشد. اینکه چه اثر مکتوبی در کجای این کشور نگهداری میشود مهم نیست بلکه چگونگی حفاظت و نگهداری آن از وظائف اصلی و اساسی ما در سازمان اسناد و کتابخانه ملی جمهوری اسلامی ایران به عنوان نهادی مرجع در حفظ و نگهداری میراث مستند می نظر به اینکه علوم مختلف نقش موثری میتواند در مرمت آثار مکتوب ایفا نماید بنابراین جهت بهبود روشها و رویههای موجود در حفظ و نگهداری ،آثار لزوم مشارکت متخصصین رشته های مختلف اجتناب ناپذیر خواهد بود لذا برای تحقق این مهم آزمایشگاه آسیب شناسی اسناد در سال 1372 در سازمان اسناد ملی ایران (سابق) راه اندازی و در آن به بررسی آسیبهای بیولوژیکی و شیمیایی به اسناد پرداخته شد. این کتاب به تفصیل درباره عوامل بیولوژیک میکروارگانیسمی شامل قارچها و باکتریهای مسبب آلودگی و فساد در منابع کاغذی بحث میکند و در فصول جداگانهای خصوصیات زیست شناسی روشهای جداسازی و شناسایی آنها از روی اسناد آلوده و یا آسیب دیده کاغذی انواع و چگونگی این آسیبها و روشهای کنترل و پیشگیری از آسیب را بیان می.کند برخی از حشرات مهم که موجب آسیب در اسناد و اشیای کاغذی می شوند نیز مورد بحث قرار گرفته است همچنین انواع آسیب های وارده توسط این میکروارگانیسم ها به کارکنان بخشهای حفاظت و مرمت مورد اشاره قرار گرفته است که آگاهی به آن در حفظ و ارتقای بهداشت
ص: 8
و سلامتی کارکنان این بخشها کمک میکند
مخاطبان ،کتاب پژوهشگران کارکنان حوزه مرمت و حفاظت منابع آرشیوی و کتابخانه ای و دانشجویان رشته های کتابداری ،هنر باستان شناسی مرمت آثار تاریخی و حتی رشتههایی نظیر میکروب شناسی قارچ شناسی و زیست شناسی می باشند.
در پایان لازم میدانم از نویسندگان کتاب که آن را با تکیه بر دستمایه های علمی چند ساله تدوین کرده اند سپاسگزاری نمایم
اسحق صلاحی
رئیس سازمان اسناد و کتابخانه ملی
جمهوری اسلامی ایران
ص: 9
عوامل مختلفی موجب آسیب منابع و مواد آرشیوی و کتابخانه ای می.شوند بطور کلی عوامل آسیب رسان را میتوان در سه دسته عوامل ،فیزیکی شیمیایی و بیولوژیکی زیستی نام برد دو عامل نخست در این کتاب مورد بحث و بررسی قرار نگرفته است. عوامل زیستی شامل طیف وسیعی از موجودات زنده است. در بین موجودات زنده برخی از گیاهان جانوران پستانداران) جونده ی موذی پرندگان و حشرات به اشیاء و مواد کاغذی آسیب میرسانند یکی از عوامل بیولوژیک مهم آسیب رساننده انواع میکروبها هستند که دربرگیرنده گروه های متفاوتی از باکتریها و دامنه ی بسیار متنوعی از قارچهای میکروسکپی میباشند هرچند که تاکید بیشتر این کتاب بر روی عوامل میکروبی ،است اما حشرات آسیب رساننده به کتاب و منابع آرشیوی و کتابخانه ای از نظر دور نمانده و در حد اشاره به آن نیز پرداخته شده است. علت این مسئله نیز آن است که هنگام بررسی منابع آرشیوی و کتابخانه ای از نظر آسیب ها و صدمات میکروبی با آثار و شواهدی از آسیب های ناشی از حشرات برخورد می.شود بطور کلی آسیب های ناشی از حشرات و عوامل میکروبی عمومیت بیشتری داشته و در همه ی مناطق دنیا بویژه در مناطق گرمسیری و نیمه گرمسیری دیده میشود در صورتیکه آسیبهای ناشی از جانوران و گیاهان محدود به برخی اماکن بوده و یا در شرایط خاص جغرافیایی یا جوی اتفاق میافتند عوامل میکروبی بدلیل آنکه به آرامی موجب فساد و خرابی در اشیاء و مواد کتابخانه ای و آرشیوی میشوند و مانند حشرات یا جوندگان برای عموم قابل رؤیت نیستند و مشاهده ی آنان نیاز به وسائل خاصی مانند میکروسکوپ دارد عوامل زنده خاموش نامیده میشوند خوشبختانه در دهه های اخیر توجه بیشتر باستان شناسان، سندشناسان حفاظت گران و مرمتگران به این عوامل زنده خاموش و بی سروصدا جلب شده و در صدد شناسایی آنها و رفع آلودگی یا ضدعفونی اسناد یا اشیای آلوده برآمده و به جستجوی راه های پیشگیری و حفاظت از آنها و مرمت اشیای آلوده پرداخته اند. بیش از بیست گونهی باکتریایی و افزون بر 350 گونه قارچی بعنوان عوامل بیولوژیک مخرب اسناد کاغذی شناخته شدهاند. با توجه به وسعت و تنوع زیاد این قارچها تنها به شناسایی انواع شایع تر این دسته از موجودات
ص: 10
،پرداخته سپس چگونگی آسیبهای وارده به مواد کاغذی مورد بررسی قرار می گیرند. در نهایت راههای پیشگیری از آلودگی راههای مبارزه با قارچ های بیماریزا قارچهای مخرب اسناد و قارچهای بیماریزای تهدید کننده سلامت مشاغل مرتبط و بالاخره نحوه مراقبت از اسناد پاکسازی شده مورد مطالعه قرار میگیرند افتخار سالیان متمادی همکاری علمی و فنی با مدیریت آماده سازی و مرمت سازمان اسناد ملی ایران که بعدها در مجموعه ی بزرگ سازمان اسناد و کتابخانه ملی جمهوری اسلامی ایران قرار گرفت برای اینجانب فرصتی برای گردآوری و پژوهش در زمینه ی آسیب شناسی آثار کاغذی فراهم آورد که در نهایت به تدوین و تنظیم مجموعه نوشتاری فعلی منجر شد. در این فرآیند جای آن دارد که از جناب آقای دکتر صلاحی ریاست محترم سازمان اسناد و کتابخانه ملی ج... ، جناب آقای عزیزی معاون محترم اسناد ملی ، جناب آقای صفی
و پورمعاون محترم ،پژوهش برنامه ریزی و ،فناوری سرکار خانم صدیقه روحی مدیرکل محترم حفاظت ،نگهداری سرکار خانم شهناز بهلولی رئیس گروه محترم آسیب شناسی و آزمایشگاه و سایر همکاران شریف و پرتلاش اداره کل حفاظت و نگهداری این مجموعه عظیم و از سایر مسئولین و مدیران مدبر و کوشای آن به ویژه جناب آقای محمد بقایی سرپرست محترم اداره کل پژوهش و آموزش و جناب آقای مرتضی معصومیان رئیس محترم اداره انتشارات تشکر و قدردانی گردد.
امید است مجموعه ای که اینک آماده ی نشر گردیده قابل استفاده و بهره برداری توسط دانشجویان و کارکنان صدیق و زحمتکش بخشهای مختلف حفاظت و مرمت موزه داران کتابداران باستان شناسان و سایر مشاغل مرتبط باشد.
محمد ،قهری استادیار دانشگاه امام حسین (ع)
زمستان 1390
ص: 11
آرتروسپور اسپور تک سلولی و رویشی که در نتیجه تولید تعداد زیادی دیواره عرضی در طول ریسه تشکیل می.شوند آرتروسپورها دیواره نسبتا ضخیم داشته و هنگام رسیدن از یکدیگر جدا میشوند
اسکلروشیوم (Sclerotium) توده ی سازمان یافته ای از هایفاها که در شرایط نامساعد و نامطلوب به حالت خفته باقی میمانند.
گاهی به جای یک سلول یک رشته ریسه) تغییر شکل داده و اندامهای دیگری را میسازد یکی از این اندامها اسکلرو شیوم است که از اجتماع ریسه ها و ضخیم تر شدن سلولهای متشکله آن بوجود می آید.
اکتینومیستالها دسته ای از باکتریها هستند که سلولهای آنها بصورت رشته ای و متصل به هم رشد کنند، اکثراً ساکن خاک بوده و از آنها در صنعت داروسازی وصنایع دیگر استفاده میشود شامل سه دسته بنامهای اکتینومیستها نوکاردیاها و استرپتومیستها میباشند
آنزیم آنزیم ها دسته ای از پروتئینها و ماکرومولکولهای حیاتی هستند که قادرند در واکنشهای بیوشیمیایی به عنوان کاتالیزور عمل نمایند. دامنه فعالیت آنزیم ها می تواند به صورت داخل سلولی یا خارج سلولی در سیستمهای بیولوژیکی باشد. اما امروزه دامنه کاربرد آنزیمها به دنیای خارج از سیستمهای بیولوژیکی نیز گسترده شده و بخش وسیعی از صنعت ترکیبات آلی را بخود اختصاص داده است
پروپاگول :(Propagule) یک واحد تولید مثلی مربوط به قارچها است.
پیکنیدیوم (Pycnidium) یک جسم میوه ای و کیسه ای شکل که در قسمت مرکزی آن کونیدی تولید می.شود
تالوسپور کلامیدوسپورها و آرتروسپورها را بدلیل آنکه مستقیماً در نتیجه ایجاد دیواره های عرضی از ریسه ها پدید می آیند تا لوسپور مینامند.
ترموفیل گرمادوست میکروبی که در دمای 55 تا 56 درجه ی سانتیگراد بهتر رشد میکند
جوانه زدن قارچهای مخمری اغلب تک سلولی یک هسته ای و به اشکال ،گرد، بیضوی و یا کشیده و سیلندری وجود دارند گونههای اندکی از مخمرها با روش دونیم شدن (Fission) تکثیر می یابند اما اغلب آنها به روش جوانه زدن (Budding) زیاد میشوند.
دگرگونی بیولوژیکی (Biodeterioration): هر گونه تغییر نامطلوبی در خواص یک ماده که در اثر فعالیتهای حیاتی میکروارگانیسمها ایجاد میشود این تعریف توسط Hueck در سال 1965 یا 1968 برای اولین مرتبه انجام شده است ریزومورف (Rhizomorph) گروهی از ریسه ها ممکن است به هم پیوسته و تولید ریزومورف نمایند که
ص: 12
منشعب و دراز بوده و قارچ را قادر میسازد تا برای دستیابی به منابع غذایی به نواحی دورتر دسترسی یابد و گسترش پیدا کند.
سایکروفیل سرما دوست، میکروبی که در دمای 15 تا 20 درجه ی سانتیگراد بهترین رشد را دارد.
سپتا (Septa) مفرد آن سپتوم است. بعد از بالغ شدن ریسه ها در قارچهای سپتومیست در آنها دیواره عرضی یا تیغه ی عرضی بنام سپتا ایجاد میشود سلولاز یکی از آنزیمهای بسیار مهمی که در دنیای صنعت امروز گسترش فراوانی یافته و کاربردهای بسیاری پیدا کرده است. این آنزیم قادر است سلولز که یک پلیمرهیدروکربنی است و به سختی تجزیه می گردد را به مولکولهای کوچکتر و واحدهای سازنده اش تجزیه .نماید به همین خاطر در بسیاری از صنایع از جمله صنعت چوب کاغذسازی نساجی و به طور کلی صنایعی که سلولز به عنوان یک ترکیب اصلی در ساختار آن صنایع میباشند اهمیت پیدا کرده است تولید این آنزیم به روشهای مختلف صنعتی و بیولوژیکی امکان پذیر
است.
سوبسترا به ماده ای گفته میشود که قارچها روی آن رشد کرده و از آن تغذیه مینمایند. کاغذ، چوب، چرم برگ درختان لاشه حیوانات و گیاهان محیطهای کشت آزمایشگاهی مواد غذایی از قبیل، مربا ، نان میوه ها و. ... سوبستراهای مناسبی برای قارچها محسوب میشوند
فومیگاسیون: استفاده از مواد شیمیایی میکروب کش بصورت بخار یا گاز در محیط و فضاهای بسته و محدود میباشند.
فونژیسید یا قارچ کش (Fungicide) : به موادی گفته میشود که خاصیت قارچ کشی داشته و سبب مرگ سلولها و اسپورهای قارچی میگردند
فونژیستاتیک (Fungistatic) عوامل مهار رشد ،قارچها این واژه برای موادی بکار میرود که قدرت قارچ کشی نداشته و تنها موجب متوقف شدن رشد قارچها میگردند
قارچهای فرصت طلب قارچهایی که فقط در شرایطی که دفاع میزبان آسیب دیده و یا تضعیف شده باشد قادر به ایجاد بیماری هستند. آسپر جیلوس یک مثال کلاسیک از این دسته از قارچها میباشند
کپک (Mold) قارچهای رشته ای یا ریسهای میکروسکپی پرسلولی از دسته ی یوکاریوتها هستند که قرابت و خویشاوندی با قارچهای بزرگ و کلاهکدار دارند اما ارتباطی با گیاهان ندارند. قارچهای کلاهکدار و قارچهای میکروسکپی در طبقه بندی موجودات زنده در سلسله مستقلی بنام قارچها (Fungi) جای دارند.
(1969 ,Whitacker)
ص: 13
کولارت (collarette) : یقه (collar) کوچک
کلامیدوسپور سلولهای منفرد ممکن است از مواد مغذی انباشته شده دیواره ضخیم و مقاومی پیدا کرده و وارد مرحله استراحت شوند که به اینها کلامیدوسپور میگویند. این سلولها معمولاً بزرگ تر از سلولهای رویشی بوده و ممکن است بصورت جدا از هم یا بصورت گروهی در انتهای ریسه ها بوجود آیند.
کلوملا (columella): یک برآمدگی گنبدی شکل در قارچهای زیگومیست که در رأس یا انتهای اسپورانژیوفور قرار دارد.
کونید یوفور یکهایفا اختصاصی که بر روی آن کونیدیها تولید میشوند. کونیدیوم (جمع: کونیدیا) یک واحد تکثیری غیر جنسی بدون حرکت که بوسیله ی شکاف سیتوپلاسمی و یا جفت شدن (conjugation تولید نمیشود
:مزوفیل میکروبی که در دمای بین 20 تا 55 درجه ی سانتیگراد بهتر رشد میکند
میسلیوم (Mycelium) تجمع توده ای از هایفا که یک قارچ را تشکیل میدهند
میسلیوم کاذب گاهی سلولهای دختری ایجاد شده از یکدیگر جدا نشده و در اتصال با یکدیگر باقی میمانند و منظرهای شبیه ریسه بوجود میآورند که به آن سودوهایفی یا میسیلیوم کاذب (Pseudohyphae or Pseudomycelium میگویند
میکروارگانیسم منظور موجودات میکروسکپی تک سلولی یا پرسلولی است که شامل باکتریها ویروسها کلامیدیاها مخمرها قارچهای کپکی و پروتوزوآها میباشند
هايفا (Hyphae) سلولهای قارچی را در انواع پرسلولی ریسه یا هایفا مینامند و از اجتماع ریسه ها میسیلیوم تشکیل میشود
ص: 14
عوامل بیولوژیک
فساد بیولوژیکی
طبقه بندی انواع آسیبهای بیولوژیکی
تخریب بیولوژیکی کاغذ
چرا قارچها و دیگر میکروارگانیسم ها باعث فساد و تجزیه اشیای کاغذی میشوند؟
تجزیه سلولز بوسیله باکتری ها
تجزیه سلولز بوسیله قارچ ها
تصویر شماره 1

ص: 15
در قدیم کلیه موجودات زنده روی زمین را در دو دسته بزرگ گیاهان و جانوران طبقه بندی میکردند با اختراع میکروسکوپ در قرن هفدهم میلادی زیست شناسان متوجه دنیای ذره بینی شدند و با توجه به اندازه بسیار کوچک و ظاهر ساده آنها که دانشمندان را به یاد موجودات زنده اولیه میانداخت نام آغازیان را برای آنها برگزیدند در سلسله آغازیان موجودات تک سلولی برخی مشابه سلولهای گیاهی و برخی مشابه سلولهای جانوری بنام پروتوزواها بودند. باکتریها، ویروسها و قارچهای ذره بینی نیز در این قلمرو قرار .داشتند در جدیدترین طبقه بندی که در حال حاضر نیز مورد توافق تمامی زیست شناسان میباشند موجودات زنده را به پنج گروه بزرگ به شرح زیر طبقه بندی میکنند
.1 مونه را Monera): موجودات پروکاریوت فاقد هسته حقیقی بوده و شامل ویروسها، باکتریها، اکتینومیستها و جلبکهای سبز آبی میباشند
2. تک سلولی ها (Protoctista): موجودات یوکاریوت (واجد هسته حقیقی بوده و شامل پروتوزواها و دیگر ارگانیسمهای تک سلولی و ایجاد کننده کلنی مانند جلبک های هسته ،دار کپکهای آبزی تاژکدار و کپکهای لعابی میباشند
3. قارچها (Fungi) ارگانیسمهای یوکاریوت هستند که بوسیله اسپور تکثیر حاصل نموده و فاقد تاژک می.باشند شامل مخمرها شبه ،مخمرها کپک های حقیقی و قارچهای کلاهکدار بوده تک سلولی یا پر سلولی هستند و بدلیل فقدان کلروفیل قادر به انجام فتوسنتز نیستند و بنابر این هتروتروف دیگر غذا) و از نظر غذایی وابسته به موجودات دیگر میباشند
4. گیاهان (Plantae) موجودات یوكاریوت بوده بوسیله تولید تخم و سلولهای جنینی تکثیر مییابند و شامل خزه ها سرخسها و گیاهان آوند دار میباشند
5. جانوران(Animalia) ارگانیسمهای یوکاریوت بوده که از طریق یک بلاستولا توپ سلولی حفره (دار توسعه و تکثیر می.یابند
اصطلاحاً به تمام موجودات زنده عنوان عوامل زنده یا عوامل زیستی و یا عوامل بیولوژیک اطلاق می گردد. در بین هر پنج سلسله موجودات زنده عوامل متعددی که هر یک به نحوی میتوانند به مواد و اشیای کاغذی آسیب برسانند وجود دارد. در این بین جانوران جوندگان و عمدتاً حشرات مونه را باکتریها و اکتینومیستها و قارچها مخمرها و عمدتاً کپکها مهمترین عوامل بیولوژیک مخرب مواد کاغذی می.باشند از بین مهمترین عوامل بیولوژیک قارچها به دلیل تنوع بسیار زیاد و قدرت تطابق بسیار بالا برای
ص: 16
زیستن در شرایط مختلف درجات حرارتی بسیار بالا یا بسیار پایین و شرایط رطوبتی (مختلف عمده ترین و شایع ترین این عوامل هستند
تخریب (فساد) بیولوژیکی (biodeterioration چیست؟ این واژه حدود 40 سال است که مورد استفاده قرار گرفته .است از زمانی که انسانها آغاز به تصرف و استفاده از مواد عناصر کرده اند این فرایند بشر را تحت تأثیر قرار داده
است. برخی از شاخه های علم و تکنولوژی یا نیازی به تعریف ندارند و یا برای استفاده متداول تعریف قابل قبولی از آنها دیده نمیشود در چارچوب موضوع تخریب بیولوژیکی تعریف خوبی اولین بار توسط H.J.Hueck مطرح گردید که به سرعت مورد قبول واقع شد Hueck در سال (1968-1965) تخریب بیولوژیکی را تحت عنوان هر تغییر نامطلوبی در خواص یک ماده تعریف کرد که نتیجه فعالیتهای حیاتی ارگانیزم زنده است. اصطلاح دیگری که از آن به طور معمول استفاده شده و معمولا بکار میرود تجزیه (انحطاط) بیولوژیکی (biodegradation) است، اگرچه هیچگونه تعریف اسمی و کاملی به لحاظ کلی درباره آن مورد قبول واقع نشده است دو تعریف یکی در مسیر منفی یا مضر تحت عنوان «فساد» بیولوژیکی و دیگری در مسیری مثبت و مورد استفاده یعنی تجزیه بیولوژیکی» وجود دارد هر دو تعریف شامل مواد و عناصر نیز می.شود تمامی مواد و فرایندها ارزشی لاینفک دارند بنابراین در اینجا جنبه مهم اقتصادی در مورد فساد بیولوژیکی مورد نظر است.
تعداد زیادی از مواد مورد نیاز انسان اولیه از گیاهان و حیوانات با حداقل تغییرات بدست می آمد. چنین موادی بطور قابل ملاحظه ای در برابر حمله ارگانیزمها آسیب پذیرتر بودهاند و دگرگونی ،بیولوژیکی، احتمالاً نقش مهمی را در تمدنهای اولیه که قادر به توسعه و گسترش ،بودند ایفا میکرده است. در منطقه ی خاورمیانه که از زمان باستان بعنوان مهد تمدن لقب ،گرفته شرایط اقلیمی برای نگهداری و پرورش آسان غلات وجود داشته و این مزیتها در گذشته و حال منجر به پیشرفت و توسعه در این ناحیه شده است. روشهای کنترل اولیه دگرگونی بیولوژیکی از اصول و قواعد اساسی بهره گرفته و امروزه نیز همچنان به خوبی حفظ شده است در گذشته غذا بصورت تازه مصرف میشد و با توجه به رشد حداقلی میکروبها فرصتی برای آنکه هرگونه دگرگونی بیولوژیکی رخ دهد وجود نداشت همچنین برای محافظت در برابر حشرات و حیوانات موذی از روشهای فیزیکی مانند استفاده از شیشه ها یا قوطیهای درب دار و یا افزودن نمک و ادویه جات به عنوان مواد نگهدارنده استفاده میشدند در جهان ،امروز سلسله حیرت آوری از مواد وجود دارند تعداد زیادی از آنها بسیار پیچیده هستند و از مواد خام اولیه تغییر زیادی مییابند جاده ها
ص: 17
و شهرهایی که در جنگلهای بارانی ساخته شدهاند بناها و ساختارهایی که در دریاها و اقیانوسها برای کاوش نفت و استخراج آن بنا شدهاند و وزارتخانه های عالی رتبه و بلوکهای آپارتمانی که از تکنولوژی ساخت و ساز جدید بهره میگیرند در تمامی این مواد و محیطهای جدید با حضور سلسله ی فراوانی از ارگانیزمهای موجود در محیط زیست انواع اساسی و اصلی دگرگونی بیولوژیکی را که ممکن است اتفاق بیفتد، میتوان طبقه بندی کرد اگر چه طرح این نوع طبقه بندی میتواند مصنوعی بنظر برسد اما ممکن است یک ارگانیزم موجب بیش از یک نوع دگرگونی بیولوژیکی .گردد
ص: 18
در این نوع دگرگونی ارگانیزم زنده با رشد و حرکت خود مواد را به سادگی تجزیه میکند یا از شکل می اندازد اما از آن به عنوان یک منبع تغذیه استفاده نمیکند در این نوع آسیب تعداد اندکی مثال وجود دارد که میکروبها مسبب آن .باشند. یکی از بهترین این مثالها افزایش تودههای میکروبی بین لایهی سنگ است که منجر به تخریب سطح رویه آن می.شود مثالهای دیگری که مسبب آنها ارگانیزم های عالی تر هستند شامل ترک خوردن لوله های زیر زمینی فرسایش کابلهای برق، بلوک های سبک و تخته های گچی و چوب توسط جوندگان و یا اصابت پرندگان با هواپیما میباشند آخرین مثال نشان دهنده آن است که دگرگونی بیولوژیکی لزوما توسط هر فرایند ذی شعوری از ارگانیزمها نمیباشند
در اینجا آسیب به حضور یک ارگانیسم (سیستم) یا جسم مرده آن مربوط می.شود فضولات یا تولیدات متابولیسمی ساخت و ساز حشرات ،مرده موارد موریزی سگ و (گربه یا پر ریزی پرندگان یا فضولات حتی اگر برخی موارد لزوماً مضر نباشند صرفا وجودشان میتواند موجب فروش نرفتن مواد غذایی .گردد یک نمونه برجسته در اینجا توده قارچهای تیره است که بر روی صابون مرطوب و پردههای دوش حمام که پلاستیکی هستند رشد می.کنند این حالت عملکرد مواد مورد ابتلا را تحت تأثیر قرار نمیدهند اما رشد آنها یک ظاهر غیر قابل پذیرش
را خلق می.کند همچنین ممکن است تعداد زیادی از قارچها رنگدانه های حل شدنی یا غیر قابل حل شدنی از خود رها سازند فاسد شدن میتواند جدی تر باشد و فراتر برود آلودگی های اضافی بر روی کشتی ها سبب تجمع خزه ها و جانوران بی مهره بر بدنه کشتی میشود
تصویر شماره 2 : آثار مربوط به قارچها روی پوشش های دیواری علاوه بر آسیب دیدن ،سطوح منظره ی ظاهری آنها را تحت تأثیر قرار میدهد.

ص: 19
که مصرف سوخت کشتی را به طور چشمگیری افزایش میدهد و فشار بیش از اندازه بر ساختارهای کشتی ساختارهای دریایی مانند سکوهای نفتی قابل ملاحظه است.
در اکثر موارد دگرگونی زیبایی شناختی به دلیل حضور لایه های سطحی میکروبها و فرآورده های آن است. تصویر شماره 2 نمونه ای از آن را نشان میدهد این لایه های میکروبی بنام بیوفیلم (غشای نازک سطحی از میکروب پوشیده شده تحت عنوان توده های سطحی از فرآورده های آلی فعالیت های بیولوژیکی تعریف شده اند. بطور کلی اما نه همیشه آنها در بر دارنده سلولهای حیاتی میکروبی هستند و در این مورد ممکن است وجود آنها منجر به تولید انواع دیگری از تخریب شوند در جایی که سلولها در تماسها و برخوردهای فیزیکی با مواد هستند و به ندرت در محیط اطراف پراکنده میشوند فعالیتهای سلولهای آسیب ،رسان، محدود و متمرکز به یک محل هستند و اثرات و نتایج آن به مراتب مخرب تر است بهترین بیوفیلم های بررسی شده آنهایی هستند که بر روی دندانها قرار دارند و نتیجه فعالیتهای این باکتریها در این بیوفیلم ها به راحتی و حتی توسط شخص غیر متخصص قابل شناسایی هستند.
این نوع ،آسیب، شاید قابل فهم ترین بخش از دگرگونی بیولوژیکی است ارگانیزم زنده بطور کلی و به سادگی از مواد مختلف بعنوان یک منبع تغذیه یا انرژی استفاده می.کند آنزیمهای میکروبی انواع متفاوت سلولزها را تحت تأثیر قرار میدهند موشها حیوانات موذی و حشرات دانههای ذخیره شده را میخورند و لاروهای حشرات که مصرف کننده میوههای انبار شدهاند همگی مثالهایی از این نوع دگرگونی بیولوژیکی .هستند مواد غذایی فاسد شده توسط ارگانیزمهای تخریب کننده در نظر اغلب مردم شناخته شده ترین و قابل در کترین مثال است این حقیقت که موادی همچون سوختهای هیدروکربنی روغنهای تقلیل یافته چسبها بتونهها و منسوجات و دیگر موارد غیر خوراکی میتوانند مورد استفاده میکروبها قرار بگیرند اغلب از طرف مردم ملموس و قابل قبول نیست و همین مسئله اغلب موجب تأخیر در پیدا کردن علت مشکلات میشود
در این نوع ،آسیب یک ماده از تخریب شیمیایی رنج میبرد اما نه به عنوان نتیجه ای مستقیم از پذیرش مواد غذایی توسط ارگانیسم ،زنده بسیاری از ارگانیسم ها مواد زائد را دفع میکنند که شامل رنگدانه ها یا ترکیبات اسیدی هستند. این مواد زائد میتوانند منابع و مواد مختلف را از شکل بیاندازند و یا خراب کنند این نوع دگرگونی
ص: 20
بیولوژیکی اغلب با دگرگونی ناهمگونی شیمیایی و با بیوفیلمها دست به دست هم میدهد و ممکن است تمیز دادن آنها را مشکل سازد
هیچ معیار مشخصی برای جدا کردن هر ارگانیزم از فاسد کننده های واقعی یا نهفته بالقوه) وجود ندارد به جز انگلهای ملزم شده که مواد غذایی خود را از بافت زنده میزبانشان تهیه می.کنند چنین انگلهایی به خوبی میتوانند با فاسد کننده ها متحد شوند مانند کک (موش) بنابراین سلسله تخریب کنندههای نهانی گسترده هستند، اگرچه با وجود تعداد زیادی از ارگانیزمها اثرات فاسد کننده ها تنها بخش ناچیزی از فعالیتهایشان میباشند.
درون زیست کره عناصر بطور پیاپی در حال باز یافت هستند. شما با چرخههای کربن و نیتروژن آشنا هستید این امکان وجود دارد که چرخه ها را برای عناصر دیگر نیز در نظر بگیرید اگرچه برخی مانند) (سدیم در محیط زیست در مقادیر عظیمی وجود دارند چنانکه اثرات ارگانیزمهای حیاتی را ناچیز میسازد. چرخه کربن به طور قطع فرایندی بیولوژیکی و مهمترین منبع تغذیه ای آن ترکیبات سلولزی است که در گیاهان عالی یافت میشود. فرجام نهایی همه مواد سلولزی که توسط انسان استفاده میشوند این است که توسط ارگانیزمها میسوزند و یا شکسته میشوند بنابراین جلوگیری از دگرگونی ،بیولوژیکی فرایندهای تخریب طبیعی را به تأخیر می اندازد. دگرگونی بیولوژیکی ضایعات میتواند به عنوان یک فرایند متضاد لحاظ گردد.
موارد دگرگونی بیولوژیکی باید ابتدا و قبل از آنکه هرگونه ارزش اقتصادی بر آنها گذاشته شود شناسایی گردند برخی از موارد تخریب مواد بطور واضح منشاء بیولوژیکی دارند سوراخهای حفر شده توسط موشها در صنعت ،نجاری چوبهای محصور شده توسط علف های هرز رشد کرده در اطراف آنها و فضولات کبوترها که لبه ساختمانها را بدشکل کرده همگی مثالهای واضحی از این امر میباشند اما مواردی که کمتر آشکار هستند عبارتست از جسم میوه ای شکل قارچها که در قسمتهای چوبی خراب شده دیده میشوند یا رشد کپک در منابع غذایی در اینجا بطور واضح مشکلی وجود دارد و آن این است که بسیاری از افراد چنین رشد و نموهایی را به عنوان ارگانیزمهای حیاتی تشخیص نمیدهند موارد رشد میکروبی که به خوبی در مواد ترکیب یا پخش شده اند مثل باکتریها در مایعات رشد قارچها در سوختهای هیدروکربنی لایه های رنگی
ص: 21
شده توسط قارچها و جلبکها با سهولت بیشتری قابل شناسایی هستند به دلیل اندازه کوچک ارگانیزمهای درگیر نا آشنا بودنشان و این حقیقت که پایه و اساس آنها به لحاظ شیمیایی خیلی متفاوت است. نمونه هایی چون فساد یا خوردگی فلزات در اثر عوامل میکروبی ممکن است در مکانیزم فیزیکوشیمیایی جداگانه ای نیز نقش داشته باشند که این میتواند به مراتب مشکل تر شناخته و اندازه گیری شود حتی اگر مشخص شده باشد که منشاء آسیب رساندن به عناصر بیولوژیکی است باز در فهرست گزارشهای معمول قرار نمیگیرند و به سادگی با دیگر انواع کمیاب مانند گندیدگی طبقه بندی میشوند بنابراین شواهد و مدارک صحیح هزینه های دگرگونی بیولوژیکی اغلب پوشیده و یا غیر قابل شناسایی است.
در هر جایی که مشخص شده باشد مواد و وسایل آن منطقه یا مکان در معرض خطر هستند میتواند از ابتدا اقدامات پیشگیرانه بکار رود. این اقدامات ممکن است فیزیکی مانند خشک کردن سرد کردن یا شیمیایی مانند افزودن ماده نابود کننده ارگانیزمهای زنده (بیوساید و یا ماده نگهدارنده باشد. هزینه این اقدامات میتواند توسط یک تولید کننده یا مصرف کننده برای محصولات انفرادی برآورد شود.
یک محاسبه گسترده
.1 میتوان انواع مواد با میزان آسیب پذیری (حساسیت شناخته شده نسبت به دگرگونی بیولوژیکی را انتخاب کرد اینها میتوانند شامل چوبهای جنگل ،الوار رنگها چسبها منسوجات طبیعی ،فیبری کاغذها و بسته بندیهای مواد و مواد غذایی ذخیره شده باشند
.2 در حین عملیات نگهداری یک محصول یا ماده غذایی مقداری از آن در اثر دگرگونی بیولوژیکی دستخوش تغییر یا نابودی میگردد این موضوع را میتوان بر حسب درصد برآورد کرد به عنوان مثال ممکن است برخی از مواد غذایی هنگام انبار شدن و یا در حین حمل ونقل در مناطق استوایی تا 90٪ دستخوش تغییر
شود.
3. پیدا کردن ارزش سالانه تولیدات ،اجناس در سطوح منطقه ای کشوری و یا جهانی
تقسیم بندی دگرگونی بیولوژیکی با عنوانهای مختلف مناسب اما تصنعی است. تعداد زیادی از مواد طبیعی غیر مصنوعی استفادههای مهم خاص دارند برای مثال چوب و سنگ مواد متداول و اولیه یک ساختمان است.
ص: 22
سلولز ترکیب ساختاری اصلی دیواره سلولی گیاه و شاید فراوان ترین ترکیب زیستی بر روی زمین است. در سراسر جهان تخمین زده شده که نزدیک به 1010×26/5 تن سلولز در مقادیر زیادی تولید شده است و این حقیقت که نسبتاً به سرعت بازیافت شده است هم بر حساسیت و آسیب پذیری آن در مقابل حمله تأکید میکند و هم بر طیف ارگانیزمهایی که قادرند چنین کاری را انجام دهند و از محصولات خراب شده استفاده کنند در گیاهان ،سبز سلولز مهمترین ماده یافت شده در دیواره اولیه سلول و به لحاظ ساختار ضخیم تر از آن است سلولز پدید آورنده منسوجات است این منسوجات خاص تعداد زیادی فیبر گیاهی را به وجود می آورند که توسط انسانها استفاده می.شود سلولز همچنین در برخی از قارچها و نیز در جلبکهای عالی یافت میشود در قارچها و جلبکها سلولز به تنهایی وجود دارد اما در گروه گیاهان عالی بطور متناوب مواد دیگری از قبیل لیگنین موجود است که نسبت به سلولز به مراتب کمتر تحت تأثیر تجزیه بیولوژیکی قرار میگیرد
سلولز یک پلی ساکارید خطی است که از پیوندهای (14) B دی - گلیکوپیرانوز تشکیل شده است گاهی بوسیله پیوندهای هیدروژنی به منظور تولید میکروفیبریلها به زنجیرههای مشابه بصورت متقاطع متصل میشوند بنابراین اگر چه در ساختار ،لیگنین عناصر شیمیایی بنیادی مشابهی همانند سلولز (عمدتاً کربن هیدروژن و اکسیژن دیده میشود اما از واحدهای قندی ساخته نشده است بلکه از واحدهای فنیل پروپان تشکیل شده و یک کربوهیدرات .نیست یک مولکول مشبک نامنظم و دارای وزن ملکولی در حدود 100000 یا بیشتر و ترکیب آن بسیار پیچیده است. لیگنین موجب محافظت از سلولز در برابر حملات میکروبی میشود. سلولز اصلی ترین جزء تشکیل دهنده چوب است و بطور مشابهی مانند فیبرهای گیاهی در منسوجات استفاده می.شود حساسیت پذیری سلولز به حمله بیولوژیکی بستگی به شکل فیزیکی و شیمیایی سلولز و در نتیجه نوع محصول دارد تجزیه فیزیکی فیبرهای سلولز توسط آسیاب شدن تدریجی میتواند شکنندگی و آسیب پذیری آنها را افزایش دهد. هنگام ساخته شدن ،کاغذ لیگنین آن زهکشی شده و قابل انعطاف به ماده ای حساس که شکننده تر است می.گردد آزمایشگاه های زیادی برای ارتقاء سطح کیفی سلولزهای نامنظم و بی شکل همانند کاغذ فیلتر پودر سلولزی و حتی سلولز از نو احیا شده مانند سلوفان فعالیت میکنند. شکی در این نیست که استفاده از این اشکال خالص و در دسترس سلولز برای کارکنان آزمایشگاه آسان تر است. اما نتیجه بدست آمده که باید دقت ویژه ای به آن ،کرد مرتبط با تخریب فساد) چوب یا پوشالها هستند. سلولز اغلب به لحاظ شیمیایی نقش اصلاح کننده در تولید اشکال مشتق شده برای مصارف ویژه را دارد این اشکال تعدیل و احیا شدهی ،سلولز استفادههایی در تولید منسوجات دارند ریون ابریشم مصنوعی سلولز
ص: 23
احیاء شده است بسته بندی فیلمها مانند سلوفان) فیلمهای عکاسی نیترات سلولز و آمیتات، ضخیم کننده ها پرکننده ها و امتداد دهندهها مثال) کربوکسی متیل سلولز در چسبها غذاها و رنگهای امولسیونی بخش عظیمی از این نوع سلولز نسبت به حمله بیولوژیکی حساس و آسیب پذیر هستند.
در گذشته برای بهبود مولکول سلولز از لحاظ شیمیایی به منظور افزایش مقاومت در مقابل حمله بیولوژیکی تلاش میشد اگر چه چنین عملی از لحاظ اقتصادی و به ظاهر چندان رضایت بخش نیست. مکانیزم تخریب سلولز تنها یک مثال از اینکه میکروبها چگونه میتوانند مولکولهای بزرگ را تخریب کنند نیست همچنین اینکه چگونه آنزیمها توسط ارگانیزمها رها میشوند و میتوانند به تجزیه کردن و خراب کردن ادامه دهند حتی هنگامی که سلولهای تولید کننده آنها در حال کاهش بوده و یا زنده نمانده باشند. در سیستمهای صنعتی مایع همه ارگانیزمهای حیاتی از یک رشته آنزیمهای درون سلولی برخوردارند. این آنزیمهای درون سلولی عکس العملهای بیوشیمیایی فراوانی را که درگیر در مصنوعات زنده و فرایندهای آزاد کننده انرژی هستند کاتالیز می.کنند در سلولهای فعال مهمترین این آنزیمهای درون سلولی بطور متناوب در حال تولید هستند آنزیمهای بنیادی آنها ممکن است هنگامی که جانشین مناسب در محیطی بی واسطه در سلول ها در دسترس است، انواع دیگری از آنزیمها را تولید کنند. آنزیمهای برون سلولی نیاز به تخریب مولکولهای بنیادین دارند به اندازه ای که مکانیزمهای انتقالی سلول می تواند به تخریب بیشتر کمک کند.
سلولز (که وزن ملکولی آن بسته به منبع و منشاء آن از 200000 تا 400000 و یا بیشتر متغیر است معمولاً از طریق تعدادی مواد واسطه ای و بوسیله مجموعه آنزیمی تحت عنوان کمپلکس سولاز به گلوکز شکسته میشود. این مجموعه ی آنزیمی از سیستمهای زیر تشکیل شده است یک اگزو گلو کاناز، یک اندو گلو کاناز به کربوکسی متیل سلولاز نیز موسوم است و یک بتاگلوکوزید از سلوبیاز) این مهم است بدانیم که یک ارگانیزم واجد کدامیک از آنزیمهای فوق است؟ در مورد برخی رنگهای امولسیونهی غلیظ که حاوی ترکیبات سلولزی هستند آلودگی میکروبی را می توان با افزودن یک ماده ی ضد حیات (بیوساید) حذف نمود ولی آنزیمها ممکن است بدون تغییر باقی بمانند و موجب کاهش غلظت و چسبندگی (ویسکوزیته رنگ گردند. سایر آنزیمهای برون سلولی مانند پکتینازها آمیلازها و پروتئازها می توانند به شیوه های مشابه عمل کنند این پدیده پاسخگوی عملکرد بیولوژیکی» پودرهای شوینده که حاوی پروتئازها و لیپازها به عنوان از بین برنده لکه های کثیفی هستند میباشند برخی باکتریها شناخته شده اند که قادر به تخریب سلولز هستند باکتری سلولیتیک همانند سلولوموناس (cellulomonas) و سلوویبریو(cellovibrio) میتوانند در سوبستراهای ویژه ای بعنوان مثال چوب یافت شوند اما جداسازی آنها در آزمایشگاه کار دشواری میباشد کارهای بیشتری در مورد اکتینومیستها (actinomycets) که قادر به کلونیزه شدن در مواد زائد قلیایی ناشی از فرایند سلولزی گیاهان هستند انجام شده است که بسرعت موجب برداشتن
ص: 24
بخش سلولزی آنها میشوند باکتری ها در شرایط مرطوب شاید بیشترین اثر خود را بر سلولز بگذارند اما حتی هنگامی که گسترش نقش آنان در تخریب سلولز بیشتر قابل درک است مجموع اثرات آنها در مقایسه با قارچها بسیار کوچک است. شرایط زیست محیطی دیگری که منجر به تخریب سلولز میشود مربوط به دسترسی یا فراهم شدن مواد غذایی می.باشند در این رابطه یک عامل کلیدی نسبت کربن به نیتروژن است. در بسیاری از انواع چوب رابطه مستقیم بین کربن و نیتروژن خیلی بالا است از 1: 350 تا 1: 1250 ، مقدار پایین نیتروژن پتانسیل قارچها را برای حمله به چوب به شدت محدود می.کند چوب جنگلی (الوار) مشتق شده از چوب سخت درختان و اشکال تصفیه شده سلولز همچون کاغذ فیلتر و کتان پخته شده عمل آمده اگر فاقد منبع نیتروژن باشند اغلب نسبت به حمله ی قارچها از حساسیت کمی برخوردار خواهند بود. برخی از بازید یومیست ها قادر به تغییر موقعیت نیتروژن در منسوجات ریسه ای رو به زوال در میسیلیومهای خودشان میباشند. آنها قادر به نفوذ و حمله کردن به چوب هستند که در نهایت باعث تولید ضایعات قهوه ای و سفید رنگ می.شوند در این ضایعات قهوه ای رنگ لیگنین به مقدار زیادی دست نخورده باقی میماند در حالی که قارچهای دیگری white-rot fungi) لیگنین و سلولز هر دو را از بین میبرند
تصویر شماره 3 میسلیومهای قارچی تخریب کننده در بافت چوب

در طول 20 سال اخیر مکانیزم تخریب لیگنین بررسی شده است و هنوز آنزیم های درگیر کم و بیش نامشخص هستند و یافته ها ممکن است در ترمیم بیولوژیکی آلودگی های زیست محیطی با مواد شیمیایی
ص: 25
فرار معطر مفید باشد لیگنینازها به دلیل تواناییشان در تخریب آلایندههایی چون منسوجات رنگ شده آفت کشها و حشره کشها بررسی شدهاند اغلب کارها توسط قارچ بازیدیومیست فانآئروکت کرایزوسپوریوم (phanaerochete chrysosporium) انجام شده است اما تحقیقات روی قارچهای دیگر نیز وجود دارد. آنزیمهای برون سلولی تجزیه کننده لیگنین ابتدا در chrysosporium) در سال 1980 کشف و شناخته شده بودند. آنها شامل لیگنین پراکسیدازها و پراکسیدازهای وابسته به منگنز میباشند و همانند محصول پراکسید هیدروژن اکسیدازها هستند. پراکسید هیدروژن برای عملکرد فاسد سازی آنزیم های لیگنین لازم است در قارچهای دیگر ممکن است لاکاز یک فنول اکسیداز شامل مس آبی رنگ موجود باشد. بدون عملکرد این آنزیمها، سیاره ی ما پوشیده از لایه ای ضخیم از عناصر گیاهان فاسد شده خواهد شد و زندگی بی معنا خواهد بود.
در گذشته مغز چوب سخت و محکم اغلب برای منظور و اهداف ساخت و ساز استفاده میشد. اخیرا با تقاضای بیشتری برای ،مواد استفاده از چوب نرم زنده (چوب که بطور ناکافی خشک و عمل ،آمده منجر به تخریب اولیه و پیش از موقع می.شود در طول فرآیند خشک کردن مواد غذایی در چوب نرم به آرامی به سطح رویه الوار بریده شده مهاجرت میکند جایی که در نهایت آنها میتوانند توسط دستگاه (ماشین) با شستن از بین بروند در این جا انواع دیگری از تهاجم قارچها به الوار وجود دارد (تصویر شماره 3 پوسته های نرم ،الوار، اشکالی از پوسیدگی سطحی هستند که اغلب در شرایط نمدار و مرطوب اتفاق میافتد عامل به وجود آمدن آنها عمدتا رشته ای از قارچهای ریز هستند با استحکام کمتر نسبت به بازیدیو مسیتها که شامل آسکو میستها همچون کتومیوم گلوبوزوم (Chaetomium globosum میباشند، ارگانیزمی که موجب پوسیدگی پرکننده های چوبی در برجهای خنک کننده ی آبی میشود انواع گوناگونی از قارچها ممکن است سبب صدمه زدن به الوار شوند یا با آزادسازی یک رنگدانه همچون Chlorociboria aeroginascens که سبب بروز لکه سبز رنگ در بلوط میشود برای چنین مقیاسی که چوب لک شده آسیب دیده به عنوان روکشی برای کارهای تزئینی معرق استفاده میشود یا با حضورهایفا تیره قارچهای سیاه درون چوب که همچون لکهای آبی رنگ هستند در نواحی معتدل توسط قارچ آسکومیستی Ceratocystis بوجود می آید دیگر قارچهایی که به عنوان عوامل تخریبی شناخته شده اند برای مثال گونه هایی از سیتالیدیوم (Scytalidium sp) و گلیو کلادیوم ویرنس (Gliocladium virens هستند. لکه دار شدن چوبها بویژه لکه های آبی ،رنگ بطور واقعی به معنای هشداری برای طول عمر چوب نیست اما باعث کاهش ارزش آن میشود قارچهای رنگی بوسیله استعمال مواد قارچ کش منتشره از طریق آب کنترل میشوند الوار چوب زنده به سرعت پس از بریدن (قطع) و ورقه های چوب و خمیر چوب میتوانند به طور نامطلوبی تحت تأثیر قارچهای تخریب کننده قرار بگیرند علاوه بر چوب و منسوجات کاغذ محصول آسیب پذیری نسبت به حمله
ص: 26
میکروبها است حمله یا تخریب ممکن است حتی پیش از شکل گیری کاغذ صورت گیرد خمیر چوب الوار توسط گروهی از بازیدیو میستها که موجب تضعیف بافت فیبرها میشود مورد حمله قرار میگیرد خمیر چوب ممکن است توسط بازیدیومیست ها و گروهی از قارچهای میکروسکپی مورد حمله قرار گیرد که در هر دو منجر به تخریب و پوسیدگی آن میشوند. فرایند ساخت کاغذ به خودی خود محیطی گرم و مرطوب فراهم می آورد که موجب بوجود آمدن لعابها یا لجنهای باکتریایی میشود و باعث بروز حساسیت در سازنده های کاغذ و بی نظمی صنعت می گردد. اعمال محدودیتها بر تخلیه کردن آب زائد که تحت عنوان آب سفید شناخته شده از کارخانههای کاغذسازی و همچنین استفاده از آب بازیافت شده میتواند منجر به افزایش خطر میکروبی شدن محتویات شود. بیوسایدها به طور منظم در کاغذها به منظور کنترل گسترش این لجن ها استفاده میشوند کاغذ ساخته شده مقدار بسیار کمی آب دارد و اصلی ترین ارگانیسمهای آسیب رساننده به آن انواع قارچها میباشند. هنگامی که کاغذ در حال تولید است برای تبدیل شدن به یک کتاب عوامل غذایی و بوم شناختی پیچیده تر میشوند یک دفتر (کتاب) حاوی مجموعه ای از مواد است؛ کاغذ نیز همچون منسوجات دارای و علاوه بر این شامل مواد مختلفی از قبیل مواد پرکننده چسبها مقوا و شاید پلاستیک یا چرم نیز میباشند همگی اینها مواد مغذی مختلفی با کیفیتهای متفاوت جذب آب دارند در هنگام استفاده از کتابها مواد دیگری همچون عرق و روغن (گریس از طریق دستهای استفاده کنندگان و نیز آلودگی محیط اطراف در هر زمانی روی آن انباشته خواهد شد. ذخیره سازی و حفاظت از کتابها کار پیچیده ای است آنها نمیتوانند به عنوان مجموعه هایی ساده از ورقه های سلولز در نظر گرفته شوند
به غیر از میکروبها تعداد زیادی میکروارگانیسمهای دیگر (حشرات، کرمهای خاکی، نرم تنان و سخت پوستان قادر به حمله به سلولز از راه های گوناگون هستند تعداد زیادی از حشرات قادرند به چوب آسیب برسانند و از آن به عنوان یک منبع تغذیه و یا به منظور پناهگاه و جایگاه تخم گذاری استفاده کنند حشرات بالغ یا لاروهای آنان میتوانند تکه های چوب را هضم کنند. به نظر میرسد که برخی از این حشرات از توانایی ترشح سلولاز به طور مستقیم درون دستگاه گوارششان برخوردارند اما برخی دیگر برای مثال موریانه ها یک رابطه همزیستی با میکروبها دارند و یا با جانوران تک سلولی یاخته ای و میکروبهای حاضر در امعاء و احشای آنها که سلولاز ترشح میکنند و حشرات را به استفاده از برخی از محصولات تخریب شده قادر میسازند. برخی از حشرات چوب را به منظور استفاده از محتویات سلول که شامل قندها و نشاسته ها هستند سوراخ و تنها از این ترکیبات استفاده می.کنند دیواره های سلولی سلولز قابل هضم نیستند. برخی ممکن است از سلولز و محتویات سلول نیز استفاده .کنند کرم چوب یا سوسک مبلمان (Anobium Punctatum در تخته سه تاییهای کهنه شده به دلیل وجود چسبهای (حیوانی نسبت به الوار جنگلی خیلی سریع تر رشد می کنند. نرمتنان و سخت پوستان در محیط دریایی
ص: 27
قادر به حفر کردن یا سوراخ کردن درون مواد سلولزی معمولا (چوب هستند و از آنها به عنوان پناهگاه تغذیه ای استفاده میکنند. مانند کرم کشتی (Teredo spp).
این حقیقت که برخی از قارچها سمی هستند به رسمیت شناخته شده است. در سال 1960 به دنبال مرگ ماکیان در انگلستان که مربوط به استفاده از بادام زمینی کپک زده به عنوان یک منبع تغذیه بود و مرگ ماهیهای قزل آلا در منطقه ای از آمریکا یک سری از تحقیقات و بررسیها آغاز شد. این تحقیقات منجر به کشف موادی تحت عنوان سموم قارچی شد که اثرات منفی زیادی بر سلامتی انسانها و حیوانات .دارند از زمانهای کهن قارچهای سمی و قارچهای چتری سمی در فرهنگ عامه مردم و در اغلب ملتها شکل گرفته .است اما مسمومیت از طریق خوردن بدنه یا ساقه قارچها و قارچهای چتری مایستیسموس یا mycetism نامیده میشود که با مایکوتوکسینها تفاوت دارد مایکوتوکسیکوز حالتی است که یک ماده غذایی توسط یک قارچ ذره بینی و سم درون آن آلوده و فاسد شده و مصرف می.شود منبع اولین سموم تعریف شده آسپرجیلوس فلاوس Aspergillus flavus بود که به نام آفلاتوکسین (aflatoxin موسوم گردید و از آن زمان سموم مشابهی پیدا شدند که توسط قارچهای دیگر تولید می.شوند برای گروههای مختلف این سموم از یک اصطلاح واحد به نام mycotoxin یا سموم قارچی استفاده می.کنند نمونههای دیگر سموم قارچی غیر از آفلاتوکسینها شامل پاتولین که) توسط انواع پنیسلیوم و آسپرجیلوس ساخته میشود اکراتوکسین (Ochratoxin نیز توسط گونههای آسپرجیلوس و پنیسیلیوم بر روی غلات تولید میشود تریکوتسنها (Trichothecenes) گروه اصلی و بزرگی از سموم قارچی که توسط انواع گونه های فوزاریوم (Fusarium) و مايكوتسيوم (Mycothecium) و استاکی بوتریس (Stachyborys موجود در غذاهای نشاسته ،دار چمن یونجه و غلات تولید میشوند زرالنون (Zearalenone) در نهایت توسط چهار نوع از فوزاریوم در غلات اغلب) (ذرت و اسپرادسمین (Sporodesmin که توسط پیتومایسس چارتاروم (Pithomyces chartarum) تولید میشود که در کاه و فضولات دامی پهن) رشد میکند و در گاو و گوسفند سبب یک بیماری تحت عنوان اگزمای (سودا) صورت تعریف شده است قارچهای تولید کننده ی سموم قارچی در سراسر جهان در خاک (زمین) و جو اتمسفر) یافت می.شوند اما توانایی اینکه عملا به صورت مصنوعی این ترکیبات را در شرایط آزمایشگاهی تولید کنیم بسیار متفاوت است شرایط مطلوب برای تولید سموم قارچی در نواحی و اماکنی که میزان رطوبت و نم در آن بسیار بالا است اتفاق میافتد غلات دانه ها و مغزها پسته و بادام و ... به میزان بیشتری حساس و آسیب پذیر هستند به لحاظ شیمیایی آفلاتوکسین ها یک گروه از متابولیت های
ص: 28
بیس فورانو ایزوکومارین هستند که توسط آسپر جیلوس فلاوس و آسپرجیلوس پارازیتیکوس تولید می.شوند. متأسفانه این سموم تحت شرایط نگهداری غذا به حالت عادی و شرایط طبخ غذا پایدار هستند بویژه هنگامی که روی نشاسته یا پروتئینهای غلات و یا غذاهای دیگر جذب میشوند. تنها فرایندی که به نظر میرسد که یک اثر ویژه و خاص ضد سمی دارد درمان با مواد قلیایی قوی میباشند، اما این مسئله در تهیه غذا متداول .نیست آفلاتوکسین ها سمیت زیادی دارند اما میزان سمی بودن آنها در بین انواع مختلف حیوانات متفاوت است. علاوه بر سمی بودن این ترکیبات نشان داده شده که با اشکال گوناگونی از سرطان مرتبط هستند آفلاتوکسین B یک کارسینوژن ماده سرطانزا مؤثر و نیرومند است یک ارتباط قوی بین میزان شیوع و دامنه سرطان کبد در انسان و مصرف غذاهای حاوی این سم بویژه در آسیای جنوب شرقی و غرب و شرق آفریقا وجود دارد افراد جوان و بیمار بیشتر در معرض خطر هستند اما در افرادی که علائم و مشکلات کبدی در آنها وجود دارد بطور ویژهای آسیب پذیرترند ممکن است یک همیاری (synergism) بین سموم قارچی و عفونت های ویروسی همانند هپاتیتهای ویروسی وجود داشته باشد در کشورهای توسعه یافته غذاهای کپک زده و فاسد شده توسط مصرف کننده ها پس فرستاده می.شود در مناطق و نواحی فقیرتر جهان عموم مردم اغلب انتخاب محدودتری در رابطه با کیفیت غذاها دارند اهمیت درجات بسیار پائین و میزان کم سموم قارچ در غذاها هنوز بخوبی اثبات نشده است مایکوتوکسین هایی که از مواد مختلف داخل ساختمانی بدست آورده اند شامل انواع زیر میباشند

(Tuomi et al. Appl. Environ. Microbiol. 2000, 66:1899-1904)
ص: 29
علاوه بر میکروبها و جوندگان حشرات گروه اصلی دیگری از ارگانیسمهایی که به محصولات انبار شده کنند هستند در سراسر جهان حشرات گوناگون زیادی وجود دارند که معمولا به مواد غذایی انبار شده حمله می.کنند همانطور که دیده خواهد شد اثرات تهاجم حشرات برحجم و مقدار زیادی غلات میتواند منجر به بروز مشکلات دیگری شود
این بید کوچک و خاکستری رنگ در انگلستان بسیار فراوان است حشره ی بالغ بین ماه های می و سپتامبر دیده میشود اما تخریب توسط لاروها انجام میشود که حدود 12 میلیمتر طول دارند و کرم رنگ هستند از غذای انباشته شده روی ترکها و شکافهای موجود در ساختار ساختمانها و بناها تغذیه می.کنند طیف گسترده و متنوعی از غذاها در معرض حمله هستند که شامل ،شکلات دانه های کاکائو غلات و محصولاتی که از غلات در آنها استفاده شده میوه های خشک شده ادویه جات دانه های ذرت و تنباکو میباشند بخشی از شفیره ها بصورت پنهان در ساختار ساختمانها هستند بنابر این هجوم آفات علی رغم میزان جایگزینی ذخایر ادامه دارد.
این نوع هم مشابه به همان بید است اما بزرگتر و تیره تر از آن میباشند لارو حشره نابالغ ( از غذایی که آنها به آن هجوم بردهاند بیرون نمی رود اما سرتاسر زمستان درون آن بصورت شفیره باقی می ماند این بید (شب پره عموما محصولات آردی یا نشاسته ای را مورد هجوم قرار میدهد مقدار زیادی از این گروه (نوع) اغلب توسط لاروها تولید میشوند و این میتواند انتقال دانهها و لوله ها و شبکه ها را مسدود کند.
بید بلغور هندی تصاویر) شماره 4 و 5 عموما در مغزها پسته و بادام ... میوه های خشک شده و غذای حیوانات خانگی یافت میشود در سالهای اخیر این نوع به عنوان آفت خانگی در خانه ها و فروشگاههای کشورهای زیادی در اروپای شمالی شامل مناطق جنوبی انگلستان شناخته شده است. در اینجا چندین گونه دیگر از بیدها در فروشگاههای محصولات در انگلستان کشف شدهاند. از جمله بید انباری استوایی
ص: 30
(cautella ) و بید آفت) برنج (Corcyracephalonica) این بیدها در مناطق آب و هوایی گرمتر بوجود میآیند و به خوبی در ساختمانهای گرم و پر حرارت عمل میکنند
تصویر شماره 4 و 5 بید بلغور هندی

این راسته سوسکهای گرد و کوچکی با یک شباهت جزئی به عنکبوتها هستند تصویر شماره 6 آنها شب پرواز و قبل از کشف و شناساییشان حمله های سنگینی را میتوانند انجام دهند آنها همه چیز خوار گوشت و گیاه خوار ) میباشند و میتوانند کیسه ها و پوششهای کاغذی و مقوا را خراب ،کنند همچنین ممکن است لانه های پرندگان فضولات حیوانات و جسد مردار) جانوران پناهگاه و مخفیگاه این حشره .باشد. نوع بالغ این حشره بالغین)، قادر به از بین بردن منسوجات هستند
تصویر شماره 6: سوسک عنکبوتی شکل استرالیایی
ص: 31
سوسک بیسکویت عمدتاً به نشاسته های خشک و یا سفت شده و محصولات نشاسته دار حمله میکند تصویر شماره 7 و 8 در صورتی که لارو آن چاله (سوراخ کوچکی حفر میکند که با آنهایی که توسط لارو کرم چوب ساخته میشوند شباهت دارد. این همان حشره ای است که سربازان قدیمی را توسط حمله اش به بیسکویت های درون کشتی،شان بشدت دچار طاعون و بیماریهای عفونی می کرد این حشره همچنین میتواند سبب آسیب و صدمه قابل ملاحظه ای به بسته های کاغذ و مقوا شود و حتی گزارش شده که باعث سوراخ شدن روکش های فلزی گردیده است. لاروهای کوچک بسیار فعال اند و میتوانند به اطراف بخزند برروی غذاهایی که روی آنها چسب نزده و باز هستند میتوانند به راحتی وارد محتویات آن شوند.
تصویر شماره 7 و 8: سوسک بیسکویت

این سوسک نیز عمدتاً در محصولات نشاسته دار و آرد یافت میشود اما همچنین میتواند به گروه دیگری از غذاها شامل میوههای خشک شده ،لوبیاها فرآورده های شکلات حمله کند تصویر شماره 9 این نوع حشره در اصل یک آفت است که در فروشگاهها و همچنین گاه به گاه در خانه ها یافت میشود این سوسک دمای حدود 25 درجه سانتیگراد را ترجیح میدهد و در دمای کمتر از 18 درجه سانتیگراد تخم آن پرورش نمی یابد.
ص: 32
تصویر شماره 9 : سوسک آرد

این راسته بی مهره گان کوچکی از خانواده عنکبوت ها و تحت عنوان «غبار زنده Living dust معروف هستند. مایت ها نیاز به رطوبت بالایی حدود 65 رطوبت نسبی و یا بیش از آن دارند و در شرایط بدون تهویه هوای آزاد و یا در اطراف غذاهایی با رطوبت بالا رشد و نمو میکنند گونه های معمولی آن شامل مایتهای آرد (Acarus siro و مایتهای آلو یا میوه های خشک شده هستند Carpoglyphus lactis). در تصویر شماره 10 و 11 منظره ی میکروسکپی مایت آرد یعنی آکاروس سیرو و در تصویر شماره 12 شکل نقاشی شده ی مایت آلو و میوههای خشک شده یعنی کارپوگلیفوس لاکتیس دیده میشود.
تصویر شماره 10 و 11 آکاروس سیرو
ص: 33
تصویر شماره 12 کارپوگلیفوس لاکتیس

این گونه ها میتوانند شرایط اگزما مانندی را در افرادی که با مواد غذایی آلوده شده در تماس هستند به نام خارش خوار و بارفروشی grocers itc) ایجاد نمایند. در شرایط مرطوب و نم دار در خانه ها، مایت خانه تصاویر شماره 13 و 14 یا مبلمان (Glycyphagus domesticus) ممکن است بر روی کپکها پیدا شود. همچنین کنه غبار (Dermatophagoides pteronyssimus) از پوسته های سطحی دست انسان تغذیه می.کند در اینجا رابطه ای احتمالی بین آلرژیها (حساسیت به غبار خانگی و گردو خاک با مایتهای خانگی و فضولات آنها وجود دارد پیشرفتهای عظیمی در چنین حساسیتهایی مانند آسم برونشیال بدنبال کار تمیز کنندگانی که با مکنده های قوی نظافت اتاقها سر و کار دارند دیده شده است.
تصویر شماره 13 و 14 مایت خانه
ص: 34
وقتی که عوامل قارچی به نشاسته و چسب کتاب حمله میکنند باعث پوسیدگی این مواد میشوند کپک پس از هضم نشاسته به نسوج سلولزی حمله کرده کاغذ را فاسد می.کند اثرات فاسد کنندگی اسید و کپک را به آسانی میتوان از یکدیگر تمیز داد. اسید کاغذ را شکننده میکند و به هنگام تا کردن کاغذ ترک خورده و میشکند ولی کاغذی که بر اثر حمله قارچها بی دوام شده باشد کماکان حالت انعطاف و نرمی خود را حفظ می.کند کپک همچنین باعث کمرنگ شدن مرکب مازو و آهن میشود و در صورتی که واکنش شیمیایی تکمیل شود نوشته ها محو میگردد و بدین صورت کتابها آسیب میبینند.
کاغذها را بر حسب مقاومتشان در برابر قارچها طبقه بندی می.کنند مقاومت کاغذ به عملیات شیمیایی بستگی دارد که در مراحل تولید کاغذ بکار رفته است. کاغذهای ماشینی تهیه شده از خمیر چوب از کاغذهای ساخت دست که ماده اصلی خمیر آنها از تکه های پارچه تشکیل شده آسیب پذیرتر است. کاغذهای آهار زده بدلیل آنکه رطوبت کمتری جذب میکنند مقاومتشان در برابر قارچها بیشتر است. کاغذهای با pH برابر 5/5 تا 6 در برابر کپکها مقاوم تر هستند کاغذهای صیقل دار شده با ماشین به دلیل نرمی تمیزی و کاهش خاصیت جذب رطوبت در مقابل کپک مقاوم هستند و در مقابل کاغذهای ضخیم تر به آسانی کونیدیها یا اسپورهای قارچی را جذب میکنند کاغذهایی که آهار ژلاتین یا نشاسته دارند برای رشد کیک مناسب می باشند. تخریبی که در کاغذ و سایر مواد مرتبط به آن از طریق عوامل بیولوژیکی پدید می آید زوال یا فساد بیولوژیکی نامیده میشود. در کتابهای مختلف بجز ،کاغذ مواد دیگری از قبیل مقوا چرم پارچه چسب یا صمغ نیز بکار رفته است که میتوانند بعنوان ماده غذایی مورد مصرف میکروارگانیسمها قرار بگیرند بعضی از کاغذها از مغز چوب و انواع دیگری از کاغذها از پنبه کتان و کاغذ باطله ساخته میشوند در هر حال تمام کاغذها دارای مواد سلولزی هستند متداول ترین عوامل زوال بیولوژیکی کاغذها شامل باکتریها حشرات و قارچ ها میباشند. از این سه دسته باکتریها دارای اهمیت کمتری هستند. قارچها یک تهدید اصلی برای اسناد کاغذی نگهداری شده و آرشیوی به حساب می آیند این دسته از قارچها استعداد زیادی در جذب مواد سلولزی دارند. لکه دار شدن کاغذ چرک یا کثیف شدن آن پوسیدگی و سست شدن کاغذ در نتیجه فعالیت این قبیل قارچها میباشند قارچهایی که بر روی کاغذ نفوذ میکنند معمولاً لکه هایی به اندازه های مختلف و اشکال نامنظم، گرد و مدور و غالباً بصورت هسته ای و به رنگهای سیاه ،قرمز ،بنفش قهوه ای ،زرد سبز و حتی گاهی بدون رنگ از خود بر جای میگذارند به لکه های رنگی ایجاد شده روی سطوح مختلف مواد طبیعی مثلا برگهای (گیاهان یا مصنوعی (مثلا تابلوهای نقاشی یا کاغذ و ... نام زنگ گیاهی mildew نیز اطلاق شده است. این تغییرات رنگی و میزان شفافیت یا تیرگی آنها به عوامل متعددی از قبیل اجزای تشکیل دهنده کاغذ میزان یا شدت اسیدیته ی آن، نوع یا گونه ی
ص: 35
قارچ مهاجم و نیز وجود همزمان میکروارگانیسمهای دیگر سن یا طول مدت رشد آنها بستگی دارد. بعنوان مثال رنگ حنایی بعلت وجود آهن در ترکیبات موجود در کاغذ و یا آلودگی با آن ایجاد میشود. معمولا رنگ حنایی در ابتدا قهوه ای زنگ زده بوده که بعدا در اثر کمرنگ شدن به رنگ حنایی درآمده است. اسیدهای آلی که در اثر مراحل مختلف سوخت و ساز متابولیسم ( قارچها دفع میشوند تحت تأثیر آهن موجود در کاغذ (که ممکن است به شکل اکسید و یا هیدروکسید آهن وجود داشته باشد ) املاح آهن را تشکیل میدهند این واکنش علت بی رنگ سازی رنگ قهوه ای زنگ زده میباشد نوع خاصی از تغییر رنگ کاغذ را اصطلاحاً فاکسینگ (foxing) یعنی ظهور لکه های کوچک روی کاغذ میگویند در روی این لکه ها معمولاً موجودات گردی، پودری یا کرکی شکلی (powdery or downy) به چشم میخورند بررسیهای آزمایشگاهی نشان داده است که گاهی نیز اجرام بی نهایت ریزی به این موجودات چسبیده.اند این لکه ها از اسپورها و رشته یاهایفای قارچها تشکیل شده اند و به آسانی در محیط اطراف خود پخش میشوند و به مجرد جابجا شدن کتابها و مواد آسیب دیده قادر به آلوده کردن کتابها و مواد سالم دیگر میباشند و به این ترتیب به آنها آسیب رسانده و نیز میتوانند سلامتی کتابداران و مطالعه کنندگان را به خطر بیاندازند بعد از حمله قارچها و باکتریها معمولاً کاغذ ظاهری نمدین به خود میگیرد و شکننده می.شود تجربه ثابت کرده است که رشد لکه ها در میان کتابها و مجلداتی که بصورت فشرده در کنار هم چیده میشوند واقعهای حتمی است قابل توجه است که بدانیم در میان انواع قارچهایی که در روی کتابها یافت میشوند حداقل 20 نوع از آنها قادر به ایجاد انواع آلرژی یا امراض قارچی مثل آسم یا گرفتگی نایژه ها سینوزیت و مشکلات پوستی در انسان میباشند تنها راه شناسایی صحیح و دقیق میکروارگانیسمهای آسیب رسان به مواد کاغذی روشهای آزمایشگاهی میکروب شناسی است که توسط میکروبیولوژیست با تجربه صورت می گیرد
استعداد قابل توجه سلولز و کلاژن موجود در ساختار کتاب برای جذب و حفظ و نگهداری رطوبت از طریق اتمسفری که دارای رطوبت نسبی بالایی است اجازه میدهد میکروبهای درون یک کتاب نمناک بخوبی رشد کنند رطوبت نسبی کتابخانه و انبارهای کتاب و کاغذ باید حتی الامکان ثابت نگاه داشته شود، رطوبت نسبی مناسب در حد %60 و درجه حرارت مناسب محیط برابر 16 درجه سانتیگراد و بطور کلی کمتر از 18 درجه سانتیگراد باید باشد اگر میزان رطوبت کتابخانه ای که درجه حرارتش 15 درجه سانتیگراد است از %57 به 63 افزایش یابد هر هزار تن کتاب میتواند در حدود 10 تن بخار آب جذب نماید برخی از میکروبها قادر هستند از رطوبتی که دراثر تجزیه سلولز آزاد میشود استفاده نمایند زیرا هنگام تجزیه
ص: 36
سلولز توسط قارچها به ازای یک گرم سلولز 0/550 گرم آب آزاد میشود ذخیره و تجمع آب بوسیله کلنی ،قارچی آن را از رطوبت هوا بی نیاز میسازد در نتیجه بعد از آنکه رشد قارچ در داخل بافت کتاب اتفاق افتاد اهمیت و نقش رطوبت موجود در محیط که برای رشد و زنده ماندن قارچ لازم است نقش ثانویه و کم اهمیت تری پیدا میکند
کاغذ یک سیستم پیچیده و بسیار جاذب الرطوبه ای است که دارای خواص موئینه ای غیر یکنواخت میباشد بر حسب نوع و روش بعمل آوردن فیبرها و الیاف موجود در کاغذ مقدار و کیفیت چسبها و مواد کامل کننده، نوع و مدل ساختن و خشک کردن چگونگی مجلد کردن کتابها و مجلات و وضعیت دما و محتوای رطوبتی کاغذ این مواد به درجات متفاوتی حساسیت یا مقاومت در برابر حمله میکروارگانیسمها از خود نشان میدهند.
قارچها برای رشد خود محیطهای اسیدی و باکتریها محیطهای خنثی و یا مختصری قلیایی را ترجیح میدهند در pH اسیدی معادل 4 و یا کمتر قارچها تنها ساکنین سلولیتیک تجزیه کننده سلولز) کاغذ و در pH معادل 6/8 الی 8 باکتریها و در pH بین 5 تا 8 اکتینومیستها بخوبی قادر به رشد و نمو در کاغذ میباشند بنابر این کاملا محتمل است که بدانیم کدام نوع میکروارگانیسم میتواند در کاغذهای قلیایی یا اسیدی بهتر رشد کرده و موجب آسیب آنها شود دما روی رشد میکروبها تأثیر بسزایی دارد، سردی هوا مطمئناً باعث کاهش سرعت رشد آنها میشود اما دمای بیش از یک حد معین نیز موجب مهار رشد آنها میگردد بویژه اگر با خشکی و بی آب شدن (دهیدراتاسیون همراه باشد از حرارت به تنهایی و یا به همراه رطوبت غالباً برای استریل کردن ابزار و ادوات جراحی و بیمارستانی استفاده میشود اما کاملاً واضح است که چنین درجات و میزانهایی از حرارت موجب تجزیه و انهدام سلولز و در نتیجه کاغذ نیز میشود رطوبت نسبی موجود در محیط برای رشد قارچها بسیار مهم است اگر چه ترکیب رطوبت نسبی و دما بسیار با اهمیت میباشد. در رطوبت نسبی کمتر از 70 درصد رشد بسیار کمی صورت میگیرد مناسب ترین شرایط برای رشد ،قارچها دمای بین 24 الی 30 درجه سانتیگراد و رطوبت نسبی بین 65 الی 80 درصد است. نور مرئی و معمولی بعنوان یک نیاز اساسی برای قارچها در نظر گرفته نمیشود نور فرابنفش برای اکثر گونه ها مضر یا مرگ آور است با این حال برخی از قارچها مقاومت زیادی به نور آفتاب نشان میدهند اکثر باکتریها در شرایط بی هوازی قادر به رشد هستند در حالیکه تقریباً تمام قارچها برای رشدشان به اکسیژن نیاز دارند هر چند که برخی از اسپورهای قارچی شرایط کم اکسیژن را برای مدتی تحمل میکنند فرح مدنی در تحقیق خود در سال 84 نشان داد که اسپور قارچهای پنیسیلیوم و آسپرجیلوس شرایط کم اکسیژنی را حداقل به مدت دو هفته تحمل میکنند در صورتی که اسپور قارچ های رایزوپوس کلادوسپوریوم و آلترناریا در این شرایط قدرت رشد خود را از دست میدهند عناصر دیگر مورد نیاز قارچها شامل ،کربن ،هیدروژن ازت گوگرد، پتاسیم و
ص: 37
منیزیم و عناصر کمیاب دیگر و برخی از ویتامینها میباشند. سلولز بسیاری از این عناصر را تامین میکند و مواد غذایی دیگر در چرمها خمیرها و چسبها یافت میشود گرد و غبار و رنگها و لکه ها نیز میتوانند مواد غذایی اضافه تری را فراهم کنند از طرفی مواد سلولزی که بوسیله تماسهای بدون پوشش دستهای انسان نیز آلوده میشود منبع عالی و مناسبی از ازت را برای قارچ ها فراهم مینماید
بعلت آنکه دامنه ی نیازهای غذایی قارچها بسیار گسترده است و با توجه به اینکه اسپورهای قارچی نیز همه جا حضور دارند بنابراین کنترل محیط امری بسیار اساسی و تعیین کننده است و در این رابطه توصیه های زیادی برای کنترل مقدار رطوبت نسبی و دمای محیط وجود دارد. عموما توصیه شده است که مواد آرشیوی و کتابخانه ای در شرایط رطوبت نسبی بین 50 الی 55 درصد و در دمای بین 16 تا 18 درجه سانتیگراد نگهداری شوند اگر تنظیم درجه حرارت و رطوبت نسبی در محدوده های مذکور میسر نباشد میتوان با برقراری جریان هوای سالم در داخل مخازن به کمک پنکه های برقی تا حد قابل ملاحظه ای از رشد قارچها جلوگیری کرد
گفته شده است که بیش از 350 گونه مختلف قارچی به کتابها و اشیای کاغذی حمله کرده و باعث فساد و تخریب آنها می گردند و از این تعداد بیش از 20 گونه از آنها میتوانند سبب بیماریهای قارچی بصورت گرفتاریهای پوستی تنفسی و آلرژیکی در انسان شوند.
برخی از باکتریهای بی هوازی مواد سلولزی را مورد مصرف قرار میدهند و مقداری از آن را به سلوبیوز تبدیل مینمایند که سرانجام به گلوکز مبدل میگردد و چون گلوکز توسط این باکتریها مصرف نمیشود در محیط جمع میگردد این نوع باکتریها از نظر تبدیل سریع سلولز به قندها و سایر فرآورده های نهایی مفید هستند. از جمله مهمترین این باکتریها باکتروییدس سلولوزولانس و کلستریدیوم تر موسلوم میباشند. باکتروپیدس سلولوزولانس یک باکتری بی هوازی مزوفیل و غیر اسپوردار است که در محیط صنعتی میتواند بعنوان تنها منبع کربن از سلولز و سلوبیوز استفاده کند این میکروب مقدار زیادی اسید استیک دی اکسید کربن هیدروژن و مقدار کمی اتانل و اسید لاکتیک بعنوان فراورده نهایی تولید میکند در ضمن موجب تجمع سلوبیوز گلوکز و گزیلوز در محیط می.گردد. در جریان رشد 14 روزه این باکتری 50 سلولزی که به محیط اضافه میشود مورد مصرف قرار میگیرد . بیش از 50 سلولز مصرفی به قند تبدیل میگردد و بقیه آن برای تولید اسید استیک دی اکسید کربن ،اتانل اسید لاکتیک و همچنین رفع نیازهای یاخته ای بکار گرفته میشود.
یوباکتری ها مایکوباکتریها استرپتومیست،ها انواع سایتوفاگا و سرانگیوم که از گروه های باکتریایی
ص: 38
میباشند روی مواد سلولزی رشد کرده و آنها را تجزیه می.کنند باسیلهایی مانند باسیلوس سرئوس باسیلوس سیرکولانس و باسیلوس سوبتیلیس و ... روی مواد سلولزی رشد میکنند
برخی از کپکهای تجزیه کننده سلولز از قبیل آسپر جیلوس و مخصوصا گونههای تریکو در ما موجب هیدرولیز سلولز و فرآورده های لیگنوسلولزی lignocellulosiques می.گردند تریکو در ما در جریان رشد مقدار فراوانی اگزوآنزیم تولید میکند که سلولز را کاملا تجزیه کرده و به گلوکز تبدیل مینماید این امر در تبدیل بقایای محصولات کشاورزی و اکتساب گلوکز اهمیت خاصی دارد. دو آنزیم آندو گلوکوناز» و «اگزو گلوکوناز» سلولز را کاملا به سلوبیوز و الیگوزیدهای کوچک تبدیل می.کند. بعد از این مرحله آنزیم سلوبیاز روی سلوبیوز و الیگوزیدها اثر کرده و در اثر تجزیه آنها گلوکز ایجاد میشود
قارچ کپکی رایزوپوس روی الیاف سلولزی رشد کرده و با تولید اسیدهای مختلف اسید سیتریک اسید اگزالیک و اسید سوکسینیک اسیدیته الیاف را بالا برده و به آن آسیب میرسانند قارچ پنیسیلیوم نیز روی الیاف سلولزی پارچه و کاغذ رشد میکند و با تولید آنزیمهایی از دسته آمیلازها و نیز با تولید اسیدهای آلی مانند اسید لاکتیک اثرات تخریبی خود را بر الیاف اعمال می.کند. قارچ کلادوسپوریوم با تأثیر بر روی نقاشیهایی که با رنگهای طبیعی رنگ آمیزی شدهاند رشد میکند و با مصرف رنگها بعنوان تغذیه لکه های قهوه ای روی تابلوها ایجاد میکنند
ص: 39
ص: 40
قارچها چگونه موجوداتی هستند؟
فعالیتهای بیولوژیکی قارچها
فاکتورهای مؤثر بر روی رشد کپکها
عوامل قارچی مخرب ،کاغذ آسیب شناسی و راه های پیشگیری و مقابله شناسایی اثرات و آسیب های قارچی در کاغذ
قارچ های کاغذ خوار

تصویر شماره 15 نگهداری متراکم کتابها در شرایط مرطوب موجب رشد سریع کپک ها و آسیب جدی به منابع کاغذی می گردد.
ص: 41
در سلسله قارچها بطور کلی دو دسته بزرگ بنام قارچهای ماکروسکوپی که اندازه) و بزرگی اندام بارور آنها که توسط آن اسپورها تولید میشوند بیش از 1 میلیمتر است و قارچهای میکروسکوپی ( یا ذره بینی که با چشمان غیر مسلح قابل رؤیت نیستند وجود دارند. قارچهای ماکروسکپی همان قارچهای کلاهکدار و گوشتی هستند که در این کتاب مورد بحث ما نمیباشند آثار قارچ های میکروسکوپی را روی سطوح مختلف اجسام یا مواد بصورت لکه های کوچک و بزرگ و نقاط رنگی به رنگهای مختلف ) به سهولت میتوان دید.
با توجه به اینکه قارچها قادر به فتوسنتز نیستند بنابر این باید مواد غذایی مورد نیاز خود را از منابع خارجی بدست آورند. قارچها مواد غذایی را از سوبستراهای مختلف هر گونه ماده ای در طبیعت که در ساختار آن ماده آلی وجود داشته باشد یا از بدن میزبان کسب می.کنند در بین قارچها سه روش عمده تغذیه ای وجود دارد که عبارتند از : ساپروتروفیسم پارازیتیسم و موتووالیسم قارچهای ساپروتروفیک مواد غذایی مورد نیاز خود را از طریق تجزیه مواد آلی مرده مربوط به اجساد و بقایای موجودات گیاهی و جانوری بدست می آورند سوبستراهای معمولی شامل ،قندها سلولز لیگنین و کراتین میباشند انواع محدودی از قارچها میتوانند از هیدروکربنها مثل نفت (چراغ رزینها یا سوبرین تغذیه نمایند. قارچهای ساپروتروفیک اساسا در رابطه با فساد وزوال مواد آلی جریان انرژی در طبیعت و چرخه غذایی بویژه در اکوسیستمهای جنگلی بسیار مهم هستند.
قارچ های پارازیت مواد غذایی خود را از ارگانیسم های زنده دیگر گیاه) یا (جانور) بدست میآورند و هیچگونه نفعی به میزبان خود نمیرسانند و حتی ممکن است باعث تخریب سلولها و بافتهای میزبان شده یا موجب مرگ آن شوند قارچهای پارازیت ممکن است بیوتروفیک (biotrophic) یا نکروتروفیک (necrotrophic باشند. قارچهای بیوتروفیک مواد غذایی را از سلولها و بافتهای زنده بدست می آورند قارچهای نکروتروفیک ابتدا به بافتهای زنده حمله کرده با کشتن سلولها یا بافتهای میزبان مواد غذایی خود را از بافتهای مرده بدست میآورند
اکثر پارازیتها پاتوژن هستند بدین معنی که باعث ایجاد علائم یا بیماری در میزبان خود میشوند. قارچهای موتوراليسم آن دسته از قارچها هستند که مواد غذایی مورد نیاز خود را از میزبان زنده بدست میآورند اما منافع کمی هم به میزبان خود میرسانند. دو نوع مهم از موتووالیسم میکوریزا mycorrhiza) و میکوفیلا mycophylla می.باشند میکوریزا یک نوع زندگی همزیستی بین قارچ بعضی از (قارچها و ریشه گیاه بعضی از گیاهان و میکوفیلا نوعی همزیستی بین بعضی از قارچها داخل بدن گیاه با بخشهای هوایی گیاه میباشند بعضی از قارچها فقط به یک میزبان از یک جنس یا گونه و برخی دیگر به میزبانهای مختلفی حمله
ص: 42
می.کنند برخی دیگر از قارچها به قسمتهای مرده گیاهان یا جانوران و برخی به قسمتهای زنده بعضی به حشرات برخی به قارچهای دیگر و بالاخره برخی نیز روی محصولات مصنوعی مانند پارچه ،قالیچه چرم و انواع اشیای موزه ای و مواد ساختمانی رشد و تکثیر می یابند
قارچ ها از نظر تشکیلات ساختمانی و عملکرد زیستی نیز تنوع بسیار زیادی دارند. اختلافات بین آنها به وسعت اختلافات موجود بین جانداران مهره دار با جانداران بدون مهره است. قسمت رویشی قارچ که شامل یک توده میکروسکوپی و رشته ای یا نخی شکل است میسلیوم نامیده می.شود میسلیوم قارچ به داخل و یا بر روی سطوح سوبسترا ماده ای که قارچ از آن تغذیه میکند یا میزبان موجود زنده دیگری که قارچ بصورت انگلی از آن تغذیه میکند گسترده میشود. بعضی از قارچها میسلیوم تشکیل نمی دهند و بصورت دسته ای از سلول ها یا به شکل سلولهای مخمری وجود دارند اسپورها که واحدهای تکثیری یا تولید مثلی قارچها هستند یا مستقیما بوسیله میسلیوم تولید میشوند و یا توسط دستگاههای اختصاصی بنام اجسام بارور که اینها بوسیله یک نوع ،میسلیوم تخصص عمل یافته ایجاد شدهاند تولید میگردند تولید مثل در قارچها هم به طریق جنسی و هم غیر جنسی میباشند از طرف دیگر هر گونه (spices) قارچ میتواند در شرایط زمانی مختلف و یا در سوبستراهای متفاوت بیش از یک نوع اسپور ایجاد نماید.
تخمین زده میشود که حدود 1/5 میلیون گونه قارچی وجود دارد Hawksworth و بنابراین قارچها دومین گروه بزرگ موجودات بعد از حشرات ) میباشند
قارچها و باکتریها باعث تجزیه لاشه موجودات عالی گیاهان و جانوران و پاکسازی محیط زیست از مواد آلوده کننده میشوند و از این جهت به این عوامل رفتگران یا سپوران طبیعی Scavenger) میگویند. یوباکتریها و مایکوباکتریها استرپتومیست ها و انواع سایتوفاگا سرانگیوم که از گروه های باکتریها میباشند روی مواد سلولزی رشد کرده و آنها را تجزیه میکنند باسیلهایی مانند باسیلوس سرئوس، باسیلوس سیرکولانس و باسیلوس سوبتیلیس و ... روی مواد سلولزی رشد میکنند
ترکیبات فعال بیولوژیکی مانند مواد ضد باکتری (سفالوسپورین، فومیگاتین، پنی سیلین مواد ضد قارچی گریزئوفولوین dendrochine, sparassol) مواد ضد پروتوزوا (antiamoebin)، ضدویروسی (statolon)، ضد گیاه یا فیتوتوکسیک (patulin) و ضد تومور (poricin calvacin و محصولات دیگری که دارای کاربردهای پزشکی میباشند مانند سیکلوسپورین که برای جلوگیری از پس زدن بافت های پیوندی بکار میرود و ارگوتامین برای درمان میگرن و نیز بعنوان دارویی که در زنان و زایمان بکار میرود را از قارچها بدست
ص: 43
می.آورند در تولید صنعتی آنزیمها ویتامینها اسیدهای آمینه و مواد شیمیایی و بیوشیمیایی دیگر نیز از قارچها استفاده میکنند در بیوتکنولوژی از قارچها بعنوان منبع ژنی و بعنوان ارگانیسمهای نشانگر استفاده می.شود وجود میکوریزا در خاک باعث سلامت و حاصل خیزی خاک و باروری درختان می.شود تجزیه مواد آلوده کننده در طبیعت توسط قارچها صورت میگیرد مانند تجزیه هیدروکربنهای ،نفتی آفت کشها و حلالهای کلردار(Groundwater Technology 1992). بعضی از قارچها عناصر فلزی را در خود جمع میکنند و بعنوان بازیابندههای فلزات از ضایعات آلوده بکار میروند.(Gadd 1993).
قارچ ها دارای سیستمهای آنزیمی متغیر و گاهی کاملا اختصاصی هستند و در طبیعت نقش مهمی در تجزیه مواد سلولزی و کیتینی و سایر ترکیبات آلی دارند. نتیجه این فعالیتها برگشت مواد و عناصر اولیه متشکله این ترکیبات به خاک و ادامه چرخه زیستی در طبیعت است. این خاصیت موجب فساد گرمسیری در اشیای ،چوبی فیبری پنبه ای و تأسیسات الکتریکی و سایر کالاهای تجارتی میشود و باعث زیانهای فراوانی بویژه در مناطق گرم و مرطوب میگردد این پدیده را تجزیه زیستی (biodegradation or biodeterioration) مینامند
بالاترین درصد خسارات وارده به کتابها توسط قارچهای جنس آسپرجیلوس (حدود 30 درصد و پنیسیلیوم بیش از 30 درصد اتفاق میافتد اسپورهای این قارچها در همه جا و در شرایط دمایی و رطوبتی مختلف حضور دارند.
برای سهولت در مطالعه قارچها برای نامگذاری آنها همانند سایر موجودات از روش نامگذاری دو اسمی (binomial) استفاده می.کنند بدین صورت که اسم جنس را با حرف بزرگ شروع کرده ولی برای اسم گونه از حروف کوچک استفاده می.کنند
هر جنس (Genus) قارچی از تعدادی گونه (species) تشکیل میشود جنسهای متعددی درون یک فامیل یا خانواده (Family) و تعدادی خانواده درون یک راسته (Order) و تعدادی راسته نیز درون یک رده (Class) تعدادی رده نیز درون یک شاخه (Division) و بالاخره یک یا چند شاخه درون یکی از سلسله های موجودات
(Kingdom) قرار میگیرند
عوامل متعددی بر روی رشد کپکها دخالت دارند که عبارتند از میزان رطوبت نسبی محیط میزان آب یا رطوبت موجود در مادۀ مورد نظر ،دما میزان و نحوۀ جریان هوا و ترکیب شیمیایی سوبستراها
ص: 44
مهمترین فاکتور محیطی که باید تحت کنترل قرار گیرد عبارت است از مقدار رطوبت موجود در هوا ونیز در کتابها و کاغذ کتاب و کاغذ بطور طبیعی حاوی مقدار معینی آب میباشند این مواد جاذب الرطوبه هستند بنابراین موقعی که رطوبت نسبی محیط بالا میرود آنها آب را برای رسیدن به وضعیت تعادلی جذب می.کنند در رطوبت نسبی %50 محتوای رطوبتی (آب) موجود در کاغذ تقریباً 7 است و در رطوبت نسبی 70 این مقدار به حدود 10 می رسد ،رطوبت کپکها را قادر میسازد که مواد غذایی را از سوبسترای کاغذی (کتاب) جذب کنند. هر چقدر که رطوبت موجود در کاغذ بیشتر باشد شانس بیشتری برای اسپورهای قارچی برای رویش و در نتیجه جذب بیشتر مواد غذایی وجود دارد. رطوبت نسبی بالای 70 براحتی باعث رشد کپک میشود. برای اطمینان و ایمنی رطوبت نسبی در آرشیوها و کتابخانه ها باید کمتر از 65 باشد رطوبت نسبی کمتر از 40 باعث میشود که کتاب و کاغذ شکننده شود بنابر این میزان قابل قبول بین 45 تا 55 میباشد برخی از کپکها در رطوبت نسبی 70 یا بالاتر شروع به رویش کرده و سپس به رشد خود در رطوبت کمتر از 70 ادامه میدهند بنابر این مواد جدید باید از نظر کیک کنترل و رفع آلودگی گردند و سپس میتوان آنها را در کنار بقیه کلکسیون قرار داد. ثبات و استحکام کاغذ در دامنهٔ رطوبت %45 الی 55 نیز مهم است. کتاب و کاغذ با جذب یا آزاد کردن آب به اتمسفر متناسب با تغییرات رطوبت نسبی ،محیط شکل خود را نیز تغییر میدهند به این صورت که دچار انبساط و انقباض میگردند و قسمتهای مختلف کتاب به میزانهای متفاوتی این تغییرات را نشان میدهند مثلاً جلد پوستی کتاب پوست حیوان نسبت به کاغذ داخل آن در اثر جذب آب سریعتر منبسط میشود و چسبی که در صحافی آن بکار رفته ممکن است بطور متوسطی دچار این تغییر حالت گردد تغییرات افت و خیز در رطوبت بصورت اجتناب ناپذیر بعلت تغییرات فصلی باید آهسته .باشد. عموما توصیه میشود که رطوبت نسبی به میزان 50٪ با تغییرات حداکثری 5 افزایش یا کاهش در طول ماه تنظیم و نگاه داشته شود.
بسیاری از کپکها در دمای گرمتر خوب رشد می.کنند در ترکیب با سطوح بالاتری از رطوبت نسبی دمای 21 تا 24 درجه سانتیگراد باعث رشد و گسترش کپک ها می.شود دمای زیر انجماد باعث کشتن کیک نمیگردد بلکه سبب خفته شدن یا بحالت کمون رفتن آن می.شود تعداد کمی از کپکها در دمای پایین تر از 10 درجهٔ سانتیگراد فعال هستند. کپکها میتوانند در دمای تا 60 درجه سانتیگراد رشد کنند دمای بسیار بالا باعث کشتن کپکها میشود اما میتواند باعث صدمه شدید به مواد آرشیوی و کتابخانه ای گردد. دمای 21 درجه سانتیگراد با 2 درجه افزایش یا کاهش برای کتابخانه ها قابل قبول است رطوبت نسبی نیز در 50 نگهداری شود
ص: 45
در ارتباط با کنترل دما و رطوبت جریان هوا به جلوگیری از رشد کپکها کمک می.کند اکثر این قارچها علاوه بر تغییر رنگ کاغذ باعث پوسیدگی و فساد در آن نیز میشوند. نکته قابل توجه این است که راه پیشگیری از ایجاد ضایعات و آسیبهای قارچی در کتابها تقریباً یکی است در حالیکه در صورت بروز آسیب بر روی کاغذ و منابع آرشیوی و کتابخانه ای بسته به نوع یا گونه قارچی مورد نظر راه و روش مبارزه و ضدعفونی متفاوت میباشند و نتیجه آنکه شناسایی دقیق انواع میکروارگانیسم های مسبب فساد و آسیب برای دفع و رفع مؤثر آن الزامی است.
پایداری و استحکام کاغذ را با آزمایشهای مختلفی میتوان تعیین کرد از جمله آزمایشهایی که بسیار متداول است آزمایش فرسودگی زودرس میباشد که عبارت است از قرار دادن کاغذ در حرارت صد درجه سانتی گراد برای مدت سه شبانه روز (72) ساعت آزمایش دیگر عبارت است از قرار دادن کاغذ در ماشین مخصوصی که میتواند بصورت متناوب کاغذ را تا کرده و باز نماید و ضمناً شماره دفعات تا شدن را تا ظهور شکاف در محل تا خوردن مشخص کند. البته غیر از آزمایشهای مزبور که اهمیت فوق العاده ای دارند آزمایشهای دیگری نیز به وسیله ماشین های خودکار مخصوصی انجام میگیرد که دقت آزمایشهای بالا را ندارند آزمایش های فوق ثابت میکنند که دوام انواع کاغذ بستگی زیادی به خاصیت اسیدی کاغذ دارد راه های نفوذ اسید بر کاغذ و مراحل تخریبی آن قبلا مورد بحث قرار گرفته است بنابر این لازم است یادآوری شود که اگر اسید موجود در کاغذ تخریب بافتها را آغاز کرده باشد راهی برای مبارزه با آن وجود ندارد.
کلیه اشیا و اسنادی که در ساختار آنها ماده آلی بکار رفته است در معرض تباهی و فساد هستند. عوامل مختلف زیستی (بیولوژیک ،شیمیایی ،فیزیکی انسانی و حوادث طبیعی سبب فساد و پوسیدگی اسناد میشوند. بطور خلاصه از هر کدام از این عوامل میتوان مثالهایی را ذکر :کرد عوامل انسانی شامل استفاده غیر صحیح عدم کاربرد شیوه های صحیح نگهداری به) تصاویر شماره 1 و 15 توجه کنید تعمیر و مرمت ،غلط سرقت آتش سوزی جنگ و آشفتگیهای دیگر می.باشند عوامل طبیعی عبارتند از سیل، زلزله و حوادث احتمالی دیگر و از عوامل شیمیایی میتوان ضایعات ،فتوشیمیایی میزان و مقدار اسیدی بودن کاغذ یا اسناد ،دیگر و ضایعات ناشی از اکسیده شدن مواد و آلودگی هوای اطراف را نام برد از عوامل فیزیکی میتوان ضایعات ناشی از تأثیر گذاری ،نور حرارت و رطوبت را مثال زد عوامل بیولوژیک مخرب اسناد و اشیای فرهنگی شامل برخی از پستانداران ،جونده حشرات باکتریها و عمدتا قارچ ها میباشند به عوامل مخرب فوق یک عامل دیگر را نیز
ص: 46
باید اضافه کرد و آن عبارت است از جنس و ترکیبات نامرغوب و نامناسبی که در فرایند ساخت کاغذ و سایر مواد متشکله کتاب بکار میرود این عامل را ممکن است بعنوان عامل ذاتی یا سرشتی آن سند نام برد و یا شاید آن را بتوان در دسته عوامل انسانی قرار داد به هر حال همانطور که در ابتدای بحث ذکر شد ساختار و ساختمان و به عبارت دیگر ترکیبات متشکله یک نمونه خاص از کاغذ میتواند بر نوع تخریبی که در آن اتفاق خواهد افتاد (بالاخص انواع فساد بیولوژیکی تأثیر جدی بگذارد.
در کاغذ میکروارگانیسم ها نه تنها به سلولز بلکه به مواد دیگری مانند ،لیگنین همی سلولزها ،پکتین،ها مومها تانن،ها پروتئینها و ترکیبات معدنی حمله می.کنند علاوه بر این کاغذ ممکن است شامل مواد ،رزینی پرکننده ها و مواد رنگی باشد که در چرخه تولید آن افزوده شده است و یا در هنگام نگهداری و استفاده
آلودگیهای مختلف بعنوان مثال آلوده شدن با مواد آلی با منشاء (انسانی نیز به آن اضافه شده باشد.
میکروارگانیسم ها در مراحل مختلف ساخت و تولید کاغذ آن را تحت تأثیر قرار می دهند، از زمانی که درخت در جنگل قطع میشود و یا پنبه و محصولات طبیعی دیگر برداشت میشود تا محصول نهایی آماده استفاده می گردد. باکتریها عمدتا در خمیر کاغذ وجود دارند زیرا رشد آنها به رطوبت بالایی نیاز دارد بعبارت دیگر در کاغذ آماده شده معمولاً قارچ ها و اکتینومیست ها دیده می شوند اینها به رطوبت کمتری نیاز دارند و رطوبت نسبی 100% تأثیر منفی بر رشد برخی از آنها دارد برخی از قارچهای شایع و آلوده کننده در رطوبت نسبی 70٪ یا پائین تر 63) تا 65٪ قادر به رویش میباشند این ارگانیسمها روی کاغذر شد کرده مواد نابجا و اضافه شده به کاغذ را مصرف کرده و سوبسترای مواد غذایی مناسب برای میکروارگانیسمهای تجزیه کننده سلولز (سلولیتیک تهیه میکنند بسته به ترکیب شیمیایی ،کاغذ ،اسیدیته میزان رطوبت آن و رطوبت نسبی محیط دما و نور موجود بوسیله میکروارگانیسمهای مختلفی مورد حمله و تخریب قرار میگیرد کاغذهایی که مقدار اسیدیته آنها بین الی 6 است نسبت به کاغذهای با pH برابر با سرعت بیشتری توسط میکروارگانیسمها آسیب می بینند در میان باکتری ها انواع مختلفی از اکتینومیستها، استرپتومایسس اسید و ترموس سلولوموناس، سل،ویبریو سودوموناس باکتروئیدها کلستریدیومها، رومینوکوکوس باکتریهای بی هوازی سلولیتیک میکروبیسپورا تر مومنوسپورا اور باسیلوسها دارای آنزیم سلولز بوده و بنابراین توان آسیب رساندن به آثار سلولزی را دارند. در این مختصر فقط تعدادی از باسیلوس هایی که واجد سیستمهای آنزیمی سلولزی میباشند بعنوان نمونه ذکر گردیده اند. باسیلوس ها دسته ای از باکتریها هستند که بعنوان تجزیه کنندگان ملکولهای پلیمری شناخته شده اند. در این جنس تعداد زیادی باسیلهای درشت گرم مثبت و اسپوردار وجود دارد که در طبیعت فراوانند زیرا اسپور آنها در
ص: 47
برابر عوامل خارجی مقاومت زیادی دارد. تنها گونه بیماریزا از باسیلوسها برای انسان باسیلوس آنتراسیس است که عامل بیماری سیاه زخم میباشند و باسیلوس سرئوس نیز ایجاد مسمومیت غذایی می نماید. باسیلوسها دارای فعالیتهای پروتئولیتیکی تجزیه کننده پروتئین و آمیلولیتیکی تجزیه کننده نشاسته میباشند و برخی از آنها نیز فعالیتهای سلولیتیکی از خود نشان میدهند. همه استرینهای باسیلوس استئار و ترموفیلوس و 85 درصد از استرینهای باسیلوس کوآگولانس و 50 درصد از استرینهای باسیلوس لیکنیفورمیس آنزیمهای سلولاز مقاوم به حرارت تولید میکنند باسیلوس استئاروترموفیلوس در خاک و گرد و غبار وجود دارد و دمای 65 درجه سانتیگراد را تحمل میکند. باسیلوس کوآگولانس نیازهای تغذیه ای متنوعی داشته و در شرایط دمایی مختلف رشد میک باسیلوس لیکنیفورمیس دارای کلنی هایی با سطح خشن و کدر پهن برجسته و موئی شکل و دارای لعاب فراوانی در سطح خود میباشند و بطور محکمی به سطح آگار غذایی می چسبد در محیط های کشت کربوهیدراتی که حاوی آهن کافی باشد به رنگ قرمز و در کشتهای کهنه به رنگ قهوه ای دیده میشوند.
از خانواده اکتینومیستاسه ارگانیسمهای کاغذ دوست زیادی» جدا شده است. این باکتری ها در کاغذ رنگهای بسیار متنوعی از قبیل صورتی ،زرد، سفید، خاکستری و سیاه ایجاد میکنند و برحسب pH و منبع ازت در دسترس آنها قدرت سلولیتیکی بالایی نشان میدهند
در میان قارچ ها جنسها و گونه های فراوانی بعنوان قارچهای تجزیه کننده سلولز و بعبارتی قارچهای کاغذ خوار» مطرح میباشند که در اینجا با تعدادی از آنها و نوع آسیبهای وارده در کاغذ اشاره میگردد. در بخشهای بعدی این کتاب خصوصیات بیولوژیکی و ریخت شناسی مرفولوژیکی آنها بطور مفصل مورد بحث قرار خواهد گرفت
از میان قارچ هایی که به کاغذ حمله میکنند حدود 20 نوع مربوط به زیگومیست ها 60 نوع مربوط به آسکومیستها 230 نوع مربوط به دو ترومیستها و 10 نوع مربوط به بازیدیومیستها میباشند. حداکثر فساد و تخریب توسط آسکومیستها بویژه گونههای کتومیوم (Chaetomium و میکسوتریکوم (Myxotrichum) انجام می گیرد
جنس کتومیوم ( Chaetomium کاغذهای با کیفیت ضعیف را تجزیه می.کند
گونه های پستالوتیا (Pestalotia) در روی کاغذ لکه های قرمز روشن با نقطه سیاه در مرکز ایجاد میکند
فوما هو ميكولا (Phomahumicula) روی کاغذ لکه های خاکستری مایل به قهوه ای یا سیاه رنگ ایجاد می.کند
کتوملا هوریدا Chaetomella horrida) لکه های خاکستری - قهوه ای ایجاد میکند سفالوسپوریوم (Cephalosporium بسته به میزان اسیدیته (pH) کاغذ باعث تغییر رنگ آن از نارنجی قرمز می شود.
سلولز موجود در کاغذ بوسیله تریکودرما (Trichoderma viride) در مدت 20 روز تا میزان 40 تجزیه
ص: 48
میشود این قارچ روی ،کاغذ کلنیهای سبز تیره تولید میکند و آن را به رنگ سبز روشن در می آورد.
بیش از 12 گونه از جنس آسپرجیلوس از کاغذ جدا شده است آسپر جیلوس فومیگاتوس سهم مهمی در فساد کاغذ دارد. استرینهای فعال در ابتدا رنگ خاکستری، سپس سبز و بالاخره قهوه ای در کاغذ ایجاد میکنند
آسپرجیلوس ونتی (Aspergillus wenti) با کندی زیاد کاغذ را نابود میکند و آن را به رنگ قرمز روشن در می آورد.
آسپرجیلوس نیجر (Aspergillus niger) غالبا در کاغذ ظاهر میشود و در حضور گلوکز سبب کاهش قابل ملاحظه مقاومت ماده سلولزی میشود کلنیهای این قارچ روی کاغذ کوچک و به رنگ سیاه میباشند
کاغذهای کهنه و قدیمی محیط مناسب و رضایت بخشی برای پنیسیلیومها و آسپرجیلوسها نیستند اما این دسته از قارچها که برای رشد خود فقط به 7 الی 9 درصد رطوبت داخل کاغذ نیاز دارند کاغذ را مرطوب کرده و از این طریق باعث آلودگی و رشد قارچهای با فعالیت سلولیتیک بیشتر میشوند
پسیلومایسس واریوتی Paecilomyces varioti) به کاغذ صدمه میزند و کلنیهای آن به رنگ زرد با سایه های قهوه ای روشن میباشند
اسکوپولاریوپسیس برویکالیس (Scopulariopsis brevicalis) نیز مانند پسیلومایسس باعث صدمه رساندن به کاغذ شده و از یون آمونیم موجود در آن بعنوان منبع ازت استفاده میکند
بوتریوتریکوم آترو گریزئوم (Botryotrichum atrogriseum) به کاغذ صدمات شدیدی وارد میکند و باعث ایجاد لکه هایی به رنگ خاکستری میشود
سپدونیوم (Sepedonium) بندرت در کاغذ دیده میشود و در صورت موجود بودن لکه هایی به رنگ سفید خاکستری ایجاد مینماید
بوتریتیس سینرا (Botrytis cinerea) بصورت کلنیهای ظریف و تا 2 میلیمتر بالاتر از سطح کاغذ رشد میکند و تشکیل اسکلروشیا (sclerotium) به قطر چند میلیمتر میدهد بهترین منبع ازت برای این قارچ سولفات آمونیم در شرایط pH برابر 8 میباشند اما رشد قارچ در شرایط pH برابر 3 نیز اتفاق می افتد. بجز سولفات آمونیم، نمکهای از ته دیگر مانند نیترات آمونیم، نیترات سدیم فسفات آمونیم پپتون و آسپاراژین نیز مورد استفاده قرار میگیرند. بعنوان منبع کربن در غلظتهای بالاتر از 5 تا 1 ساکارز مالتوز ،مانوز گلوکز گالاکتوز، گزیلوز و گلیسرول استفاده میشود.
آکر واستالاگموس سینابارینوس (Acrostalagmus cinnabarinus) باعث ایجاد نواحی شبیه زنگ زدگی روی کاغذ میشود
اید املا اسپینوزا (Eidamella spinosa) لکه های بزرگ تاج خروسی شکل ایجاد کرده و بشدت به سلولز آسیب می رساند.
از خانواده دیماتیاسه قارچهای سیاه یا فئوهیفومیست ها قارچ Mycogone nigra اثر تجزیه کنندگی شدیدی روی سلولز دارد و روی کاغذ لکه های سبز کدر ایجاد می.کند این قارچ در دامنه وسیع دمایی از 5 تا 30 درجه
ص: 49
سانتیگراد رشد میکند و البته دمای مطلوب برای رشد آن 20 تا 25 درجه سانتیگراد است.
تورولا (Torula) در کاغذ لکه های سیاه ایجاد می.کند
استاکی بوتریتیس آترا (Stachybotrya atra) باعث ایجاد رنگ سیاه یا سبز متمایل به سیاه با لبه های سبز مایل به خاکستری یا قهوه ای میشود
گلیوماستیکس کونوولته (Gliomastix convolute قدرت تجزیه کنندگی زیادی داشته و در کاغذ رنگ سیاه بر جای میگذارد
گلیوکلادیوم روزئوم (Gliocladium roseum) سبب رنگ قرمز در کاغذ میشود تریکو کلادیوم (Trichocladium با صدمه شدید به کاغذ آن را به رنگ سبز مایل به زرد یا قهوه ای زنگ زده بسته به استرین سویه قارچ و pH کاغذ در می آورد کلادوسپوریوم هر باروم (Cladosporium herbarum) روی کاغذهای مختلف دیده میشود و در دمای بالا و پائین و نیز در pH مختلف و حتی در حضور غلظتهای بالایی از مواد قارچ کش رشد میکند
هلمنتوسپوریوم (Helminthosporium روی کاغذهای بازیافت شده بسیار بهتر رشد کرده و در کاغذ ایجاد لکه های خاکستری مایل به سفید مینماید.
کوروولاريا لوناتا (Curvularia lunata) روی کاغذ لکه های سیاه ایجاد کرده که این لکه ها سریعاً گسترش یافته و بزرگتر میشوند این گونه نیز از قارچهایی است که فعالیت سلولیتیکی زیادی دارد و بهترین منبع ازت برای رشد آن فسفات آمونیم است.
تریکوتشیوم روزئوم (Trichotecium roseum باعث ایجاد کلنیهای کرکی و پف کرده روی کاغذ میشود این کلنیها ابتدا سفید رنگ بوده سپس به رنگ قرمز کمرنگ در می آیند بهترین منبع ازت برای این قارچ نیز فسفات آمونیم است
آکروتشیوم (Acrothecium) فعالیت سلولیتیک بالایی دارد و در کاغذ رنگ سبز زیتونی ایجاد میکند
اوره بهترین منبع ازت برای این قارچ است جنس آلترناریا و جنس استمفیلیوم در انواع مختلف کاغذ آسیبهای شدید ایجاد مینمایند و لکه های سیاه قهوه ای متمایل به سیاه و قهوه ای متمایل به سبز تولید میکند اپیکوکوم نیگروم (Epicoccum nigrum) لکه های سیاه ایجاد میکند و بهترین منبع ازت برای آن فسفات آمونیم ( در pH برابر ( میباشند
بسیاری از گونه های فوزاریوم از کاغذ جدا شدهاند این گونه ها سبب ایجاد رنگ بنفش آبی صورتی مایل به بنفش و رنگهای صورتی زرد میشوند
از خانواده اکتینومیستاسه ارگانیسمهای کاغذ دوست زیادی جدا شده است این باکتریها در کاغذ رنگهای بسیار متنوعی از قبیل ،صورتی ،زرد ،سفید خاکستری و سیاه ایجاد میکنند و برحسب pH و منبع
ص: 50
ازت در دسترس آنها قدرت سلولیتیکی بالایی نشان میدهند
در شرایط رطوبت نسبی بالا 80 تا 90 درصد و همچنین رطوبت بالای درون کاغذ تعدادی از باکتریها از قبیل سل فاسیکولا سل ویبریو و سایتوفاگا جدا شدهاند این باکتریها در کاغذ تغییر رنگ شدید ایجاد می کنند.
استاکی بوتریس ،کتومیوم کلادوسپوریوم آلترناریا استمفیلیوم تریکودرما، آسپر جیلوس فومیگاتوس بوتریوتریکوم، آیداملا سپینوزا، سپدونیوم مایکوگون، پنیسیلیوم، سفالوسپوریوم
بوتریتیس، تورولا، تریکوکلادیوم و پلیکولاریا بندرت دیده شدهاند و قارچهای زیر بصورت محدودتری مشاهده گردیده اند:
تریکوتشیوم ،کوروولاریا ،اپیکوکوم اسکوپولاریوپسیس پستالوشیا آسپر جیلوس نیجر، پسیلومایسس سویه های کمی از جنس فوزاریوم گلیوماستیکس و آکروتشیوم
ص: 51
ص: 52
عوامل مساعد کننده رشد و تکثیر عوامل قارچی در کتابخانه
چگونگی جلوگیری از ایجاد آسیبهای بیولوژیک توسط میکروارگانیسم ها در کاغذ راه های ورود قارچها به داخل ساختمان
اقدامات پیشگیرانه در ارتباط با محل احداث کتابخانه و آرشیو رفع آلودگی قارچی از کتابها و اسناد آلوده
روشهای مختلف ضد عفونی آثار آلوده و آسیب دیده
راه های مبارزه با اثر ،رطوبت موجودات ذره ،بینی تخمیر و تغییر رنگ
تصویر شماره 16 آثار کپک زدگی

ص: 53
قارچها و باکتریها در طبیعت باعث تجزیه لاشه موجودات عالی گیاهان و جانوران و بازگشت مواد اولیه به خاک جهت استفاده مجدد بوسیله گیاهان چرخه حیات در طبیعت و نیز پاکسازی محیط زیست از مواد آلوده کننده - از جمله مواد مصنوعی ساخته دست انسان میشوند و از این جهت به این عوامل رفتگران یا سپوران طبیعی میگویند
در صنعت از قارچها برای تولید آنتی بیوتیکها اسیدهای ،آلی ،استروئیدها آشامیدنی های الکلی و محصولات دیگر استفاده می.کنند عمل ورآمدن خمیرنان و تهیه انواع پنیر جز با کمک قارچها میسر نیست. قارچها به عنوان مدل های علمی برای مطالعات ژنتیکی فرآیندهای بیوشیمیایی و ارتباطات بین میزبان و انگل مورد استفاده قرار میگیرند اسپور قارچها در همه جا وجود دارند اما در اتمسفر گرم و مرطوب و در جایی که تهویه ضعیف است به خوبی رشد میکنند قارچها از نظر اکولوژیکی بینهایت تطابق پذیر میباشند دامنه ی دما برای رشد مطلوب و تکثیر قارچها متفاوت و متغیر است خیلی از گونه ها مقاومت و تحمل زیادی نشان میدهند و قادرند در دمای انجماد یا زیر انجماد در مدت زمان طولانی زنده بمانند، برخی نیز ممکن است دمای 100 درجه سانتیگراد را حتی تا 25 سال تحمل کنند.
از منظر نیازمندیهای تغذیه ای قارچها بدلیل مجهز بودن به سیستمهای آنزیمی قوی و متنوع قادر هستند که انواع مواد و اشیایی را که در ساختمان آنها آثاری از مواد آلی وجود داشته باشد مورد حمله قرار دهند و به خاطر همین ویژگی است که میتوانند به اشیای کتابخانه ای و موزه ای حمله کرده و آنها را تخریب نمایند. از واژه میکروارگانیسم (میکروب برای توصیف ،کپک ها اکتینومیستها و مخمرهایی که میتوانند روی مواد تشکیل دهنده کتابها و اسناد رشد و زندگی کرده و باعث تغییر شکل و یا نابودی آنها شوند، استفاده میشود میکروبهایی که روی اسناد و کتابها اثرات بد و زیان آوری برجای میگذارند در نوع احتیاجات و نیازمندیهای تغذیه ای ،خود مقدار رطوبت و دمای مناسب رشد و میزان اسیدی یا قلیایی بودن محیط کشت اختلافات گسترده ای با یکدیگر دارند از بین عوامل میکروبیولوژیکی فوق قارچها عمده ترین و مهمترین تهدید برای مواد و اشیای آرشیوی و کتابخانه ای هستند
وجود گرد و غبار بدلیل آنکه اسپورهای قارچ نیز ممکن است در آن موجود باشند و از طرف دیگر حاوی موادی است که برای برخی قارچها جنبه غذایی ،دارد تهویه کم و نامناسب که سبب راسب شدن و تراکم اسپورهای معلق در هوا میشود نور کم با توجه به اینکه اکثر میکروارگانیسمها نسبت به اشعه فرابنفش موجود در نور خورشید حساس میباشند دمای بالا و نیز رطوبت نسبی بالا که شرایط را برای رشد و تکثیر
ص: 54
اغلب میکروارگانیسم ها تسهیل مینماید استفاده از مواد نامناسب در ساخت و مرمت کتابها که خود ممکن است به اسپورهای قارچی آلوده باشند و یا اینکه محیط و بستر مناسبی برای رشد و تکثیر آنها مهیا نمایند و بالاخره اینکه رشد قارچها در کتابها و اسنادی که بصورت فشرده در کنار هم قرار داده میشوند (تصویر شماره 1 و 15) امری معمول و حتمی است اما کتابها و اسنادی که در قفسه ها با فواصل لازم و مناسب چیده میشوند معمولاً خیلی کمتر مورد حمله قارچها قرار میگیرند

تصویر شماره 17 آثار کپک در حاشیه ها نسخه ای که مربوط به قرن 15 است کتابخانه بوداپست
اگر کتابها و یا اسناد در شرایطی قرار گیرند که از نظر دما و رطوبت نسبی محیط ( آنطور که قبلا گفته شد و نیز تهویه یا هوادهی بطور دائم تحت کنترل و نظارت باشند آلودگی میکروبی و قارچی در آنها واقع نخواهد شد البته برای حصول اطمینان بهتر است از سکون و عدم گردش کتابهایی که معمولا به آنها مراجعه نمیشود جلوگیری ،کرد هر چند وقت یکبار وضعیت آلودگی هوای مخزن یا فضای کتابخانه یا آرشیو با کمک میکروبیولوژیست از نظر وجود اسپورهای قارچی مورد آزمایش و ارزیابی قرار گیرد. قفسه ها و کلیه سطوح بصورت دوره ای با مواد ضد عفونی کننده ملایمی تمیز و ضدعفونی شوند
قارچها براحتی همراه با جریان هوا از طریق درب های ورودی پنجره ها سیستم های گرم کننده یا سرد کننده وسیستمهای تهویه وارد محیط داخل ساختمان می شوند.
ص: 55
اسپورهای موجود در هوای خارجی روی سطوح خارجی بدن افراد و حیوانات رسوب میکنند و بنابراین البسه،کفشها، کیف و ... بعنوان ناقلین و حاملین معمولی و شایع کپک ها به فضای داخلی عمل می کنند. مهمترین کپکهای داخل ساختمانی شامل کلادوسپوریوم، پنیسیلیوم، آسپرجیلوس و آلترناریا می باشند
تصویر شماره 18
لکه های سیاه و تیره مربوط به کلنی و اجتماع قارچها هستند

تصویر شماره 19
نشت آب موجب تقویت و تکثیر اسپورهای قارچی در داخل ساختمان میشود
محل ساختمان کتابخانه و آرشیو نباید در ناحیه صنعتی قرار داشته باشد بهترین وضعیت آب و هوایی در داخل ساختمان مهیا شده باشد و حفاظ دائمی در مقابل ،نور حشرات و گرد و غبار وجود داشته باشد. مصالح چوبی باید قبل از استفاده به وسیله ی انواع قارچ کش و حشره کش ضد عفونی شوند و روی قسمتهای فلزی از جلای قارچ کش و حشره کش استفاده کنند. شیشه پنجره ها باید جاذب اشعه ی ماورای بنفش و مادون قرمز باشند و به توریهای ریز نیز مجهز ،بوده تعداد و اندازه ی پنجره ها در حد کفایت کوچک باشند پایه ی ساختمان بلندتر از سطح زمین ،باشد دیوارها و سقفها عایق کاری شوند و اتاقها حتی الامکان مستقل از یکدیگر باشند محوطه ی ساختمان ،وسیع کاملا تمیز و دارای تعداد زیادی دستگاه تهویه باشد امور نظافت ساختمان با نظم
ص: 56
و با استفاده از دستگاه های مکنده ای مانند جاروی برقی قوی صورت گیرد مقدار آلودگی هوا به صورت دوره ای مورد سنجش قرار گرفته و در صورت مشاهده ی آلودگی اقدامات ضد عفونی مناسب انجام گیرد. هر گونه نشتی و ریزش بیمورد آب در هر قسمت از ساختمان باید مرتفع گردد. با توجه به اینکه اکثر قارچها خاکزی بوده یا بر روی سطوح مختلف گیاهان وجود دارند از قرار دادن گلدانهای حاوی گل و گیاه در محوطه های داخلی کتابخانه ها و مراکز نگهداری اسناد باید خودداری کرد
تصویر شماره 20 اسپورهای کلادوسپوریوم روی صفحات پخش کننده ی هوا

تصویر شماره 21
کلنی های قارچی موجب آسیب در این نسخه ی خطی شده است (عکس از آرشیو سازمان اسناد ملی ایران)
در صورتیکه هجوم و رشد قارچها بر کتابها و اسناد کاغذی قبلا اتفاق افتاده ،باشد، تنها راه از بین بردن آنها استفاده از روشها و مواد ضد عفونی کننده است مواد ضد عفونی کننده قارچها را از بین میبرند ولی اکثراً آثار نامطلوبی نیز بر روی کاغذ برجای می،گذارند از طرف دیگر آثار و بقایای آفات قارچی و لکه های بجا مانده از آنها از طریق راه ها و روشهای ترمیمی به کمک مرمتگران برطرف میشوند
ص: 57
کتاب ها و اسناد آسیب دیده و آلوده با میکروارگانیسم ها میتوانند سلامتی کاربران ،کتابداران حفاظت گران و مرمت گران را نیز تهدید نمایند و از طرف دیگر مواد ضدعفونی کننده مختلفی که برای رفع آلودگی مورد استفاده قرار میگیرند علاوه بر آثار کم و بیش نامطلوبی که در خود کتابها و اسناد بر جای میگذارند تهدید کننده سلامتی این افراد نیز میباشند بنابر این در صورت ضرورت کاربرد هر یک از این روشها باید احتیاطات لازم را بکار برده و بسته به موقعیت و وضعیت خاص از روش مناسب و از هر لحاظ مقرون به صرفه استفاده نمود. بعنوان مثال برای نگهداری تعداد بسیار اندک و محدود از کتاب یا سند خاصی میتوان از جعبه نفوذناپذیر در مقابل هوا، رطوبت، تغییرات دمایی، نور و... که کاملاً عاری از هوا بوده و محتوی گاز بی اثری چون ،نئون آرگون یا هلیم و یا ازت میباشند استفاده نمود اما برای نگهداری مجموعه بزرگی از کتابها و اسناد از مجموعه ای از امکانات از قبیل محل و موقعیت ساختمان امکانات و تدابیر خاص داخل ساختمان به شرح فوق ،الذکر حفظ و نگاهداری شرایط محیطی استاندارد درجه حرارت رطوبت نسبی ،نور تهویه و جریان هوا ،نظافت استفاده کنندگان و... و کنترل دوره ای و منظم آلودگی های محیطی با کمک میکروبیولوژیست و ضدعفونی دوره ای سطوح میزها و قفسه ها کف و دیوار اتاقها و هوا همواره شرایط را برای رشد و تکثیر عوامل میکروارگانیسمی محدود نمود.
کتابهای با حجم و یا تعداد کم را میتوان به ناحیه خشک با تهویه خوب و ترجیحاً در هوای خارج از ساختمان انتقال داده و نسبت به رفع آلودگی از آنها اقدام نمود. اسپورهای فعال کپکها را به کمک برسهای نرم از جنس خز میتوان از سطح کاغذ خارج کرد جلد کتاب و صفحات انتهایی آن از نظر وجود لکه ها و آثار قارچی باید به دقت بررسی شوند زیرا این نواحی معمولاً قسمتهایی هستند که قارچ ها در ابتدا در آنجا ظاهر می.شوند جلد کتابها با کمک یک پارچه مرطوب به نرمی و آهستگی باید پاک شوند و سپس بمدت 2 تا 3 ،روز در هوای تازه خشک شوند برای کتابخانه ها باید از محفظه های کوچک و مناسبی برای فومیگاسیون کتابهای آلوده استفاده کرد و اگر چنین چیزی هم میسر نباشد میتوان ورقه هایی را که قبلا با تیمول درصد در الکل خیسانده شده اند لابلای صفحات کتاب در فواصل ده صفحه ای نسبت به یکدیگر قرار داد برای ضدعفونی کردن کتابها و اسناد آلوده در کتابخانهها و مراکز اسناد از راه های مختلفی ممکن است استفاده شود که هر یک دارای محدودیتها و احیانا معایب یا مزایای خاص خود است که در ادامه این نوشتار بطور خلاصه به مهمترین و معروفترین این روش ها پرداخته شده است.
ص: 58
استاکی بوتریس چارتاروم Stachybotrya chartarum بر روی موادی با پایهی سلولزی و در شرایط مرطوب رشد می.کند شرایط مرطوب و مناسب برای رشد این قارچ بعلت تراکم هوا و تهویه و عایق کاری ضعیف فراهم می.شود در چنین شرایطی اسپورها بوسیله ی سیستمهای تهویه و گردش هوا منتقل میشوند در صورتیکه سیستمهای تهویه هوا رطوبت سازها دوشها و جکوزیها بطور منظم و بصورت مؤثر تمیز و ضدعفونی نشوند میتوانند موجب بروز مشکلاتی بشوند.
روشهای استاندارد آشکارسازی و شناسایی برای میکروارگانیسمها که در پزشکی و بهداشت بکار میرود در فرآیند دگرگونی بیولوژیکی مواد نیز استفاده میشوند کتابها و منابع مختلفی در زمینه ی میکروب شناسی تشخیصی پزشکی (clinical) و محیطی (environmental ) موجود و در دسترس میباشند و در این زمینه مفید هستند برخی از آزمایشهای جدید به سادگی قادر به شناسایی آنزیمها و یا محصولات اختصاصی آنها در ارتباط با این پدیده اند. یک مثال خوب در این مورد تست هیدروژناز برای SRB است که میتواند مربوط به این مسئله باشد که آیا آنزیم هیدروژناز در خوردگی بیولوژیکی مهم است یا خیر؟
نمونه برداری مهمترین مرحله برای هرگونه آنالیز میکروبیولوژیکی است. اگر نمونهی مناسب قابل دسترس نباشد حتی حساس ترین روش های شناسایی بی ارزش خواهند بود.
پایش یک محیط یا ماده برای ارزیابی خطر تجزیه بیولوژیکی عموما از طریق آنالیز نمونه هایی که در یک دوره ی زمانی بدست میآید انجام میشود در این مورد با استفاده از روش نمونه گیری که خوب استاندارد شده باشد مهم است طوریکه بتوان نتایج بدست آمده را به راحتی با یکدیگر مقایسه کرد و هر گونه افزایشی در تعداد میکروارگانیسمهای تجزیه کننده به سرعت شناسایی شوند. ارگانیسمهایی که باعث فساد میشوند همان ارگانیسم های محیطی هستند و تعداد کم آنها ممکن است در موقعیت و وضعیت های ایمن (safe) یافت شوند. تنها اگر این تعداد شروع به افزایش کنند باید عملیات مناسب برای حفاظت از آثار صورت گیرد. هنگامی که هدف از نمونه برداری ارزیابی میزان تأثیر مواد بیوساید است می توان از هر روش استاندارد شده ای استفاده کرد. استاندارد کردن روش استفاده از سواب برای نمونه برداری تقریباً غیر ممکن است زیرا رطوبت سواب و میزان فشاری که هنگام نمونه برداری روی شی مورد نظر بعمل می آید بصورت ثابت و یکنواخت حفظ نمیشود. اخیراً روش هایی
ص: 59
که به کمک آنها تعداد و یا ضایعات میکروارگانیسمهای موجود در بیوفیلم را اندازه گیری میکنند توسعه یافته اند. یک مثال ساده استفاده از واکنش اکسیداسیون و احیاء برای اندازه گیری تنفس میکروبی است. تغییر رنگی که در سوبسترا پدید می آید برای تخمین فعالیت عمومی میکروبی در بیوفیلمهایی که بر روی سطوح سنگها تشکیل شده اند استفاده شده است. رنگهای فلوئورسنت مثل آکریدین اورنج (acidine orange ) و 4 و 6 دی آمیدینو-2- فنیل ایندول (DAPI) را میتوان برای رنگ آمیزی سلولهای میکروبی در یک بیوفیلم نازک بکار برد و سپس بصورت مستقیم با استفاده از میکروسکپ فلئورسانس آنها را شمارش کرد سلولهای زنده را بوسیله ی رنگهایی که فقط هنگامی که آنزیم های میکروبی روی آن اثر می کنند دارای درخشش میشوند می توان شمارش کرد. بعنوان مثال 2، 7 دی کلرودی هیدروفلوئورسئین در فرم اکسید شده بکار میرود و تنها هنگامی که بوسیله ی سلولهای زنده احیاء میشود درخشش سبز دارد. روشهای بسیار پیشرفته تر استفاده از متدهای نوین میکروسکپی نظیر میکروسکوپ اتمی (atomic force microscope) و میکروسکوپ الکترونی environmental scanning electron microscopy) که البته در حال حاضر بیشتر دارای کاربرد تحقیقاتی هستند مورد دیگر استفاده از حسگرهای بسیار ظریف و دقیق است که برای اندازه گیری pH و غلظت اکسیژن بکار میروند
روشهای معمولی و استاندارد میکروسکپی و کشت نیز در اینجا بطور فراوان مورد استفاده قرار میگیرد شرح این روشها در کتابهای میکروب شناسی پزشکی و میکروب شناسی محیطی وجود دارد. روشهایی که بر پایه ی شناسایی و سنجش بیوملکولهایی نظیر آدنوزین تری فسفات فسفولیپیدها و ارگوسترول وجود دارند نیز میتوانند برای سنجش سریع و کمّی برای آلودگی عمومی یا اختصاصی با میکروارگانیسمها مورد استفاده قرار گیرند سنجش آدنوزین تری فسفات بوسیله ی اندازه گیری بیولومینسانس از مدتها پیش استفاده شده است. در صنایع غذایی برای ارزیابی آلودگی میکروبی سطوح دستگاههای تهیه ی غذا از روش فوق استفاده شده است اندازه گیری ارگوسترول یک روش اندازه گیری سریع و مفید برای تشخیص توده ی زنده ی قارچی .است ارگوسترول یک جزء ساختمانی غشاءهای سلولی قارچی است که در ارگانیسمهای دیگر وجود ندارد و یا در مقادیر کم دیده میشود علاوه بر روشهای سریع ایمونوفلورسانس از روشهای ایمیونولوژیکال (ELISA) که در حوزههای پزشکی استفاده ی وسیعی میشود برای سنجش سریع میکروبی و تعیین اندازه و تعداد آنها در مورد قارچ Hormoconis resinae بکار رفته است اصول تکنیک مشابه روش ایمیونوفلورسانس است اما بعنوان نشانگر ملکولی به جای ترکیبات فلوئورسنت از آنزیم استفاده میشود این تکنیک نیازی به میکروسکوپ ایمیونوفلورسانس ندارد و واکنش مثبت بصورت تغییر رنگ سوبسترای آنزیم
ص: 60
قابل رؤیت میباشند و تمام فرآیند بصورت اتوماسیون صورت گرفته و نتایج کمی بسرعت بدست می آیند
عبارت «پیشگیری بهتر از درمان است» در اینجا نیز کاملاً بجا است. با مروری مختصر بر روشهای پیشگیری و کنترل فساد بیولوژیکی باید در نظر داشت که هیچکدام از این روشها کامل و بدون نقص نیستند و هیچیک به منزله ی نوش دارو و علاج قطعی عمل نمیکنند نتایج سعی و کوشش ما اغلب کنترل سطح آلودگی یا رشد میکروبی و یا به حداقل رساندن میزان آلودگی و رشد میکروبی است.
آشنایی با فیزیولوژی مادهی زنده ی تجزیه کننده در تعیین استراتژی استفاده از روشهای فیزیکی مفید است. بعنوان مثال دانش و آگاهی از رفتار جوندگان در پریدن و جویدن گرفته تا تحمل و مقاومت قارچهای خاص به شرایط رطوبت کم در محیط میتواند ما را در انتخاب راه های کنترل پیشگیری و مبارزه یاری دهد پایین نگاه داشتن دما تا 20 درجه ی سانتیگراد اغلب برای به تأخیر انداختن رشد در طی یک دوره ی طولانی ضرورت دارد اگر چه کپکهای آهسته رشد در سردخانههای بزرگ گزارش شده.اند توانایی برخی از ارگانیسمها برای تولید مواد ضدیخ در داخل سلولهایشان توجیه کنندهی استمرار رشد آنها در شرایط بسیار سرد است. رشد قارچها در مواد غذایی که در دمای 4 الی 6 درجه سانتیگراد در یخچالهای خانگی نگهداری میشوند پدیده ای شایع و معمول است در آنسوی دیگر طیف ،دمایی دمای بیش از 40 درجه ی سانتیگراد فعالیت تعداد زیادی از میکروارگانیسم ها را کاهش میدهد هر چند که برای کاهش شدید در حیات ارگانیسم های تولید کننده ی اسپور دماهای بالاتر از نقطه جوش لازم است استریلیزاسیون کامل فقط در دمای 121 درجهی سانتیگراد به مدت 15 دقیقه بوسیله دستگاه اتوکلاو در شرایط فشار 1/5 کیلوگرم نیرو بر سانتیمتر مربع (یا 15 پوند بر اینچ مربع صورت میگیرد در مورد استریلیزاسیون مواد با حجم زیاد شرایط فوق باید به مدت یک ساعت دوام داشته باشد تا حرارت بطور کامل نفوذ کند.
حرارت دادن تا میزان 60 درجه ی سانتیگراد بوسیله ی تکنیک solar bagging برای حذف آفتهای اشیاء موزه ای استفاده می.شود در این روش مواد و اشیای موزه ای را در پوششهای پلاستیکی قرار داده و در معرض تابش مستقیم خورشید قرار میدهند در این حالت دما بسرعت بالا رفته و حشرات بالغ تخمها و مراحل بینابینی رشد آنها در طول چند ساعت بوسیله دهیدراتاسیون کشته میشوند. این یک روش ساده با سطح تکنولوزی پایین است و برای کشورهایی که در مناطق گرمسیری واقع شده اند مناسب و ایده آل
ص: 61
است. در انستیتوی حفاظت کانادا از همین روش و البته شکل توسعه یافته ی آن استفاده میشود. استفاده از روشهای دیگر از قبیل flash heating پاستوریزاسیون و افزایش موضعی دما در سیستمهای گردش کننده برای کاهش آلودگی باکتریایی و قارچی در سوختها و روغنها توصیه شده است. حذف نسبی آب از یک محصول یا نگهداری آن در اتمسفری با رطوبت پایین نیز عموماً استفاده میشود. خشک کننده ها (desiccants اغلب داخل بسته های کالاها قرار داده میشوند تا آب موجود در اتمسفر را جذب کند و رطوبت داخل بسته را کاهش دهد. این عمل احتمال رشد میکروبی را کاهش میدهد سطح رطوبت هوا یا رطوبت نسبی و سطح دما دو پارامتری هستند که بر میزان بقا و پایداری مورد انتظار یک شی تأثیر می گذارند. اگرچه محتوای رطوبتی به آسانی قابل اندازه گیری و پایش است اما یک نشانگر مطلق برای ارزیابی پتانسیل رشد میکروبی روی یک ماده نیست فعالیت آب (Aw) یک ماده اندازه ی قابل دسترسی آب برای میکروارگانیسم در اتمسفری است که در آن رشد میکند فعالیت آب عبارت است از نسبت فشار تبخیر آب یک ماده به فشار تبخیر در آب خالص در شرایط دمایی ،یکسان بنابر این فعالیت آب (Aw) مربوط به آب خالص برابر 1 است و این میزان هنگامی که به آب مواد حل شونده اضافه میشود کاهش مییابد. تابشهایی مثل اشعه گاما اشعه فرابنفش و امواج میکروویو اغلب در مواقعی که مشکل بزرگ و عمدهای بعنوان مثال در یک محصول مایع وجود داشته است بعنوان عوامل استریل کننده بکار رفته اند. اشعه ی گاما برای درمان کتابهای کتابخانه ای که از حادثه سیل آسیب دیده اند و رشد قارچی وسیعی داشتند بکار رفته است.
چگونگی و کیفیت سطح یک ماده بر روی کلونیزاسیون اولیه ی میکروارگانیسمها اثر میگذارد سطوح صاف هیدروفوبیک نظیر فیلم های epoxy paint نسبت به سطوح ناصاف تر که میتوانند ذرات و مواد آلی را بر روی خود حمل کنند کمتر احتمال کلونیزاسیون میکروبی را فراهم میکنند
مواد شیمیایی که برای کنترل فساد بیولوژیکی مورد استفاده قرار می گیرند به اشکال مختلف گازی (فومیگانتها) پودرهای پخش شونده و مایعات میباشند استریلیزاسیون گازی یا فومیگاسیون برای رفع آلودگی موادی بکار می رود که قبلا بوسیله ی حشرات یا میکروارگانیسم ها آلوده شده است و نمیتوان از راه های دیگر مثل حرارت اشعه دادن یا افزودن مواد شیمیایی به ضدعفونی کردن آنها پرداخت استفاده ی موفقیت آمیز از آنها نیاز به دانش تخصصی و تجهیزات مناسب دارد از سالها پیش متیل بروماید برای آفت حشرات در بسیاری از کشورها تا سال 2004 استفاده شده است و سرانجام در کشورهای توسعه یافته کنار گذاشته شده است. اکسید اتیلن و
ص: 62
اکسید پروپیلن هنوز در برخی کشورها برای نابود کردن باکتریها و قارچها مورد استفاده قرار میگیرد. مزیت این دو ماده در قدرت نفوذ خوب آنها به مواد بسته بندی شده .است مواد را درون اتاقکهایی که قبلاً هوای آن خارج شده است قرار میدهند و بعد ماده ی ضدعفونی کننده در غلظت دما و رطوبت نسبی مشخص و تعیین شده را درون آن تزریق میکنند. بعد از اتمام کار گاز را کاملا خارج کرده و محصولات ضدعفونی شده را نیز در شرایطی قرار میدهند که گازهای نفوذ کرده از داخل آن به تدریج خارج شوند.
اتمسفر با اکسیژن پایین کمتر از 0/03 درصد در مورد آلودگی با حشره چوبخوار و موریانه ها در موزه ها بکار رفته است. حُسن این روش این است که از روشهای کم خطر برای پرسنل میباشد اما کنترل سخت و دقیق دما و رطوبت نسبی برای حصول موفقیت بسیار اساسی میباشند بیوساید ایده آل که البته در حال حاضر چنین چیزی وجود ندارد ماده ای است که خواص زیر را داشته باشد
برای ماده ی فاسد کننده یا تجزیه کننده ی هدف سمی.باشد
برای ،انسان حیوان و گیاه سمی نباشد.
با محصول مورد ضدعفونی سازگار باشد و آثار و رنگ ناخواسته روی آن ایجاد نکند و خواص آن را تحت تأثیر قرار ندهد.
- در هر دو فرم غلیظ و رقیق شده اش پایدار باشد.
ارزان باشد
در ادامه ی بحث به پاره ای از روشهای متداول شیمیایی اشاره شده است.
اکسید اتیلن بعنوان یک ماده موتاژن سرطانزا) شناخته شده است حدود تماس مجاز که بوسیله اداره ایمنی و تندرستی ایالات متحده پیشنهاد شده 50 قسمت در میلیون ppm) است میزان مؤثر آن 500 گرم به ازای هر متر مكعب حجم هوا میباشند و از آنجا که ماده قابل انفجاری است در عمل هنگام استفاده در نسبت 10 به 90 با گاز دی اکسید کربن در یک محفظه خلاء (تصویر شماره (22 مخلوط مینمایند اگر این عمل در شرایط رطوبت نسبی 30 تا 35 درصد انجام شود تأثیر بیشتری داشته و اثر آن با افزایش میزان رطوبت نسبی کاهش میباید برخی از سویههای باسیلوس سوبتیلیس در دمای 54 درجه سانتیگراد و در رطوبت نسبی 40 تا 60 درصد و با غلظت 1000 میلی گرم در لیتر از این ماده در مدت 25 دقیقه از بین میروند و در دمای 21 درجه سانتیگراد با غلظت 2200 میلی گرم در لیتر نابود میشوند
ص: 63
از معایب این ماده علاوه بر خطر سرطانزائی ،آن این است که همه میکروارگانیسم ها به این ماده حساس نیستند و برخی مقاومت قابل توجهی به آن نشان میدهند در مطالعات مختلفی نشان داده شده است که این ماده روی برخی از قارچها از جمله کتومیوم گلوبوزوم تریکودرماویریده گونه هایی از فوزاریوم و پنیسیلیوم و برخی از اکتینومیست ها تأثیری نداشته است
تصویر شماره 22
اتاقک محل قرار دادن اسناد یا کتابها آلوده برای ضدعفونی سازمان اسناد ملی ایران

تصویر شماره 23
تاسیسات مربوط به ضد عفونی با اتیلن اکساید سازمان اسناد ملی (ایران
برخی از مشکلات و معایب دیگر این روش عبارتند از مشکلات مربوط به نقل و انتقال کتابهای آلوده به محلی که دستگاه های خلاء مربوطه نصب شده است هزینه بالا زمان هوادهی طولانی بعد از رفع آلودگی زمان) (قرنطینه و خطرات مربوط به سلامتی کارکنان بنابراین علی رغم مؤثر بودن آن در کتابخانه ها و مراکز آرشیو بندرت توصیه شده یا بکار برده میشود.
یک ماده ضد عفونی کننده ملایم و متوسط است. در دمای اتاق به شکل کریستال است و باید در فضای بسته بکار رود خاصیت فونژیسیدی آن ثابت نشده اما بنظر میرسد که بعنوان یک ماده فونژیستاتیک مؤثر است و برای اینکه اثرات فونژیستاتیک خود را اعمال کند باید بمدت 3 هفته در مجاورت کتابهای آلوده قرار بگیرد
ص: 64
اگر کریستالها به کمک حرارت تصعید شوند به زمان کمتری نیاز خواهد بود پارادی کلروبنزن بعنوان یک روش برای جلوگیری از رشد کپکها بویژه در فضاهای کوچک و بسته بسیار مفید است.
استنشاق بلعیدن یا تماس پوستی با آن خطرناک است برخورد با آن میتواند باعث گیجی، سردرد تحریکات پوستی و چشمی مشکلات تنفسی و عدم هماهنگی اعضاء (تعادل) شود اثرات تماس دراز مدت با آن شامل درماتیت ورم) و التهاب پوست و آسیب کبد و کلیه میباشند.
پارادی کلروبنزن در حقیقت یک ماده حشره کش است اما در فضاهای بسته و محدود دارای اثرات ضد قارچی نیز میباشند این ماده در نمونههای پنبه پشم و کتاب که توسط قارچهای زیر آلوده شده باشند اثرات ضد قارچی را دارد آسپر جیلوس نیجر آسپر جیلوس اوستوس گونه های پنیسیلیوم کتومیوم گلوبوزوم و میروتشیوم و روکاریا
پارادی کلروبنزن در غلظت 50 گرم در هر متر مکعب بطور کامل باعث از بین بردن قارچهای کتومیوم گلوبوزوم استاکی بوتریس ،آترا تریکودرما ویریده شده اما در قارچهای آسپرجیلوس فلاوس، آسپرجیلوس ترئوس و پنیسیلیوم فونيكولوزوم تنها موجب توقف رشد آنها میگردد.
در یک مطالعه نشان داده شد که اشعه دادن با گاما به میزان KGY تمام اسپورهای قارچی تحت مطالعه را از بین برد اما این مقدار اشعه موجب دگرگونی شیمیایی در کاغذ نیز گردید استفاده از پرتوهای الکترونیکی نیز با دوز KGY 10 روی قارچها مؤثر بوده ولی در کاغذ نیز موجب فساد شده است. به نظر میرسد که استفاده از امواج میکروویو برای کاغذ امیدبخش تر است. در یک مطالعه با استفاده از دستگاه میکروویو با توان 600 وات شرایط مناسبی فراهم کرده است. نتایج نشان داد که این امواج در نابود کردن قارچهای مورد آزمایش بسیار مؤثر بودند در این مطالعه هیچگونه اثرات فیزیکی یا شیمیایی منفی روی چند نوع کاغذ دیده نشد. البته این روش نیز دارای محدودیتی به این شرح میباشند که با کمک اغلب دستگاههای میکروویو میتوان اسناد نازک و یا صفحات کاغذ را در حجم های اندک تحت تأثیر قرار داد و بنابراین در مقیاس بزرگ مناسب و قابل بهره برداری نمی باشند
این ماده یک مشتق گوانیدینی ،است یک ترکیب غیر سمی و پلیمری است که در روسیه ساخته شده و برای محافظت از مواد کتابخانه ای در مقابل عوامل قارچی بکار رفته است. این ماده یک باز (قلیا) قوی و قدرت آن
ص: 65
برابر قدرت سود سوزآور است. با توجه به ساختمان پلیمری و خواص کاتیونی فضاهای بین فیبرهای کاغذ را بطور کامل پر میکند این ماده با غلظت یک درصد باعث مهار رشد قارچ های زیر شده است
Chaetomium globosum, Penicillium cyclopium, Penicillium roquefortii,
Sporotrichum bombycinum, Aspergillus terreus, Aspergillus amstelodami, Stachybotrys chartarum,
Verticillium tenerum, Myxotrichum deflexum
اما اسپورهای قارچ های زیر به غلظتهای بالاتری به میزان 1/5 تا 2 و حتی 3 درصد از این ماده شیمیایی نیاز دارند
Penicillium purpurogenum, Trichoderma viride,
Rhizopus nigricans, Aspergillus niger, Aspergillus flavus
میزان 800 کیلوراد برای نابود کردن اسپورهای قارچ کافی است اما این مقدار اشعه در کاغذ سبب کهنگی (aging) آن می.گردد
تیمول ماده شیمیایی با سمیت نسبتاً کمی است بطوریکه در پزشکی از این ماده در قرصهای ضدعفونی کننده گلو و حلق استفاده میشود در کتابخانه ها و مراکز بزرگ اسناد از آن بصورت فومیگاسیون به شکل بخار (درآمده استفاده میشود تصویر شماره (24 اما در کتابخانه های کوچک یا برای دارندگان کلکسیونهای کوچک تر بهتر است از تیمول بصورت کاغذهای آغشته به آن که لابلای کتابها و یا بین اسناد قرار داده میشوند استفاده گردد مهمترین ایراد در استفاده از تیمول قابلیت حل شدن و به حالت پلاستیکی درآمدن و چسبناک کردن رزینهایی است که در صحافی و یا در برخی از جوهرها ( در (لیتوگرافی بکار میرود بر طبق تحقیقات انجام شده تیمول بر روی قارچهای زیر اثر کشندگی دارد:
Aspergillus niger, Chaetomium globosum, Stachybotrys atra, Penicillium vermiculatum, Epicoccum purpurascens
همچنین تیمول بر روی باکتری استرپتومایسس سلولزه اثر کشندگی دارد
ص: 66
تصویر شماره 24 محفظه ی مربوط به کاربرد تیمول در ضد عفونی کتابهای آلوده به قارچ
یک ماده قارچ کش فونژیسید قوی است که بطور وسیعی در حادثه سیل فلورنتین در سال 1966 در کارهای حفاظت روی میلیونها جلد کتاب و سند بکار رفته است. این ماده به اندازه کافی فرار نیست و بنابراین براحتی بعنوان ضد عفونی کننده در دسترس قرار نمی گیرد
ماده ای مؤثر است به شرط آنکه در کاغذهایی بکار رود که میزان رطوبت پائینی دارند اگر رطوبت دائمی موجود باشد این ماده را نمیتوان بمدت طولانی در داخل فیبرها یا الیاف کاغذ نگاهداری کرد
مخلوط کلرید جیوه و تیمول نیز دارای اثرات ضد قارچی و بسیار سمی است. در ضمن باعث میشود که اسیدیته کاغذ به تعداد کمی افزایش یابد.
این ماده علاوه بر اینکه سمی است بطور ضعیفی حالت اسیدی دارد و در مجاورت نور علاوه بر هیدروکلراید (اسید) تولید محصولات رنگی مختلفی از جمله یک محصول قرمز رنگ بنام اسید کلرانیلیک مینماید
ص: 67
این ترکیبات تنها بر روی باکتریهای گرم مثبت مؤثر هستند و آنها را میتوان ترجیحاً با ارتوفنیل فنل بکار برد.
بنظر میرسد که برای ضدعفونی کاغذهای نو که فاقد نوشته ها میباشند مناسب است. طرز استفاده بدین صورت است که با کمک کاغذ خشک کن blotting paper) که با این ماده خیسانده شده آن را بین اوراق آسیب دیده کاغذ قرار میدهند این ماده موجب تغییر حالت اسیدی یا قلیایی کاغذ نمیشود اگر در مورد اسنادی که با جوهر نوشته شده باشد بکار رود ممکن است مضر باشد علاوه بر این مانند دیگر ترکیبات فنلی کلردار تا حدودی فرار بخار شدنی بوده و هنگام تجزیه و فساد دارای خطر بالقوه در آزاد کردن گاز کلر می باشند.
فرمالین یک ماده ضدعفونی کننده قوی است که از بخور آن برای ضدعفونی در فضای بسته استفاده میشود بوی بسیار تحریک کننده ای دارد و برخی از افراد نسبت به بو و بخارات آن بسیار حساس میباشند. کتابهای آلوده باید در صندوق های نفوذ ناپذیر و یا اتاق هایی که درزهای آن بصورت محکمی مسدود شده باشد در شرایط دمای 20 درجه سانتیگراد و رطوبت نسبی 60 درصد حداقل به مدت 12 ساعت در مجاورت بخار فرمل قرار گیرند.
از این روش برای نگهداری اسناد میتوان استفاده کرد اشکال کار این است که نیاز به ایجاد و احداث تأسیسات سردکننده دارد و نگاهداری این تأسیسات نیز هزینه بالایی دارد
مواد ضد عفونی کننده بسیاری وجود دارند که اغلب مخلوطی از میکروب کشهای اساسی هستند مانند پاراکلرومتا گزایلنول به همراه صابونها حلالها و ترکیبات خوشبوی ،دیگر این گونه مواد نباید مستقیما روی کتابها و اسناد قرار گیرند بلکه مطابق با دستورات و توصیه های سازندگان آنها به نسبت های مشخص رقیق شده و برای تمیز کردن قفسه ها قبل از قرار دادن کتابها در آن بکار روند.
ص: 68
تصویر شماره :25 کاربرد متیل بروماید بصورت افشانه

فعالیت هایی که لازم است در کنار استفاده از روشهای شیمیایی یا غیر شیمیایی صورت گیرد
با استفاده از یک تکه پارچه خشک و تمیز یا یک برس نرم کپکهای قابل مشاهده را از روی کاغذ یا کتاب آلوده دور نمایید. برای پاک کردن کپک از روی جلد یا شیرازه کتاب از الکل اتیلیک البته) توسط یک مرمتگر با تجربه استفاده شود. در مواردی که آلودگی بسیار شدید است این کار را قبل و بعد از پاکسازی ضدقارچی باید انجام داد لازم به توضیح است که این عملیات پاکسازی باید در هوای بیرون از ساختمان و یا زیر دستگاه هود بیولوژیک فیلتردار صورت گیرد. پارچه ها یا برس های استفاده شده تا قبل از شستشو جهت استفاده مجدد باید در پاکتهای پلاستیکی نفوذناپذیر نگهداری شوند.
کپکهای قابل مشاهده روی کتابها را میتوان با کمک دستگاه مکنده با جریان خشک یا مرطوب برداشت .نمود محفظه تانک این دستگاه باید محتوی یک ماده قارچ کش مناسب مانند هیپوکلریت سدیم 10 باشد. موقع کار با مواد آلوده به کپک از دستکش پلاستیکی یکبار مصرف و ماسکهای فیلتردار استفاده شود
همزمان با رفع آلودگی از کتاب ها ناحیه و فضایی که قرار است کتابها و اسناد بعد از رفع آلودگی در آنجا نگهداری شوند باید تمیز وضد عفونی گردند ،قفسه،ها ،دیوارها کف و سقف اتاق و پنجره ها باید با یک محلول قارچ کش مناسب از قبیل - Lysol, loox تمیز و ضد عفونی شوند هنگام تمیز کردن مطمئن شوید که هوا بطور مطلوبی تهویه میشود و قبل از آنکه محیط نگهداری به خوبی پاک نشده باشد کتاب های تمیز به محل خود بازگردانده نشوند.
ص: 69
تصویر شماره 26 آثار کپک زدگی روی سقف

برای این منظور میتوان از ذغال یا جوش شیرین بی کربنات سدیم ( استفاده کرد بدین شکل که پودر ذغال یا بی کربنات دوسود را در ظرفی ریخته و سپس آن را در محل مناسبی قرار میدهند
تصویر شماره 27 تجمع اسپور و کلنی قارچی متعاقب نشت آب در سقف
فضا و نواحی ضدعفونی شده و نیز کتابها و اسناد را با ایجاد تغییراتی در محیط باید پاک و تمیز نگاه داشت. کنترل دما و رطوبت باید دائما صورت گیرد جریان هوا (تهویه) بطور مطلوب انجام شود نشتی های آب در هر کجا که هستند اصلاح شوند و منابع دیگر رطوبتی برداشته شده و تحت کنترل در آیند.
نگاهداری کلکسیونها در شرایط محیطی مناسب نیاز به فومیگاسیون را کاهش داده و یا ممکن است بطور کامل برطرف نمایند. مواد جدیدی که به کلکسیونها اضافه میشوند ممکن است گاهی اوقات به ضدعفونی شیمیایی نیاز داشته باشند به هر حال اگر قرار است از روشهای شیمیایی برای ضدعفونی کتابها یا اسناد آلوده استفاده شود بهتر است کارهای زیر انجام گیرد
ص: 70
-1 بررسی علت
سطح دما و رطوبت را اندازه بگیرید بررسی کنید که آیا مادۀ آسیب دیده مرطوب است یا خیر و اگر مرطوب است علت را جستجو کنید دستگاههای تهویه هوا را از نظر نشتی بازرسی کنید
2 - جدا و ایزوله کردن مواد آسیب دیده
اشیای آلوده را در کیسه های پلاستیکی در بسته و نفوذناپذیر قرار دهید توده باقیمانده را قرنطینه کنید و در موارد آلودگی شدید و وسیع دسترسی به اتاق یا ساختمان را محدود کنید
3 - اصلاح محیط رطوبت محیط را تنظیم نمایید فنها یا هواکشها را تنظیم کنید تا باعث جریان یافتن هوا در نواحی آلوده ،شود دستگاه های رطوبت گیر و یا ضدرطوبت سیار را راه اندازی نمایید
4 - تمیز کردن
کپکهای قابل مشاهده را با کمک پارچه تمیز و خشک یا برس نرم و مناسبی از روی کتابها بردارید جلد کتاب را با کمک اتانول یا پمپ مکنده مناسبی پاک نمایید قفسه ها دیوارها کف و سقف اتاق دستگاه های تهویه مطبوع و منافذ هوا در اتاق و ساختمان را با محلول Lysol ,Clorox و یا 14 x یا محلولهای قارچ کش
دیگر ضدعفونی کنید
-5 پیگیری و مراقبت دائمی
نواحی آلوده را تا چندین ماه بعد از پاکسازی تحت نظر قرار دهید حتی بعد از آنکه محیط برای جلوگیری از رشد کپکها اصلاح شده باشد.
همانگونه که ملاحظه گردید آسیبهای بیولوژیک در کاغذ توسط باکتریها و قارچهای مختلفی پدید می آید و شکل، نوع و رنگ حاصل اختصاص به قارچ یا باکتری خاصی ندارد از طرفی قارچهای مختلف ممکن است آسیبهای مشابه پدید آورند و از جانب دیگر یک گونه اختصاصی از یک قارچ در کاغذهای مختلف از نظر جنس، قوام میزان رطوبت درونی کهنگی یا تازگی میزان اسیدیته و .... آثار متفاوتی برجای میگذارد بنابراین صرفا با مشاهده رنگ و شکل لکه ای روی کاغذ نمیتوان در مورد علت بیولوژیک آن قضاوت نموده و اقدام به استفاده از مواد شیمیایی ضد قارچ کرد علاوه بر این با توجه به رفتارهای متفاوت قارچها در برابر شرایط فیزیکی و شیمیایی
ص: 71
محیط و میزانهای مختلفی از حساسیت و مقاومت آنها در برابر مواد شیمیایی لازم است عامل بیولوژیک ایجاد کننده آسیب در کاغذ حداقل در سطح جنس قارچ یا باکتری ) و در صورت لزوم تا سطح (گونه توسط میکروبیولوژیست شناسایی شده و با توجه به میزان حساسیت یا مقاومت آن در برابر عوامل شیمیایی یا روشهای فیزیکی مربوطه و نیز ارزیابی مضرات و فواید روش در نظر گرفته شده برای کاغذ و همچنین ملاحظات انسانی از منظر بهداشت و سلامتی اقدام به استفاده از آن .کرد بطور خلاصه قبل از استفاده از مواد و روشهای ضدعفونی سه نکته باید بطور جدی مورد ملاحظه قرار گیرد
-1 با کدام جنس یا گونه از قارچ یا باکتری مواجه هستیم؟
-2 میزان آسیب کاغذ توسط این روش یا ماده چقدر است؟
-3 میزان ریسک و خطر برای سلامتی کارکنان و محیط زیست چقدر است؟
-4- در صورت استفاده از ماده ضدقارچی مورد نظر میزان تأثیرات سوء آن روی کاغذ چقدر است؟
کنترل رطوبت اماکنی که کاغذ یا کتاب در آنها نگاهداری میشود بسیار حائز اهمیت است رطوبت نسبی کتابخانه و انبارهای کتاب و کاغذ را باید حتی الامکان ثابت نگاه داشت رطوبت نسبی 60 و درجه حرارت محیط 16 تا 18 درجه سانتیگراد و اگر رطوبت نسبی محیط از %70 تجاوز نماید بزودی کپکها و موجودات ذره بینی دیگر شروع به رشد و نمو خواهند کرد اگر ضمن بازدید از کتابها آثاری از کپک بر اوراق کتابها دیده شود باید بلافاصله اقدام به خشک کردن آنها نمود در غیر اینصورت کاغذ زرد رنگ شده و لکه های رنگین بر سطح آن باقی خواهد ماند.
تصویر شماره :28 رشد انبوه کپک در سطوح تحتانی و نمناک دیوارها

ص: 72
اشیاء و آثار غیر کاغذی تاریخی و فرهنگی
پارشمن اشیای موزه ای
آثار نقاشی
چرم و پوست
فلاپی دیسکها و نوارهای ویدیوئی
تصویر شماره 29 آثار کپک در لبه ی جلد کتاب

ص: 73
پارشمن از پوست بز یا گوسفند بدست میآید و یکی از مواد خیلی رایج برای گنجینه های دست نویس و انواع وسایل مختلف هنری .است پارشمن به رطوبت خیلی حساس است و از ،کلاژن مقداری ،کراتین الاستین و مقدار بسیار کمی آلبومین و گلبولین تشکیل شده است.
قارچهای آلترناریا آسپر جیلوس نیجر کلادوسپوریوم هرباریوم فوزاریوم و اسکوپولاریوپسیس برویکالیس را از پارشمن جدا کرده اند
قارچ در ماتوفیت میکروسپوروم فولووم (Microsporum fulvum) بعنوان عامل تجزیه کننده و فساد در اشیای موزه ای که واجد کراتین هستند جدا شده است. این اشیا ممکن است واجد ،مو، پشم و یا پر پرندگان باشند. فساد منسوجات عمدتا مربوط به قارچهای مصرف کننده سلولز از قبیل قارچهای خانواده کتومیاسه (Chaetomiaceae است. مواد و کالاهای چوبی عمدتا بوسیله اعضای خانواده کتومیاسه و مونیلیالها تغییر شکل میدهند
مواد و کالاهای چرمی معمولاً توسط دو ترومیست ها و مونیلیالها(بالاخص گونه هایی از جنس پنیسیلیوم، آسپرجیلوس اسکوپولاریوپسیس و کلادوسپوریوم مورد حمله قرار گرفته و تخریب میشوند شایع ترین قارچهایی که روی اشیای موزه ای ایجاد آلودگی و تخریب میکنند عبارتند از کلادوسپوریوم کتومیوم، کوروولاریا فوزاریوم ،موکور پنیسیلیوم رایزوپوس اسکوپولاریوپسیس استاکی بوتریس استمفیلیوم تریکودرما، آلترناریا، آسپر جیلوس و اورئوبازیدیوم رشد قارچها در منسوجات باعث تشکیل رنگ و یا کاهش قدرت ماده (منسوجات ) میشود فیبرهای
سلولزی نسبت به فیبرهای پروتئینی به آسیبهای وارده توسط قارچها حساس تر میباشند.
غالب ترین قارچهایی که از نقاشیهای روی دیوار جدا شده اند عبارتند از:
Aspergillus flavus, Alternaria alternata, Cladosporium cladosporoides
این قارچها از رطوبت موجود در صمغها یا چسبها و نیز ذرات گرد و غباری که روی نقاشیها وجود دارد برای رشد خود استفاده مینمایند
ص: 74
پنتا کلروفنات سدیم Sodium Penta chlorophenate با غلظت یک دهم درصد برای کنترل میزان رشد قارچها در نقاشیها بسیار مؤثر است. سایر قارچهایی که از نقاشیها جدا شده اند عبارتند از:
Aureobasidium pullulans, Alternaria tenuissima, Rhizopus stolonifer
حداقل 18 جنس قارچی از روی نقاشیهای دیواری در تایلند جدا شده است این قارچها عبارتند از:
Aspergillus, Aureobasidium. Cladosporium. Curvularia, Fusarium. Dendrophoma, Emericella , Geotrichum, Helminthosporium, Monilia, Myrothecium, Paecilomyces, Penicillium, Schizophyllum, Stachybotrys, Syncephalastrum, Trichoderma, Sterile hyphae.
آنزیم های قارچی مانند ،آمیلاز کیتیناز سلولاز همی سلولاز و نیز متابولیتهای قارچی مانند اسیدهای آلی و پیگمانها باعث تغییرات تخریبی روی نقاشیها می گردند.
تقريباً همه نقاشی ها اعم از آنهایی که روی کاغذ هستند یا ،چوب منسوجات یا دیوار به فساد قارچی حساس هستند. در نقاشیهای روی پارچه های کرباسی یا کتانی canvas) قارچها معمولا از قسمت پشت آنها شروع به رشد می.کنند حساسیت طبیعی منسوجات بوسیله آهار چسب افزایش مییابد همانطور که بداخل منسوجات نفوذ میکنند به قسمت پشت لایه رنگینه دار میرسند و باعث شکاف ترک و جداشدگی ذرات رنگدانه میشوند هیدرولاز سلولز باعث ایجاد اختلاف در اتصال بین لایه پیگمان دار و پارچه کتان میشود در خیلی از موارد فیلامنت های روی لایه رنگینه دار گسترش مییابند و باعث پوشش (masking) رنگ و طرح آن میشوند
چرم دارای درصد قابل ملاحظه ای از پروتئین چربی و گلیسیدها است در شرایط دمای 20 تا 30 درجه سانتیگراد و رطوبت نسبی بیش از 65 همراه با گرد و غبار قارچها در آن بسرعت رشد کرده باعث ایجاد لک شده و حتی تخریب فیزیکی را بدنبال خواهد داشت قارچهای زیر از چرم جدا شده اند آسپر جیلوس ،نیجر آسپر جیلوس نیدولانس آسپر جیلوس ،فلاوس رایزوپوس موکور پنیسیلیوم
کرایزوژنوم پنیسیلیوم لوتئوم و گونه های دیگری از پنیسیلیوم رشد قارچها روی چرم باعث از بین بردن ظاهر صیقل دار آن شده و سبب خشکی، شکنندگی و سخت شدن آن می.شود چرمهای دباغی شده با گیاهان(Vegetable-tanned leathers) نسبت به فساد قارچی بسیار
ص: 75
حساس است و تقریباً چرمهای دباغی شده با کروم بعلت حضور ترکیبات کروم کاملاً مقاوم است .
نوارهای ویدیوئی فلاپی دیسکها یا دیسکت ها محتوی ذرات مغناطیسی معمولاً از جنس اکسید آهن فریک میباشند که بر روی پایه ی پلی استری متصل شدهاند. ذرات مغناطیسی عموماً در یک دوغاب (shurry) پلی اورتان بکار برده شده اند اجزای دیگری نیز از قبیل اجسام پلاستیکی کننده (plasticizer)، مواد ساینده و فرسایش گیر یا خراشنده (abrasive) مواد لیز کننده (lubricant) و مواد پراکنده کننده (dispersant) در این قبیل محصولات وجود دارند تمام این مواد میتوانند نسبت به رشد میکروبی حساس باشند. گونه هایی از جنس آسپرجیلوس پنیسیلیوم و پسیلومایسس را که بر روی سطح فلاپی دیسکها رشد کرده اند از این مواد جدا کرده اند این ارگانیسمها تجزیه کننده ی پلاستیک نیستند. در واقع در صورت آلودگی لایه سطحی و نازک مغناطیسی با این قارچها منجر به نقص القای الکتریکی یا اختلال رسانایی میشود و تجزیه و فساد پلاستیک ضرورتی ندارد کتومیوم که از قارچهای تجزیه کننده ی سلولز است از فلاپی دیسکهای مستعمل جدا شده است. کتومیوم احتمالا از فیبرهایی که بین محیط مغناطیسی و مواد پلاستیکی قرار دارند تغذیه میکند اینگونه صدمات میتواند بصورت دائمی اطلاعات روی دیسکت را نابود کرده و به رایانه نیز صدمه برساند. تنها اقدامی که میتوان انجام داد این است که سطح روی دیسکت پاک شود و اطلاعات روی آن بر روی یک فلاپی دیسک جدید منتقل شود.
نوارهای ویدیوئی ترکیبی از تصویر صوت و اطلاعات کنترل سرعت را در بر دارد هنگام روشن شدن و ،نواختن نوار باید از لابلای قسمتهای مختلف عبور کند تا نتایج مطلوبی حاصل شود مقاومت (tolerance) و تاب و تحمل بین نوار و سر (head) سیستم کمتر از مقاومت یک چهارم ضخامت تار موی انسان است. تنها فقط یک کلنی کوچک قارچی لازم است تا به کارکرد مؤثر این سیستم (دستگاه مداخله کند و در شرایط بدتر موجب صدمه به دستگاه میشود
رشد قارچها بر روی لوح های فشرده (CD) در محیطهای گرم و مرطوب یک اتفاق معمول است. اولین بار در سال 2001 موردی از رشد قارچ ژئوتریکوم کاندیدوم بر روی یک عدد لوح فشردهی موزیک گزارش شد. پاکسازی ساده با آب و صابون و یک پارچه نرم میتواند به حذف آثار رشد میکروبی کمک کند هرچند که ممکن است اثر یا نقشی از این آسیبها در آن باقی بماند برای از بین بردن نقش و آثار حک شده با کمک یک پارچه ی کتان با کیفیت خوب میتوان از یک پوشش فلزی با پایهی آب و بدون آمونیاک مشابه آنچه که برای پاک کردن و تمیز کردن نقره بکار میرود استفاده نمود. البته این روش همیشه موفقیت آمیز نیست.
ص: 76
آلودگی قارچی اشیای فرهنگی و مسئله سلامت کارکنان بخشهای حفاظت و مرمت
شایع ترین علائم مربوط به آلودگی با کپکها
راه های ورود کپک ها به بدن انسان
آلرژن ها
ارتباط بین وفور کپکها با برخی علائم بیماریها
ساختمانهای اداری
تهدیدات از طریق هوای داخل ساختمان
بیوآئروسلهای موجود در فضاهای داخلی 1 و 3 بتا دی گلوکان
هیدروفوبین ها
ملانین قارچی
ترکیبات فرار آلی میکروبی
مایکوتوکسین ها
بیماریهای آلرژیک و مسمومیتهای ناشی از قارچها
بیماریهای آلرژیک
تصویر شماره 30

ص: 77
در مطالعات گوناگونی که در نقاط مختلف دنیا انجام گرفته است بین فراوانی اسپورهای قارچی (کپکها در هوای داخل ساختمانها و علائم و اختلالات تنفسی ارتباط مستقیمی مشاهده شده است از آن جمله در مطالعه ای که در 13 شهر مختلف سوئد توسط Holmberg انجام شد افزایش سطح اسپورهای آسپر جیلوس حضور بیش از 50 کلنی در متر مکعب هوا با افزایش موارد گزارش شده تحریکات پوستی و چشمی سرفه و حالت سرماخوردگی، سستی و بیحسی رابطه مستقیم داشته است چنین مطالعاتی در آمریکا، کانادا، انگلستان و هلند نیز همین نتایج را تایید میکنند بین میزان رطوبت نسبی در هوای داخل ،اماکن پراکندگی و فراوانی اسپورهای قارچی نیز رابطه مستقیمی نشان داده شده است محلها و نقاط خاصی در فضاهای داخل ساختمان بعنوان نقاط آمپلی فایر تقویت کننده و تکثیر کننده برای کپکها عمل میکنند که بعنوان مثال برخی از آنها عبارتند از راهها و مجاری آب و فاضلاب هواکش و دستگاههای تهویهای موادی که در ساختار آنها سلولز بکار رفته است مانند ،کاغذ چوب قفسه ها و کمدهای چوبی و مواد و وسایل خلل و فرج دار در مورد بروز یا شیوع اختلالات و ناراحتیهای مختلف ،پوستی تنفسی و علائم عمومی ناخوشی در کارکنان بخشهای حفاظت مرمت اشیای تاریخی و فرهنگی که غالباً آلوده با اسپورهای کپکهای آلرژن و توکسین زا هستند مطالعات کنترل شده آزمایشگاهی باید صورت گیرد.
از دست دادن حافظه اختلال در تمرکز حواس و فراموشی
اختلال در یادگیری و تفکر
ترشحات مخاطی رقیق و آبکی رینیت خروج ترشحات لعابی و سبز رنگ از بینی
خونریزی مکرر از بینی
،سرفه، التهاب و زخم در ریه ها
اختلالات تنفسی
سردرد
دانه های پوستی و کهیر
خارش ،بینی دهان چشمها، گلو، پوست و ...
قرمزی اسکلرا سفیدی چشم راش های پوستی و قرمزی پوست
عطسه و احساس خستگی مزمن
ص: 78
بخش اول - فصل پنجم - جنبه های بهداشت و سلامت کارکنان ب-
حفاظت و مرمت
راه های ورود کپکها به بدن انسان
. استنشاق
• تماس پوستی با کپک یا مواد آلوده شده با آن
اگر چه کپکها ارگانیزم های زنده و تکثیر شونده هستند اما برای تحت تأثیر قرار دادن سلامتی ما ممکن است زنده نباشند.
آلرژن ها
تمام کپ کهایی که تا به امروز مطالعه شدهاند قادر به ایجاد واکنشهای آلرژیک در افراد حساس میباشند این واکنشها از پاسخهای ملایم و موقتی مانند آبریزش از چشمها یا بینی و تحریک حلق، سرفه و عطسه تا بیماریهای شدید و مزمن مانند سینوزیت و آسم وجود دارند درصد قابل توجهی از بیماران آسماتیک (32- (10 نسبت به قارچها حساس میباشند
کپکهای آلرژن شایع در فضای داخل و خارج ساختمانها عبارتند از:
آلترناریا کلادوسپوریوم آسپرجیلوس پنی سلیوم هلمنتوسپوریوم اپی ،کوکوم فوزاریوم موکور، رایزوپوس و اورئوبازیدیوم
(Horner,et al.1995;Einarsson, et al.1992;Burge,1985)
نمونه هایی از مطالعات اپیدمیولوژیک در کشورهای مختلف به شرح زیر میباشد
انگلستان
Melia et al در شمال ،انگلستان در مطالعه ای روی 191 بچه 5 تا 6 ساله حداقل یک علامت تنفسی(سرفه، ،سرماخوردگی خس ،خس ،آسم برونشیت و ارتباط آن با فراوانی اسپورهای کپکی در اتاق خواب بچه ها را به میزان 85 در پسرها و 64 در دخترها متوسط رطوبت نسبی در هفته 75 بوده است بدست آوردند.
هلند
در یک مطالعه 328 فرد بالغ و 190 بچه از 185 خانه تحت بررسی قرار گرفتند متوسط اسپورهای کپکی در خانه های با رطوبت بالا 192 عدد در متر مکعب و در خانه های خشک تر 107 عدد بوده است.
ص: 79
دو مطالعه روی بچه های مدرسه 6 تا 12 سال در سال 1987 روی 1051 نفر و در سال 1989 روی 3344نفر انجام شد نتایج حاصل از تجزیه و تحلیل دادهها نشان داد که ماکزیمم جریان هوای بازدمی یکی از فاکتورهایی که در ارزیابی سلامت دستگاه تنفس مورد بررسی قرار میگیرد. در ساکنین خانههای مرطوب تر واجد) (کیک %4/5 کاهش داشت و در خانه های بدون کپک %1 کاهش نشان داده شد.
سوئد
33 نفر در 13 شهر مورد بررسی قرار گرفتند :(Holmberg) افزایش سطح اسپورهای آسپرجیلوس بیش از 50 کلنی در متر مکعب با افزایش موارد گزارش شده تحریکات پوستی و چشمی سرفه و حالت سرماخوردگی سستی و بیحسی ارتباط مستقیم داشته است
Rylander et al ارتباط بین بتا 31 گلوکان موجود در دیواره سلولی قارچها و سرفه و خارش را گزارش داده است.
ایالات متحده
4625 کودک از 6 شهر مورد مطالعه قرار گرفت و ارتباط بین نم و رطوبت داخل ساختمان با علائم تنفسی و نیز ارتباط بین وجود کپکها و همان علائم بررسی و نتایج زیر بدست آمد
. افراد بدون ناراحتی تنفسی با نسبت شانس معادل 1/4
• افراد واجد ناراحتی های تنفسی با نسبت شانس 2/12
کانادا
در سال 1988 اداره بهداشت کانادا 17692 پرسشنامه برای 30 جامعه کانادایی افراد بالغ شامل والدین و مراقبين ومعلمين (مدارس ارسال نمود. 14984(83) پس از تکمیل عودت شد و بعد از تجزیه و تحلیل نتایج زیر بدست آمد
• شیوع نم و رطوبت یا کپک در خانه های کانادایی 38
. شیوع علائم تنفسی تحتانی ،سرفه، سستی و بیحسی خس خس سینه و خس خس همراه با (دیسپنه در افرادی که نم و رطوبت یا کپک را در خانه های خود گزارش داده بودند بیشتر بود. در 12569 بچه 5 تا 8 ساله شیوع علائم تنفسی 5/19 در خانههای دارای (کپک و 2/13 در خانه های بدون رطوبت و (کپک
بدست آمد.
ص: 80
ساختمان های اداری
هاریسون و همکارانش در تحقیقی که در بریتانیا انجام گرفت متوسط اسپورهای قارچی را 277 کلنی در هر متر مکعب در 4 ساختمان با) تهویه طبیعی و 30 کلنی در هر متر مکعب در بقیه ساختمانها بدست آوردند. بین شیوع علائم تنفسی و تعداد اسپورهای قارچی ارتباط مثبتی گزارش شد.
43 نفر از 49 کارمند یک ساختمان اداری در نیویورک با توکسین ساتراتوکسین اچ استاکی بوتریس (آترا مواجه شدند علائم بالینی شامل ناراحتی های تنفسی خستگی و ضعف ناراحتیهای سیستم اعصاب مرکزی و تحریکات چشمی و پوستی بوده است آنتی بادی اختصاصی از کلاس IgE برای استاکی بوتریس آترا در 4 نفر از آنها نشان داده شد. بیش از 100000 اسپور زنده در هر سانتیمتر مکعب در آلودگی بر روی سطوح دیوار وجود داشت.
47 درصد از ایزوله های قارچی جدا شده از خانه های نمور در ادینبورگ توکسین زا بوده اند. در یک مطالعه در 52 خانه در کانادا در 3 خانه کپک توکسین زای آسپرجیلوس فومیگاتوس نشان داده شد. مایکوتوکسین تریکوتسن از سیستم تهویه در 3 ساختمان در مونترال کانادا جدا شده است. 14 نفر از 26 بیمار آلرژیک رینیت و آسم با کپک های موجود در خانه های خودشان تست پوستی مثبت نشان دادند.Tarlo et al)
فضولات پرندگانی مثل کبوتر و خفاش که در کانالها و مجاری ورود هوا و یا بعضی از اتاقها تجمع می یابد حاوی قارچ بیماریزای کریپتوکوکوس نئوفرمنس و در بعضی مناطق جغرافیایی دیگر حاوی هیستوپلاسما کپسولاتوم علاوه بر آسپرجیلوس فومیگاتوس توکسین را که قدرت ویرولانسی کمتری دارد میباشد قارچ های توکسین را مانند استاکی ،بوتریس آسپرجیلوس پنیسیلیوم و فوزاریوم در صورتی که در کشتهای متوالی جدا ،شوند نیاز به بررسیهای بیشتر و اقدامات مناسب دارند. حضور یک یا چند نوع اسپور قارچی که با درصد بسیار زیادی نسبت به هوای خارج تایید شده باشد
نشانگر وجود عوامل افزاینده آمپلی فایر در محیط درون خانه است. مایکوفلورای هوا در حالت طبیعی در هوای داخل به لحاظ کیفی مشابه و به لحاظ کمی کمتر از
مایکوفلورای هوای خارج است اگر بیش از 50 کلنی در هر متر مکعب از اسپورهای یک گونه قارچی هوای داخل یا خارج - غیر از کلادوسپوریوم و آلترناریا - نشان داده شود علت آن باید بررسی شود.
ص: 81
تا 150 کلنی در هر متر مکعب اسپورهای قارچی در هوای داخل به شرطی که متفاوت و متنوع بوده و انعکاسی از قارچهای خارج ،باشند طبیعی است. تعداد بیشتر نشان دهنده هوای کثیف یا فیلتراسیون نامناسب است.
تا 500 اسپور متنوع قارچی در متر مکعب هوا در فصل تابستان قابل قبول است و گونه های شایع تر ابتدا کلادوسپوریوم و سپس قارچهای دیگری که عمدتا روی درختان حضور دارند میباشند تعداد اسپورهای بیشتر از این تعداد آلودگی داخلی یا نارسایی در فیلتراسیون ساختمان را نشان میدهد.
در نواحی مانند کف اتاقها کانالهای هوایی دستگاههای مرطوب کننده و دیگر سطوح در صورتی که آثار و نشانه های قابل رؤیتی از قارچها دیده شود، بدون توجه به وضعیت اسپورهای موجود در هوا نیاز به بررسی و پاکسازی کامل دارند
اولین گام در پیشگیری از رشد و نمو کپکها این است که منبع و منشاء رطوبت شناسایی و هرگونه نشتی و ریزش آب اصلاح یا متوقف شود رطوبت هوای داخل اتاق کاهش یابد پاکسازی مناسب آبهای ریخته شده و بویژه پاکسازی مناسب آب بعد از حوادثی مانند سیل نخستین مراحل برای جلوگیری از ژرمیناسیون کپکها میباشد
ذرات زنده ی معلق موجود در فضاهای داخلی شامل گرده گیاهان (Pollen) باکتریها، ویروسها، پروتوزوآها، جلبکها (Algae مایتها حشرات و مواد دفعی آنها پوست و موی حیوانات خانگی بزاق خشک شده ی دهان حیوانات خانگی مخمرها و کپکها میباشند رشد کیک داخل خانه ها و ساختمانها با مشکلات و مسائل بهداشتی انسان به درجاتی مرتبط است این مشکلات در دامنه ای از بیماریهای آلرژیک تا توکسیکوزها وجود دارند. برخی از فاکتورهای مهم که ممکن است در بیماری زایی این کپکها سهیم باشند عبارتند از بتا 1و3
دی گلوکانها ،هیدروفوبینهای خارجی دیواره سلولی قارچی 1 و 8 - دی هیدروکسی نفتالن ملانین ترکیبات آلی فرار ،قارچی مایکوتوکسینها و استاکی لایزین
ص: 82
تصویر شماره 31 اجزای شیمیایی سازنده دیواره ی سلولی قارچها

اثر بیولوژیکی بتاگلوکانها - که یک جزء عمده و مهم دیواره سلولی قارچی میباشند - به وزن ملکولی درجه انشعابات جانبی با پیوندهای 1 و 6 و ساختمان مارپیچی هلیکال آنها بستگی دارد (تصویر شماره (31) باید در نظر داشت که بتا 1 و 3 دی گلوکانها مختص سلولهای قارچی نبوده و در گیاهان و باکتریها نیز وجود دارد و منشاء آلودگی به آنها در فضاهای داخلی این منابع نیز مطرح میباشند
-1 - Dectin رسپتور بتاگلوکان در سطح سلولهای دودمان منوسیت - ماکروفاژ و نوتروفیلها بیان شده است. این رسپتور تولید TNF-C را باعث میشود مواجهه ریه با بتاگلوکانها در افراد آلرژیک میتواند یک پاسخ قوی IgE را تحریک کند.
پاسخ سلولهای T بر طبق پروفایل لنفوکاینهای تولید شده به دو ساب کلاس Th1 و Th2 تقسیم می.شود این پروفایلها عبارتند از:
Th1: IFN-Y, IL-2
Th2: IL-4, IL-5, IL-10
افراد آتوپیک پاسخهای با واسطه Thi را به آلرژنهای محیطی بیان میکنند در حالیکه افراد آلرژیک بطور تیپیک پاسخ Th2 را نشان میدهند
12-IL تولید اینترفرون گاما را توسط سلولهای T و NK cell تحریک میکند
سلولهای Thi در تمایز لنفوسیتهای B و تولید ایزوتیپ IgG2a دخالت دارند.
ص: 83
سلولهای Th2 سلولهای تولید کننده آنتی بادی را برای القاء class-switching آنتی بادیهای IgG1 و IgE کمک میکنند که در ایجاد یک پاسخ ازدیاد حساسیت فوری مهم هستند
بتا 1 و 3 دی گلوکان با فعالیت ضد توموری ،میزبان اثرات ادجوانت فعال سازی نوتروفیلها ائوزینوفیلها ماکروفاژها NK،, cells ،کمپلمان واکنشهای التهابی غیر اختصاصی، تحریک چشم و حلق، سرفه خشک درماتیت و کاهش حجم مؤثر بازدمی مرتبط بوده است.
بتاگلوکانها پلیمرهایی از گلوکز هستند که به پروتئینها ،لیپیدها مانان و کیتین متصل شده اند. در آب نامحلولند و در اکثر ،قارچها برخی از باکتریها اغلب گیاهان عالی و بسیاری از گیاهان پست وجود دارند و تا 60 درصد وزن خشک دیواره سلولی قارچها را به خود اختصاص میدهند
پروتئین های سطحی کوچکی هستند که توسط قارچهای رشته ای تشکیل میشوند وزن ملکولی آنها 7 الی 10 کیلودالتون است و ممکن است گلیکوزیله شده باشند این پروتئینهای کوچک شامل 75 الی 125 اسید آمینه هستند و در قسمت انتهای C دارای 8 جایگاه سیستینی میباشند وقتی که قارچ با یک سطح میانی هیدروفیلیک - هیدروفوبیک مواجه میشود این پروتئینها یک لایه پروتئینی آمفیپاتیک (مثل مرز و سرحد بین آب و هوا تشکیل میدهند. سطوح کونیدیها بازیدیوسپورها و آسکوسپورها هایفای هوایی ساختمانهای تشکیل دهنده کونیدیا و اجسام میوه ای مانند پیکنیدیا، آسکوکارپ و بازیدیوکارپها واجد آن میباشند. آسپرجیلوس فومیگاتوس یک پاتوژن فرصت طلب مهم در بیماران با ایمنی آسیب دیده میباشند یکی از عوامل آسپر جیلوزیس آلرژیک برونکوپولمونری است و نیز میتواند مایکوتوکسین هایی مثل گلیوتوکسین تولید کند.
.Paris et al متعاقب استنشاق کونیدیهای آن در موش گزارش کردند که پروتئین هیدروفوبین rod A (16) در جوندگان در سطح خارجی دیواره سلولی کونیدیا مقاومت به کشتن کونیدی توسط ماکروفاژهای آلوئلار موشی را فراهم میکند
آشکارا اکسیدانتهای واکنشی ماکروفاژ قادر نبودند که بطور مؤثری از طریق سد هیدروفوبیک که کونیدی های بلعیده شده را احاطه کرده بودند بگذرند. موقعی که کونیدیای آسپر جیلوس فومیگاتوس برای اولین بار با مجاری تنفسی تماس پیدا میکند هیدروفوبین هایی مانند rod AP یک ملکول شناساگر مهم برای سیستم ایمنی است
در دیواره سلولی کونیدی کلادوسپوریوم هرباریوم هیدروفوبین - بعنوان یک نشانگر بیماری آلرژیک بوسیله الایزا نشان داده شده است.
ص: 84
هیدروفوبینها ممکن است آنتی ژنهای مهمی برای شناسایی و تفکیک بیماریهای آلرژیک و تهاجمی باشند هیدروفوبینهای دیواره سلولی کونیدیال اختصاص به گونه داشته و فقط در کونیدی وجود دارند.
قارچهای سیاه یک گروه هتروژن از قارچهای آسکومیست هستند که در دیواره سلولی خود ملانین دارند. ملانین از یک گروه از ترکیبات هتروژن تشکیل شده است و ماکروملکولهایی هستند که بوسیله پلیمریزاسیون اکسیداتیو ترکیبات فنولیک یا ایندولیک تشکیل میگردند هیدروفوبیک ،هستند، شارژ منفی دارند و در سطح خارجی دیواره سلولی قرار گرفته و لایه پیوسته ای را بوجود آورده اند ممکن است بصورت شبکه هایی در اطراف دیواره های سلولی یا بصورت پلیمرهای خارج سلولی وجود داشته باشند گرانولهای ملانین اگر با کربوهیدرات ها یا پروتئینها کنژو که در هم آمیختگی شوند محلول در آب می گردند.
از انواع مختلف ملانین،ها نوعی که از مسیر بیوسنتتیک - 1,8 Dihydroxynaphthalene ساخته میشود مهم ترین نوع ملانین را تشکیل میدهد (DHN-melanin) بیوسنتز ملانین در قارچها در خارج از غشاء پلاسمایی انجام میگیرد
DHN-melanin قارچ را از اثرات مضر نور فرابنفش محافظت میکند فشار turgor را نگاه میدارد سیستم ایمنی را تنظیم و تعدیل میکند بعنوان یک عامل آنتی میکروبیک عمل میکند یک ویرولانس فاکتور در بیماریهای گیاه و انسان است و ارگانیسم را برعلیه خشک شدگی لیز آنزیمی دمای خیلی بالا و اکسیدانها محافظت میکند
الكلها، آلدئیدها و کتونهای با وزن ملکولی پائین هستند که بوسیله راه های متابولیک اولیه یا ثانویه در متابولیسم هوازی یا بی هوازی تولید میشوند
• MVOCهایی مثل geosmin و methyl-isoborneol-2 مسئول ایجاد بوی نم و رطوبت ناخوشایند و نامطبوع کپکها هستند
. جئوسمین بوسیله آسپرجیلوس ،ورسیکالر کتومیوم گلوبوزوم و استرپتومایسس ساخته میشود.
• آستانه ایجاد بوی مربوط به ترکیب methyl-isoborneol-2 در آب 0.1ppb میباشد
. بنظر میرسد که تندی بوی MVOC مربوط به باند شدن آنها (MVOC) به رسپتوری در لایه داخلی
هیدروفوبیک از غشاء دولایه ای انتهای trigeminal عصبی باشد. این ترکیبات میتوانند باعث ،منگی کاهش زمان رفلکسی و گیجی شوند در غلظتهای بالاتر میتواند
ص: 85
باعث تحریک غشاءهای سیستم اعصاب مرکزی و در نتیجه سردرد ناتوانی و یا کاهش تمرکز حواس و گیجی شود. برخی از افراد بعنوان مثال در افراد مبتلا به آسم به غلظت های پائین این مواد حساس بوده و واکنش نشان میدهند
این ترکیبات ممکن است پاسخهای عصبی توام حسی و حرکتی را باعث شوند که منجر به تنگی نفس (breath holding) ،ناراحتی ،بیحسی ،خارش، سوزش یا حساسیت پوست گردند.
MVOC میتوانند در غلظتهایی که علائم فوق را ایجاد میکند در خانه ها وجود داشته باشند برخی از این ترکیبات توکسیک هستند مانند Trichodiene و Sesquiterpen ها که مربوط به مسیر بیوسنتتیک تریکوتسن هستند.
برخی از VOCها مایکوتوکسینهای حقیقی هستند Trichodiene یک مایکوتوکسین کلاسیک است و هنگام جذب از راه پوست موجب آسیب پوستی میشود. رخوت و خمودگی، سردرد، تحریک چشم و بینی و غشاءهای مخاطی از دیگر اثرات این گونه ترکیبات می باشند
مایکوتوکسین ها متابولیتهای آلی ،ثانوی غیر پروتئینی و با وزن ملکولی پائین هستند و برای میکروارگانیسمها گیاهان و جانوران سمی میباشند. برخی از آنها ،فرار برخی نیمه فرار و بالاخره بعضی دیگر غیر فرار هستند. مشتقات بیوسنتتیک از اسیدهای آمینه shikimic acid یا مالونیل کوآ میباشند.
متابولیتهای ثانویه برای رشد و نمو قارچ ضروری نیستند و همه متابولیتهای ثانوی سمی نمیباشند مایکوتوکسینها آشکارا در رقابتی عمل کردن بیشتر در محیط اکولوژیک قارچ به آن کمک میکند برخی مایکوتوکسین ها مانند پنیسیلین، سفالوسپورین، گریزئوفولوین و عوامل ایمیونوساپرسیومانند سایکلوسپورین آ و داروهای پائین آورنده کلسترول خون مانند lovastatin در پزشکی مورد استفاده قرار میگیرند و ترجیح میدهند که از واژه مایکوتوکسین در مورد آنها استفاده نکنند
در محیط های بسته مواجهه با مایکوتوکسینها از طریق خوراکی یک حادثه غیر معمول و نادر است اما استنشاق یا تماس پوستی از عمده ترین روشهای مواجهه با آنها میباشند تحقیقات روی مدل حیوانی نشان داده است که اثر توکسیک مایکوتوکسینها هنگام مواجهه استنشاقی با آنها بیشتر از مواجهه در اثر خوردن و بلعیدن است مایکوتوکسینهایی مانند تریکوتسنها و ترکیبات فراری که در جریان بیوسنتز trichodiene و دیگر سسکوئی ترپنها تشکیل میشوند میتوانند بسیار سمی باشند
مایکوتوکسینها میتوانند بصورت مستقل و یا بصورت سینرژیک عمل نمایند. بسیاری از تریکوتسن ها
ص: 86
بصورت سینرژیک عمل مینمایند مانند DAS و T-2 NOD و DAS
شدت بیماری مایکوتوکسین به نوع مایکوتوکسین طول مدت زمان برخورد و میزان مایکوتوکسین سن جنس و وضعیت تغذیه ای و بهداشتی افراد و هرگونها ثر سینرژیک با مواد شیمیایی یا مایکوتوکسین های دیگر بستگی دارد.
بطور کلی مایکوتوکسینها دارای یک اثر ایمیونوسوپرسیو هستند که میتواند باعث مستعد شدن افراد به کسب عفونت توسط دیگر میکروبها شود سیتوتوکسیسیته آنها میتواند باعث صدمه به ریه ها، پوست و دستگاه گوارش شود تولید مایکوتوکسین توسط رطوبت ، دما، سوبسترا میزان دی اکسید کربن و اکسیژن آسیب مکانیکال آسیب ،حشره لود ،کونیدیال میکروبهای رقابت ،کننده اینتراکسیونهای میکروبیال و درجه و میزان بلوغ قارچ تحت تأثیر قرار میگیرد بسته به نوع مایکوتوکسین مقدار مواجهه مدت زمان مواجهه و دوز سن و وضعیت سلامتی فرد
تأثیرات ممکن است حاد یا مزمن باشد.
براساس جذب و ورود روزانه مایکوتوکسینها از طریق رژیم ،غذایی اروپاییها روزانه 7/6 و 7 نانوگرم به ازای کیلوگرم وزن بدن -2-T و HT2 دریافت میکنند ساکنین آفریقا و خاورمیانه روزانه g/kg 0/77 الی 2/4 DON در حالیکه آمریکاییها Mg/kg 0/49 دریافت میکنند.
بیماریها و عفونتهای ناشی از قارچها فصل مهم و حجیمی از مسائل پزشکی را به خود اختصاص میدهند. رشته تحصیلی و تخصص قارچ شناسی پزشکی در ممالک مختلف دنیا به بررسی و مطالعه این گونه بیماریها و راهها و روشهای پیشگیری کنترل و درمان آنها می پردازد. هدف از نوشتار حاضر اشاره بسیار مختصر به آن دسته از عوامل قارچی است که بطور اختصاصی سلامت و بهداشت کارکنان کتابخانه ها و مراکز موزهای و اسناد مرمتگران و حفاظت ،گران آسیب شناسان و مشاغل مرتبط به آنها را تهدید مینماید. البته بدیهی است که این تهدیدات اضافه بر مخاطرات دیگر زیست محیطی است که سایر شهروندان را نیز مورد آزار قرار میدهند باید خاطر نشان ساخت که علاوه بر عفونت ها و بیماریهایی پوستی و یا داخلی ،قارچی بیماریهای دیگری وجود دارند که از طریق استنشاق اسپورها و سلول های قارچی موجود در محیط باعث تحریک و بروز واکنشهای حساسیتی و آلرژیکی میگردند نوع دیگر این دسته از بیماریها بیماریهایی است که بدنبال استفاده خوراکی از محصولات غذایی آلوده و آغشته به قارچها یا محصولات و فرآورده های آنها پدید می آیند.
ص: 87
این امراض یا بوسیله خوردن قارچهای گوشتی (کلاهکدار) که سمی هستند بوجود می آیند (که در این صورت به آنها مایستیسموس میگویند و یا در اثر خوردن مواد غذایی که قبلا توسط قارچهای میکروسکپی و یا سموم مترشحه از آنها آلوده شده اند ایجاد می گردند که بنام مایکوتوکسیکوزیس مشهور هستند. مایکوتوکسیکوز عبارت از یک حالت مسمومیتی مربوط به خوردن مواد غذایی است که قبلاً بوسیله رشد کپکهای خاصی در آن مسموم شده است و مشابه مسئله مسمومیت کلستریدیوم بوتولینوم یا مسمومیت غذایی ناشی از باکتری استافیلوکوک است.
مایکوتوکسین ها که گروهی از سموم میکروبی هستند تحت شرایط محیطی ویژه ای یعنی روی سوبستراها یا مواد غذایی ویژه ای و در درجه حرارتهای خاصی از محیط و توسط گونهها یا استرینهای خاصی از کپکها تولید میشوند بعنوان مثال کلادوسپوریوم کلادوسپوروئیدس (Cladosporium cladosporioides) که از کپکهای معمولی موجود در خاک است هنگامی که روی گیاهان خاصی رشد میکند یک نوع سم که باعث قرمز شدن پوست میشود تولید میکند ولی هنگامی که روی مواد دیگر رشد میکند این سم را تولید نمی.کند برخی از استرینهای آسپرجیلوس فلاوس هنگامی که روی گندم یا فندق رشد می کند، آفلاتوکسین تولید میکنند که سم خطرناکی برای کبد میباشند توکسین استریگماتوسیستین (sterigmatocystin) که توسط آسپر جیلوس فومیگاتوس تولید میشود یک فرآورده قارچی کارسینوژنیک سرطانزا) است این سم در موش سبب هپاتوما سرطان (کبد میشود و استعمال طولانی مدت آن موجب آدنوما و آدنوکارسینوما در اپیتلیوم بافت پوششی آلوئلار و برونشیال (سرطان در نسج ریه) میگردد. اهمیت این گفته ها در این است که اسپورهای قارچی موجود در محیط اطراف ما اغلب آلوده به این سموم میباشند و اثرات خود را بصورت آهسته و مزمن بر روی سلامتی ما اعمال می.کنند استاکی بوتریس قارچ کپکی دیگری است که بر روی مواد سلولزی داخل ساختمان ها رشد میکند و اسپورهای آن به برخی از سموم قارچی آغشته است.
در مطالعات مختلف بین میزان پراکندگی اسپورهای قارچی (کپکها در هوای داخل ساختمانها با علائم و اختلالات تنفسی ارتباط مستقیمی گزارش شده است. از آن جمله متناسب با افزایش تعداد اسپورهای آسپرجیلوس بیش از 50 عدد در متر مکعب ( موارد گزارش شده تحریکات پوستی و چشمی سرفه و حالت ،سرماخوردگی سستی و بیحسی نیز سیر فزاینده ای داشته .است بین میزان رطوبت نسبی در هوای داخل اماکن و پراکندگی و فراوانی اسپورهای قارچی نیز رابطه مستقیمینشان داده شده است . محلها و نقاط خاصی در فضاهای داخل ساختمان بعنوان مناطق تقویت کننده برای کپکها عمل میکنند که بعنوان مثال برخی از آنها عبارتند از مجاری آب و فاضلاب هواکشها و دستگاه های تهویه کننده هوا به تصاویر شماره
ص: 88
18 ، 19 و 20 توجه کنید و نیز موادی که در ساختار آنها سلولز بکار رفته است مانند کاغذ، چوب، قفسه ها و کمدهای چوبی و مواد و وسایل خلل و فرج دار که با نظافت و بهداشت مرتب و منظم آنها میتوان از تجمع و انباشت اسپورهای قارچی در آنها جلوگیری کرد
با انجام بازدیدهای مرتب و دوره ای از سرویسهای دستشویی و توالت حمام و آشپزخانه و موارد مشابه میتوان اقداماتی برای رفع آبریزش و نشت آب انجام داد و بدین گونه شرایط رطوبتی که مناسب برای رشد و تکثیر قارچها است را کنترل نمود
تصویر شماره 32

در افراد آتوپیک یعنی آنهایی که بصورت ذاتی یا ژنتیکی آمادگی و استعداد کسب بیماریهای آلرژیک را دارند حساسیت بصورت آسم برونشیال خودش را نشان میدهد آلرژنها مواد) و ترکیبات حساسیت زا معمولاً اسپورهای قارچهای موجود در خاک هستند که از راه هوا منتشر می.شوند حساسیت میتواند در افراد نرمال و طبیعی که بطور مزمن بدلیل نوع شغل و حرفه خود در معرض برخورد با اسپورهای قارچی قرار میگیرند نیز ایجاد شود.
آسم و آلرژی مربوط به استنشاق اسپورهای قارچها از مدتهای طولانی قبل بعنوان بیماری شغلی اختصاصی
ص: 89
شناخته شده اند. بسیاری از موارد بیماری مزمن ریه ایدیوپاتیک با علت نامشخص امروزه بعنوان تظاهرات ازدیاد حساسیت ناشی از اسپورهای قارچی یا محصولات قارچی شناخته شده است.
اسپورهای قارچهایی نظیر آلترناریا، هلمنتوسپوریوم درکسلرا کلادوسپوریوم پنیسیلیوم و آسپر جیلوس که تماما از هوای موجود در کتابخانه ها و مراکز اسناد جدا شدهاند و نیز به فراوانی بر روی کتابها و اسناد اشیای موزه ای و تاریخی وجود دارند غالبا مسئول بروز این واکنشها میباشند تعداد و پراکندگی اسپورهای این قارچها در طول سال متغیر بوده بطوریکه در فصل پائیز بسیار زیاد و در فصل بهار نسبتا کمتر هستند. بطور کلی دو نوع آسم وجود دارد نوع مربوط به دوران بچگی که اوج آن در حوالی دوران بلوغ است و بعد از آن بتدریج فروکش مینماید و نوع دوم که معمولا بعد از سن 40 سالگی شروع میشود و با افزایش سن ممکن است تشدید پیدا کند نوع اخیر میتواند سیر بسیار سریع و کشنده ای هم داشته باشد
سينوزيت التهاب یا عفونت پاکتهای هوایی موجود در اطراف و یا پشت بینی است و توسط عوامل مختلفی از قبیل باکتریها ،قارچها ویروسها و احتمالاً آلرژن ها ایجاد میشود حدود 15 تا 20 درصد جمعیت از سینوزیت مزمن رنج میبرند سینوزیت قارچی اولین بار در سال 1791 بوسیله Plaignaud گزارش شد. در اروپا و آمریکا مهمترین عامل قارچی سینوزیت اعضای جنس آسپر جیلوس و سپس موکور کاندیدا پنیسیلیوم و فوزاریوم میباشند. در دهه اخیر قارچهای پیگمان دار نظیر آلترناریا ،کوروولاریا درکسلرا بایپولاریس و اگز روهیلوم به لیست قارچهای عامل سینوزیت فرم آلرژیک ) اضافه شده است. سینوزیت های قارچی به سه گروه به شرح زیر طبقه بندی میشوند سینوزیت آلرژیک ،قارچی توپ قارچی و بالاخره سینوزیت های مهاجم قارچی
سینوزیتهای آلرژیک قارچی بیشتر در افراد بالغ و نوجوانانی دیده میشود که سابقه ازدیاد حساسیت آتوپی همراه با پولیپ های بینی و اغلب توام با آسم هستند زندگی در مناطق گرم و مرطوب میتواند بعنوان یک فاکتور خطر برای ابتلا به این نوع سینوزیت محسوب شود. گرفتگی بینی همراه با خروج ترشحات از آن و سردرد از جمله شایع ترین عوارض بوده اما علائم و خیمتری مانند تورم اطراف چشم بیرون زدگی چشم و اختلال در دید نیز ممکن است مشاهده شود تشخیص نیازمند گرفتن نمونههایی برای آزمایش آسیب شناسی و کشت قارچی است. در 80 درصد موارد قارچهای سیاه آنهایی که دارای پیگمان ملانین در دیواره سلولی خود هستند عامل این نوع سینوزیت میباشند سینوزیتهای مزمن قارچی نسبت به نوع قبلی از پیشرفت آهسته تری برخوردارند ولی تهاجمی بوده و به بافت اطراف حمله می.کنند علائم این نوع سینوزیت
ص: 90
ممکن است مشابه نوع قبلی باشد و این احتمال نیز وجود دارد که در صورت تهاجم قارچ به سیستم اعصاب مرکزی شاهد بروز علائمی چون ،صرع غش و یا اغماء باشیم. مبتلایان به نوع سوم از سینوزیت های قارچی یعنی توپ قارچی سینوسی بطور معمول دارای علائم گرفتگی بینی درد سینوس و احساس بوی بد در بینی خود بوده و بندرت ممکن است دچار حمله غش شوند شیوع سینوزیتهای آسپرجیلوسی در مناطق با آب و هوای گرم و خشک بیشتر است و علت آن میتواند ناشی از التهاب مزمن بینی در اثر گرما، خشکی و گرد و غبار باشد که ورود قارچ به سینوسهای اطراف بینی را آسانتر نموده و باعث تسهیل در رشد آن و آسیب بافتی در اثر رشد خود قارچ و متابولیتهای آن می.شود
آسپرجیلوزیس گروه بزرگی از بیماریهای قارچی است که توسط اعضای جنس آسپرجیلوس ایجاد میشود. در حدود 900 گونه در جنس آسپرجیلوس وجود دارد که تمامی آنها در محیط موجود بوده در خاک بر روی سبزیها و مواد آلی در حال ،فساد بقایای مواد غذایی داروهای باز شده دیواره های یخچال، لباسهای کهنه و غیره رشد می.کنند. اسپورهای این قارچ در هوا موجود بوده و دائماً استنشاق میشوند با وجود تعداد زیاد گونه های آسپر جیلوس در محیط بطور عمده 8 گونه آن باعث بیماری نزد انسان میگردند که عبارتند از آسپر جیلوس ،فومیگاتوس آسپرجیلوس ترئوس آسپرجیلوس کلاواتوس آسپر جیلوس نیدولانس آسپرجیلوس نیجر، آسپرجیلوس فلاوس، آسپرجیلوس نیوئوس و آسپرجیلوس رستریکتوس آسپر جیلوس میتواند بیماریهای مختلفی را در پوست ناخن بینی و چشم سیستم اعصاب مرکزی ایجاد نماید، همچنین اشکال سینوزیتی و جلدی میتوانند در افراد مستعد ایجاد شوند.
اسپور قارچهای ساپروفیت در همه جا حضور دارند امروزه گفته میشود که تمامی قارچهای شناخته شده دارای توان بیماریزایی برای انسان میباشند هر چند که در این پتانسیل بین عوامل مختلف قارچی شدت و ضعف وجود دارد. برخورد ما انسانها با اسپورهای قارچی از جمله استنشاق دائم آنها اجتناب ناپذیر است. همه ما روزانه چندین هزار اسپور آسپر جیلوس را از راه استنشاقی وارد دستگاه تنفسی خود میکنیم در برخی مشاغل شدت تماس و برخورد با اسپورهای قارچی بسیار زیاد است که مشاغلی همچون مرمتگری، آسیب شناسی موزه داری و کتابداری و موارد مشابه از آن جمله اند. بسیاری از اسپورهای قارچی حتی در حالت غیر زنده در سطوح خارجی خود آلوده به سموم قارچی هستند.
ص: 91
برخورد با قارچها در مشاغل ذکر شده میتواند منجر به اشکال خاصی از بیماری های قارچی از قبیل آسپر جیلوزیس ،سینوزیت آسم و آلرژی و یا مسمومیت تحت عنوان مایکوتوکسیکوزیس گردد با انجام اقدامات اولیه بهسازی محیط کار و زندگی مانند موارد زیر میتوان از شدت و کثرت تماس و برخورد با عوامل قارچی فرصت طلب و بیماریزا کاست
تهویه مؤثر و مناسب هوا نظافت و غبار روبی مکرر و منظم از روی سطوح و اشیاء، اصلاح نشتیهای آب در فضاهای داخلی ساختمان استفاده از دستکش و ماسک مناسب بینی و در موارد لزوم عینکهای ایمنی هنگام کار با اشیاء آلوده و کپک زده انجام معاینات پزشکی و آزمایشهای تشخیصی بصورت منظم و دوره ای مراجعه به پزشک در موارد مشاهده علائمی مانند حساسیتهای پوستی به شکل خارش و سرخ شدن پوست و بروز نشانه های اگزمایی گرفتگی و احتقان بینی و ترشحات غلیظ و چرکی بینی به همراه سردرد، سستی و بیحالی، گیجی و ،منگی سرفه و خلط در افرادی که سابقه قبلی این علائم را نداشته اند
ص: 92
مدنی فرح سادات بررسی روش استفاده از محیط کم اکسیژن در ضد عفونی آثار کاغذی آنوکسی نیتروژن پایان نامه
برای دریافت درجه کارشناسی ارشد گرایش مرمت اشیاء فرهنگی و تاریخی سال 1384
نیکنام مهرداد آفتها و آسیبهای ،کتاب روشهای علمی و عملی پیشگیری و ،ترمیم انتشارات مرکز اسناد و مدارک علمی چاپ دوم (1365)، صفحه 63 - 62
فوستا گالو، ترجمه عباسعلی عابدی ،استاد نقش عوامل بیولوژیک در فرسایش ،کاغذ انتشارات کتابخانه مرکزی آستان قدس رضوی . 1371
زینی فریده مهبد امیر سید علی امامی مسعود قارچ شناسی پزشکی جامع 1383. چاپ دوم انتشارات دانشگاه تهران
www.cool.conservation-us.org
BIODETERIORATION OF CULTURAL PROPERTY 3 .Proceedings of the 3rd International Confer-
ence on Biodeterioration of cultural property July 4-7 1995. P:630-42, 202
Caring for Books and Documents : A.D.Baynes-cope, Research Laboratory, British Museum, British
Museum Publications
Disinfection of paper using Gamma Rays, Electron Beam,and Microwaves. Flieder,F. et al.: Biodeterio-
ration of cultural property 3 Bangkok, Thailand 1995,P:283-97
Fogarby W.M., Kelly T.T.: Microbial enzymes and biotechnology, 2nd edition, 45-7, 1991
Kowalik R.: Microbiodeterioration of library materials part 2, Microbiodecomposition of basic organic
library materials chapter 4, Restaurator 4:135-219, 1980
Microbiodeterioration of Library materials part 2 Microbiodecomposition of basic organic Library
Materials chapter 4, Ronuald Kowalik, Restaurator 4: 135-219 : 1980
Preserving Library materials - A manual: Swartzburg, S.G., The Scarecrow Press, London,1980
Anaissie EJ, McGinnis MR, Pfaller MA. 2003. Clinical Mycology. CHURCHILL LIVINGSTONE
Collier L, Balows A, Sussma M. 1998. Topley Wilson's Microbiology and Microbial Infections. Vol.4:
Medical Mycology. Arnold.
ص: 93
ص: 94
نقش و اهمیت میکروارگانیسم ها در زندگی بشر
باکتریهای تجزیه کننده سلولز
الف- باکتریهای سلولولیتیک هوازی
اسید و ترموس
اکتینومیستها
استرپتومیسس
میکروبیسپورا
ترمومنوسپورا
باسیلوس
سلولوموناس
سل ويبربو
سودوموناس
ب باکتریهای سلولیتیک بی هوازی
استوویبریو باکتروئیدها
كلدو سلوم
کلستریدیوم رومینوکوکوس
تصویر شماره 33

ص: 95
-1 نقش بیماری زایی میکروبها باعث ایجاد بیمارهای مختلفی در انسان، دام و گیاه میشوند. پیدایش بیماریها در انسان به اشکال مختلف خسارات انسانی و اقتصادی بر پیکره جامعه بشری به بار می آورند مثلاً هر از چند گاهی بیماریهای مهلک و همه گیر در سطح جهان پدید آمده و کشتار مهلکی را از خود به یادگار میگذارند میتوان به سابقه کشتار توسط میکروب ، طاعون ،تیفوس آبله و ایدز اشاره نمود. علاوه بر این محصولات دامی ،گوشت ،شیر پوست .... دچار آسیب شده و بیماریهایی از این طریق نیز به انسان سرایت میکنند که به
بیماریهای مشترک انسان و دام مانند تب مالت سل و بسیاری از بیماریهای انگلی شناخته شده اند. ایجاد بیماری در گیاهان نیز بطرق زیاد باعث ایجاد خسارات و صدمات جبران ناپذیر می.گردد پوسیدگی چوب و تنه درختهای جنگلی بویژه در کشورهایی که صنایع چوب آنها نقش مهمی در اقتصادشان دارد آسیب دیدگی و فساد میوه ها و دانههای ،گیاهان آسیب ساقه ها و برگ ،گیاهان آلوده شدن محصولات کشاورزی بعد از برداشت در انبار فروشگاه و منزل و احیاناً انتقال برخی از بیماری ها از طریق گیاهان آلوده به بعضی ویروسها به انسان و... را میتوان نام برد
-2 نقش میکروارگانیسمها در تولید دارو از جمله انواع مختلف آنتی بیوتیکها که توسط اکتینومیستها و قارچها ساخته میشود میتوان به آنتی بیوتیکهایی مانند پنی سیلین سفالوسپورینها استرپتومایسین آمفوتریسین B گریزئوفولوین نیستاتین اریترومایسین و... اشاره نمود
3- نقش میکروارگانیسمها در تولید آنزیمها و اسیدهای آلی که کاربردهای صنعتی صنایع غذایی دارویی و آزمایشگاهی دارند مانند تولید آمیلاز اسید سیتریک گلوکز اکسیداز اسید گلوکونیک، اسید ،اگزالیک اسید استیک و ...
4- نقش میکروارگانیسمها در تولید مواد غذایی قند و چربی ،پروتئین ویتامینها و... قارچ های کلاهکدار خوراکی منابع سرشاری از پروتئین و بعضا چربی و ترکیبات قندی هستند قارچهای مخمری منبع ویتامین بویژه ویتامینهای گروه (B اسیدهای آمینه و برخی پروتئینها هستند از پودر و عصاره مخمر بعنوان منابع غذایی و یا مواد افزودنی در سایر غذاها استفاده مینمایند در صنایع مشروب سازی آبجوسازی و مشروبات الكلی ( استفادههای وسیع و متنوعی از قارچهای مخمری میشود
-5 قارچها و باکتریها باعث تجزیه لاشه موجودات عالی گیاهان و جانوران و برگرداندن عناصر اولیه تشکیل دهنده بدن آنها به طبیعت میباشند.
-6- بعضی از قارچها باعث عفونت ریشه برخی از گیاهان سبز شده و متعاقب این عفونت توانایی ریشه گیاه در جذب مواد معدنی افزایش مییابد این حالت نمونه ای از یک زندگی سمبوتیک symbotic) بین قارچها
ص: 96
و گیاهان سبز است که این پدیده را میکوریزا mycorrhiza) مینامند.
7- برخی از قارچها بعنوان ابزار کار و مدل آموزشی و تحقیقاتی در تحقیقات زیست شناسی سلول ،شناسی بیوشیمی ،میکروبیولوژی ژنتیک مهندسی ژنتیک و فیزیولوژی استفاده شده است.
چشمه های اسیدی نواحی غرب آمریکا منبع قابل توجه باکتریهای ترموفیل سلولیتیک است. درجه حرارت این چشمه ها حدود 60-45 درجه سانتیگراد و pH آن حدود 5/5-4 میباشد این باکتریها میله ای شکل و هوازی بوده و درجه حرارت مناسب برای رشد آنها 55 و 5 pH میباشد هنگام رشد روی سلولز بیشتر فعالیت سلولاز در طی آخر فاز لگاریتمی و اول فاز سکون اتفاق میافتد یکی از این سویه ها اسیدوترموس سلولیتیکوس (Acidothermus cellulolyticus می.باشند آنزیم سلولاز این باکتری جزو مقاوم ترین آنزیمهای سلولاز در برابر حرارت میباشند. اگرچه این باکتری ترموفیل در دمای 55 درجه سانتیگراد خوب رشد میکند اما دمای مناسب برای فعالیت سلولاز در کشت مایع آزاد سلول 75 درجه سانتیگراد است.
اکتینومیستها به لحاظ مرفولوژیکی فیزیولوژیکی و اکولوژیکی گروهی از باکتریها
هستند بعنوان مثال منظره ی میکروسکپی این دسته از باکتریها در تصویر شماره 34 و 35 مشاهده میشود آنها جمعیت عمده میکروارگانیسمهای خاک را تشکیل میدهد فعالیت سلولیتیک در 1/2 تا 1/3 اکتینومیستهای جدا شده از خاک مشاهده می.شود عوامل اکولوژیکی مهم دیگر در بیومس گیاهان مانند تفاله نیشکر و یونجه خشک و چوب و فضولات شهری دیده میشود. چنین محیطهایی بطور اولیه غلظتهای مواد
تصویر شماره 34

ص: 97
لیگنوسلولزیک برای رشد اکتینومسیتهای ترموفیلیک و هوازی که آنزیمهای آمیلاز سلولاز و همی سلولاز و پکتیناز دارند تهیه میکند. این تنوع برای تجزیه بیوپلیمرها در بخش وسیعی از مواد برای موفقیت اکتینومسیتهای ترموفیلیک در محیطهای مختلف مسئول است
سه اکتینومیستی که بیشتر از بقیه برای تواناییها و فعالیتهای سلولیتیک مطالعه شدهاند عبارتند از: ،استرپتومایسس میکروبیسپورا و ترمومنوسپورا استرپتومیسسها نسبت به اکتینومیستها بیشتر مورد توجه واقع شدهاند بخاطر اینکه 85 آنتی بیوتیکها از آنها بدست می آید.
تصویر شماره 35

حداقل 500 سویه استرپتومایسس شناخته شده است تعدادی از سویه های ترموفیلیک در خاک یافت میشوند حداکثر هیدرولیز کربوکسی متیل سلولز در 6/5 pH و درجه حرارت 55 درجه سانتیگراد اتفاق می افتد و مخلوطی از ،گلوکز سلوبیوز و اولیگوساکاریدها آزاد میشوند Sthermovulgaris در طول رشد روی پودر سلولز ، CMC و مواد اولیه متعدد غیر سلولزیک (مثل ،آرابینوز ،پیرووات، مالات و سیترات حداقل 5 جزء سلولیتیک شامل آندو گلوکاناز اگزو گلو کاناز و سلوبیاز را تولید می.کند این اکتینومیستهای
تصویر شماره 36
ص: 98
ترموفیلیک بطور اولیه در فضولات مختلف حیوانی که شامل حدود %40 سلولز میباشد وجود دارند. بعضی از سویههای ترموفیلیک میتوانند همی سلولز را تجزیه کنند تجزیه لیگنین نیز توسط استرپتومایسسها اتفاق می افتد. سویه های استرپتومایسس های سلولیتیک دیگر مانند S.lividans و S.flavogriseus در مقابل حرارت مقاومند تر موتولرانت) اما پایداری سلولاز آنها در برابر حرارت ضعیف .است تصویر شماره 36 مربوط به منظره کلنی یکی از استرپتومیستهای خاکزی است.
در سال 1986 Microbispora bispora در زنجیره باکتریهای تجزیه کننده ی سلولز معرفی شد اندو گلو کاناز خارج سلولی و سلوبیوهیدرولاز ویژگی مشابه با ترشحات قارچهایی مانند Trichoderma reesei دارد.
جنسهای ترمومنوسپورا بطور کلی از طریق Henssen شرح داده شده اند که بطور کلی شامل 5 سویه میباشند ترمومنوسپورا شامل اکتینومیستهایی است که دارای اسپورهای منفرد و حساس به حرارت روی هیفهای هوازی با دیواره سلولی که شامل Meso-diaminopimelic acid میباشد اما فاقد قندهای اختصاصی در ساختمان خود هستند.
هیدرولیز سلولز از طریق E1 بطور عمده سلوبیوز با مقدار کمی گلوکز آزاد میکند در حالیکه E2 مخلوطی از گلوکز سلوبیوز سلوتریوز و اولیگومرهای بیشتری تولید میکند
اگرچه سویه های ترمومنوسپورا یک کمپلکس کامل سلولاز تولید میکنند آنها قادر هستند سلولز کریستالین را تجزیه کنند. اگر چه نسبت مصرف سلولز در کشت اکتینومیست ترموفیلیک ممکن است بیشتر از کشت قارچی باشد
ص: 99
تصویر شماره 37

باسیلوسها دارای فعالیتهای آمیلولیتیک (تجزیه کننده ی مواد نشاسته ای و پروتئولیتیک تجزیه کننده ی مواد پروتئینی هستند و تمام گونه های آن آنزیمهای خارج سلولی ترشح میکنند تمام سویه های باسیلوس استئار و ترموفیلوس و 85 از سویه باسیلوس کوآگولانس و 50٪ از سویه باسیلوس لیکنیفورمیس آنزیم سلولاز پایدار در برابر حرارت تولید می.کنند پدیده همولیز گلبولهای قرمز در محیط کشت مربوط به باسیلوس سرئوس در تصویر شماره 37 مشاهده میشود
تصویر شماره 38 سلولوموناس
بر اساس همولوژی Y DNAگونه را در بر میگیرد. آنها ممکن است از منابع طبیعی در محیط آزمایشگاه در دمای 3035 درجه سانتیگراد تحت شرایط هوازی روی محیط نمک های معدنی شامل عصاره مخمر و سلولز جدا شوند کشتهای جوان اشکال میله ای بوجود می آورند که بطور ضعیف گرم مثبت میباشند تصویر شماره 38 بیشتر مطالعات ژنتیکی و فیزیولوژیکی روی گونه هایی از قبیل firmi و uda . متمرکز شده است. .C biazotea هنگامی که روی مواد اولیه سلولوزیک طبیعی یا مصنوعی رشد میکند سطوح آنزیمهای همی سلولیتیک و سلولیتیک سلولی و خارج سلولی بیشتری از گونه های دیگر تولید می.کند
ص: 100
اگرچه درجه حرارت مناسب برای سلولازهای سلولوموناس در دامنه 50-40 درجه سانتیگراد میباشد ولی پایداری آنها در این درجه حرارت تحت شرایط آزمایش بخاطر فقدان مواد اولیه کم است.
اعضای جنس سل ویبریو هوازی و گرم منفی هستند دارای سلولهای تاژکدار قطبی بوده که ممکن است از خاک توسط تکنیکهای توسعه یافته با استفاده از نمکهای معدنی میکروکریستالین محیط سلولز و در دمای 28 درجه سانتیگراد جداسازی شوند سلولازهای خارج سلولی از gilvus . تخلیص شده و چهار اندو گلوکاناز شناسایی شده است.
آنزیمها فیبرهای پشمی را به آرامی تجزیه می.کنند تماس فیزیکی بین سلولها و فیبرسلولزی برای تولید آنزیم سلولاز به مقدار زیاد ضروری است اگرچه فعالیت ویژه CMCase در هر سلول در حدود همان است که رشد روی غلظت محدود سلوبیوز یا فیبرهای سلولز است اما تولید سلولازها در محیط کشت حاوی
سلولز بیشتر است.
این جنس ها تقریباً 100 گونه گرم منفی هوازی و میلهای شکل متحرک را در بر می گیرند (تصویر شماره (39 و تنوع وسیعی دارند کربوهیدراتها و آمینو اسیدها را بعنوان منبع انرژی مصرف میکنند تعدادی از سویه ها میتوانند ترکیبات آروماتیک مانند بنزوات و سالیسیلات را استفاده کنند اگرچه گونه های سلولیتیک آنچنان رقیب هوازیهای گرم منفی دیگر مانند سلولوموناس نیستند و گروهی از مواد پوسیده و در حال فساد را بیشتر جذب میکنند.
تصویر شماره 39

ص: 101
بیوسنتز سلولاز در سودوموناس فلورسنس وارتیه سلولزا (Psendomonas fluorescens var. cellulosa) از طریق القاء و نیز بازدارندگی کاتابولیک کنترل می.شود سوفوروز» و «ایزومالتوز » القاء کننده تر از سلوبیوز و
معادل با سلولز میباشند.
استوویبریو سلولولیتیکوس Acetovibrio cellulolyticus یک باکتری گرم منفی بدون اسپور و بی هوازی میباشد و از کشتهای غنی از فاضلاب متانوژنها و در محیط حاوی نمکهای معدنی - ویتامین سلولز آگار شامل 80 نیتروژن و 30 دی اکسید کربن در دمای 35 درجه سانتیگراد جداسازی شده است. A. cellulolyticus پلئومورف می،باشد به شکل رشته ای و مستقیم به عرض 0/9m 0/5 و طول 410m میباشد. محل قرارگیری تاژک - mu آن حدود 1/3 انتهایی سلول و حرکتی شبیه به رقصیدن دارد. A. celluloyticus به آرامی روی گلوکز رشد می یابد در حالیکه برخی گونههای دیگر روی فروکتوز ،گالاکتوز ،لاکتوز ،مالتوز ،مانیتول مانوز و پیرووات بخوبی گلوکز و پکتین رشد میکند اما نمیتواند از سلوبیوز استفاده کند و سلولز را تجزیه نمی.کند مقداری اتانول در طی رشد روی سلولز تولید میشود اما حساسیت زیاد سلول ها به اتانول مانع تخمیر مستقیم سلولز میشود.
اعضای این جنس مزوفیلیک و بدون اسپور گرم منفی و بی هوازی هستند تصویر شماره (40 تعدادی از گونهها اعضای سلولیتیک فلور نرمال جهاز هاضمهی نشخوار کنندگان میباشند B succinogenes. انواع آنزیمهای سلولیتیک را تولید می.کنند فعالیت سلولیتیک در سه شکل وجود دارد حدود 60 مربوط به قطعات غشایی می،باشد 10 بعنوان آنزیم غیر قابل رسوب با وزن ملکولی بیشتر از 106×4 و 30% بعنوان شکل آزاد با وزن ملکولی 45000 میباشند.
تصویر شماره 40 باکتروپیدس فراجیلیس :

ص: 102
باکتری فوق العاده بی هوازی و ترموفیلیک می.باشد یکی از گونه های آن Caldocellum saccharolyticum .است. اخیرا از استخرهای آب گرم هلند از طریق محیط کشت حاوی سلولز میکروکریستالین در دمای 75 درجه سانتیگراد جداسازی شده است. Csaccarolyticum میتواند انواعی از سوبستراهای غیر محلول از جمله سلولز میکروکریستالین پولپهای چوب مغز و ساقه چوب و مواد همی سلولزیک را تجزیه کند
این جنس حداقل 85 گونه شناسایی شده را در بر می گیرد. در رنگ آمیزی گرم بصورت باسیلهای گرم مثبت و سیلندری شکل دیده میشود تصویر شماره .(41 کلستریدیوم در ،خاک فضولات حیوانات اهلی و وحشی و رستنیهای پوسیده وجود دارد اسپورهایشان برای دورههای طولانی تحت شرایط سخت باقی می ماند. عمده آنها مزوفیلها هستند. اگر چه بعضی مانند C thermocellum و C hydrosulfuricum بهترین رشدشان در 60-70 درجه سانتیگراد می،باشد بیشتر گونه ها بی هوازی هایی اجباری .هستند بعضی از آنها هنگامی که در معرض اکسیژن کافی قرار میگیرند قابلیت رشد در حضور هوا را پیدا می.کنند حضور گسترده ی آنها روی مواد پوسیده گیاهی در طبیعت نشان دهنده توانایی تولید انواع آنزیمهای خارج سلولی دپلیمریزه کننده می باشد. با وجود این فقط حدود %12 گونههای شناخته شده را برای آنزیمهای اختصاصی خارج سلولی مانند آمیلازها سلولازها و پکتینازها مورد مطالعه قرار داده اند. C. thermocellum و stercorarium . دو گونه از باکتریهای سلولیتیک بی هوازی و ترموفیلیک می باشند
تصویر شماره 41

آنزیم ها در سه شکل وجود دارند که نسبت گوناگونی با سن محیط کشت و ماهیت منبع کربنی دارند. در کشتهای جوان رشد یافته روی سلولز بیشتر فعالیت آنزیم وابسته به سلول یا وابسته به سوبسترا است
ص: 103
همچنان که کشتها بالغ و سلولز قابل حل میشوند مقدار بیشتر آنزیم را میتوان در مایع آزاد شناسایی و ردیابی نمود.
8 گونه شناخته شده در جنس Ruminococcus» وجود دارد اینها کوکسیهای گرم منفی بی هوازی و مزوفیلیک هستند که در روده کور و روده بزرگ انواعی از حیوانات وجود دارند و موجب تخمیر سلولز و پلی ساکاریدهای دیگر می گردند.
خانواده با سیلاسه (Bacillaceae ) و جنس باسیلوس گروهی از باکتریها هستند که تولید کننده ی آنزیم سلولاز میباشند
این خانواده شامل باکتریهای درشت گرم مثبت و اسپوردار میباشد که برخی از آنها هوازی بعضی میکروآئروفیل و عده ای از آنها نیز بیهوازی هستند در این گروه شش جنس زیر وجود دارد
-1 جنس باسيلوس (Bacillus) که شامل باسیلهای هوازی یا بی هوازی اختیاری بوده و کاتالاز مثبت هستند.
2 اسپورولاکتوباسیلوس (sporolactobacillus) که باسیلهای میکرو آئروفیل بوده و کاتالاز منفی میباشند
-3 کلستریدیوم (Clostridum) که باسیلهای بی هوازی بوده و سولفات را احیاء نمی نمایند.
-4 دسولفوتو ماکولوم (Desulfotomaculum) که باسیلهای بی هوازی بوده و سولفات را احیاء می نمایند و برای انسان بیماری زا نیستند
-5 اسپرو سارسینا (sporosarcina) که هوازی بوده و بشکل گرد است و چون دارای اسپور میباشد آن را در این گروه قرار داده اند.
6- اسیلوسپیرا osillospira) که باسیلهای بی هوازی میباشند
در این جنس تعداد زیادی باسیلهای درشت گرم مثبت و اسپوردار وجود دارد که در طبیعت فراوانند زیرا
ص: 104
اسپور آنها در برابر عوامل خارجی مقاومت زیادی دارد و بقای نسل آنها را تامین می.کند. باسیلوسها اهمیت زیادی از لحاظ پزشکی و اقتصادی دارند تنها گونه باسلیوس آنتراسیس (B. anthracis) برای انسان و بعضی از حیوانات بیماریزا بوده و ایجاد بیماری سیاه زخم (Anthrax) را مینماید. سیاه زخم یکی از نخستین عفونتهای باکتریایی است که عامل اتیولوژیک(مسبب) آن دقیقاً شناخته شده است. بعضی از آنها مانند باسیلوس سرئوس (B. cereus) ایجاد مسمومیت غذایی می.کنند برخی نیز به علت قدرت تخمیری زیاد باعث تجزیه مواد قندی و پروتئین شده و باعث فساد و گندیدگی مواد غذایی میگردند
تعدادی از آنها نیز در تهیه آنتی بیوتیکها استفاده میشود که برخی از این آنتی بیوتیکها نظیر پلی میکسین و باسیتراسین مصرف بالینی پیدا کرده اند تعداد بسیاری از آنها بحالت ساپروفیت در هوا، خاک، آب، شیر، سبزیجات، گردو غبار مدفوع و... زندگی میکنند که از نظر شکل ظاهری و رنگ آمیزی به باسیل آنتراسیس شباهت دارند و بنام انتراکوئید نامیده می.شوند گونه های دیگر از نظر تولید حلالها الكلها آنزیمها و ویتامینها اهمیت پیدا کرده اند. یکی از مشخصات بارز این جنس دامنه وسیع مقدار درصد CG در مولکول DNA در گونه های مختلف میباشد که از 32 تا 62 مول درصد متغیر میباشند و با اطلاعاتی که در مورد معدود بودن مقدار CG در سایر باکتریها بدست آمده این یافته مغایر است دامنه وسیع CG وجود ناهمگونی گونه ها را در این جنس منعکس می سازد
باسلیوسها از نظر نوع متابولیسم نیازمندی غذایی و ترکیب و ساختار دیواره در سلولهای رویشی گوناگونی نشان می دهند. در این جنس گونه های سرما دوست مزوفیل و ترموفیل همچنین قلیایی دوست اسید دوست و خنثی دوست نوتروفیل دیده میشوند گونههای شناخته شده جدید آنزیمهای برون سلولی محلول متنوعی تولید میکنند که این خود نشانه گوناگونی شرایط زیستگاهی آنها میباشد به علت هتروژن بودن انواع این جنس روشهای مختلف طبقه بندی تاکنون ارائه گردیده است که هیچ کدام رضایت بخش نمی باشد زیرا این باکتریها از نظر درصد CG متابولیسم ،تغذیه ترکیب دیواره سلولی درجه حرارت و pH مناسب برای رشد بسیار متنوع هستند در طبقه بندی برجی (bergey) در سال 1986 بیش از 50 نوع شرح داده شده است و به طور کلی در بیشتر منابع 34 گونه برای این جنس بیان کرده اند با توجه به کاربرد فراوان صنعتی این باکتریها اطلاعات ژنتیکی و فیزیولوژیک بسیاری در مورد جنس باسیلوس جمع آوری شده است. در آزمایشگاه های میکروبیولوژی بالینی گونه های باسیلوس به عنوان عامل اتیولوژیک مسمومیت غذایی و عامل عفونت در معتادان به هروئین به عنوان پاتوژن مهم در بیماران دارای نقص ایمنی موجب گردیده که در شناسایی آنها دقت بیشتری به عمل آورند. برخی از گونه های جنس باسیلوس روی محیطهای حاوی یک منبع کربن آلی براحتی رشد میکنند ولی در محیطهای حاوی نمکهای معدنی به آمینواسیدها و ویتامینها نیز نیاز دارند.
ص: 105
براساس آخرین طبقه بندی جنس باسیلوس که در چاپ سال 1986 کتاب برجی آمده است جنس باسیلوس به 34 گونه مختلف طبقه بندی شده است از این گونههای مختلف ذکر شده از جنس باسیلوس تنها دو گونه از لحاظ پزشکی حائز اهمیت میباشند. گونه باسیلوس آنتراسیس عامل بیماری خطرناک سیاه زخم و باسیلوس سرئوس عامل مسمومیت ،غذایی سایر گونه ها یا ساپروفیت بوده و یا به صورت پاتوژن فرصت طلب محسوب میشوند. دسته ای از این باسلیوسها ممکن است به علت شباهت از نظر شکل اندازه و رنگ آمیزی به باسیل شاربن سیاه زخم با آن اشتباه شوند که به این باسلیوسها آنتراکوئیدها .گویند اغلب این باسیل ها سا پروفیت بوده ولی بعضی از آنها مانند با سلیوس سوبتیلیس و سرئوس در انسان بیماریهایی از قبیل ورم ملتحمه اندوکاردیت یا مسمومیت غذایی ایجاد میکنند
باسیلوس اسفریکوس particus . مننژیت خطرناک باسیلوس برویس (B.brevis) زخم قرنیه باسیلوس سیرکولانس (B.circulans) مننژیت، باسیلوس کوآگولانس (coagulans . زخم ، قرنیه، باسیلوس لیکنی فرمیس (Bicheniformis باکتریمی و سپتی سمی باسیلوس مگاتریوم (B. megaterium) فارنژیت و برخی از انواع نیز پنومونی بوجود میآورند تعدادی از آنها نیز برای حشرات بیماریزا می.باشند با برخی از این باسیلها نیز آنتی بیوتیک تهیه می.شود. باسیلوس سوبتیلیس (Bubtilis در ،هوا ،خاک آب آلوده و سبزیجات وجود دارد و معمولاً در آزمایشگاه ها باعث آلودگی محیط کشت میشوند علاوه بر این میتوانند عفونت چشم و باکتریمی تولید نمایند. از اسپور استئارو ترموفیلوس (tearothermophilus . . . برای تعیین میزان استریلیزاسیون در اتوکلاو و سایر دستگاه ها استفاده میشود گونه های باسیلوس سوبتیلیس باسیلوس ليکنیفورمیس B. licheniformis)، باسیلوس پومیلوس (B. pumilus)، باسیلوس استئاروترموفیلوس (B stearothermophilus و باسیلوس کوآگولانس (B. coagulans) در تولید ترکیبات سلولزی و سنتز آنزیم سلولاز فعالیت دارند.
بررسی خصوصیات گونه های سلولیتیک
کلنی های این باکتری روی محیط آگاردار گرد یا نامنظم باسطح کدر و مات است بر روی محیط آگار خوندار در اطراف ،کلنی همولیز نشان میدهد (تصویر شماره 43 کلنی ها ممکن است چروکیده و شاید به رنگ زرد یا قهوه ای باشند در محیط 1 گلوکز رشد کرده و کلنیهای سطحی ضخیم که اغلب چین دار و قهوه ای است دیده می.شود ممکن است یک سطح پیگمان مایل به قرمز در زیر منطقه رشد تولید کند به صورت عمقی شروع به رشد
ص: 106
میکند اما رشد آن به سرعت متوقف می.شود پکتین و پلی ساکاریدهای بافتهای گیاهی را تجزیه میکند و برخی استرینهای آن موجب فساد در غده های سیب زمینی می.شود پیگمانها به عنوان ملانین ها یا (pulcherrimin) ممکن است در کلنیها یا محیطهای مجاور تولید شوند. در بسیاری از استرینها این پیگمانها قهوه ای یا قرمز و در موارد کمتری نارنجی یا سیاه میباشند تولید هر پیگمانی بستگی به ترکیب محیط کشت دارد.
تصویر شماره 42 منظره میکروسکپی باسیلوس سوبتیلیس

محیطهای کشت ،حداقل برای رشد رویشی باکتری فاقد ویتامینها و شامل گلوکز و یک نمک آمونیم به عنوان تنها منبع کربن و نیتروژن میباشند هوازی هستند و خیلی محدود در شرایط بیهوازی در محیطهای کمپلکس رشد می.کنند بیشترین رشد را در حضور اکسیژن دارا میباشند. میزان درصد CG آنها بین 47/5 - 41/5 درصد برای 31 ،استرین 46/3 - 41/8 برای 34 استرین و برای بقیه استرینها 42/9 درصد گزارش شده است
تصویر شماره 43
تصویر شماره 44
ص: 107
کلنی های این باکتری با سطح کدر و خشن در محیط آگاردار می.باشد عموماً برآمده و شبیه به مو (Hair-like) باشند. معمولا خیلی محکم به سطح محیط آگار چسبیدهاند پهن و برجسته و شامل مقدار زیادی لعاب بوده که اغلب روی کلنی انباشته است و به طور اختصاصی روی محیط آگار گلوکز دار و یا گلوتامات – گلیسرول آگار (glutamate glycerol agar) وجود دارد پلی پپتید گلوتامیل (glutamyl) به عنوان یک لعاب بی شکل خارج سلولی تشکیل می.شود پیگمان قرمز بوسیله خیلی از استرینها روی محیطهای کربوهیدرات که شامل آهن کافی باشد تشکیل میشود که در کشتهای کهنه ممکن است قهوه ای شود فرشلی (Freshly) استرینهایی را که در حضور آمونیا (ammonia به عنوان تنها منبع نیتروژن در غیاب فاکتورهای (رشد رشد کرده بودند جدا سازی کرد اشکال رویشی در بسیاری غذاها بویژه اگر در دمای 30-50 درجه نگهداری شده باشند رشد می.کنند درصد CG آنها 49/9-42/9 درصد برای 12 استرین 46/4 - 44/9 درصد برای 19 استرین و برای بقیه استرینها 46/4 درصد گزارش شده است.
کلنی های این باکتری خیلی متنوع میباشد نیاز به بیوتین دارد و در برخی استرینها نیاز به آمینو اسیدها نیز وجود دارد. میزان درصد CG مولکول DNA آنها 45/1-3 درصد برای 12 ،استرین 46/9-40 درصد برای 25 استرین و برای بقیه استرینها 41/9 درصد گزارش شده است.
بارزترین مشخصه تشخیصی آنها ظرفیت رشد در دمای 65 درجه سانتیگراد و محدودیت تحمل اسیدها میباشد. در خاک گرد و غبار رسوبهای اقیانوس آبهای قطب شمال غذا و کودها وجود دارند میزان CG ملکول DNA آنها 62/2-43/5 درصد برای 19 استرین، 52-46 درصد برای 7 استرین و برای بقیه استرینها 51/9 درصد گزارش شده است
تنوع مورفولوژیکی این گونه قابل توجه است دارای نیازهای غذایی متنوع و دمای انکوباسیون مختلف میباشد برای رشد به چندین آمینواسید و ویتامین نیاز دارد. اسیداوریک برای محدود کردن رشد مناسب آنها، سطح pH را در حدود 6 نگه می.دارد حداقل pH بین 5-4 و برای استرینهای مختلف متفاوت است. میزان درصد
ص: 108
C+G مولکول DNA آنها 50/3-44/3 برای 7 ،استرین 56-45/6 برای سه استرین و برای بقیه استرینها 47/1 گزارش شده است.
نقش اکولوژیکی باسیلوس ها به عنوان تجزیه کنندگان تودههای پلیمری شناخته شده است. بهر حال گونه های مختلف باسیلوسها با حضور فراگیرشان و قابلیت آنها در ترشح دامنه وسیع و متنوعی از آنزیمهای دپلیمر کننده تجزیه کننده پلیمرها ظاهراً فقط به صورت جانبی و حاشیه ای به عنوان تجزیه کنندگان سلولز مطرح می باشند فعالیتهای پروتئولیتیکی تجزیه کننده (پروتئین و آمیلولیتیکی تجزیه کننده نشاسته باسیلوسها خیلی زودتر تشخیص داده شده بود (1953) Allen و مطالعات بعدی نشان داده است که همه گونه های باسیلوسهای شناخته شده، آنزیمهای خارج سلولی ترشح می کنند (1977 Priest).
پروتئازها و آمیلازهای تولید شده توسط باسیلوسها محاسبه شده و نشان داده شده است که بیش از نیمی از حجم کل آنزیمهای تجارتی را تشکیل می دهند. 1982 و Cruger Draeger ، اما اخیراً نقش دومی برای این ارگانیسمها تعیین شده است که باسیلوسها را با سلولایتیکهای برجسته و بی هوازی و گرما دوستی از قبیل کلستریدیوم ترموسلوم (Clostridium thermocellum مورد مقایسه قرار میدهد بهرحال زمک (zemek) و همکارانش در سال 1981 نشان دادهاند که 11 گونه از 25 گونه باسیلوسها آنزیم - B1 glucanase 4 را ترشح می.کنند همه استرینهای باسیلوس استئاروتر موفيلوس (B, stearothermophilus) 85 از استرینهای باسیلوس کوآگولانس (B.coagulans) و 50 از استرینهای باسیلوس لیکنیفورمیس .B) licheniformis) (سه گونه ای که بخوبی در درجه حرارت 60-50 درجه سانتیگراد رشد می کنند) (1974 Gibson Gordon ترکیبات سلولازی مقاوم به حرارت تولید می.کنند فوکوموری و همکارانش (Fakumori) در سال 1985 تولید ترکیب سلولزی CMCase را در یک گونه باسیلوس آلکالوفیل قلیایی (دوست) شرح داده اند. باسلیوسهای مقاوم به حرارت به طور ویژه ای علاقمند به تولید سلولازهایی با حداکثر pH مناسب میباشند. اخیراً کاوائی و همکارانش (Kawai et al در سال 1988 یک CMCase قلیایی را که از یک استرین مشابه به باسیلوس پومیلوس (milus ) جدا شده را شرح داده است. این آنزیم دارای pH مناسبی در حدود 10 می باشد و در حدود 80٪ از حداکثر میزان فعالیتش را حتی در pH برابر 11 نیز حفظ می.کند این آنزیم همچنین نسبت به پروتئآزهای متنوع فلزات سنگین مواد ژلاتینی و دترجنتها (مواد شوینده مقاوم باشد. هوریکوشی و همکاران Horikoshi et a در سال 1984 یک استرین تقریبا همانند باسیلوس پاستئوری (pasteuri ) را از خاک جدا نمودند دو اندو گلو کاناز فعال روی سلوترائوز (Cellutraose) دارای
ص: 109
pH مناسب برابر 10 میباشند که در این pH بالا یکی از آنها به دمای 60 درجه و دیگری به درجه حرارت 80 درجه مقاوم میباشد. برخی از ترکیبات آنزیمی باسیلوسها تقریباً با منابع دیگر تمایل به جذب شدن به هم را دارند ولاسکو و همکارانش lasenko et al در سال 1985 به طور موفقیت آمیزی آنزیم B ماناناز (B-mannanase تولید شده توسط باسیلوس سوبتیلیس (B. subtilis) را با آنزیم سلولاز تولیدی توسط تریکودرما ریسه ای (Trichoderma reesei به طور همزمان برای تجزیه گلوکوموناز گیاهی بکار گرفتهاند. شاید مهمترین نقش گونههای باسیلوس در تغییر بیوتکنولوژی سلولز این باشد که سیستم بیان ژن برای آنزیم سلولاز را میتوان از دیگر گونه ها کلون کرد دوی و همکارانش Dietal) در سال 1986 مزایای باسیلوس سوبتیلیس (B. subtilis را برای تولید پروتئینهای بیگانه به شرح زیر بیان کرده اند
-1 غیر بیماریزا .است
-2- میتوان بوسیله روشهای رایج مهندسی ژنتیک آن را دستکاری کرد
3- فاقد دو اندوتوکسین یک نشانه مهمی در تولید پروتئینها برای مصارف پزشکی و مواد غذایی (است و تغییر مکانیسم پروتئینهایی است که ممکن است ایجاد آنزیمهای غیر فعال کند.
-4 خیلی راحت رشد میکند و میزان زیادی از پروتئینهایی را سنتز میکند که سیستم یوکاریوتیک قادر است سنتز کند.
-5 قادر است پروتئینهای متنوع زیادی ترشح ،کند بیشتر از آنچه که پروکاریوت های رقیب از جمله E-coli ترشح میکند
معایب باسیلوس سوبتیلیس (B. subtilis)
-1- گرایش باسیلوس سوبتیلیس به تولید چندین پروتئاز که قادر است پروتئینهای نامناسب را چه داخل
سلولی و چه خارج سلولی تجزیه کند
2- عدم تغییر سیستم برای برخی پروتئینهایی که نیاز به تغییرات پس از ترجمه برای فعالیتشان دارند.
-3- کاهش میزان صدور برای برخی پروتئینهای یوکاریوتیک
چنین مدلهایی دارای بیشترین پتانسیل موفقیت برای کلون نمودن و انتقال ژنهای سلولاز بین گونه های باسیلوس میباشند. اخیرا کیم و پاک Kim Pack در سال 1988 ژن آنزیم اندو گلوکوناز باسیلوس سوبتیلیس را به ژن آنزیم سلولاز منفی باسیلوس مگاتریوم (megaterium .. کون کرده اند. از آنجایی که باسیلوسها باکتریهایی واجد اندوسپور هستند که میتوانند شرایط محیطی نامساعد را
ص: 110
برای مدت زمان طولانی تحمل کنند با توجه به حضور فراگیر این جنس باکتریایی که دارای پراکندگی اکولوژیکی فراوان میباشند این باکتریها قادر خواهند بود در محیطهای واجد سوبسترای آنزیم سلولاز خساراتی وارد کنند و بدین جهت در صنایعی از جمله کاغذ سازی نساجی و صنایع چوب که عمدتاً ترکیبات سلولزی در ساختمان و مواد اولیه موجود است میتوانند با تولید آنزیم سلولاز زمینه تجزیه و فساد این ترکیبات را فراهم کنند اما این نکته قابل ذکر است که باسیلوسها را نمیتوان منبع و منشاء اصلی میکروبی (بیولوژیکی تولید آنزیم سلولاز دانست بنابراین خسارات و تجزیههای بیولوژیکی عمدتا به طور مختصر خواهد بود. با توجه به مطالب گفته شده در فوق شاید تاکنون کمتر از باسیلوسها در تولید صنعتی این آنزیم استفاده شده است.
ص: 111
ص: 112
اختلاف باکتریها و قارچها
طبیعت و ماهیت قارچها
خصوصیات قارچها
ساختمان رویشی
قارچهای ساپروب
طبقه بندی قارچهای ساپروب
احتیاط و مراقبتهای لازم در آزمایشگاه قارچ شناسی
روشهای آزمایشگاهی در مطالعات قارچ شناسی
آشنایی با خصوصیات ظاهری و میکروسکپی قارچهای آسیب رساننده

ص: 113
قارچها دارای اندازه بزرگتری نسبت به باکتریها هستند کوچکترین قارچ ها حداقل 2 میکرون قطر دارند در صورتی که قطر بزرگترین باکتری ها در حدود یک میکرون میباشند باکتریها فاقد هسته حقیقی و جزء موجودات پروکاریوت میباشند در صورتی که قارچها یوکاریوت بوده و دارای هسته مشخص با جدار معین هستند. قارچها نسبت به آنتی بیوتیکهای ضد باکتری مقاوم و باکتریها نسبت به مواد ضد قارچی (Anti mycotic) چندان مقاوم نیستند در ساختمان شیمایی دیواره سلولی قارچها سلولز، کیتین کالوز ، فوکوز و... بکار رفته است در صورتی که در ساختمان دیواره سلولی باکتریها مواد دیگری از قبیل گلیکوپپتیدها بکار رفته اند همچنین اسید مورامیک و اسید دی آمینوپیملیک در ساختمان دیواره سلولی باکتریها دیده میشوند تکثیر قارچها بوسیله تولید اسپور صورت میگیرد در صورتیکه در باکتریها عمدتا بطریق تقسیم دوتایی (Binary fission)، تقسیم و
تولید مثل صورت میگیرد
سلول قارچ مشخصات سلولهای یوکاریوت را دارد یعنی واجد یک هسته با کروموزوم های مشخص غشای هسته ای و ارگانهای سیتوپلاسمی مانند میتوکندری و شبکه اندوپلاسمیک میباشند. قارچ ها معمولا در حالت ها پلوییدی قرار دارند اگر چه حالت دیپلوییدی در نتیجه آمیزش هسته های آنها در جریان تولید مثل جنسی تشکیل می.شود
ساختمان سلول شامل دیواره سلولی سخت و محکم و یک غشاء سیتوپلاسمیک در بر دارنده ی ارگوسترول است به) تصویر شماره 31 رجوع نمایید در غشاء پلاسمایی پستانداران استرول ،غالب کلسترول میباشد ساختمان آنتی ژنیک و شیمیایی دیواره سلولی قارچها بطور قابل ملاحظه ای با باکتریها اختلاف دارد در دیواره سلولی باکتریها پپتیدو گلیکان اسیدهای تئوکوئیک گلیسرول یا لیپوپلی ساکارید بکار رفته است در صورتی که در ساختمان دیواره سلول قارچها پپتیدومانان گلوکان و کیتین بکار رفته است. پپتیدومانان پلیمرهای مانان میباشند که در سطح و در ماتریکس ساختمانی دیواره سلولی به صورت متصل با پروتئین بکار رفته است. آنها مشخصه های آنتی ژنیک مهمی هستند که در واکنشهای سرولوژیکی نقش اختصاصی دارند و این به علت ترکیب و نیز اتصالات و پیوندهای زنجیره های جانبی پلیمری میباشد. گلوکانها پلیمرهای گلوکوزیل هستند بعضی از آنها تشکیل فیبریلها را میدهند که اغلب در ارتباط نزدیک با کیتین بر قدرت و استحکام دیواره سلولی قارچ می افزاید
کیتین از زنجیره های طولانی و بدون انشعاب پلی ان استیل گلوکزامین تشکیل شده است. کیتین ماده بی اثر نامحلول و سخت و محکم است و دارای عمل حمایتی و نگهدارنده تشکیلات ساختمانی در حالتی مشابه با کیتین پوسته خرچنگها یا سلولز گیاهان میباشد. کیتین جزء اصلی و عمده دیواره سلولی قارچهای رشته ای است.
ص: 114
متابولیسم قارچی هتروتروفیک است و به منابع انرژی خارجی نیاز دارد تنوع متابولیکی زیادی وجود دارد اما اغلب قارچها در حضور یک منبع آلی کربن و یونهای آمونیم یا نیترات بعنوان منبع نیتروژن قادر به رویش هستند. در طبیعت مواد غذایی برای قارچهای گند رو از طریق مواد آلی در حال فساد تأمین میشود. یک اختلاف عمده بین قارچها و گیاهان این است که قارچها فاقد مکانیزمهای تولید انرژی فتوسنتتیک هستند اغلب قارچها بطور مشخص هوازی اند اگر چه بعضی از آنها در وضعیتهای غیر هوازی میتوانند رشد نمایند.
در حال حاضر بیولوژیستها واژه ی قارچ یا fungus را به موجوداتی اتلاق میکنند که
فاقد کلروفیل بوده، تولید اسپور میکنند سلولهای آنها واجد هسته حقیقی است، عموماً بوسیله زاد آوری جنسی و غیر جنسی تکثیر می یابند در ساختمان شیمیایی غشاء سلولهای رشتهای آنها سلولز و یا کیتین و یا هر دو آنها دخالت دارد و به آنتی بیوتیکهای ضد باکتری مقاوم هستند
تعداد کمی از آنها در انسانهای سالم از نظر سیستم ایمنی قادر به ایجاد بیماری هستند. این بیماریها تحت نام میکوز دارای اشکال کلینیکی و میکروبیولوژیکی خاص خود میباشند باید خاطر نشان ساخت که تعداد قارچهایی که در انسانهای دارای سیستم ایمنی آسیب دیده قادر به ایجاد بیماری و اختلالات سلامتی هستند زیاد است و در مطبوعات پزشکی شاهد افزایش روز به روز در لیست این بیماریها هستیم قارچها نسبت به باکتریها دارای پیچیدگی بیولوژیکی بیشتری میباشند آنها درجه ای از تمایز بطرف ارگانیسمهای پر سلولی مشابه با گیاهان از خود نشان میدهند
میکوزها در نشان دادن علائم و تظاهرات خود به مقدار وسیعی با یکدیگر اختلاف دارند اما تمایل دارند که اشکال تحت حاد و یا ،مزمن آرام و کم سر و صدا و عود کننده ای را نشان دهند و بیماری حاد مانند آنچه که به علت بسیاری از ویروسها و باکتریها پدید می آید در عفونتهای قارچی شایع نیست.
واژه مایکولوژی (Mycology) به معنای قارچ شناسی ترکیبی از دو ریشه mykes = به معنی قارچ و logus= به معنی شناخت و شناسایی میباشد
علم قارچ شناسی تا قبل از اختراع میکروسکپ عمدتاً به مطالعه بر روی قارچ های کلاهکدار می پرداخته است. در قرن هفدهم بعد از اختراع میکروسکپ توسط وان لیون ،هوک شناسایی قارچها بویژه از نظر طبقه بندی توسط دانشمندان شروع گردید اولین کسی که علم قارچ شناسی را پایه گذاری کرد یک گیاه شناس ایتالیایی بنام پیرآنتونیو میشلی Pier Antonio micheli بود که در سال 1729 میلادی نشریه ای تحت عنوان Nova plantarum genera منتشر نمود که شامل تحقیقات وی روی قارچها بود.
ص: 115
رشد و مرفولوژی قارچ
اندازه سلول قارچی در انواع مختلف آنها بطور قابل ملاحظه ای با هم فرق میکند یک سلول منفرد بدون دیواره عرضی ممکن است از 2 تا 4 میکرون تا اندازه ای که با چشم غیر مسلح قابل مشاهده باشد متفاوت باشد اشکال مرفولوژیک قارچها از رویش کلنیهای مشابه با کلنیهای باکتریایی تا تشکیل ساختمانهای زیبای رنگارنگ و فوق العاده پیچیده در طبیعت دیده میشود که قارچهای کلاهکدار مثالی از این بابت می.باشند ساده ترین طریقه رویش تشکیل و تولید جوانه است که از سلول مادری گرد یا بیضوی بصورت عمده در مخمرها پدید آمده، سپس کوتاه و منقبض گشته و یک سلول جدید را تشکیل میدهد این جوانه ها بلاستوکنیدی یا بلاستوسپور نامیده میشود و قارچهایی که به این حالت تولید مثل مینمایند مخمر نامیده میشوند. قارچها در نتیجه گسترشهایفا نیز رشد می.کند هایفا عناصر لوله ای شکل بوده که دارای دیواره موازی و ضخیم هستند همانطور که هایفا رشد میکند توده در همی را ایجاد مینماید که میسیلیوم خوانده میشود اغلب قارچها دارای دیواره عرضی یا سپتوم میباشند که هایفا را به واحدهای فرعی تر تقسیم میکند برخی از گونه ها فاقد دیواره عرضی هستند و هایفا و میسیلیوم آنها به شکل یک سلول واحد و بسیار طویل میباشند در قارچهای واجد دیواره عرضی و نیز در آنهایی که فاقد دیواره عرضی هستند هستههای چندگانه وجود دارد و نیز جریان آزاد سیتوپلاسم در سرتاسرهایفا و نیز از طریق سوراخ داخل دیواره عرضی شکل می گیرد بخشی از میسیلیوم رویشی معمولا به داخل محیط کشت یا سوبسترای آلی بعنوان) مثال خاک رشد کرده و عملی نظیر ریشه گیاهان دارند که به عنوان گیرنده مواد غذایی و رطوبت عمل مینماید سطح کلنی به علت رشد و توسعه میسیلیوم های رویشی که هوایی نیز نامیده میشوند، کاملاً کرکی و پرزآلود به نظر میرسد. دیواره هایفا به قدر کافی سخت و محکم است که از این شبکه در هم پیچیده میسیلیومها حمایت نماید در این رده از قارچها هایفای هوایی بر روی خود ساختمانهای تولید مثلی زایشی) را پدید می آورد. بعضی از قارچها ساختمانهایی را به نامهایفای کاذب پدید می آورند که اختلاف آنها باهایفای حقیقی در این است که که دیواره سلولی در آنها به سختی دیواره سلولی هایفای حقیقی نیست و اشکال شبیه به جوانه در طول هایفا تولید مینمایند.
کونیدیا و اسپور کپکها و ساختمانهایی که تولید کننده این اسپورها و کونیدیاها هستند دارای تنوع زیادی در اندازه شکل و ارتباط آنها باهایفای مولد هستند و مرفولوژی این ساختمانها اولین پایه و اساس شناسایی کپکهای مهم از پزشکی میباشد. ساختمان میسیلیوم نیز تا حدودی به شناسایی قارچ کمک میکند بسته به اینکه آیاهایفا دیواره عرضی
ص: 116
دارد یا خیر این اختلافات طوریکه بتوان گونههای قارچی را به کمک آنها شناخت به قدر کافی تمیز دهنده نیستند کونیدیای اگزوژنوس غیر جنسی ممکن است مستقیماً از هایفا خارج شود و یا اینکه بر روی ساختمان ساقه مانندی به نام کونید یوفور پدید آید گاهی اوقات واژه هایی مانند ماکروکونیدیا یا میکروکونیدیا برای نشان دادن اندازه و یا پیچیدگی این کونیدیاها بکار میرود کونیدیایی که در داخلهایفا بوجود میآید
کلامیدو کونیدیا» یا «آرتروکونیدیا» نامیده میشود «کلامیدو کونیدیا معمولا از هایفا بزرگتر میشود و ساختمانهایی بشکل گرد هستند و ممکن است در انتهای هایفا و یا در طول آن دیده شوند آرترو کونید یا از نظر شکل و اندازه بیشتر شبیه به واحدهای میسیلیوم میباشد و بشکل یک سری کونیدیاهایی که به دنبال هم قرار گرفته اند و میتوانند از هم گسسته شوند و پخش گردند دیده میشود .
عمده ترین یا به عبارتی مهمترین اسپور جنسی آسکوسپور می.باشد بطور کلی قارچها یا بصورت کپک یا بشکل مخمر رشد میکنند کپکها انتشار و تنوع بسیار زیادی دارند برخی از گونه ها تحت شرایط محیطی متفاوتی بصورت مخمر و کپک قادر به رشد میباشند این گونه ها تحت عنوان قارچهای دو شکلی (دیمورفیک) شناخته میشوند تعدادی از پاتوژنهای انسانی دی مورفیسم را نشان میدهند اینها در بافت عفونی شده به حالت مخمری و در محیط طبیعت و نیز در محیط کشت و دمای معمولی آزمایشگاه بصورت کپک دیده میشوند تبدیل فازهای مختلف آنها به یکدیگر تحت شرایط آزمایشگاهی امکانپذیر است . فازهای مخمری آنها نیاز به شرایطی مشابه به آنچه در محیط زنده وجود دارد مانند دمای بدن و محیط غنی شده دارند. فاز کپکی نیاز به مواد غذایی کمتر و دمای معمولی محیط دارد. اسپورهای غیرجنسی که در فاز کیکی تولید میشوند ممکن است مسبب عفونت و به انتشار قارچ کمک نمایند
تخمین زده شده است که تعداد گونه های شناخته شده قارچها متجاوز از یکصدهزار گونه است و سالانه حدود هزار و پانصد گونه جدید به این لیست اضافه میشود با توجه به اینکه قارچها موجوداتی هتروتروف دیگر) غذا هستند و در نتیجه قادر به ساختن مواد غذایی مورد نیاز خود نبوده و بلکه آن را باید از طریق موجودات زنده دیگر کسب ،نمایند بر حسب گرایش تغذیه ای و رشد آنها در بین موجودات مختلف به گروه هایی از قبیل فیتوپاتوژن رشد و تکثیر بر روی گیاهان زنده)، زوپاتوژن رشد و تکثیر در بدن جانوران ،زنده ساپروب رشد و تکثیر بر روی مواد آلی در حال فساد یا بقایای غیر زنده جانوران و گیاهان تقسیم بندی میشوند اکثریت قارچهای موجود در طبیعت را قارچهای بیماریزای گیاهی (فیتوپاتوژن) تشکیل میدهند و تعدادی از همین دسته از قارچها قادر به رشد و رویش بر روی کلیه مواد سلولزی و آلی هستند. از طرف دیگر برخی از همین قارچها قادر به ایجاد بیماری و عفونت در انسان نیز میشوند به همین دلیل در
ص: 117
این کتاب ضمن معرفی این قارچها به جنبههای بیماریزایی و مخاطرات انسانی آنها نیز اشاره شده است. عفونتهای حاصله از قارچها دارای طیف بسیار وسیعی بوده و بسته به محل ابتلا میتوان آنها را به پنج گروه عفونتهای سطحی ،جلدی مخاطی زیر جلدی و احشایی طبقه بندی نمود عفونتهای احشایی معمولاً کشنده هستند ولی عفونتهای سطحی و جلدی غالباً محدود و موضعی بوده و قابلیت بهبودی بیشتری را دارا میباشند امروزه در پزشکی قارچها را به دو گروه بیماریزا و فرصت طلب طبقه بندی مینمایند گروه اول قادرند که افراد سالم را گرفتار سازند ولی گروه دوم معمولا در افرادی که سیستم ایمنی آسیب دیده ای دارند ایجاد عفونت و بیماری میکنند با توجه به پیشرفت روزافزونی که در درمان و پیشگیری از عفونتهای قارچی بیماریزا صورت گرفته از موارد بروز آنها کم و بیش کاسته شده است ولی به همان نسبت بر موارد بروز عفونتهای ناشی از قارچهای فرصت طلب افزوده شده است. علاوه بر این با پیشرفتهای درمانی که در زمینه بیماریهای بدخیم بیماریهای خودایمنی و پیوند اعضاء فراهم شده موجب افزایش طول عمر بیمارانی گردیده است که از سیستم ایمنی سالم و طبیعی برخوردار نیستند بنابراین بیش از گذشته شاهد افزایش چشمگیر عفونتهای قارچی فرصت طلب هستیم عوامل قارچی این دسته از عفونتها در محیط اطراف محل کار و زندگی ما فراوان است کارمندان بخشهای حفاظت و مرمت آثار تاریخی و فرهنگی بیش از بقیه مشاغل مرتبط در معرض برخورد و تماس با اسپورهای این دسته از قارچها میباشند.
طبقه بندی امروزه قارچها براساس طبقه بندی ویتاکر (Whittaker (1969) است که بر طبق آن کلیه موجودات زنده را در پنج دودمان زیر طبقه بندی کرده اند
1- مونه را (Monera) شامل پروکاریوتها بوده و از جمله میتوان باکتریها اکتینومیست ها و جلبکهای سبز – آبی را نام برد.
-2- پروتوکتیستا (Protoctista) یوکاریوت بوده بعنوان مثال میتوان از پروتوزوآها و سایر موجودات تک سلولی و ارگانیسمهایی که بصورت گروهی زندگی میکنند مثل جلبکهای هسته دار کپکهای تاژکدار ،آبی کپکهای لزج سلولی و کپکهای لزج مشبک نام برد.
-3- قارچها (Fungi) یوکاریوت بوده و ارگانیسمهای فاقد تاژک هستند همه آنها از رویش اسپور پدید می.آیند می توان به مخمرها، کپکها (Molds) ، زنگ گیاهان و قارچهای کلاهکدار Mushrooms) اشاره کرد.
-4- گیاهان :(Plants) ارگانیسمهای یوکاریوت بوده که از سلول تخم جنین دار بوجود می آیند مانند خزه ها و گیاهان آوندی
-5 جانوران (Animals) ارگانیسمهای یوکاریوت هستند که از یک توده توخالی سلولی بنام بلاستولا
ص: 118
بوجود میآیند مانند اسفنج،ها مرجانها کرمها بندپایان و پستانداران
قارچهای ساپروب در محیط زیست انسان هوا ،آب، خاک و مواد غذایی بطور گسترده ای پراکنده بوده و موجب آلوده کردن مواد غذایی محصولات کشاورزی و نیز محیطهای کشت آزمایشگاهی میگردند و چون رشد سریعی دارند در شرایط آزمایشگاهی به سرعت محیط کشت را پوشانده و مانع رشد قارچهای بیماریزای اصلی می.گردند بعضی از این قارچها سا پروبهای فرصت طلب هستند که در افرادی که دارای اختلال در سیستم ایمنی خود میباشند ایجاد بیماری مینمایند در چنین مواردی برای اثبات بیماریزا بودن قارچ ساپروب میبایست شرایط زیر محرز شده باشد :
-1 باید عامل قارچی را بیش از یک بار از نمونه بیمار جدا کرد مثلاً در مورد نمونه خلط، بشرط آنکه چند نمونه خلط طی روزهای متوالی و بطور صحیح جمع آوری شده بموقع به آزمایشگاه رسیده و بلافاصله مورد آزمایش قرار گرفته باشد و قارچ ساپروب مورد نظر در تمام موارد در نمونه ها دیده شود.
2 نمونه بالینی یا ماده بیولوژیکی بدست آمده منظره و حالت بیماری زایی پاتولوژیک داشته باشد در مثال فوق خلط منظره عادی و طبیعی نداشته و بلکه چرکی بلغمی دارای رگه های خونی و یا واجد دانه هایی به رنگ قهوه ای یا سبز یا سیاه باشد.
-3- علائم بیماریهایی که در تشخیص افتراقی با بیماری قارچی قرار میگیرند بوسیله آزمایشات تکمیلی دیگر مانند رادیولوژی و آسیب شناسی رفع گردد.
-4- هایفا یا میسیلیومهای قارچی و در مواردی دستگاه زایشی و یا اسپورهای قارچی در آزمایش مستقیم میکروسکپی در نمونهای که تازه تهیه شده است مشاهده شده باشد
میدانیم که در هر زمینه علمی طبقه بندی مطالعه و سرعت دستیابی به اطلاعات را تسهیل مینماید در این بخش دو گونه طبقه بندی مطرح شده است که در ادامه بحث از طبقه بندی نوع دوم همانند سایر کتابها استفاده می.شود
-1 روش اول طبقه بندی قارچهای ساپروب شایع
الف - قارچهایی که هیف آنها بدون دیواره عرضی است فیکومیست یا زیگومیست)، تولید مثل غیر جنسی با ایجاد اسپورانژیوم sporangium محتوی اسپور مشخص میشود و در تولید مثل
ص: 119
جنسی سلولهای جنسی زیگوسپور Zygospore بوجود می آیند.
-1 - آنهایی که بطور شایع از بیماران جدا میشوند
گونه های آبسیدیا موکور رایزوپوس
2- آنهایی که بندرت از بیماران جدا میشوند
گونه های سیرسینلا، کانینگهاملا سین سفالاستروم
ب- قارچهایی که هیف آنها واجد دیواره عرضی بوده و رنگی هستند (Dematiaceus)
-1 آنهایی که دارای ماکروکونیدیای چند سلولی با دیواره های فقط عرضی هستند
گونه های کوروولاریا، هلمنتوسپوریوم، اورئو بازیدیوم دیماتیوم هستروسپوریوم 2- آنهایی که ماکروکونیدیای چند سلولی با دیواره عرضی و طولی دارند
گونه های آلترناریا، اپیکوکوم، استمفیلیوم، اولو کلادیوم
3- آنهایی که دارای کونیدیهای تک سلولی میباشند
گونه های کلادوسپوریوم کونیدیهای زنجیره ای ساده یا منشعب، نیگروسپورا کونیدیهای منفرد در انتهای کونيديوفور)
ج- قارچهایی که هیف آنها شفاف و دارای تیغه میانی است
-1 تال زایشی آنها منشعب است و دارای ساختمان پنی سیلی یا مسواکی شکل هستند گونه های پنیسیلیوم اسکوپولاریوپسیس، پسیلومایسس، گلیوکلادیوم
-2- آنهایی که کونیدی یا اسپورهایشان بصورت مجتمع (Clump) برروی کونیدیوفورهای ساده یا منشعب ایجاد میشوند
گونه های تریکودرما، فوزاریوم، سفالوسپوریوم، تریکوتشیوم بوتریوسپوریوم
د- قارچهایی که تشکیل پیکنید یوم (Pycnidium) یا کلیستوتشیوم (Cleistothecium) می نمایند
گونه های آسپر جیلوس منوسپوریوم آپیوسپرموم، فوما کتومیوم و کتوفوما
ه- قارچ های ساپروبی که از لحاظ شکل ظاهری شبیه قارچهای بیماری زا میباشند
گونه های ژئوتریکوم مشابه) کوکسیدیوایدس ،ایمیتیس کرایزوسپوریوم) مشابه با بلاستومایسس
ص: 120
درماتیتیدیس)، سپدونیوم مشابه با هیستوپلاسما کپسولاتوم
-2 روش دوم طبقه بندی قارچهای ساپروب شایع:
در این روش قارچهای ساپروب شایع در دو دسته طبقه بندی میشوند:
الف - زیگومیستها zygomycetes
ب- هیفومیستها قارچهای شفاف که خود به دو گروه طبقه بندی میشوند:
-1- قارچهای بی رنگ Hyaline hyphomycetes
-2 قارچهای رنگی یا سیاه phaeohyphomycetes یا Dematiaceous fungi
الف - زیگومیست ها
میسیلیوم فراخ دارند که بندرت در آنها تیغه میانی دیده میشود رده ای از قارچهای حقیقی خاکزی با رشد سریع هستند که هیچگونه سلول متحرکی ندارند و عموماً ساپروب هستند با اتصال گامتانژیاهای (ساختارهای تک سلولی که گامت یا هسته گامت تولید میکنند معمولا مشابه اسپورهای غیر جنسی حاوی یک تا چندین اسپور غیر متحرک که روی اسپورانژیوفورهای ساده یا مرکب قرار دارند در آنها مشاهده میشود. بصورت غیر فعال توسط باد و باران و حیوانات منتشر میشوند تعدادی از قارچهای ساپروب شایع که در این دسته قرار دارند عبارتند از:
موکور رایزوپوس، آبسیدیا سین سفالاستروم، سیرسینلا، کانینگهاملا فیکومایسس پیلوبولوس، پیلایرا تامینه ،یوم هلیکوستیلوم، کتوکلادیوم کواندفورا، پیپتوسفالیس مورتیرلا، بازیدیو بولوس انتو موفتورا
ب-هیفومیست ها
-1 هیفومیستهای بی رنگ دارای میسیلیومهای واجد دیواره عرضی بوده و فاقد رنگدانه ملانین در دیواره ی سلولی چه در مقاطع بافتی و چه در محیط کشت میباشند. در این قارچها کونیدیاهای غیر جنسی روی کونیدیوفورها قرار دارند و فاقد پوشش محافظتی میباشند. تعدادی از قارچهای ساپروب شایع که در این گروه قرار دارند عبارتند از آسپر جیلوس، پنیسیلیوم اسکوپولاریوپسیس، پسیلومایسس آکر مونیوم، فوزاریوم ،سپدونیوم کرایزوسپوریوم گلیو،کلادیوم تریکودرما ورتیسیلیوم ،بیوریا بوتریتیس تریکوتشیوم اپیکوکوم کتومیوم و فوما.
-2- هیفومیستهای رنگی یا سیاه واجد رنگدانه ملانین در دیواره سلولی خود در محیط کشت و مقاطع بافتی میباشند تعدادی از قارچهای ساپروب شایع که در این گروه قرار دارند عبارتند از:
ص: 121
،آلترناریا ،هلمنتوسپوریوم در کسلرا ،نیگروسپورا کلادوسپوریوم ،کوروولاریا اولوکلادیوم استمفیلیوم اورئوبازیدیوم، سفالوتریکوم پیتومایسس هومیکولا رینو کلادیلا، استاکی بوتریس و تورولا
ساپروبهای قارچی نقش مهمی در تجزیه و فساد مواد آلی و در چرخه مواد غذایی در محیط طبیعی و کشاورزی دارند در واقع ترکیبات آلی طبیعی بسیار محدودی وجود دارند که توسط یک قارچ نمیتوانند مورد مصرف قرار گیرند از ساده ترین ترکیب آلی متان که توسط برخی مخمرها مصرف میشوند تا پیچیده ترین پلیمرها مانند لیگنین که توسط برخی از قارچهای عامل فساد چوب مورد استفاده قرار میگیرند اگر چه تجزیه سلولز توسط قارچها ممکن است در مقیاس جهانی بسیار مهم باشد زیرا سلولز (فراوانترین پلیمر طبیعی روی زمین حدود 40 درصد تمام مواد ساختمانی گیاهان را تشکیل میدهد تجزیه پلیمر توسط آنزیمهای خارج سلولی انجام میشود قارچهای مختلف در تجزیه انواع مختلفی از پلیمرها مهارت دارند بنابراین قارچهای ساپروتروف با توجه به قابلیتهای آنزیمی متفاوت خود روی مواد پیچیده و مخلوطی رشد میکنند علاوه بر خاصیت ،بیماریزایی قارچهای تجزیه کننده باعث فساد محصولات مفید مثل غذا، تیرهای
ساختمانی ،چرم پارچه کتاب و .... میشوند.
چنین فعالیتهای غیر مطلوب تحت عنوان واژه Biodeterioration گروه بندی میشوند در مقابل این اصطلاح واژه biodegradation نیز وجود دارد که به معنای فعالیتهای ساپروتروفیک عمومی تر قارچ ها است.
بعنوان مثال Serpula lacrymans) dry rot fungus عامل مهم فساد چوب در ساختمانهاست Sooty molds دودی سیاه ) کپکهای (سیاه مانند Aureobasidium pullulans، آلترناریا و گونههای کلادوسپوریوم در دیواره های حمام و آشپزخانه ها شایع هستند در این محلها از ژلهای محلول سلولز که به عنوان پایدار کننده در رنگهای امولوسیونی و یا در چسبهای کاغذهای دیواری به کار رفته اند استفاده میکنند این قارچها باعث تغییر رنگ ) بعلت اسپورهای تیره رنگشان و نیزهایفای پیگمانته شان دیوارهای حمام و آشپزخانه میشوند
Kerosene Fungus بنام Amorphothera resinae مسائل و مشکلات قابل توجهی بعلت رشد خود در هیدور کربنهای بازنجیره طولانی موجود در سوخت هواپیما نرم کنندههای ماشینها ... ایجاد میکند برخی از قارچها در شرایطی که آب بسیار کمی در دسترسشان باشد میتوانند به رشد خود ادامه دهند. برخی از گونه های آسپرجیلوس که باعث فساد غلات میشوند در شرایطی که مقادیر بینهایت کم آب در دسترس آنها باشد قادر به رشد هستند این قارچها نه تنها باعث فساد و نابودی مواد و محصولات کشاورزی و غذایی میشوند بلکه میتوانند مایکوتوکسین نیز تولید نمایند مانند آفلاتوکسین،ها که از مهمترین کارسینوژنها
می باشند.
ص: 122
کار کردن در آزمایشگاه قارچ شناسی مستلزم رعایت نکات چندی است که رعایت این نکات در حفظ سلامت ،خود همکاران و بستگان اهمیت به سزائی دارند توجه و مراقبت هنگام کار با قارچهای پاتوژن و قارچهای بیماریزای فرصت طلب بر کسی پوشیده نیست آنچه که در اینجا مورد تأکید قرار می گیرد این است که بدانیم که تمام قارچهای ساپروفیت نیز دارای پتانسیلهای بیماریزایی متفاوتی هستند و بنابراین شایسته است که با هر کلنی رشد کرده در محیطهای کشت آزمایشگاهی همانند یک گونه پاتوژن برخورد شود.
.1 هرگز کلنیهای قارچ را بو .نکنید
.2 هرگز کلنیهای قارچی را در محیط باز امتحان ننموده مگر آنکه این عمل در زیر هود بیولوژیک با ایمنی بالا صورت گیرد
3. استفاده از هود مخصوص و ایمن برای بررسی تمام کپکهایی که از ترشحات دستگاه تنفسی بافتهای عمقی بدن احشاء)، خون ادرار و سایر مایعات جدا شدهاند الزامی بوده و هم چنین برای نمونه هایی که روی آنها آزمایشهای لازم جهت جداسازی قارچ در حال انجام است باید مورد استفاده قرار گیرد.
.4 تمام کشتها قبل از دور ریخته شدن اتوکلاو شده و کشتهای کهنه ای را که مورد نیاز نیستند در آزمایشگاه نگهداری نکنید.
5 برای ذخیره کشتها و قارچهای جدا شده باید از لوله های شیشه ای در پیچ دار استفاده کرد.
.6 هر بار پس از پایان کار روی میز را ضد عفونی ،نموده هرگز نباید اجازه داد گرد و خاک روی وسایل و محیط آزمایشگاه قارچ شناسی جمع شود چون اسپورهای قارچی تجمع یافته و شروع به تکثیر می نمایند.
7. از قرار دادن گلدان در آزمایشگاه قارچ شناسی خودداری کنید زیرا گیاهان میتوانند مانند محیط کشت برای قارچهای مهم سیستمیک و به خصوص کوکسیدیوئیدس ایمیتیس مورد استفاده قرار گرفته و موجب ایجاد اسپورهای بیماری زا شوند. در ضمن ،گیاهان مایتها (Mites و پاتوژنهای گیاهی و قارچهای درون خاک را به خود جذب کرده و باعث آلوده شدن کشتها میگردند
8. در مناطقی که کوکسیدیوئیدومایکوزیس بصورت آندمیک وجود دارد و بطور کلی در صورت احتمال برخورد با عامل این بیماری به افراد سیاه پوست و زنان حامله توصیه میشود که با کشتهای کوکسیدیوئیدس ایمیتیس تماس نداشته باشند چون نسبت به این ارگانیسم حساس تر از بقیه هستند
ص: 123
بعد از انجام کشت قارچ در لوله یا بوات ،دوپتری آن را باید در حرارت اتاق 22 تا 25 درجه سانتیگراد و در شرایط رطوبت 90 - 85 درصد نگاهداری کرد تا رشد کند بهتر است که شدت نور اتاق زیاد نباشد و نیز اتاق فاقد پنجرههای بزرگ بوده جریان شدید هوا هم در آن نباشد
با توجه به اینکه شدت و میزان رشد قارچها یکسان نبوده بعضی سریع و بعضی کند رشد میکنند میبایست هر چند روز یکبار و یا حداقل هفته ای یکبار کشتها را بازدید نمود و به محض پیدایش کلنی جهت تشخیص نوع قارچ به ترتیب زیر عمل کرد
-1- تعیین مشخصات کلنی
-2 تعيين مشخصات ساختمان قارچ
3- تعیین خواص بیولوژیکی قارچ
-4- ایجاد بیماری زایی تجربی در حیوانات آزمایشگاهی
در مورد قارچهای ساپروب (ساپروفیت اجرای روشهای 1 و 2 غالباً منجر به تشخیص نوع قارچ میشود ولی در موارد دیگر بخصوص در قارچهای بیماریزا گاهی انجام کلیه روشهای فوق جهت تشخیص نوع قارچ ضروری است. بدیهی است که همیشه باید تاریخ انجام کشت نوع محیط کشت مورد استفاده و نیز مشخصات مربوط به نمونه کشت داده شده را بمنظور پرهیز از اشتباه با مداد چرب یا مدادهای علامت گذار (marker) روی لوله یا درب بوات دوپتری یادداشت نمود.
-1 تعيين مشخصات کلنی Gross morphology- colony characteristics
برای تعیین مشخصات کلنی باید به صفات و خصوصیات زیر توجه کافی مبذول داشت
الف - میزان رشد قارچ rate of growth
شدت یا کمیت رشد قارچ بطور کلی تابع درجه حرارت عمق محیط کشت و نوع محیطی است که جهت کشت قارج بکار رفته است ( مثلا فصول بهار و پاییز در شرایط طبیعی و غیر آزمایشگاهی فصول مناسب تری .هستند هر چقدر عمق آگار بیشتر باشد رشد قارچ سریعتر است و نیز محیطهای واجد قندهای ساده مانند دکستروز یا گلوکز بهتر از قندهای مرکب عمل میکنند
برای تعیین میزان رشد قارچ در کشتهایی که درون پلیت انجام شده ،باشد از اندازه گیری قطر کلنی ایجاد شده در زمان معین استفاده میشود و آن را با صفاتی مانند سریع کمی سریع آهسته یا کند و خیلی کند تفسیر کنند مثلاً اگر رشد کلنی قطر (آن در 5 روز به 50 الی 55 میلی لیتر برسد رشد آن خیلی سریع میباشد.
در کشتهایی که درون لوله انجام گرفته باشد صفات فوق بدین صورت مشخص میشوند
رشد خیلی سریع کلنی در مدت 5 روز یا کمتر تمام سطح آگار را فرا می گیرد.
ص: 124
رشد سریع کلنی در مدت یک هفته تا ده روز تمام سطح آگار را فرا میگیرد
رشد کمی سریع در این حالت رشد کلنی در مدت یک هفته تا ده روز از نصف سطح آگار تجاوز میکند
رشد کند وسعت کلنی در مدت یکماه به نصف سطح محیط نمیرسد.
رشد خیلی :کند اندازه کلنی در مدت مشابه از سطح یک ناخن دست متجاوز نیست.
بدیهی است که حالات بینابینی نیز وجود دارند که با استفاده از واژه های کمکی بیان میشوند
ب - حالت و شکل کلنی General topography - General appearance
شکلی که کلنی قارچ به آن حالت دیده میشود منظره کلنی گفته میشود و این حالت بطور غیر مستقیم وابسته به درجه رشد قارچ .است کلنیهای قارچی ممکن است به اشکال زیر باشند
مسطح ( flat)، برجسته (heaped)، مدور (rounded)، منظم (regular)، نامنظم(irregular)، شیاردار(fissured)، مخچه ای شکل (cerebriform) ناخن شکل برآمده در محیط و فرو رفته در وسط umbiliform)، با چین و شکنهای نامرتب و عمقی (folded) ، بصورت دوایر متحدالمرکز (concentrically ringed) محیط کلنی ممکن است خیلی مشخص باشد و بطور سریع و ناگهانی در سطح آگار تمام شود (sharply defined) و یا اینکه به شکل اشعه ای محیطی در زیر سطح آگار ادامه داشته باشد. (submerged growth)
ج- منظره سطح کلنی surface appearance
قوام و منظره کلنی بطور کلی تابع عمق آگار و نیز ترکیبات محیط کشتی است که در آن رشد میکند منظره سطح کلنی ممکن است به یکی از حالات زیر دیده شود.
خامه ای (creamy یا pasty که قوام و شکل کلنی شبیه به خامه و همانند کلنی باکتریها است پوستی (glabrous) که در این حالت سطح کلنی حالت درخشندگی نداشته و مشابه پوست بدن است چرمی (leathery) که در این حالت کلنی مانند چرم صاف و براق است گچی (chalky کلنی مانند گچ آبدیده و خشک شده است پودری (powdery دانه ای (granular شنی ( sandy) پرزی (downy) کرکی fluffy یا floccose)، پنبه ای (cottony) پشمی (woolly) و بالاخره ممکن است قوام نرم (soft) مومی (waxy) و یا سفت داشته باشد.
د- رنگ کلنی
رنگ کلنی ممکن است ،سفید ،کرم ،خاکی ،زرد ،نارنجی قرمز ارغوانی، سبز، آبی یا سیاه باشد و یا ممکن است از رنگهای ترکیبی مانند سبز ،زیتونی زرد ،نخودی قهوه ای خرمایی قرمز آجری قرمز ،شرابی و غیره تشکیل شده باشد. گاه ممکن است در تمام سطح خود یک رنگ یکنواخت داشته باشد یا اینکه در نقاط مختلف مانند مرکز و محیط رنگ متفاوت داشته باشد. ممکن است از حیث منظره و رنگ واجد مناطق گوناگون باشد که به
ص: 125
حالت منطقه ای یا zonate موسوم است گاهی نقاط کرکی شکل و سفید رنگی در سطح کلنی ظاهر میشود که با رشد سریع ممکن است در اندک مدتی تمام کلنی را فرا گیرند این نقاط کرکی و سفید رنگ که چیزی جز میسلیومهای شفاف و متراکم نیستند و فاقد دستگاه زایشی قارچ میباشند (میسلیومهای عقیم یا استریل اصطلاحا به نقاط پلئومرفیسمی موسومند و این پدیده را پلئومورفیسم مینامند.
ه- رنگ پشت کلنی
بعضی از قارچها در پشت کلنی رنگ مشخص ایجاد نمیکنند در حالیکه بعضی دیگر رنگهای ساده یا مرکب در عمق آگار و در سطح خلفی محیط کشت بوجود می آورند.
و- بوی کلنی
بعضی از کلنیهای قارچی بوی مخصوص میدهند مثلا استرپتومایسسها که بوی خاک نمناک میدهند و یا ترایکوفایتون شوئن لاینی که بوی لانه موش میدهد بعضی از قارچها رایحه مشخصی دارند که از خواص شناسایی آنها به شمار میرود ولی اکثر قارچها فاقد بوی خاصی هستند. استشمام بوی قارچ بعلت امکان استنشاق اسپورهای آن بخصوص در انواع بیماریزا کاملا خطرناک است و باید از آن اجتناب ورزید
ز- قطرات ترشحی (exudate)
بعضی از قارچها در ضمن رشد و نمو خود ایجاد قطرات ترشحی در لابلای میسیلیومهای خود میکنند که ممکن است کوچک و میکروسکپی باشند یا اینکه درشت تر بوده و با چشم غیر مسلح دیده شوند. این قطرات ترشحی ممکن است بی رنگ و یا رنگین به رنگهای (گوناگون باشند .
(ژ) پیگمانتاسیون منتشر در محیط
بعضی از قارچها در محیط پیگمان تولید مینمایند که در محیط کشت منتشر میشوند مانند فوزاریومها و برخی از پنیسیلیومها
-2 تعیین مشخصات ساختمان میکروسکپی قارچ
برای مشاهده ساختمان میکروسکوپی قارچ با استفاده از لوپ یا میکروسکوپ میتوان به طریق زیر آنها را مورد مطالعه و بررسی قرار داد.
ص: 126
(الف) مشاهده کشت قارچ درون لوله در زیر میکروسکپ یا لوپ
با درشت نمایی کوچک میکروسکپ میتوان ساختمانهای قارچی راکه در اطراف کلنی ودر جدار لوله بالا
آمده است مشاهده کرد و به ساختمان آن و طرز قرار گرفتن اسپورها پی برد.
ب) مشاهده کشت قارچ دربوات دوپتری
با استفاده از لوپ ونور منکسر شونده در کشت قارچ درون بوات دوپتری میتوان چگونگی اسپورزایی ساختمانهای مربوط به آن و طرز قرار گرفتن آنها را بخوبی مشاهده و مطالعه کرد.
ج) تهیه نمونه خرد شده قارچ (Teased mount)
قسمتی از کلنی قارچ را به کمک میله پلاتین نسبتاً ضخیم که سر آن علاوه برزاویه خمیده در قسمت رأس کمی پهن و تیره شده باشد برداشته و آن را در روی یک اسلاید میکروسکپی تمیز قرار میدهند ابتدا برای خارج ساختن هوایی که ممکن است بین الیاف میسیلیوم محبوس باشد یک قطره الکل 95 درجه به آن افزوده و سپس به کمک دو سوزن تشریحی تا آنجا که مقدور باشد آن را به قطعات کوچک تقسیم کرده و یک قطره لاکتوفنل کاتن بلو به آن اضافه کرده و بعد از پوشاندن با لامل در زیر میکروسکوپ چگونگی ساختمان میسیلیوم و اسپورها را مطالعه میکنند با توجه به اینکه در این طریق ساختمانهای اسپورزای قارچ و چگونگی ارتباط آنها از هم گسیخته میشود
برای مطالعه دقیق و کامل آنها باید از یکی از روشهای کشت روی لام استفاده نمود.
د) تهیه کشت روی لام Slide culture (1)
1) طریقه ریدل (Riddle)
این طریقه معمولی ترین روش کشت روی لام است که برای کلیه قارچهای میسیلیوم دار مناسب است. اساس این روش کشت قارچ برروی قطعه ای از آگار و تهیه حالت رویشی آن در روی لام ولامل .است مواد لازم بوات دوپتری - لوله خمیده U شکل - محیط کشت که به قطعات 1×1 سانتیمتر باشد. محیط کشت بهتر است Potato Dextrose Agar باشد ولی میتوان محیط مناسب دیگر یا محیط سابوروی قند دار نیز استفاده نمود
روش کار :
-1 لوله U شکل را درون بوات دوپتری قرار داده روی آن یک لام بگذارید و در فور استریل نمایید.
-2 برای تهیه قطعات مربع محیط کشت بهتر است یک لوله از محیط کشت که محتوی 14 سانتیمتر مکعب محیط کشت باشد در ظرف آب قرار داده و بوسیله حرارت آن را ذوب نمود پس از ذوب شدن ابتدا جدار لوله را با کاغذ حوله ای یا پارچه تمیز خشک کرده و در نزدیکی شعله گاز محتوی لوله را در حالیکه شرایط کامل سترونی
ص: 127
رعایت شده باشد بعد از برداشتن پنبه درب لوله با دست چپ و عبور دادن دهانه لوله از روی شعله گاز درون بوات دوپتری استریل دیگری خالی میکنیم سپس با حرکت دورانی که به بوات دوپتری میدهیم محیط کشت را بطور یکنواخت در آن پخش کرده و مهلت میدهیم تا سرد و سخت شود سپس این بوات دوپتری راروی کاغذی که قبلا به مربعهای 11 سانتی متری خط کشی و تقسیم شده است قرار داده و به کمک سوزن تشریحی یا چاقوی استریل آن را به قطعات کوچک و مجزا برش میدهیم
-3 یک قطعه از برش مربعی شکل محیط کشت را با اسکالپل استریل در روی لام درون بوات دوپتری اول قرار میدهیم
-4- قطعات کوچکی از میسیلیوم یا مقدار کمی از اسپور قارچ را در وسط هر ضلع مربع آگار کشت میدهیم
-5 با کمک پنس استریل یک عدد لامل استریل که قبلا در دستگاه فور استریل شده است یا لاملی معمولی که از شعله چراغ گاز عبور داده باشیم برداشته و قطعه آگار را به طریقی میپوشانیم که قطعه ی آگار مربع شکل دروسط لامل قرار گیرد برای این منظور لامل 22×22 میلی متر مناسب است.
6- بارعایت شرایط سترونی مقدار 8 سانتی متر مکعب آب مقطر استریل به ته بوات دوپتری اضافه میکنیم
7- درب بوات دوپتری را در جای خود قرار داده و تاریخ و مشخصات نمونه را روی آن ثبت نموده و کشت انجام یافته را در دمای اتاق 25 درجه سانتیگراد نگهداری میکنیم
-8- بعد از آنکه رشد قارچ در اطراف قطعه آگار آشکار و مشخص گردید برای تعیین وجود حالت اسپوزایی میتوان لام را از درون بوات دوپتری خارج کرد و پس از خشک نمودن سطح زیرین آن لام را مستقیما زیر میکروسکوپ با درشت نمایی کوچک امتحان کرد چنانچه اسپورها بوجود آمده ،باشند، بطریق زیر لام تهیه کرده واگر تولید نشده باشد مجدداً آنها را درون بوات دوپتری قرار داده و چند روز دیگر باید به آن مهلت داد.
-9 لامل را برداشته و آن را بطور وارونه قرار دهید بطوریکه سطحی از لامل که قارچ در آن رشد کرده است رو به بالا قرار گیرد
10 - قطعه آگار روی لام را به کمک سوزن تشریحی یا اسکالپل از روی لام بردارید
-11 برروی لام ولاملی که بدین ترتیب تهیه شده است یک قطره الکل 95 درجه بریزید تا حباب هوای محبوس بین الیاف میسیلیومها خارج شود
12 - روی لام در محلی که قارچ رشد کرده است یک قطره لاکتوفنل کاتن بلو اضافه کرده و با احتیاط لامل تمیز دیگری روی آن به طریقی قرار دهید که ایجاد حباب هوا .نکند به همین ترتیب در روی لام دیگری یک قطره لاکتوفنل کاتن بلو قرار داده و لاملی که قارچ در سطح زیرین آن رشد کرده بود و آن را بطور معکوس در محل دیگری قرار داده بودید مجددا بطور وارونه روی قطره لاکتوفنل قرار دهید محل) کشت قارچ روی مایع قرار میگیرد
ص: 128
13 - نمونه تهیه شده را میتوان بلافاصله زیر میکروسکپ مشاهده و مطالعه کرد و برای تهیه نمونه ثابت بعد از چند روز نگاهداری آن در محیط سربسته جعبه های جای لام مقوایی افقی برای این منظور مناسب است به منظور خشک شدن مایع لاکتوفنل اطراف ، لامل دور آن را با لاک ناخن قیر یا رنگ به خوبی مسدود نمایید ابتدا از گوشه های لامل شروع کرده و سپس اطراف آن را مسدود کنید
(2 کشت روی لام به طریقه هنریسی (Henrici)
با این روش ساختمان میسیلیوم زایشی و رویشی بخوبی مشخص شده و درضمن روابط اتصالی اسپورها و ساختمانهای بوجود آورنده آنها به هم نمیخورد
روش کار:
-1- درته بوات ،دو ،پتری کاغذ فیلتر یا کاغذ آب خشک کنی را که به قطر داخل بوات دوپتری بریده شده است قرار داده و در اتوکلاو بافشار 15 پوند به مدت 20 دقیقه استریل نمایید این) کاغذ باید همیشه مرطوب باشد و در صورتی که در اثر ماندن خشک شده باشد بارعایت شرایط سترونی، آب مقطر استریل روی آن بریزید
-2 شش عدد لامل تمیز را در شعله چراغ الکلی استریل نموده و در روی کاغذ مرطوب درون بوات دوپتری قرار دهید.
3- محیط سابورو دکستروز آگار را که قبل از استریلزاسیون آن در اتوکلاو از کاغذ صافی رد شده و کلیه عناصر خارجی آن صاف شده باشد درون ظرف آبی ذوب کرده و بگذارید تا حدود 50-40 درجه سانتیگراد سرد شود. در این حالت محیط کشت هنوز مایع بوده و گرمای آن به حدی نیست که قارچ را بکشد. اسپور قارچی راکه مورد مطالعه قرار خواهد گرفت به این لوله اضافه کرده و آن را بخوبی بهم بزنید تا یک سوسپانسیون یکنواخت بوجود آید .
-4 بوسیله میله پلاتین با سر حلقه ای یک قطره کوچک از این سوسپانسیون را برداشته و در روی لاملها آن چنان پخش کنید که یک طبقه نازک روی آن ایجاد کند
-5- درب بوات دوپتری را در جای خود قرار داده و آن را در دمای اتاق نگهداری نمایید تا رشد کافی ایجاد شود.
6- لامل را با پنس استریل خارج کرده برای مطالعه فوری یا تهیه نمونه موقتی آن را بطور وارونه درون یک قطره آب مقطر روی لام قرار داده و بلافاصله آزمایش کنید.
7- برای تهیه نمونه دائمی یک یا دو قطره الکل 95 درجه روی لامل ،ریخته پس از 2 دقیقه که الکل تبخیر شد در روی لام یک قطره لاکتوفنل کاتن بلو قرار داده ولامل را بطور وارونه روی آن قرار دهید. بعد از 2 تا 3 روز مایعات اضافی لامل را پاک کرده و دور آن را با قیر یا لاک ناخن مسدود نمایید. این نمونه در
ص: 129
صورت نگهداری در محل مناسب به مدت چندین سال قابل استفاده خواهد بود.
آبسیدیا قارچی از خانواده موکوراسه زیرشاخه زیگومایکوتینا و شاخه یومایکوتا میباشد بعنوان آلرژی زا گزارش شده است همچنین بعنوان یک قارچ ساپروب در تجزیه و فساد مواد آلی نقش دارد. گونه های شایع آن عبارتند از : Absidia corymbifera, A. ramosa, A. glauca, A. orchidis, A. spinosa
ساختمان ظاهری کلنی دارای رشد سریع میباشد و کلنیهای سفید کرکی تا پشمی ایجاد میکند که رنگ آن خاکستری یا قهوه ای است تصاویر شماره 45 و 46 .
ساختمان میکروسکوپی دارای هیفهای فاقد دیواره عرضی و اسپورانژیوفورهای بلند و شفاف تا خاکستری روشن تصویر) شماره (47 میباشند اسپورانژیوفورها معمولا در گروههای 25 تایی از استولونهای طولی مشتق می شوند برخلاف رایزوپوس که اسپورانژیوفور مستقیماً در محل گره ایجاد میشود). اسپورانژیوم 20 تا 35 میکرون قطر دارد اسپورانژیومهای قطره اشکی یا گلابی ،شکل شفاف و در بعضی گونه ها به اندازه 10 تا 70 میکرون و واجد مقدار فراوان آندوسپور گرد یا بیضی و با دیواره صاف هستند تصویر شماره 48 کلوملا بیضوی تا قاشقی شکل میباشند. اسپورانژیوفورها ممکن است ساده بوده و یا انشعابات کوریمبیفرم داشته باشند و گرد تا بیضی شکل هستند ریزوییدهای ریشه مانند در محیط کشت نفوذ میکنند و مثل رایزوپوس در محل گره برخلاف جهت اسپورانژیوفورها ایجاد میشوند تفاوت این قارچ با رایزوپوس در آن است که اسپورانژیوفورهای منشعب دارد که روبروی ریشک (ریزویید قرار ندارند و در انتها متورم شده و کلوملا تشکیل میدهند
بیماری زایی آبسیدیا یکی از عوامل موکورمایکوزیس در انسان و سایر حیوانات خونگرم میباشد و ابتلا به عفونت آبسیدیا غالبا بوسیله استنشاق اسپورانژیوسپورها بوجود می آید آبسیدیا کوریمبیفرا ( A corymbifera) یکی از دو گونه پاتوژن انسانی از بین گونههای این قارچ بوده و در دمای 25 درجه سانتیگراد تا 45 درجه سانتیگراد بخوبی رشد میکند همچنین بعضی از ایزوله های گونه آبسیدیا کوریمبیفرا میتوانند در دمای 50 درجه سانتیگراد نیز رشد .کنند گونه پاتوژن دیگر آبسیدیا کورولا .است بطور کلی قارچ ترموفیلیکی بوده و ماکزیمم دمای رشد آن 48 تا 52 درجه سانتیگراد است. محل های ایجاد عفونت عبارتند از ریه ها سینوسهای اطراف بینی مغز چشم و پوست
در مقاطع هیستوپاتولوژیک به شکل هیف های پهن و فراخ معمولا بدون دیواره میانی همراه با قسمتهایی
ص: 130
که بطور نامنظم متورم شده است دیده میشود انشعابات هیفها با زاویه 90 درجه مشاهده میشوند. عامل عفونت مهاجم در بیماران ،ایدزی نوتروپنی پیوندی و نیز عامل بیماریهای قارچی جلدی و زیر جلدی کراتیت و عفونتهای مختلف دیگر میباشند همانند رایزوموکور پوسیلوس عامل سقط جنین در گاو است.
تصویر شماره 45 کشت در محیط PDA بعد از 6 روز

تصویر شماره 46
تصویر شماره 47
تصویر شماره 48
ص: 131
ابعاد کونیدیا -25 - 15 میکرون .است یک آلرژن شایع بوده ،در گیاهان ،خاک ،غلات، حبوبات، منسوجات محصولات کاغذی یافت میشود رشد سریعی داشته و کلنیهای آن ابتدا زرد تا نارنجی بوده ولی با بلوغ کلنی ها و به علت ایجاد شدن انبوه کونیدیهای تیره ،رنگ رنگ آنها نیز تیره میشود (تصویر شماره 49 این قارچ فاقد کونيديوفور مشخص و یا دارای کونیدیوفور بسیار کوتاهی میباشد که بصورت گروهی در اطراف میسیلیومهای رویشی رشد میکنند کونیدیاها در ابتدا بدون تیغه میانی و گرزی شکل با سطحی صاف بوده ولی سرانجام ،کروی توتی شکل و به رنگ قهوه ای در می آیند (تصویر شماره 50 )
تصویر شماره 49

تصویر شماره 50
ص: 132
اکثر گونه های این قارچ آلرژیک هستند. برخی از اعضای این جنس عفونتهای گوش ایجاد میکنند. بسیاری از گونه ها مایکوتوکسین تولید میکنند که در انسان و حیوانات بیماری ایجاد می نمایند تولید توکسین وابسته گونه ها یا یک استرین در یک گونه و روی منابع غذایی خاصی می.باشد برخی از این توکسین ها در گونه های مختلف حیوانات کارسینوژن و تعدادی دیگر کارسینوژنهای بالقوه برای انسان می باشند. عامل شایع آسم اکستری نزیک ازدیاد حساسیت نوع I هستند علائم حاد شامل ادم و برنکواسپاسم است. جنس آسپر جیلوس مشتمل بر حدود 600 گونه میباشد این گونه ها در اندازه و شکل و رنگ ،کونیدی طول و ضخامت و رنگ و جدار ،کونیدیوفور، شکل و اندازه وزیکول، شکل و رنگ کلنی و..... با هم واجد اختلافاتی می باشند از انواع بیماریزای آن میتوان گونه های آسپر جیلوس فومیگاتوس و یا آسپر جیلوس نیجر را نام برد. آسپر جیلوس فلاوس نیز بعلاوه آسپر جیلوس پارازیتیکوس از گونههای تولید کننده سم آفلاتوکسین میباشند کلنی آنها معمولاً مخملی تا پنبه ای و به رنگهای متنوع ،سفید ،زرد قهوه ای خاکستری، سبز، صورتی، ،آبی خرمایی و سیاه دیده میشود در واقع رنگ کونیدیاهای ارگانیسم تعیین کننده رنگ کلنی بوده و پشت کلنی غالباً بی رنگ است. ساختمان میکروسکوپی آن از میسیلیومهای رویشی شفاف، بی رنگ، با تیغه میانی و نیز دستگاه زایشی مخصوص تشکیل شده است. کونیدیوفور آسپرجیلوسها از سلول مشخصی در میسیلیومهای رویشی منشاء میگیرند که به خاطر شکل خاصی که دارد به نام سلول پا (Foot cell) خوانده میشوند کونیدیوفور کشیده و بلند (Macronematous)، معمولاً با تیغه میانی و یا بدون آن با جداری صاف و یا خاردار میباشد. غالبا در انتها متسع و فراخ گشته و به شکل بیضی چماقی و یا کروی در میآید که به آن وزیکول (vesicle .گویند وزیکول خاص آسپر جیلوسها بوده و در سطح آن یک ردیف (Moneseria) و یا دو ردیف (Biseria) اجسام قمقمه ای شکل به نام استریگما یا فیالید (Strigma or phialide) مشاهده میشود. از قاعده فیالیدها کونیدیاهای گرد یا بیضی شکل با جدار صاف و یا خاردار به صورت زنجیره پشت سر هم خارج میشوند قاعده زایی = Basiepetal) به طوری که به دستگاه ،زایشی نمایی شبیه گلاب پاش را داده و به همین علت نیز این جنس را آسپر جیلوس یا گلاب پاش نامند. بعضی از گونه های آسپرجیلوس دارای تکثیر جنسی بوده و جزء آسکومایستاسه طبقه بندی میشوند محصول تکثیر جنسی آنها آسکهایی است که به صورت اسکلروتیا (Sclerotia) و یا کلیستوتشیاهای Clistotheca روشن و یا تیره رنگ دیده میشوند. به همین دلیل نیز این گونه ها را در جنسهای مریلا Emericella) يورتيوم (Eurotiom) همی کارپنتلز ( Hemicarpenteles) نئوسارتوریا (Neosartorya) چائتوسارتوریا (Chaetosartorya)، فنليا (Fennellia)، دیكلائنا (Dichlaena)، ادییو ئیلیا (Edyuillia)، پترومایسس Petromyses) و اسکلرو کلیستا (Sclerocleista)
ص: 133
طبقه بندی میکنند هر چند ساختمان کونیدی زایی بعضی از آسپر جیلوسها ممکن است با پاره ای از گونه های پنیسیلیوم که دارای کونیدیوفور کشیده و واحدی هستند . Monoverticillate) اشتباه گردند، ولی توجه به وجود سلول پایه (Foot cell میتواند در این مورد مفید باشد.
عامل عمده و مهم آسپرژیلوزیس است. آسپرژیلوزیس آلرژیک و آسپرژیلوزیس مهاجم هر دو توسط این قارچ ایجاد میشوند آسپر جیلوس افرادی را مبتلا میکند که از نظر سیستم ایمنی مستعد هستند بعنوان یک قارچ پاتوژن انسانی در نظر گرفته میشود در دمای 35 درجه سانتیگراد به خوبی رشد می.کند. بطور شایع در هوا و در روی توده ها و کپه های کود گیاهی با دمای بالاتر از 40 درجه سانتیگراد و نیز در خاکهای مناطق معتدل تا گرم و روی غلات و حبوبات دیده میشود
ساختمان ظاهری کلنی ابتدا سفید ،رنگ سپس به رنگ خاکستری مایل به سبز و نهایتاً به رنگ قهوه ای تیره در می آید سطح کلنی صاف یا پیچیده است و منظره مخملی و غده ای دارد و در دمای 37 درجه به خوبی رشد میکند
تصویر شماره 51

تصویر شماره 52
ساختمان میکروسکپی کونید یوفور معمولاً کوتاه است طول آنها بیشتر از 300 میکرون میباشند سطح كونيديوفور صاف و به رنگ سبز مایل به قهوه ای است وزیکول بطری شکل است (تصویر شماره 51) قطر وزیکول 20 تا 30 میکرون و اغلب در 1/2 و یا 1/3 قسمت محدب انتهایی آن یک ردیف فیالید
ص: 134
قرار گرفته است فیالیدها در انتها خمیدهاند و به موازات محور کونیدیوفور قرار میگیرند (تصویر شماره (52 کونیدیها کروی شکل و به قطر 2 تا 3 میکرون و سبزرنگ میباشند. کلیستوتشیوم (cleistothecium) و اسکلروتشیا (sclerotethia) ایجاد نمی کند.
A fisheri از لحاظ ظاهری و ریختی شباهت کاملی به آسپرجیلوس فومیگاتوس دارد. تفاوت آن در این است که ممکن است کلیستو تشیا ایجاد نماید.
قارچی است با رشد سریع سطح صاف و کرک دار (Floccose) در ابتدا سفید یا زرد کم رنگ و سپس سطح آن از دانه های سیاه رنگ پوشیده میشود پشت کلنی سفید است. کونیدیوفور آن صاف با جدار کلفت تقسیم نشده و بلند بطول 300 میکرون تا چند میلیمتر و به قطر 7 تا 20 میکرون میباشد انتهای کونیدیوفور به یک وزیکول کروی شکل با جدار کلفت به قطر تا 225 میکرون که در تمام محیط خود بارور میباشد ختم می گردد. استریگما در دو ردیف وجود دارد استریگماهای ردیف اول بهم فشرده چماغی شکل با تیغه میانی یا بدون تیغه میانی با قاعده باریک و در رأس پهن تر به طول 6 تا 8 میکرون و استریگماهای ردیف دوم کوچکتر و یکنواخت و قمقمه ای شکل به ابعاد 6 تا 10 در 2 تا 3 میکرون که به تعداد 2 یا 3 و یا چند عدد در رأس خارجی استریگماهای ردیف اول بوجود می آیند و معمولاً سیاه رنگ هستند کونیدی کروی ناصاف لب) کنگرهای سیاه رنگ به قطر 5 تا 10 میکرون که به شکل زنجیره به دنبال هم قرار میگیرند. در بعضی از گونه های گروه آسپرجیلوس نیجر اسکلروتشیا (Sclerotethia که توده بهم فشرده و سختی از میسیلیومها است بوجود می آید. این قارچ در بسیاری از محلولهای شیمیایی خالص یا مرکب رشد میکند و در خاک همه نقاط دنیا فراوان
یافت میشود. در این قارچ وزیکول و فیالید غالباً به سختی قابل رؤیت است به دلیل آنکه توسط اسپورهای تیره رنگ کاملا پوشانده میشود این قارچ باعث تلخی کره و پنیر و سایر چربیها میشود و شکر خام را تجزیه میکند همچنین از روی مواد غذایی در حال فساد و منسوجات جداسازی شده است. آسپرژیلوس نیجر در
تولید اسید سیتریک کاربرد دارد.
ساختمان ظاهری
این قارچ روی محیط سابورو و در دمای 25 درجه سانتیگراد رشد سریعی دارد. سطح کلنی صاف و دانه ای تا کرکدار، در ابتدا سفید یا زرد کم رنگ است که بتدریج با ایجاد کونیدیهای سیاه ،رنگ سطح کلنی از دانه های سیاه رنگ پوشیده میشود تصویر شماره 53 و 55 این قارچ بر روی محیط czapekdox agar کلنی فشرده
ص: 135
سفید با زمینه غده ای زرد تشکیل میدهد که به وسیله لایهای پر رنگ از سرهای کونیدی قهوه ای تیره متمایل به سیاه پوشیده شده است.
تصویر شماره 53
تصویر شماره 54
تصویر شماره 55
ص: 136
ساختمان میکروسکپی
کونیدیوفور از سلول پایه منشاء می گیرد صاف و دارای دیواره ضخیم تقسیم نشده و بلند بطول 300 میکرون تا چند میلیمتر است و قطر آن به 20 میکرون میرسد و فاقد دیواره عرضی .است در انتها به وزیکول کروی کاملا پوشیده از فیالید و اسپورهای بارور ختم می.شود در روی وزیکول دو ردیف فیالید مشاهده میشود که ردیف اول متراکم میباشند ولی فیالیدهای ردیف دوم کوچکتر و قمقمه ای شکل هستند و 2 یا 3 و یا چند تا از آنها از فیالیدهای ردیف اول منشاء میگیرند و معمولاً سیاهرنگ .هستند طول فیالیدهای اولیه 20 برابر فیالیدهای ثانویه است کونیدی های کروی خشن قهوه ای یا سیاهرنگ بصورت رشته ای از فیالیدهای قمقمه ای ردیف دوم منشاء می گیرند که خاردار هستند و بطور کامل وزیکول و فیالیدها را میپوشانند و باعث میشوند که غالباً این اجزاء مشاهده نگردند (تصویر شماره 54) بیماری زایی باعث اوتیت گوش خارجی اتومیکوز) و آسپر جیلوز مهاجم ریوی میشود و گاهی میستوما ایجاد می.کند به عنوان سومین گونه بسیار رایج مهاجم دستگاه تنفسی شناخته شده و به صورت مکرر به عنوان عامل اتومایکوز با آن برخورد شده است. این قارچ یک عامل آلوده کننده در آزمایشگاه میباشد.
این قارچ گاه با رشد سریع در ظرف ده روز در محیط سابورو و دمای اتاق کلنیهایی به قطر 6 تا 7 سانتیمتر ایجاد مینماید و گاه با رشد نسبتاً کند در مدت ده روز قطر کلنیها به 3 تا 4 سانتیمتر میرسد دیده میشود سطح کلنی کرکی و رنگ آن ،آجری زرد مایل به سبز روشن یا تیره است (تصویر شماره 56 پشت کلنی بیرنگ یا صورتی رنگ است. در برخی از سوشها اسکلروتشیوم قرمز مایل به قهوه ای و به قطر 400 تا 700 میکرون ایجاد میشود برخی از سوشها در دمای 37 درجه بهتر از 25 درجه سانتیگراد رشد
تصویر شماره 56
ساختمان میکروسکپی
کونیدیوفور این قارچ بلند به طول یک میلیمتر یا بیشتر بیرنگ و با دیواره ضخیم و خاردار است. وزیکول
ص: 137
کروی شکل به قطر 10 تا 65 میکرون است و فیالیدها ممکن است یک یا دو ردیفی باشند تصویر شماره 57 و 58). کونیدیها بیضوی یا کروی، خاردار و به رنگ مایل به سبز هستند. منظره زبر و کرکی کلنی و رنگ زرد مایل به سبز ،آن دیواره خشن کونیدیوفور و نیز خاردار بودن آن اغلب گروه آسپر جیلوس فلاوس را از گروه آسپرجیلوس فومیگاتوس جدا می سازد
ابعاد کونیدی 6-3 یا 5-3 میکرون است روی ،ذرت ،پسته و بادام زمینی رشد میکند و در خاک گرم پیدا می.شود در غذاها و محصولات لبنی یافت میشود بعضی از استرینها قادر به ایجاد گروهی از توکسینها هستند مدارک محدودی در رابطه با سرطان زا بودن این قارچ در انسان وجود دارد توکسین این قارچ در صورت مصرف خوراکی برای انسان مسمومیت ایجاد می.کند همچنین از طریق استنشاق به صورت بیماری شغلی دیده می.شود آزمایشها و تجربیات نشان داده است که یک ماده تراتوژن و موتاژن می باشد اثر سمی در کبد دارد و آلرژی زا .است حضور آن در ارتباط با گزارش هایی مربوط به آسم میباشد. در قالیهای آسیب دیده در اثر آب پیدا میشود.
تولید توکسین قارچی وابسته است به شرایط رشد قارچ و سوبسترایی که به عنوان منبع غذایی مورد استفاده قرار داده است. این قارچ در ارتباط با آسپرجیلوزیس ریه ها و آسپرجیلوزیس منتشره دیده میشود این قارچ بعنوان عامل عفونتهای قرنیه گوش بینی و چشمی شناسایی میشود
تصویر شماره 57

تصویر شماره 58
ص: 138
کلنی این قارچ به رنگ دارچینی یا قهوه ای تیره دیده میشود سطح کلنی کرکی یا مخملی و دارای رشد سریع است تصویر شماره (60 وزیکول این قارچ کوچک به قطر 10-15) (میکرون بوده و فیالیدها در نیم دایره از وزیکول در یک یا دو ردیف واقع شدهاند نوعی کونیدی ثانوی نیز دیده میشود که گاه از فیلاکونیدیها بزرگترند به قطر 6 تا 7 میکرون) و مستقیماً در اطرافهایفاهای کوتاه بوجود می آیند تصاویر شماره 59 و 61).
ابعاد کونیدی 2/4-1/8 یا 2/5-2 میکرون است . آلوروسپورها که 6 تا 7 میکرون قطر دارند نیز ایجاد میشوند در خاکهای گرم تر و در حبوبات ،غلات در پنبه حصیر و گیاهان فاسد شده یافت میشوند. توکسین پاتولین و سیترینین را تولید میکند که ممکن است با بیماری در انسان و حیوانات دیگر در ارتباط باشد این قارچ با آسپر جیلوزیس ریه ها و یا آسپرجیلوزیس منتشره در ارتباط است از عفونت گوش و انیکومایکوز (عفونت قارچی ناخنهای انگشت دست (یا (پا جداشده است.
تصویر شماره 59

تصویر شماره 60
تصویر شماره 61
ص: 139
این قارچ در خاک نقاط مختلف دنیا بر روی مواد گیاهی در حال پوسیدن و کودها و روی دانه های تغذیه دام یافت می.شود بعضی از انواع این دسته تولید واکنش قلیایی شدید کرده و pH محیط را به 9/5 میرسانند و بوی مخصوص تری متیل آمین (Trimethylamine) ایجاد میکنند.
ساختمان ظاهری این قارچ رشد نسبتاً سریعی دارد و در مدت 10 روز کلنی به قطر 35 میلیمتر تشکیل می.شود سطح کلنی صاف یا کمی شیاردار ابتدا کرکی وسپس در روی آن نقاط دانه ای ایجاد میشود کلنی سبز رنگ است اما در بعضی نواحی ممکن است رنگهای دیگری ایجاد شود (zonate) پشت کلنی بی رنگ است ولی در کشتهای کهنه قهوه ای می.شود کلنی این قارچ در محیط چاپکس آگار رشد سریعی داشته و در طی 14-10 روز در دمای 24 درجه سانتیگراد قطری برابر 5 تا 6 سانتیمتر خواهد داشت. در روی این محیط ممکن است ابتدا سفید رنگ و همزمان با بلوغ، کونیدی ها به رنگ آبی تا سبز کم رنگ مایل به سبز روشن دیده شوند. پشت کلنی به رنگ خرمایی مات دیده میشود که همزمان با افزایش سن کلنی به رنگ قهوه ای در میآید.
تصویر شماره 62

ساختمان میکروسکپی کونید یوفور از سلول پایه منشاء می گیرد و بلند و ضخیم است. عموماً بی رنگ و واجد دیواره صاف و طول آن به 1/5 تا 3 میلیمتر میرسد و قطر آن 20 تا 30 میکرون میباشد. ابعاد کونیدیا 4/5 2/5 × 3-4/5 میکرون است در خاک و کود حیوانات یافت می.شود توکسین پاتولین را که در انسان و حیوانات قادر به ایجاد بیماری است تولید میکند این گونه گاهی اوقات پاتوژن .است دیواره کونیدیوفور نازک صاف و شفاف است و در انتها به وزیکول بیضی شکل کشیده (clavate) ختم میشود (تصویر شماره (62 و وزیکول در تمام سطح بارور .است یک ردیف فیالید قمقمه ای شکل و به اندازه 230 × 10-8 میکرون روی آن قرار دارد و کونیدیهای خربزهای شکل (ellipticall) با جدار نسبتا کلفت صاف از فیالید منشاء میگیرند کونیدیها بصورت رشته ای و بطول 400 300 میکرون و گاهی تا یک میلیمتر هستند و این رشته ها در سه یا چهار ستون مجزا آرایش مییابند و از هم دور میشوند
بیماری زایی اسپورهای آسپر جیلوس کلاواتوس در هوا وجود دارند و با ورود به دستگاه تنفسی ورسوب در آلوئل ها، باعث ایجاد عفونت حاد کیسه های هوایی میشوند. این قارچ در روی دانه ها با ترشح سم قارچی پاتولین باعث مسمومیت اعصاب (Neurotoxin) میشوند.
ص: 140
تصویر شماره 63
Aspergillus glaucus
ابعاد کونیدیا 6/5-5 میکرون است قارچ شایع در هوا در فصل زمستان و آلرژن میباشد این گونه گاهی اوقات پاتوژن نیز هست روی ،چرم دانه های (granis)
دارای سطوح پایین ،رطوبتی محصولات غذایی شیرین گوشت و پشم رشد می کند. نام حالت یا مرحله آسکومیستی آن .Eurotium sp است.
این قارچ در خاک سر تا سر دنیا به مقدار فراوان وجود دارد و از شایعترین قارچهای موجود در طبیعت است که در شرایط خشک و مرطوب زیست میکند و بر روی گیاهان در حال پوسیدگی وجود دارد از محصولات کشاورزی خشک با aw فعالیت آبی کم انواع مرباها ،شیرینی عسل گوشتهای نمک زده و ترشی که در شرایط مساعد نگهداری میشوند همچنین از کالاهای ساخته شده از چرم و چوب که در شرایط بد نگهداری شده باشند و البسه در هوای نمناک و مرطوب
جداسازی شده است.
ساختمان ظاهری این قارچ رشد متوسطی دارد و در مدت یک هفته تا ده روز نیمی از سطح محیط کشت را فرا می گیرد کلنی آن متراکم صاف، مخملی (velvety) و در بعضی سویه ها کلنی بصورت پیچ خورده و برآمده (wrinkled است رنگ آن ،زرد زرد مایل به سبز سبز خاکستری رنگ و پشت کلنی سبز متمایل به زرد است تصویر شماره 63 و 64 در کشتهای کهنه پری تشیا (perithecia بصورت دانههای زرد رنگ و بسیار کوچکی ایجاد میشود که اجتماع آنها با چشم قابل مشاهده است. با کشتهای مکرر به تدریج تعداد کلیستو تشیا کاهش می یابد.
ساختمان میکروسکپی : کونیدیوفور که از سلول پایه منشاء گرفته کوتاه است (100 تا 300 میکرون و قطر آن به 3 تا 8 میکرون میرسد ضخامت آن از میسیلیوم بیشتر و دیواره آن ضخیم و صاف است. دیواره عرضی ندارد و در انتها به وزیکول گنبدی شکل dome) - like) به قطر 20 میکرون ختم میشود وزیکول در تمام سطح بارور است و فیالیدها و رشته های کونیدی سرهای کونیدیایی آن را احاطه کرده اند روی وزیکول یک ردیف فیالید قمقمهای به ابعاد 3 تا 4 در 6 تا 8 میکرون قرار دارد که رشته های کوتاهی از کونیدیهای
ص: 141
کروی یا بیضی خاردار نامتقارن روی آنها قرار دارد تصویر شماره 65 در بعضی گونه ها بویژه در محیط کشت محتوی 20 درصد ،قند ساختاری کروی یا تخم مرغی به قطر 100 تا 250 میکرون تشکیل میشود که بوسیله توده ای از میسیلیوم احاطه میشوند این ساختار پری تشیا نامیده میشود تعدادی آسک بیضی شکل به اندازه 10 تا 12 میکرون بطور نامنظم درون پری تشیا وجود دارد. درون آسکها آسکوسپورهای عدسی شکل (lenticular) با جدار صاف یا ناصاف و معمولا واجد یک خط کمربندی وجود دارد این خط کمربندی ممکن است واجد برجستگی و فرورفتگی باشد و اسپور را به دو نیم تقسیم می.کند این قارچ آلرژن و پاتوژن میباشد
تصویر شماره 64

تصویر شماره 65
ص: 142
ابعاد کونیدیا 4-2/5 میکرون است در خاکهای گرم دانههای غلات حبوبات و در فساد ثانویه سبزیجات یافت میشوند با ناراحتی های تنفسی در بعضی از افراد ساکن در خانه ها در ارتباط است. توکسین پاتولین تولید میکند که در انسان و دیگر حیوانات ایجاد بیماری مینماید
ابعاد کونیدیا 4-2 میکرون .است در خاکهای ملایم و در گیاهان در حال فساد دیده میشود. توکسین استریگماتوسیستین (Strigmatocystin) تولید می.کند این توکسین باعث آسیب به کبد و کلیه در حیوانات آزمایشگاهی میشود این قارچ در ارتباط با آسپر جیلوزیس ریه ها و آسپرجیلوزیس منتشره مطرح شده است. تصاویر شماره 66 الی 71 مناظر کلنی و میکروسکپی آسپر جیلوس نیدولانس را نشان میدهد.
تصویر شماره 66

تصویر شماره 67
ص: 143
تصویر شماره 68

تصویر شماره 69
تصویر شماره 70
تصویر شماره 71
ص: 144
ابعاد کونیدیا 3-2/5 میکرون است تصویر) شماره (72 در غلات و حبوبات خاک و محصولات غذایی شور دیده میشود. معمولاً با فساد گیاهی مرتبط نیست قادر به تولید یک توکسین آسیب رساننده به کلیه ها بنام ochratoxin A میباشند که موجب بروز اوکراتوکسیکوزیس در انسان می.شود این بیماری تحت عنوان نفروپاتی بالکان شناخته شده است توکسین تحت شرایط مطلوب برای رشد ،قارچ دمای 25 درجه سانتیگراد و شرایط رطوبت بالا ایجاد میشود او کراتوکسین بوسیله گونههای دیگر آسپرجیلوس و پنیسیلیوم تولید میشود توکسینهای دیگری که توسط این قارچ تولید میشوند شامل اسید پنی سیلیک، زانتومگنین (Xanthomegnin) و ویومیلین می.باشد تمام این توکسینها برای کلیه و کبد سمی هستند
تصویر شماره 72

بعضی از استرینها قادر به تولید یک گروه از مایکوتوکسین ها در گروه آفلاتوکسین هستند. این توکسین از طریق خوراکی در انسانها تولید مسمومیت می.کند تولید این توکسین توسط قارچ به شرایط رشد قارچ و سوسبترای استفاده شده به عنوان منبع غذایی بستگی دارد
ص: 145
ابعاد كونيديا 5-4 × 3/5-3 میکرون تصویر شماره 73 و (74 و در نواحی که میزان آب در آن کم است میتواند رشد کند در گرد و غبار خانه ها و در غذا یافت میشود.
تصویر شماره 73

تصویر شماره 74
ص: 146
ابعاد کونیدی 3/5-2 میکرون است. بطور شایع در خاک یونجه و علف پنبه و محصولات لبنی یافت میشود تصویر شماره 75 منظره کلنی و تصاویر شماره 76 و 77 مناظر میکروسکپی این قارچ را نشان میدهند
مایکوتوکسینی بنام استریگما توسیستین و اسید سیکلوپیاکسونیک تولید می کند. این توکسین ها باعث ایجاد اسهال و آشفتگی معده می.شوند راجع به کارسینوژن بودن آنها برای کبد و کلیه گزارشهایی وجود دارد.
تصویر شماره 75

تصویر شماره 76 و 777
ص: 147
تصویر شماره 78

کلنی های این قارچ دارای رشد سریع و در ابتدا سفید و کرکی و با گذشت زمان تیره رنگ میشوند کونیدیوفور بصورت کشیده، ساده یا منشعب با جداری صاف یا خشن بوده و در رأس آن گروهی از فیالیدها دیده میشوند فیالیدها شفاف یا رنگین بدون تیغه میانی بوده و بطور متوالی ایجاد کونید یا میکنند. کونید یا سیاه، تک سلولی، گرد یا بیضی شکل با جداری صاف یا خشن بوده و توسط ماده لزج و چسبنده ای به یکدیگر متصل شده اند
(تصویر شماره 78)
دارای کلنیهای تیره رنگ مخملی یا کرکی با رشد سریع میباشند پشت کلنی سیاه رنگ است. دستگاه زایشی آن از کونید یوفورهای قهوه ای ساده و یا همراه با انشعابات جانبی کم تشکیل شده که در ناحیه رأسی متورم شده و دارای منافذ ریزی هستند که از طریق آنها کونیدیها خارج میشوند بعد از خروج اولین کونیدی و در محل اسکار ناشی از خروج ،آن کونیدیوفور تکثیر کرده و رأس آن متورم شده و کونیدیای دوم را تولید میکند به دلیل تکرار این مراحل کونید یوفور گره دار به نظر میرسد کونیدیاها ،منفرد نیمه کروی یا کشیده دارای تیغه های میانی و به شکل توت و به رنگ قهوه ای تیره بوده و ممکن است در ناحیه تیغه های میانی با یا بدون فشردگی باشند کونیدیاها دارای جداری صاف یا خشن و انتهایی برجسته یا صاف هستند (تصویر شماره 79 و 80)
تصویر شماره 79
تصویر شماره 80
ص: 148
تصویر شماره 81
از عوامل ایجاد کننده بیماری قارچی ناخن انیکومایکوز) بیماری قارچی چشم کراتیت قارچی و اوتیت یا بیماری قارچی گوش خارجی میباشد کونیدیهای این قارچ منظره ای شبیه لیمو دارند که در سطح خارجی آنها کرک یا خارهای ریز و ظریفی دیده میشود کونیدیوفور منظره ای شبیه پنیسیلیوم دارد دارای ساختمان پنی سیلی است یعنی ساختمان کونیدیازایی آن شبیه ،برس فرچه ویا جارو میباشند از عوامل آلوده کننده پنیر میباشد که به آن طعم تلخ و نامطلوبی می دهد قارچی با رشد کند است در ابتدا صاف و غشایی یا پوستی شکل و چین دار و سپس پودری شکل شده و به رنگ قهوه ای روشن در می آید (تصویر شماره 81) پشت کلنی بی رنگ .است میسیلیوم رویشی آن گاهی به شکل دستجات بهم پیوسته درآمده و یا دارای پیوندهای جانبی هستند. برخلاف پنیسیلیوم هیچگاه کلنیهای این قارچ به رنگ سبز و یا آبی مشاهده نمیشوند.
ساختمان اسپورزایی در اطراف میسیلیوم رویشی یا میسیلیومهای بهم پیوسته بطور غیر قرینه و فراوان وجود داشته و به دو صورت دیده میشود کونیدیوفور منشعب و پنی سیلوس مانند که شاخهای غیر قرینه و تقسیمات نامرتب دارد و کونید یوفور کوتاه و بطول 30-10 میکرون است. ساختمان پنی سیلی ،آن یک یا دو بار بطور غیر قرینه شاخه میزند
استریگما لوله ای شکل با یک قسمت قاعده ای پهن تر و یک رأس یا دهانه ای باریک شونده است که غالباً بخوبی شاخه های کونیدیوفور مشخص نمی باشد 5-4) 15-12 میکرون). كونيديا لیمویی شکل یا نخودی شکل به قطر 670 میکرون قاعده باریک و قسمت وسطی بر آمده و رأس نخودی دارد بطوریکه قسمت تحتانی آن حلقه ای شکل و سوراخ دار به نظر می رسد. جدار کونیدیا کلفت بوده و در سطح خارجی خود خار دار یا دانه دار است ) تصاویر شماره 82 و (83 در بعضی از انواع آن این سطح خاردار بخوبی مشخص نمی.باشد زنجیره کونیدیا از هم دور شونده بدون شاخه های جانبی و طول آن تا 150 میکرون میرسد این قارچ در خاک به فراوانی یافت می.شود اگر در روی سوبسترای آرسنیک رشد کند ممکن است گاز آرسین تولید .بنماید آرسین) گاز بی رنگ و محترق و سمی به فرمول
ص: 149
ASH می باشد این عمل میتواند بر روی کاغذهای دیواری که با سبز پاریس پوشانده شده است اتفاق افتد. این قارچ روی مواد بسیار متفاوتی از جمله در گرد و غبار خانه ها رشد میکند و با آلرژی تیپ 3 مرتبط است.
تصویر شماره 82

تصویر شماره 83
ص: 150
یازده گونه این جنس بعنوان عامل بیماری در انسان گزارش شدهاند که مهمترین و شایعترین آنها گونه برویکالیس است. این گونه نیز مانند پسیلومایسس باعث صدمه رساندن به مواد کاغذی شده و از یون آمونیم موجود در آن بعنوان منبع ازت استفاده می.کند این گونه در انسان عفونتهای چشمی و ناخن ایجاد میکند ضایعات گرانولومایی در ریه و توپ قارچی (fungus ball) سینوزیت اندوکاردیت و اندوفتالمیت توسط این قارچ نیز گزارش شده است.
تصویر شماره 84
Acremonium
نام دیگر این قارچ سفالوسپوریوم و شامل 100 گونه میباشد که اکثر آنها ساپروب هستند تاکنون 12 گونه بعنوان عامل بیماری در انسان شناخته شده است. بیماریزایی این قارچ عمدتاً محدود به گیاهان و حشرات است ولی گزارشهای متعددی برای بیماریزایی برخی از گونه های آن ،مانند Acremonium Kilinse
A. restrictum, A. falciforme A. recifei در انسان وجود دارد که میتوانند مایستوما عفونت قرنیه چشم (کراتیت) ضایعات ،جلدی ناخن (انیکومایکوز)، آرتریت و حتی مننژیت را ایجاد نمایند همچنین بعنوان قارچ آلرژی زا نیز گزارش شده است یک نوع سم بنام تریکوتسن تولید میکند تهوع، استفراغ و اسهال از علائم مسمومیت با این قارچ است. برخی گونههای آن تولید مایستوما میکند در بافت ایجاد گرانولهای سفید و نرم میکنند آکرومونیوم از خاک هوا و فاضلاب جدا
ص: 151
شده است و بعنوان قارچ آلرژی زا شناخته شده است آکرومونیوم علاوه بر ناخن و پوست از صفرا ،خون شیره معده و مایع نخاع نیز جدا شده است. علائم کلینیکی هیالوهایفومیکوز ناشی از آکرومونیوم شامل آرتریت استئومیلیت ،پریتونیت اندوکاردیت پنومونی، التهاب مغز و عفونت زیر جلدی است.
تصویر شماره 85

تصویر شماره 86
مشخصات :کلنی این قارچ با رشد کمی سریع در مدت 7 روز قطر کلنی آن به حدود 44-40 میلیمتر میرسد در ابتدا کلنی بهم فشرده و متراکم بوده ولی بزودی تمایل به پخش و گسترش در روی محیط کشت پیدا میکند منظره کلنی صاف نمدی شکل یا دانه ای و یا پودری و دارای شیارهای غیر منظم می باشد البته اغلب به صورت شعاعی و چین خورده است رنگ کلنی بر حسب گونههای آن متفاوت و معمولا به رنگ ،سفید ،خاکستری قرمز ،روشن ارغوانی کرم مایل به زرد نارنجی یا لیمویی صورتی دیده میشود پشت کلنی بیرنگ یا زرد قهوه ای و یا ارغوانی است تصاویر شماره 84 و 85 برخی از قارچها وجود دارند که اسپورهای آنها به صورت توده های مرطوب در نوک سلولهای کنید یوژنوس مستقیم و طویل تولید میشوند اینها عمدتا در درجه پیچیدگی انشعابات کونیدیوفور با هم تفاوت دارند ساده ترین آنها گروه وسیع آکرومونیوم میباشند. گونه های این قارچ بر روی اکثر محیطهای کشت رشد سریعی دارند کلنی آنها در ابتدا مسطح و با گذشت زمان پنبه ای شکل میشوند کلنیها به رنگهای سفید ،زرد، صورتی و نیز خاکستری دیده میشوند و پشت کلنی بی رنگ است.
ساختمان میکروسکپی میسیلیومهای رویشی نازک، منشعب با تیغه های میانی دارد. دارای کونید یوفور مشخص و واضحی نبوده و در اصل سلولهای مولد کونیدیا مستقیما از میسیلیومهای رویشی ریشه گرفته اند. کونیدیها عمدتاً تک سلولی بوده به اشکال ،کروی بیضوی استوانه ای شکل و کمی خمیده، شفاف و بی رنگ
ص: 152
میباشند که بوسیله ماده موکوئیدی و چسبناکی به یکدیگر اتصال یافته اند این اتصال سست بوده و هنگام دستکاری ) تهیه لام برای مشاهده میکروسکپی به آسانی و به سرعت پراکنده میشوند عموماً کونیدیها بصورت توده های کروی بر روی میسیلیوم های کوتاه دیده میشوند تصویر شماره 86)
کونید یوفور این قارچ در صورت مشاهده کوتاه و مستقیم به پهنای 3 میکرون و بطول 20 تا 60 میکرون و بدون تیغه میانی و شاخه های جانبی است کونیدیوفور به صورت شاخه های یک درمیان در اطراف میسیلیوم هوایی بوجود می آید. هیفهای این قارچ به فیالیدهای بدون انشعاب و کوتاه ختم میشوند که گاه طویل گردیده و در طول آن دیواره عرضی بوجود می آید. کونید یا در رأس کونیدیوفور ایجاد شده تخم مرغی یا شلجمی کشیده بیضی خمیده شفاف و معمولا تک سلولی است و گاهی در اثر وجود یک یا دو تیغه میانی 2 تا 3 سلولی دیده میشوند کونیدیا تک تک در رأس کونیدیوفور ایجاد شده و در اثر فشار به یکدیگر تشکیل اسپور بهم فشرده و مجتمعی در رأس آن مینماید که بوسیله یک ماده چسبنده به یکدیگر چسبیده اند ولی این اتصال بقدری سست است که در اثر دستکاری به آسانی در محیط پراکنده میشوند هنگام تهیه اسلاید مرطوب میکروسکپی معمولا یک اسپور در اتصال به بعضی از سلولهای کونیدی را باقی میماند در کلنیهای شبه مخمری خوشه ای از اسپورها اغلب در اسلاید تهیه شده از حاشیه کلنی دیده می.شود اسپورهای آکرومونیوم گاهی مشابه حالت میکروکونیدیال فوزاریوم است تصویر شماره 87 اگرچه در فوزاریوم اسپورها معمولا قلوه ای شکل بوده و رنگ کلنی ارغوانی تر است تا نارنجی که در آکرومونیوم دیده میشود کونیدیها بیضی شکل و 1 تا 2 سلولی هستند گاهی زنجیروار و گاه به صورت توده ای در اطراف فیالیدها جمع میشوند.
برای شناسایی این قارچ محیط Potato dextrose Agan» و «Commealaga» بسیار مناسب هستند. اگر کلنی ها در معرض نور طبیعی قرار گیرند ویژگیهای رنگی کلنی ها به صورت نمایان تری خود را نشان خواهند داد.
تصویر شماره 87

ص: 153
در آکرومونیوم کلارت (collarette روی فیالید وجود ندارد یا در صورت وجود از رشد و توسعه بسیار محدودی برخوردار است همچنین فیالیدها درفشی شکل و بخوبی تمایز یافته اند و در قاعده خود دارای دیواره عرضی می.باشند
تصویر شماره 88

گونه های مختلف این قارچ از گندرویان شایع خاک میباشند که برخی از آنها برای گیاهان بیماریزا محسوب میشوند از شایع ترین قارچهای سیاه آلوده کننده محیطهای کشت در آزمایشگاه میباشند.
یک آلرژن بسیار شایع است. اغلب اوقات در قالی منسوجات و بر روی سطوح افقی قسمتهای داخلی ساختمانها اغلب روی فریمهای چارچوب پنجره ها یافت میشود ممکن است در فضای خارج ساختمانها از نمونه های خاک دانه ها و گیاهان جدا شود. این قارچ بطور شایع در نمونه هوای خارج ساختمانها وجود دارد. ساختمان :ظاهری رشد سریع سطح کلنی در ابتدا صاف و در نهایت کرکی میشود رنگ کلنی بسته به گونه آن متفاوت بوده و به رنگهای سبز زیتونی ،قهوه ای ،دودی، خاکستری و یا سیاه
ص: 154
دیده میشود پشت کلنی سیاه رنگ است تصویر شماره (90
ساختمان میکروسکپی میسیلیومهای رویشی ،سیاه منشعب و واجد تیغه میانی می باشند کونیدیوفور ساده، کوتاه، دارای تیغه میانی و اغلب غیر منشعب است. کونیدیاها سیاه رنگ، چماقی یا توتی شکل، پایه کونیدیا پهن و محدب و رأس کونیدیا باریک و کشیده است تصاویر شماره 88 و 89) تیغه های طولی و عرضی کونیدیاها را به قطعات کوچکی تقسیم نموده بطوریکه شبیه نارنجک دیده میشوند کونیدیاها بدنبال یکدیگر و بصورت
تصویر شماره 89

تصویر شماره 90
زنجیرهای کوتاه دیده میشوند تکثیر کونیدیا به روش آکروپتال و ابعاد کونیدیا 837180-18 میکرون است. اندازه اسپورهای بزرگ آن که 200-20 میکرون طول و 718 میکرون عرض دارد (تصویر شماره 91 اجازه میدهد که اسپورهای این قارچ در بینی دهان و راههای فوقانی تنفس رسوب کند و با آسم نانوایان در ارتباط است. گونه آلترناریا آلترناتا قادر به تولید اسید تنازوئیک و متابولیتهای سمی مختلف است که با بیماری انسان یا حیوانات در ارتباط است عامل شایع آسم اکسترنزیک ازدیاد حساسیت نوع (I .است علائم حاد شامل آدم و برونکواسپاسم و در موارد مزمن ممکن است آمفیزم ریوی ایجاد شود.
شش گونه از جنس آلترناریا قادرند موجب بروز عفونت در افرادی شوند که بعلت ضعف سیستم ایمنی مستعد شده اند که مهمترین آنها آلترناریا آلترناتا میباشد. آلترناریا بخوبی قادر به رشد و ایجاد کلنی بر روی سطح برهنه و مرطوب ضایعه یا زخم قبلی پوست بوده و بطور مکرر نیز از این مناطق جدا میشوند هر چند که در آسیب زایی آنها هنوز اطمینان کافی وجود ندارد. گزارشهای معتبری از بروز فئوهایفومایکوزیس توسط این قارچ وجود دارد ،استئومیلیت عفونت ،بینی ندولهای ریوی لوکالیزه و نیز ندولهای جلدی از
ص: 155
تصویر شماره 91

انواع آزردگی های دیگری است که توسط این قارچ و اغلب در افراد واجد اختلالات سیستم ایمنی دیده و گزارش شده اند.
اکثر گونه های این قارچ گنده رویانی هستند که در طبیعت به فراوانی وجود داشته و غالباً در خاک روی گلها و چوب زندگی میکنند و موجب خرابی و فساد میوههایی مانند گلابی و پرتقال میشوند. گزارشهایی نیز مبنی بر بیماری زایی گونه پولولانس (A. pullulans در دست می باشد.
کلنی ،مسطح نرم و paste - like یا مرطوب و موکوئید است و ظاهری مخمری داشته و در ابتدا ممکن است به رنگهای سفید و صورتی روشن مشاهده شوند ولی به سرعت تیره گشته و به رنگهای قهوه ای تیره و یا سیاه براق با حاشیههای کم رنگتر دیده میشوند کلنی ها در مجموع شباهت بسیار به واریته های سیاه رنگ اسپوروتریکس شنکئی دارند پشت کلنی آنان نیز سیاه رنگ می.باشد میسیلیوم هوایی ندارد و یا مقدار آن کم است به رنگ سفید یا صورتی کمرنگ است و اغلب تغییر رنگ در کلنی بصورت نواحی تیره سبز مایل به سیاه ایجاد میشود تصویر شماره (92) این قارچ اغلب به عنوان مخمر در نظر گرفته میشود اسپورهای آن بلاستوسپور حقیقی است که ممکن است جوانههای ثانوی ایجاد نماید گرچه اساسا کلنی میسلیال پیگمانتاسیون آن به تشخیص قارچ کمک می کند.
همچنین اسپورهایی که بعدا بوجود می آیند به صورت تودهای اغلب متورم و شبیه کوسن یا بالش
ص: 156
می.باشند معمولا باعث بروز عفونت در انسان نمیشود . برخلاف اکثر گونه های دیگر این جنس که پارازیتهای اختصاصی گیاهان هستند، A. pullulans روی گیاهان در حال فساد زندگی میکند. واجد هیفهای بزرگ تیره رنگ با جدار عرضی و دیواره ضخیم است که به همراه آنهایفهای ظریف شفاف با دیواره نازک نیز دیده می.شود در اطراف سلولهای کونیدی،زا کونیدیهای شفاف تشکیل میشود و در محل آزاد شدن در روی سلولهای کونیدی را نشانه های دندانه مانند باقی میماند کونیدی جوانه میزند و بلاستوکونیدی ایجاد مینماید از ضایعات زگیلی شکل جدا شده و عفونت آن در جوجه تیغی نیز گزارش شده است. در بررسی میکروسکوپی کشتهای ،جوان میسیلیومها باریک بوده و جدار نازک و بی رنگی دارند ولی به مرور زمان میسیلیومها قطور و طویل ،گشته جدارشان ضخیم و رنگشان تیره شده و در نهایت به زنجیره ای از سلولهای چهار گوش دو جداره و سیاه رنگ تبدیل میگردند تصویر شماره (93 در کلنیهای جوان و همچنین در کشتهای کهنه کونیدیوفور فرق چندانی با میسیلیومهای رویشی نداشته و چنین به نظر میرسد که کونیدیاها مستقیماً از میسیلیومهای رویشی منشاء گرفته اند. در کلنیهای جوان تعداد زیادی کونیدیاهای کروی و یا بیضی شکل در اطراف میسیلیومها دیده میشوند که بی رنگ بوده و یا نخودی بوده و بر روی یک برجستگی کوچک دانه مانندی قرار میگیرند .کونیدیاها به سرعت جوانه زده و و ایجاد توده ای از کونیدیا را میکنند در کلنیهای کهنه کونیدیاها تیره تر شده و پخش میشوند در عین حال ممکن است از پاره ای از سلولهای قطور میسیلیومهای قدیمی لولههای زایای کوچکی خارج گشته و ایجاد جوانه کوچکی را بنمایند و یا آن که لولههای زایا رشد نموده و میسیلیوم های تازه و باریکی را ایجاد کنند.
تصویر شماره 92

تصویر شماره 93
ص: 157
عمدتاً جزو قارچهای گندروی محیطی بوده و مواردی از آن بعنوان عامل فئوهایفومایکوز گزارش شده است. دارای رشد سریعی بوده کلنیهای قهوه ای تیره ایجاد میکند (تصویر شماره (94) کونیدیوفور این قارچ کشیده و صاف با تیغه های میانی نزدیک به هم و به رنگ قهوه ای و سمپودیال زیگزاگی .است کونیدیوفورها بصورت گروهی رشد می.کنند. کونیدیها از منافذ موجود بر روی کونیدیوفور خارج شده به شکل تخم مرغ یا بیضی پهن بوده و بدلیل وجود تیغه های درونی شباهتی به میوه توت دارند کونیدیها به رنگ قهوه ای تیره بوده و بصورت منفرد و یا بصورت گروهی در اطراف یک منفذ دیده میشوند تصویر شماره 95 و 96).
تصویر شماره 94

تصویر شماره 95 و 96
ص: 158
تصویر شماره 97

قارچی با اسپورهای بزرگ که در مجاری تنفسی فوقانی به دام می افتند . این قارچ مایکوتوکسینی به نام استریگما توسیستین تولید میکند که باعث آسیب کبد و کلیه در حیوانات آزمایشگاهی میشود
بایپولاریس قارچ سیاهی است که از نظر کونید یازایی ساختمانی شبیه به جنسهای درکسلرا واكسروهيلوم (Exserohilum) دارد سه گونها سپیسیفرا
( B, spicifera) هاوائینسیس (B. hawaiiensis) و استرالینسیس (ustraliensis ... بیماری زا می.باشند بایپولاریس دارای تکثیر جنسی بوده و به همین علت نیز در جنس کوچلیوبولوس (Cochliobolus) طبقه بندی میشود.
کلنی آن رشد سریعی داشته به رنگ قهوه ای خاکستری دودی تا تقریباً سیاه رنگ است (تصویر شماره 97 از نظر میکروسکپی میسیلیومهای رویشی آن فرق چندانی با دیگر قارچهای سیاه ندارند. کونیدیوفورها مشخص بلند تیره رنگ و دارای تیغه میانی هستند. اغلب ساده و گاه دارای شاخههای جانبی بوده و به صورت گروهی رشد میکنند کونیدیاها بزرگ و تیره رنگ بوده و دارای تیغه های کاذب افقی هستند. ماکرو کونیدیا ماکروکونیدیاها از منافذ کوچک و نزدیک به هم از رأس کونیدیوفور خارج گشته و به صورت دسته های چند تایی دیده میشوند تصاویر شماره 98 و 99
تصویر شماره 98
تصویر شماره 99
ص: 159
ابعاد کونیدیا 59 × 14-7 میکرون میباشد پارازیت گیاهان و میوههای نرم و آلرژن است در خاک و سبزیجات یافت میشود منظره کلنی در تصویر شماره 100 و منظرهی میکروسکپی بوتریتیس در تصویر شماره 101 مشاهده می.شود
تصویر شماره 100

تصویر شماره 101
ص: 160
کلنی با میسیلیومهای هوایی متراکم به رنگ سفید خالص است و در آزمایش میکروسکپی اغلب اسپورهای کوچک و پراکنده و محدودی را نشان می دهد که غیر پیگمانته و بیضی.اند اینها به صورت انفرادی در یک زمان در نوک یا رأس رشته های زیگزاگی شکل نازک بوجود می آیند یک سلول کونیدی زای بالغ اسپورهایی را که در زوایای زیگزاگ مانند تشکیل شده در بر دارد اگر چه غالباً فقط جوانترین اسپور انتهایی به صورت متصل باقی میماند تصاویر شماره 102 و 103) این قارچ و وابستگانش برای حشرات پاتوژن میباشد گزارشهایی از میکوزهای به علت این قارچ در خزندگان وجود دارد.
گونه های این جنس قارچی در طبیعت به صورت گنده رو زندگی میکنند ولی دو گونه آن به نامهای
براسیکانا (Brassicana) و دنسا (Bensa قادر به ایجاد ضایعه و عفونت در انسان می باشند.
کلنی های بیوریا رشد متوسطی داشته سفید و یا نسبتا رنگین بوده و ظاهری پودری و یا کرکی دارند. میسیلیومهای رویشی آن باریک و جداری نازک دارند کونیدیوفور ساده و یا منشعب بوده و فرق چندانی با میسیلیومهای رویشی .ندارد سلولهای کونیدیازا (استریگما) در انتهای کونیدیوفورها قرار داشته، قاعده ای پهن و انتهایی تیز و منقار مانند دارند کونیدیاها معمولا به صورت گروهی (Sympodial) به طور غیر منظم و یا توده شعاعی ،شکل در انتهای کونیدیوفورها دیده میشوند کونیدیاها تک سلولی کوچک شفاف گرد یا بیضی شکل بوده و تک تک از استریگماهای نامشخص فوق الذکر تولید میشوند
تصویر شماره 102

تصویر شماره 103
ص: 161
تصویر شماره 104
بطور شایع در خاک و گرد وغبار و کمتر در هوا یافت میشود P. variotii باعث پسیلومایکوزیس میگردد در ارتباط با بیماری مربوط به نجاران و منبت کاران و بیماریهای مرتبط با دستگاههای رطوبت ساز گزارش شده است که آلرژیک می.باشند برخی از اعضاء این جنس ایجاد کننده پنومونی میباشند. اگر روی سوسبتراهای آرسنیکی رشد کنند ممکن است گاز آرسنیک تولید کنند این امر در
نتیجه رشد آنها روی کاغذ دیوارهایی که با سبز پاریس پوشانده شده اند اتفاق می افتد.
قارچهایی ساپروب با انتشار وسیع بوده که به طور معمول موجب آلودگی و فساد میوه ها و سبزیها می گردند از این قارچ آنتی بیوتیکی به نام واریوتین (variotin ) جدا شده که در درمان بعضی از ضایعات قارچی جلدی مؤثر .است پاره ای از گونه های پسیلومایسس بندرت در انسان ایجاد ضایعات ناخن و چشم را می نمایند گزارشهایی نیز مبنی بر ایجاد اندوکاردیت متعاقب عمل جراحی قلب باز، ذات الریه در افراد مبتلا به لوسمی سلول موئی (Hairy cell leukemia)، سینوزیت و نفریت در بیماران مستعد توسط گونه واریوتی P. varioti) موجود است. پسیلومایسس دارای رشد سریع بوده و کلنی آن ظاهری پودری و اندکی مخملی دارد (تصویر شماره 104). از نظر ریز بینی میسیلیومهای آن پهن منشعب و با تیغه میانی هستند هر چند دستگاه زایشی آن مشابه با جنس پنیسیلیوم میباشد ولی فیالیدهای پسیلومایسس پهن تر بوده و هیچ گاه کونیدیاها به رنگ سبز و یا آبی مشاهده نمیشوند بعضی از گونه های پسیلومایسس دارای کونید یوفور مشخصی با تیغه میانی ساده و یا منشعب بوده ولی پاره ای دیگر فاقد کونیدیوفور مشخص می باشد. فیالیدها در انتها قرار می گیرند و ممکن است انتهای کونید یوفورها به یک فیالید ختم شود (monoverticil) و یا آنکه برروی هر کونید یوفورچند فیالید قرار گیرد (polyverticil). همان طور که گفته شد ممکن است فیالیدها بر روی میسیلیومهایی قرار گیرند که فرق چندانی با سایر میسیلیومهای رویشی نداشته و تنها دارای انتهای پهن تر از دیگران باشند از دهانه فیالیدها کونیدیاهای بیضی لیمویی شکل و یا بندرت کشیده و استوانه ای شکل خارج گشته و ایجاد زنجیره ای از کونیدیا را می.کنند کونیدیاها شفاف، بیرنگ
ص: 162
و یا به رنگهای روشن زرد یا صورتی بسیار (کمرنگ میباشند. جدار آنها صاف و یا کمی خشن است. زنجیره کونیدیاها نیز مستقیم بوده و فاقد زنجیره های جانبی است بعضی از گونه های آن ایجاد کلامیدو کونید یا می نمایند. از آنجایی که بعضی از گونه های پسیلومایسس دارای تکثیر جنسی میباشند آنها را در جنسهای بایسو کلامیس (Byssochlamys)، تالارومایسس (Talaromyces) و ترمواسکوس (Thermoascus) طبقه بندی مینمایند.
کلنی دارای رشد سریع قطر کلنی در عرض 5 روز به 7 سانتیمتر میرسد ) بوده بصورت پوشش صاف و نازکی سطح آگار را فرا می گیرد کلنی رنگ سبز ،طلایی، خاکستری مایل به قهوه ای یا صورتی دارد ممکن است به رنگ قهوه ای زرد یا سبز قهوه ای نیز دیده شود همچنین ممکن است پشت کلنی بی رنگ یا زرد قهوه ای باشد. ساختمان اسپورزایی آن اکثرا پنی سیلی می باشد ولی علاوه بر آن اسپورهای دیگری که بنام اسپورهای درشت Macrospore گفته میشوند و به شکل کروی یا نزدیک به آن و به ابعاد 8-6 میکرون در نزدیکی میسیلیوم رویشی و مجاور سطح کشت دارد.
تصویر شماره 105

کونیدیوفورها با جدار صاف و نازک 4 × 90-80 میکرون و در انتهای خود به 4 تا 6 شاخه چتری مانند ختم میشوند. اکثراً در اطراف کونیدیوفور انشعاباتی دیده میشود که فقط از استریگما بوجود آمدهاند کونید یوفورها از میسیلیوم هوایی بوجود می آیند. ساختمان پنی سیلیوس واجد انشعابات چتری شکل و اکثراً غیر منظم و چندین بار تقسیم شده است. شاخهها قاعده باریک تر و رأس پهن تری داشته و در رأس خود نیز یک یا دو بار تقسیم میشوند و هر یک 4-3 شاخه یا متولا در رأس خود دارند و غالباً واجد یک یا چند تیغه میانی بوده و به اندازه 5-3×40 - 30 میکرون می باشند. استریگما قمقمه ای شکل با دهانه کشیده
یا مانند چماق ،واژگون واجد یک قسمت بدنه ای یک دهانه نسبتا طویل و بتدریج باریک شونده است که از محور اصلی بدنه به سمتی خم
ص: 163
می،شود بطوریکه ما بین محور این دو قسمت زاویه منفرجهای وجود دارد استریگماها از یکدیگر دور شونده میباشند کونید یا لیمویی شکل به فرم بیضی کشیده یا خربزه ای شکل با جدار صاف یا کمی مخطط و کلفت است که بتدریج از دهانه استریگما خارج میشوند زنجیره کونیدیا بدون شاخههای جانبی نسبتا طویل و از یکدیگر دور شونده هستند. فیالیدهای این قارچ بطور منفرد یا مجتمع بر روی کونیدیوفور و یا مستقیماً در روی هیفهای رویشی تشکیل می گردند (تصاویر) شماره 105 و 106)
تصویر شماره 106

این قارچ در خاک به وفور یافت میگردد. از این قارچ آنتی بیوتیکی بنام verotin جدا کرده اند که در بعضی از ضایعات قارچی پوست مؤثر است برخی از گونه های آن را از عوامل ضد عفونی کننده مانند ساولن در اتاقهای عمل یا بخشهای مراقبت ویژه جدا کردهاند که به راحتی قادر به رشد و زنده ماندن در این مواد بوده است. این قارچ بندرت به عنوان عامل اندوکاردیت کراتیت و عفونت ریوی شناخته شده است از طرفی پسیلومایسس شباهت به ورتیسیلیوم، اکرومونیوم و پنیسیلیوم دارد اختلاف آن با پنیسیلیوم بیشتر در ایجاد رنگ طلایی است. علاوه بر سلولهای کیندی زای اغلب) منفرد و طویل این قارچها از دیگر گونه های پنیسیلیوم در رنگ اسپور فرق میکنند. اسپورها و کلنی در P. Lilacinum ارغوانی ،کمرنگ در حالیکه در varioti . آنها قهوه ای هستند به شکل ماسه یا ریگهای قهوه ای رنگ هر دو نوع فوق دارای کلنیهای مسطح و پودری با رشد متوسط میباشند گونه های این قارچ گاهگاهی به عنوان عامل عفونتهای عمقی در جانوران خونسرد و حشرات گزارش شده اند.
Paecilomyces varioti به کاغذ صدمه میزند و کلنیهای آن به رنگ زرد با سایه های قهوه ای روشن می باشند.
ص: 164
تصویر شماره 107

تعداد متنوعی از ارگانیسم ها در این جنس جای دارند شناسایی گونه ها مشکل است. معمولاً در خاک، غذا، سلولز و دانه ها یافت میشوند میتواند سبب پنمونیت ازدیاد حساسیت و آلوئلیت آلرژیک در افراد حساس شود. خاصیت آلرژیک برای پوست دارد بطور شایع در قالیچه کاغذ دیواری و در داخل مجاری یا لوله های عایق فایبرگلاس دیده میشوند. برخی از گونه ها مایکوتوکسین تولید میکنند عامل معمولی آسم اکستر نزیک ازدیاد حساسیت است علائم حاد شامل ادم خیز و ورم ) و برونکواسپاسم ،است حالات مزمن ممكن است به سمت آمفیزم ریوی گسترش پیدا نماید.
پنیسیلیوم از بیماران مبتلا به کراتیت، اندوفتالمیت اتومایکوزیس ازوفاژیت نکروزدهنده پنومونی اندوکاردیت، پریتونیت و عفونتهای مجاری ادراری جدا شده است. اغلب اینگونه عفونتها در بیمارانی اتفاق افتاده است که از نظر سیستم ایمنی نقص و نارسایی مشاهده می.شود عفونتهای قرنیه چشم اغلب بعد از
ضربه و تروما بوده است.
پنیسیلیوم و روکوزوم مایکوتوکسینی تولید میکند ) ochratoxin) که یک نفروتوکسین و کارسینوژن قابل توجهی است معمولاً بر روی دانه غلات و حبوبات در نواحی سرد این سم را تولید مینماید. مشخصات عمومی جنس پنیسیلیوم جنس پنیسیلیوم گروه بزرگی از قارچها در حدود 800 (گونه را در بر میگیرد کلنی آنها دارای رشد سریع میباشند و معمولاً کلنی ،پودری صاف و سبز مایل به آبی مربوط به پیگمانتاسیون (اسپورها ایجاد مینمایند که تدریجا به رنگ خاکستری مایل به قهوه ای تبدیل می.گردد در گونه های مختلف رنگ سطح کلنی متفاوت است سفید ،آبی صورتی قهوه ای ،نارنجی پشت کلنی غالباً بی رنگ قهوه ای یا قرمز است (تصویر شماره 108
ساختمان میکروسکپی در این جنس کونیدیوفورها منشعب یا ساده.اند سلولهای کونیدی زا
ص: 165
بطری شکل هستند و فیالید نام دارند فیالیدها یا مستقیماً در انتهای کونیدیوفور یا در روی انشعابات کونیدیوفور(metula) قرار میگیرند و حالتی شبیه جارو ) یا مسواک ( دارند که به آن ساختمان پنی سیلی یا پنی سیلوس می.گویند کونیدیها عموما کروی ،شکل با دیواره خاردار یا ،صاف بی رنگ یا سبزرنگ میباشند این جنس از زنجیره هایی از کونیدیهای تک سلولی تشکیل شدهاند که از آن سلول کونیدی زای اختصاصی بنام فیالید بصورت basipetal تولید میشوند (تصویر شماره 107)
تصویر شماره 108
برای شناسایی پنیسیلیومها آنها را در محیط Potato dextrose Ager و Czaped dox Agar کشت داده و در 25 درجه سانتیگراد انکوبه مینمایند. اکثر گونهها ظرف 7 روز اسپورزایی می.کنند. برخی از جنسهای دیگر شباهت میکروسکپی خیلی زیادی با این قارچ دارند گلیو کلادیوم و تریکو در ما بوسیله توده ها یا خوشههای اسپور مشخص میشوند و زنجیره های هیدور فوبیک تشکیل نمی دهند پسیلومایسس بوسیله گردن دراز سلول کونیدیوژنوس فیالید) مشخص می گردد برخی از گونههای شایع تر این قارج به سیکلوهگزامید مقاوم هستند
اهمیت کلینیکی بسیاری از گونه های پنیسیلیوم آلوده کننده های شایع سوسبتراهای مختلفی بوده و بعنوان تولید کننده های بالقوه مایکوتوکسین مطرح میباشند بنابراین شناسایی دقیق آنها بویژه اگر آلوده کننده
ص: 166
مواد غذایی باشند بسیار اهمیت دارد برخی از گونه ها دارای خواص بیماریزایی می.باشند به بیماری عمقی و درونی ایجاد شده توسط این گونه پنی سیلیوز می.گویند اشکال درون سلولی آن شبیه به قارچ بیماریزای حقیقی هیستوپلاسما کپسولاتم می.باشد گونههای پاتوژن برای انسان نادر هستند اما عفونت با گونه های فرصت طلب باعث ایجاد کراتیت ،قارچی اتومایکوزیس و اندوکاردیت می.شود. اخیرا عفونتهای ریوی و منتشره بویژه بوسیله marneffei . در بیماران مبتلا به AIDS گزارش شده اند.
گونه های این قارچ به دلیل تولید فرآوردههای دارویی نظیر داروهای ضد باکتریایی و یا ضد قارچی واجد اهمیت فراوان میباشند. برخی دیگر از گونه ها قادر به تولید توکسینهای سرطان زا و خطرناک میباشند بطور مثال از Pencillium griseofulvum داروی ضد قارچی گریزئوفولوین و از کشت P. rubrum و پنیسیلیوم پاتولوم توکسینهایی مانند پاتولین و آفلاتوکسین تولید میشود. همچنین گونههای پنیسیلیوم از رشد C. immitis جلوگیری میکنند این جنس بر روی الیاف سلولزی پارچه و کاغذ رشد میکند و با تولید آنزیمهایی از دسته آمیلازها و اسیدهای آلی مانند اسید لاکتیک اثر تخریبی روی الیاف باقی می گذارد
رشد سریع دارد و در مدت دو هفته قطر کلنی به 5060 میلی متر میرسد سطح کلنی مخملی ورنگ آن سبز و گاهی به رنگ سبز آبی است و در کشتهای کهنه خاکستری رنگ می.شود حالت منطقه ای (Zonate) در آن خیلی واضح است و در سطح کلنی شیارهای شعاعی فراوانی از مرکز به محیط دیده میشود. پشت کلنی بیرنگ و اکسودا (exudates) کوچک و محدود و بوی مخصوص ندارد کونيديوفور کوتاه 3/5-3 × 200-100 میکرون با جدار صاف و قسمت رأس آن پهن تر می شود. ساختمان پنی سیلی این قارچ همیشه و تقریباً یک شاخه ای و بدون انشعاب است. استریگما به صورت دستجات 12-10 تایی به هم فشرده قمقمه ای شکل که قسمت بدنه و دهانه آن تقریباً مساوی و 3/5-3 × 812 میکرون اندازه دارند و در رأس آنها زنجیره های کونیدی به صورت ستونی و موازی به طول تا 150 میکرون قرار دارند کونیدی کروی یا نزدیک به کروی با جدار نازک و صاف یا خیلی کم و به قطر 3/5-3 میکرون است. این قارچ از شایعترین پنیسیلیومهای موجود در طبیعت میباشد که در خاک و در مواد گیاهی در حال فساد فراوان یافت میشود و روی کلیه مواد آلی رشد میکند و باعث خرابی غلات و محصولات کشاورزی می.گردد در کارخانجات لبنیات سازی و در پنیر و کره باعث خرابی محصول میگردد این قارچ قادر است تانن (Tannin) را به عنوان منبع کربن مورد تغذیه قرار دهد.
ص: 167
قارچی است با رشد نسبتا متوسط که اندازه کلنی آن در مدت 2 هفته به حدود 2 سانتی متر میرسد کلنی این قارچ در قسمت مرکزی برجسته و در قسمت محیطی صاف و معمولا چهار شیار کم عمق از قسمت مرکزی به سمت محیط دارد منظره آن پنبه ای و رنگ کلنی سفید و حالت منطقه ای Zonate) ندارد. قطرات بیرنگ مایع exudates) در لابلای الیاف میسیلیوم وجود دارد پشت کلنی بیرنگ و کلنی بوی مخصوص سیب زمینی میدهد کونید یوفورها از میسیلیوم رویشی یا از میسیلیوم هوایی بوجود می آیند در حالت اول نسبتا بلند و طول آن 450-400 میکرون و در حالت دوم کوتاه و 100-50 میکرون طول دارد و ناصاف زبر و دارای پهنایی به اندازه 4-3 میکرون است ساختمان پنی سیلی (Penicilli) آن منشعب و شاخه دار و غیر قرینه و 2 تا 3 بار زیر متولا (metula) تقسیم میشود و 85-60 میکرون طول دارد شاخه ها جدار صاف و 4-3 × 20 15 میکرون طول دارد متولا در سطوح مختلف در پنی سیلی بوجود می آیند استریگما به درستی از متولا قابل تفکیک نبوده و معمولا در دستجات کوچکی بوجود میآیند کونیدی ابتدا خربزه ای شكل (elliptical) و بعداً کروی شکل میشود جدار آنها صاف و اندازه آنها 4/5-3/5 × 5-4 میکرون است. زنجیره کونیدی به شکل ستونهای به هم فشرده که یک دسته از دستجات دیگر دور میشود و به طول 50-70 میکرون دیده میشود از این قارچ و قارچ مشابه آن Comemberti . . در ساختن انواع پنیرهای Neufchatel و Comemberti استفاده میشود
رشد نسبتا سریع دارد و در مدت ده روز قطر آن به 34 سانتی متر میرسد کلنی آن صاف یک قسمت زیرین بهم فشرده و یک قسمت سطحی پودری دارد مرکز کلنی زرد رنگ و اطراف آن سبزآبی رنگ و در بعضی از ،انواع آبی خاکستری است حالت شیارهای شعاعی از مرکز به سمت محیط در آن دیده میشود فاقد حالت منطقه ای است ولی در محیط خود حاشیهای سفید رنگ به قطر 21 میلیمتر دارد. قطرات بی رنگ مایع گاهی خیلی درشت به اندازه 3-2 میلیمتر و رنگ پشت کلنی زرد یا زرد طلایی ،است در کشت های قدیمی دارای پیگمانی قهوه ای روشن است که در تمام محیط نفوذ میکند و بوی مخصوصی ندارد کونیدیوفور از میسیلیوم رویشی بوجود آمده و نسبتا بلند و به طول 450 - 250 میکرون و به عرض 3-2/5 میکرون با جدار صاف و بیرنگ است. ساختمان پنی سیلی معمولا دو شاخه و هر یک به یک دسته متولا ختم میشوند. در صورتی که شاخه ها موجود باشند 2/53*15 - 10 میکرون اندازه دارند متولا در دستجات 5-3 تایی و فاقد دهانه واضحی بوده و 3-2 × 10-8 میکرون اندازه دارند کونیدیها کروی یا نزدیک به کروی به قطر 3-2/5 میکرون با جدار صاف و رنگ زرد آبی میباشند
ص: 168
این قارچ کلنیهایی به رنگ ،زرد سبز تیره یا خاکستری - سبز تولید می.کند در آب یا عصاره سیب کلونیزه شده و رشد میکند کونیدیوفورها طویل بوده و طولی برابر 500 میکرون یا بیشتر دارند و میتوانند صاف یا خشن و خاردار باشند. کونیدیها به فراوانی تولید میشوند و دیواره آنها خاردار است. این قارچ عمدتاً در خاک و بقایای مواد آلی و میوهای فاسد شده یافت می.شود در دمای صفر درجه رشد میکند و آسیبهای شدید به سیب و هلو در زمان انبارداری وارد میسازد
واجد کونيديوفورهایی است که در انتهای آنها حلقه قرینه ساده ای از استریگمای کاملا فشرده وجود دارد. کلنیها به رنگ زرد - سبز مشاهده میشوند و فاقد پری ،تشیا ،اسکلروتشیا هستند این کلنی ها به سرعت بر روی اکثر محیطهای کشت پخش و گسترده میشوند. کونیدیها دارای خارهای مشخص هستند. رنگ پشت کلنی بی رنگ متمایل به سبز و یا متمایل به قهوه ای می باشد.
گونه های این قارچ مهمترین عوامل تولید کننده اسید پنی سیلیک میباشند کلنیهای این سری به رنگ آبی - سبز مشاهده میشوند و بصورت دسته دسته در نواحی حاشیه ای کلنی قرار میگیرند پشت کلنیها غالباً به رنگ نارنجی - قهوه ای تا قرمز تیره یا ارغوانی دیده میشود این قارچها به فراوانی در طبیعت پراکنده هستند و از ذرت و سایر محصولات کشاورزی جدا شده اند (تصویر شماره 109
تصویر شماره 109
ص: 169
کلنی ها عمدتاً حالت مخملی دارند و بطور محدودی بر روی محیط چاپکس رشد میکنند و برروی این محیط هایفهای هوایی زرد تا نارنجی یا قرمز رنگ به همراه ساختمانهای کونیدیال زرد تیره تا سبز یا خاکستری سبز- تولید می.کنند نفوذ پیگمانها موجب ایجاد رنگ قرمز تیره یا قرمز مایل به ارغوانی در پشت کلنی ها میگردد.
کونیدیها بیضی شکل و قرینه هستند و در گونه پورپوروژنوم خاردار و در گونه روبرم صاف و بدون خار هستند رنگ هایفهای هوایی نیز در این دو گونه متفاوت است در گونه پورپوروژنوم به رنگ زرد یا نارنجی قرمز و در گونه روبروم به رنگ زرد سبز تا خاکستری - سبز مشاهده می.شود پنیسیلیوم روبروم و پنیسیلیوم پورپوروژنوم در طبیعت به فراوانی بر روی ترکیبات آلی و خاک حضور دارند. گونه پوپوروژنوم از ذرت جدا شده .است گونه روبروم نیز جزو چندین قارچ سمی است که از غلات و حبوبات پوسته و مغز بادام زمینی ذرت و دانه های آفتابگردان همچنین مکرراً از کاغذ مرطوب جداسازی شده است.
قارچ ساپروفیتی است که بویژه بر روی برگهای خشک علوفه یافت می.شود کونیدیهای آن آلوریواسپور نامیده میشود که به صورت منفرد در انتهای کونید یوفورهای کوتاه قرار میگیرد و خاردار و منقسم هستند. این اسپورهای قهوه ای رنگ منقسم پس از جدا شدن تکه کوچکی از کونیدیوفور را با خود حمل میکنند که این خصوصیت کمک مناسبی در شناسایی این جنس میکند (تصویر شماره 110) اسپورهای این قارچ حاوی اسپوریسمین میباشند که به دنبال مصرف باعث بیماری اگزمای صورت در گوسفند می.شود اگزمای صدفی در نشخوار کنندگان
تصویر شماره 110

ص: 170
ساختمان :ظاهری کلنی ها سریع رشد میکنند به رنگ خاکستری تا سیاه جیر مانند تا نرم بوده و پیگمانهای تیره تولید میکند
ساختمان میکروسکپی کونیدی پرسلولی فراگرا) یا دیکتیوکونیدی و به صورت شاخههای کوچک میخی شکل بر روی هیف ها روییده است. کونیدی بیضی پهن (کشیده گلابی مستطیلی و معمولاً خاردار یا صاف است بیماری زایی یک گونه آن به نام پیتومایسس کارتاریوم اغلب اگزمای عمیقی در صورت ایجاد میکند
تصویر شماره 111

روی مواد گیاهی فاسد شده خاک دانه های غلات و آرد وجود دارد.
ساختمان ظاهری رشد کلنی این قارچ سریع بوده و سطح آن ابتدا پشمی وسپس پودری میشود رنگ کلنی ابتدا سفید است ولی بعدا به رنگهای نارنجی صورتی وزرد نخودی در می آید .
ساختمان میکروسکپی ساختمان آن از میسیلیومهای شفاف با تیغه میانی و کونید یوفور طویل و باریک بدون انشعاب که در انتهای آن کونیدیهای نخودی بیضوی یا گلابی شکل دو سلولی با جدار صاف و نازک که به صورت دسته جمعی قرار دارند تشکیل شده است. این قارچ به علت داشتن کونیدیهای دو سلولی که در انتهای کونیدیوفور به صورت دسته جمعی قرار دارند به راحتی تشخیص داده میشود تصاویر شماره 111 و 112).
بیماری زایی : با ایجاد توکسین تریکوتسن در انسان و حیوان ایجاد بیماری میکند و قارچی آلرژیک است .
ص: 171
تصویر شماره 112

تریکوتشیوم روزئوم باعث ایجاد کلنیهای کرکی و پف کرده روی کاغذ میشود این کلنیها ابتدا سفید رنگ بوده سپس به رنگ قرمز کمرنگ در می آیند بهترین منبع ازت برای این قارچ نیز فسفات آمونیم است.
از قارچهای خاکزی است که در چوبهای پوسیده زیاد یافت میشود بعلاوه در ،کاغذ شیشه و سرامیک هم رشد میکند و مواد حاصل از متابولیسم آن سمی است
بیماری زایی قارچی آلرژیک است و از عوامل سببی بیماریهای ریوی میباشد.
تعیین گونه در جنس تریکودرما بر اساس مرفولوژی کونید یوفور، ضخامت stipe و درجه پیچیدگی انشعابات شکل فیالید و اندازه آن شکل و اندازه کونیدیا می.باشد مرفولوژی کونیدی از اهمیت کلی در شناسایی برخوردار است زیرا گونههای مختلف کلنی یکسانی دارند کلنی آن رشد سریعی دارد بطوریکه در مدت 5 روز تمام سطح بوات دوپتری را پر میکند کلنی در ابتدا صاف و نازک بوده و سپس دستجات پشمی سفید رنگ بتدریج در آن ظاهر میشود که الیاف آن بهم فشرده شده و در اثر بوجود آمدن کونیدیا سبزرنگ سبز خاکستری یا زرد مایل به سبز و سفید باقی میماند و تولید توده انبوهی از کونید یا در سطح کلنی میکند اغلب بر روی نواحی کوچک یا مدارهای حلقوی هم مرکز روی سطح آگار رشد می.کند پشت کلنی خاکستری
ص: 172
مایل به قهوه ای یا سیاه رنگ یا بی رنگ میباشد لکه های نا منظمی از اسپورولاسیون سبز که در اطراف پلیت بهتر دیده میشود ایجاد میشود کشت آن از نظر رنگ به پنیسیلیوم خیلی شبیه است اما حالت کلنی و منظره میکروسکپی آن با پنیسیلیوم فرق دارد. کونيديوفور این قارچ کوتاه و به شکل شاخه های نا منظم بوجود میآید 3-2/5 میکرون ) دو تا سه بار شاخه میزند.این شاخه ها به شکل چتری قرار نگرفته اند. کونیدیوفور در انتهای خود متورم نبوده و در رأس خود ایجاد کونیدیا میکند که به شکل دستجات چند تایی کنار هم قرار گرفته اند و با توجه به اینکه در ماده چسبنده ای نیستند به سهولت در موقع تهیه لام از هم جدا میشوند
فیالیدها بیضوی یا فلاسکی شکل هستند کونیدیها ،کوچک تک سلولی کروی تا بیضوی، صاف شفاف تا سبز رنگ میباشند و به شکل تودهای توپ مانند در نوک فیالیدها دیده میشوند
میسیلیومهای آنها شفاف منشعب با تیغه میانی است دستگاه زایشی از کونیدیو فورکوتاه، نامنظم، تقریباً مستقیم که غالباً به دو یا چند شاخه به رنگ زیتونی یا سیاه تقسیم میگردند تشکیل شده است. ساختمان اسپورزایی شبیه درخت .است کونیدیها تک سلولی گرد با جدار صاف یا خشن بوده و به صورت دسته جمعی در انتهای کونیدیوفور قرار دارند و به راحتی از هم جدا شده با یک تیغه میانی) و پخش میشوند. رنگ کونیدی سبز زیتونی گاهی بیرنگ است. کونیدیهای بالایی لزج و در انتهای نوک) فیالید بطری شکل بصورت خوشه ای شکل دیده میشود
کلنی ها معمولا تمام سطح پلیت را می پوشانند. اغلب پیرامون و محیط کلنی نامنظم است میسیلیومهای سفید تا زرد با کونیدیهای روشن تا زرد مایل به سبز پر رنگ ایجاد مینماید و پشت کلنی کمرنگ یا مایل به زرد است. معمولا در 5 و 37 درجه سانتیگراد رشد نمی کند اما گاهگاهی ژرمیناسیون دارد.
کونیدیوفور ساختمان خیلی منشعبی دارد تمام این انشعابات با زاویه قائمه هستند و شکل هرمی به کونیدیوفور میدهند فیالیدها آمپولی شکل هستند و معمولاً 3/5-3 57 میکرون می باشند. فیالیدهای انتهای کونید یوفور بزرگترند و کونیدیای منفرد پدید می آورند کونید یا اغلب به صورت دستجات کوچک بهم میچسبند گرد یا کروی یا گاهی تا حدودی بیضوی شکل به ابعاد 3/2 2/5 میکرون هستند و دیواره صافی دارند.
ص: 173
خصوصیات تشخیص این قارچ
کونیدیوفورهای خیلی منشعب به شکل هرم قاعده هرم شدیداً منشعب و شلوغ و رأس هرم فیالیدهای کمتری دارد که بصورت تک و منفرد دیده میشوند کونیدی صاف و حدوداً گرد و کروی است و طول آن در حدود 3/5 میکرون میباشد درجه مطلوب برای رشد harzianum . حدود 30 درجه سانتیگراد است این قارچ از خاک جنگل در اکثر نقاط دنیا جدا شده است.
مهمترین درجه افتراق این قارچ از T. harzianum این است که در این قارچ کونیدی دارای دیواره ناصاف است. ساختمان کونیدیوفور در هر دو مانند هم است. اما در مورد T. viride ممکن است از انشعابات کمتری برخوردار باشد (1980) Domsch et al پیشنهاد میکند که کونیدیهای 2 هفته ای را با عدسی روغنی میکروسکپ برای صاف یا ناصاف بودن دیواره اش باید بررسی کرد تصویر شماره 113 منظره ی کلنی و تصویر شماره 114 منظره ی میکروسکپی تریکو در ما را نشان میدهد
تصویر شماره 113

تصویر شماره 114
ص: 174
تصویر شماره 115
کونيديوفورها غیر قابل تشخیص ،کوتاه ساده استوانه ای شکل و نسبت به هایفای رویشی با زاویه کم و بیش 90 درجه سانتیگراد بوجود آمده و بر روی رأس خود یک فیالید انتهایی پدید می آورند. فیالوسپورها شفاف یا کمی پیگمانته هستند و بطور پیوسته نسبت بهم قرار گرفته، صاف یا کمی خاردار هستند. فیالیدهایی که بطور انفرادی در انتهای یک کونیدیوفور کوتاه و استوانه ای قرار گرفته و زنجیره ای از اسپورهای بدون دیواره عرضی نمایانگر این قارچ بنام T lagena میباشد (تصویر شماره 115
تصویر شماره 116
از بین گونه های متعدد ،ژئوتریکوم تنها ژئوتریکوم کاندیدوم در انسان بیماریزا می.باشد ابعاد کونیدیا 6-3×612 میکرون .است یک آلوده کننده شایع غلات و
،حبوبات، میوهها و محصولات لبنی کاغذ ،منسوجات خاک و آب است و اغلب اوقات به عنوان فلورنرمال انسان نیز وجود دارد. گونه ژئوتریکوم کاندیدوم میتواند یک عفونت ثانویه در ارتباط با توبرکولوزیس ایجاد نماید این بیماری نادر میتواند سبب ایجاد ضایعاتی در ،پوست ،برونش دهان ریه و روده گردد. عفونت حاصل از این ارگانیسم را جئوتریکوزیس مینامند که معمولا بوسیله ژئوتریکوم کاندیدوم ایجاد میشود همانطور که ذکر شد در این بیماری ضایعات ،ریوی دهانی جلدی و بندرت گوارشی دیده میشود بیماری ریوی شایع ترین فرم گزارش شده بیماری است تصویر شماره 116 کلنی ژئوتریکوم کاندیدوم را نشان میدهد
ص: 175
کلنی دارای رشد آهسته برجسته و چین خورده به رنگ کرم یا سفید با میسیلیومهای هوایی کم میباشد. اسپورها اغلب زیاد نیستند و تنها در دستجات یا تودههای هوایی دیده میشوند تهیه لام از این قسمتها با دقت زیاد باید صورت بگیرد این اسپورها بسیار شبیه میکروکونیدی درماتوفیتها میباشند اما اندازه آنها کوچک است به طول 3-1) میکرون) یک تصویر مشخصه انشعابات هایفای تولید کننده اسپور با زوایای حاد میباشد (تصویر شماره (117) گونه های این قارچ اختلافات زیادی با هم دارند. جزو ساپروبهای خاک میباشد ) بر روی سوبسترای کراتین رشد میکند) ممکن است عفونتهای ناخن به صورت خفیف ایجاد نماید.
قارچی با انتشار جغرافیایی وسیع است که اغلب از خاک گیاهان جدا میشود
ساختمان ظاهری کلنیها دارای رشد سریعی بوده شبیه چرم مخملی ،کرکدار به رنگ قهوه ای مایل به سیاه همراه با لبههای سیاه هستند
تصویر شماره 118

ص: 176
تصویر شماره 119

ساختمان میکروسکپی کونیدیهای قهوه ای تیره ،رنگ بیضوی یا شبه ،بیضوی کشیده و دارای دیواره صاف هستند این کونیدیها در داخل یک روزنه (poroconidia و بر روی یک کونیدیوفور کشیده و خمیده که محور اصلی است قرار دارند (تصویر شماره 118
این کونیدیها دارای تیغه میانی بوده که سلولهای اصلی کونیدی را در طول دوره بلوغ از هم جدا می کنند جوانه از یک سلول یا همه سلولها منشاء میگیرد و محل جوانه پیوندگاه متورم نیست انتهای کونیدیوفور پیچ خورده و آن را به عصای چوپانان تشبیه کرده اند درکسلرا از کورولاریا بخاطر ایجاد کونیدیهای بیضی شکل با دیواره صاف و از هلمنتوسپوریوم بخاطر کونیدیوفور خمیده و ناصاف قابل تشخیص میباشد (تصویر شماره 119)
بیماری زایی این قارچ از ورم چرکی مغزی یا آبسه مغزی جدا شده است. همچنین در موارد کشنده آنسفالیت در بیمارانی که به لنفوسار کوم مبتلا بودند دیده شده است گاهی میتواند عفونت قرنیه چشم را سبب شود و در حیوانات، ضایعات زخمی جلدی و زیرجلدی ایجاد می کند
ابعاد کونیدیا 28-17 × 120 - 40 میکرون است. روی علوفه غلات، حبوبات و غذاهای در حال فساد یافت میشود
ص: 177
این قارچ در خاک گرد و خاک ،خانه روی ،میوهها ،گردو دانه و بذرهای گیاهی و مواد غذایی دیگر و تمام مواد در حال فساد وجود دارد و از آلوده کنندههای شایع محیطهای کشت آزمایشگاهی میباشد رایزوپوس استولونیفر اغلب روی موز رسیده بویژه اگر شرایط هوای مرطوب وجود داشته باشد یافت میشود از گونه های بیماریزای آن میتوان oryza - microsporous - arizus را نام برد
تصویر شماره 120

تصویر شماره 121
ساختمان ظاهری کلنی رشد سریعی دارد رنگ سطح کلنی خاکستری و یا قهوه ای و پشت آن بیرنگ است مثل موکور واجد میسیلیومهای هوایی فراوان می.باشند کلنی این قارچ پنبه ای وسفید رنگ بوده ولی در طول ،رشد خاکستری و پشمی یا قهوه ای میشود ساختمان ظاهری آن شبیه موکور است ولی از نظر میکروسکوپی اختلاف دارند
ساختمان میکروسکپی میسیلیوم آن شفاف منشعب و فاقد تیغه های میانی است. میسیلیومها بر دو نوعند. یکی میسیلیوم تغذیه ای که در داخل محیط کشت فرو میرود و دیگری میسیلیومهای هوایی که از آن
ص: 178
تصویر شماره 122

تصویر شماره 123 رایزوپوس استولونیفر و 124
رشته های کمانی شکل بنام استولون خارج میشود و در انتهای خود به قسمت پهن تر و گره مانندی (node) منتهی میشود که از یک طرف این گره ها یک دسته ساختمان میسیلیوم قهوه ای رنگ بنام ریشک (rhizoid) با انشعابات متعدد را بوجود میآورند و در سمت دیگر آن اسپورانژیوفور به شکل دستجات 2-4 تایی قرار میگیرد ریشکها باعث چسبندگی استولون به محیط کشت یا جدار شیشه میشوند. دیواره اسپورانژیوفور صاف، بسیار طویل و عریض بوده به ابعاد 400 - 500×24 - 42 میکرون میباشد و بصورت منشعب نیست و در رأس خود به یک ناحیه کروی شکل بنام (columella) کلوملا ختم میشود که دور آن را اسپورانژیوم احاطه می.کند اسپورانژیوم کروی یا تقریباً کروی شکل است و واجد قسمت قاعده ای پهن تر با جداره ای نازک و غیر منطبق به اندازه 100 - 350 میکرون که در ابتدا سفید رنگ و بعد از رسیدن آبی سیاه رنگ میشود. اسپورانژیوسپور بیضی ،کشیده کم رنگ یا قهوه ای رنگ با جدار صاف یا کمی مخطط و یا خاردار است که 12-9 × 8-7 میکرون اندازه دارد تصاویر شماره 120 ، 121، 122، 123، 124).
در بعضی از انواع رایزوپوس زیگوسپور ایجاد میشود که در قسمت میسیلیوم تغذیه ای و یا استولونها دیده میشود و بصورت کروی شکل و عریان و اندازه آن 160 - 220 میکرون است.
ص: 179
بیماری زایی جزو عوامل موکور میکوز است و در بافت به شکل هیفهای ،فراخ، بدون دیواره عرضی و به قطر یک تا 25 میکرومتر دیده میشود قارچی آلرژیک و نواحی ابتلا در انسان عمدتاً از ریه چشم سینوسهای بینی و مغز میباشد
قارچ زیگومیست آلرژی زایی میباشد باعث موکور مایکوزیس در افرادی که سیستم ایمنی ضعیفی دارند می.شود اغلب مرتبط با آلرژی شغلی و محل عفونت ریه سینوسهای ،بینی ،مغز چشم و پوست میباشد. تصاویر شماره 125 و 126 مناظر میکروسکپی رایزوموکور را نشان میدهند
تصویر شماره 125

تصویر شماره 126
ص: 180
سپدونیوم و گونه های خاصی از جنس کر ایزوسپوریوم کونیدیهایی تولید میکنند که شبیه ماکروکونیدیای کنگره دار هیستوپلاسما کپسولاتم میباشند. اما باید توجه داشت که این دو قارچ ساپروب میکروکونیدیا تولید نمی کنند و نیز در دمای 37 درجه سانتیگراد فاقد فاز مخمری هستند تصاویر شماره 127 و 128)
تصویر شماره 127

تصویر شماره 128
ص: 181
عامل معمولی و شایع آسم اکسترنزیک ازدیاد حساسیت (تیپ (I میباشد. علائم حاد شامل ادم و برونکواسپاسم .است موارد مزمن ممکن است به سمت آمفیزم ریوی گسترش یابد تصویر شماره 129 اسپورهای سرپولا لاکریمنس و تصویر شماره 130 منظره ی کلنی این قارچ را نشان میدهد
تصویر شماره 129

تصویر شماره 130
این قارچ را از خاک و فاضلاب جدا کرده اند سود آلشریا بویدی ای در انسان عفونت زیرجلدی مایستوما و عفونتهای مغزی و ریوی ایجاد می.کند سود آلشریا بویدی ای نام مرحله کامل این قارچ است و امروزه نام مرحله غیر جنسی آن سدوسپوریوم آپیوسپرموم است که در گذشته پتریلیدیوم بویدی ای یا آلشریا بویدی ای
ص: 182
تصویر شماره 131

نامیده می شده است کلنی این قارچ در محیط سابورو دکستروز آگار و در دمای 25 درجه سانتیگراد دارای رشد سریع بوده، سطح آن کرکی و در ابتدا سفید و سپس متمایل به قهوه ای یا خاکستری و سرانجام خرمایی رنگ می.گردد. منظره پشت کلنی خاکستری تا سیاه رنگ .است این ارگانیسم همو تالیک بوده و در بعضی انواع آن در سطح محیط آسکو کارپ از نوع کلیستو تشیا ایجاد می.شود اندازه کلیستوتشیا 100 الی 300 میکرون بوده و به رنگ زرد مایل به قهوه ای است در داخل آن تعدادی آسک بیضی یا چماقی شکل دیده میشود و داخل هر کدام از این آسکها 8 آسکوسپور به ابعاد 79 × 5-4 میکرون و به رنگ قهوه ای وجود دارند. دمای مطلوب برای رشد این قارچ 30 تا 37 درجه سانتیگراد است
در آزمایش میکروسکپی میسیلیوم ها ،منشعب دارای تیغه ،میانی شفاف و به قطر یک الی سه میکرومتر همراه با کونیدیهای فراوان بیضی یا گلابی و یا لیمویی شکل دارای جدار ضخیم و به ابعاد 10-6 × 9-4 میکرون مشاهده می.شوند کونیدیاها ممکن است بدون کونیدیوفور و یا با کونیدیوفورهای کوتاه یا بلند به میسیلیومهای رویشی متصل گردند (تصویر شماره 131).
ص: 183
میسیلیوم بسیار منشعب و در ابتدا سنوسیتیک است ولی بعداً تیغه های میانی در آن پیدا میشود. اسپورانژیوفور بالا آمده و در اطراف آن انشعاباتی وجود دارد. انتهای اسپورانژیوفور به رشد خود بطور غیر مشخصی ادامه میدهد و به اسپورانژیوم ختم نمیشود. اسپورانژیومها بصورت انشعابات جانبی بطور انفرادی یا به صورت حلقه و پیچ دیده میشوند و نسبت به محور اصلی میسیلیوم به طرف پایین یا داخل انحناء پیدا میکنند
اسپورانژیوم محتوی تعداد زیادی اسپورهای کروی پوسته دار با کریستالهای اکسالات کلسیم است و نیز کولارت شکسته شده و نا منظمی دارد کلوملا بزرگ و قاعده اش هلالی شکل می باشد تصاویر شماره 132 و 133).
تصویر شماره 132

تصویر شماره 133
ص: 184
قارچهای گنده رویی هستند که بندرت ایجاد عفونتهای پوستی مینمایند کلنی آن دارای رشد سریعی بوده بطوریکه در مدت 4 روز تمام سطح محیط کشت را می پوشانند قوام کلنی کرکی و رنگ آن در ابتدا سفید و سپس با بلوغ مرواسپورانژیوها بتدریج خاکستری روشن میشود (تصویر شماره (135). پشت کلنی بیرنگ بوده و ساختمان میکروسکپی آن از میسیلیومهای شفاف منشعب و بدون تیغه میانی تشکیل یافته است. در میسیلیومهای قدیمی امکان مشاهده تیغههای عرضی و البته بصورت نامنظم وجود دارد. اسپورانژیوفور این قارچ در گونههای مختلف آن ممکن است کوتاه و یا کشیده بوده و از میسیلیومهای رویشی منشاء می گیرد. اسپورانژیوفور دارای انشعابات نامنظم بوده و در انتها به وزیکول گرد یا بیضی شکلی به نام اسپورانژیوم منتهی میشود که بر روی آن مرواسپورانژیاهای لوله ای یا انگشت مانند بلندی بصورت شعاعی قرار میگیرند در داخل اسپورانژیاها یک ردیف اسپورانژیوسپور ،گرد بیضی یا استوانه ای شکل مشاهده میشود به دلیل شباهت کلنی و منظره میکروسکپی سین سفالاستروم با آسپر جیلوس ،نیجر این دو به راحتی با یکدیگر اشتباه میشوند در این گونه موارد توجه به فقدان تیغه میانی در میسیلیومهای سین سفالاستروم و نیز مشاهده مرواسپورانژیاها که در درون خود واجد اسپور هستند به تشخیص کمک میکند تصویر شماره 134، 136 و 137).
تصویر شماره 134

تصویر شماره 135 و 1367
تصویر شماره 137
ص: 185
تصویر شماره 138
قارچی است با رشدی سریع قطر کلنی در 5 روز به 4/5 سانتی متر می رسد با سطح صاف پنبه ای یا دانهای ابتدا سفید رنگ که بزودی به رنگهای ارغوانی ،بنفش قرمز قهوه ای و خاکستری در می آید پشت کلنی به رنگ خود کلنی و معمولا قرمز صورتی است در بسیاری از گونههای آن پیگمانهای رنگ (دانه قرمز یا صورتی در محیط کشت بوجود آمده و در آن نفوذ میکند (تصویر شماره (138)
کونیدیوفور به شکل شاخه های جانبی و نزدیک بهم دیده میشود کوتاه و صاف بوده که یا به صورت ساده و تقسیم نشده باقی مانده و یا در رأس خود به شاخه های متعدد نزدیک بهم تقسیم می.شود این قارچ دارای دو نوع کونیدی است که هر دو نوع از طریق فیالید ایجاد میگردند که عبارتند از میکروکونیدی که تک سلولی و یا گاهی با یک تا دو تیغه میانی چند سلولی گرد بیضی کشیده یا نخودی شکل دیده میشود که بطور تک تک در رأس کونیدیوفور ساده ایجاد شده و پس از خروج بلافاصله توسط ماده چسبنده ای دور هم جمع شده و یک دسته اسپور رأسی توپی شکل یا کروی شکل ایجاد می.کند نوع دیگر کونیدی این قارچ عبارتست از ماکروکونیدی باریک و کشیده یا هلالی شکل و یا رأسی شکل با جدار نازک و انتهای نقطه ای و تیز و واجد 6-3 تیغه میانی است که به شکل خوشه موز در رأس کونیدیوفورهای منشعب بوجود می آید. ماکروکونیدیها بی رنگ هستند و یا رنگ روشنی دارند و هیچگاه سیاهرنگ نیستند تصاویر شماره 139 و 140). این قارچ انگل بسیاری از گیاهان و نیز بصورت ساپروب روی مواد گیاهی در حال فساد رشد میکند خاکزی و اسپورهای آن در هوا خیلی فراوان هستند برخی از گونه ها با ترشح فرآوردههای توکسیک سبب مسمومیت غذایی می.گردند این قارچ اغلب در مزارع پنبه کاری و صیفی کاری به ،کدو ،خیار گوجه فرنگی بادمجان و پنبه صدمه می زند بافتهای هدف برای توکسینهای تریکوتسن شامل سیستمهای گردش خون ،گوارش، پوست و اعصاب می.باشند در روی غلات و حبوبات تحت شرایط نم و رطوبت غیر معمولی تولید Vomitoxin می نمایند. علائم . بیماری هم بعد از مصرف غلات و حبوبات آلوده به توکسین و هم بعد از استنشاق اسپورها بوجود میآیند این جنس سندرم هموراژیک در انسان ایجاد مینماید این سندرم ،با ،تهوع، استفراغ، اسهال، درماتیت و خونریزی
ص: 186
وسیع داخلی مشخص میشود. غالباً در عفونتهای چشم، پوست و ناخن دیده میشود.
ابعاد ماکروکونيديا 6/8-4/4 52-27 میکرون و ابعاد میکروکونیدیا 4-2×16-8 میکرون است. در گیاهان و خاک یافت می.شود توکسینهای تریکوتسن تولید میکند که در انسان و حیوانات بیماریزا است.
تصویر شماره 139

تصویر شماره 140
ص: 187
میکروکونیدهای فوراز یوم شبیه کونیدیهای آکرومونیوم است اما فوزاریوم معمولا بسیار سریعتر رشد می و کلنیهای آن حالت کرکی مشخص دارد.
آکرومونیوم از خاک هوا و فاضلاب جدا شده و بعنوان قارچ آلرژی زا شناخته شده است. یک نوع توکسین تریکوتسن تولید میکند که از علائم مسمومیت با این سم (قارچ) ،تهوع، استفراغ، اسهال می باشد. آکرومونیوم از ،ناخن ،پوست صفرا ،خون شیره معده و مایع نخاع جدا شده است و عامل ایجاد کننده مایستوما در بافت ایجاد گرانولهای سفید و نرم میکند عفونتهای قرنیه (کراتیت) و ناخنها انیکومایکوز) می باشد. گونه هایی که سبب مایستوما انیکومایکوز و هیالوهایفومایکوز میشوند شامل : recifi, A. kiliense,A. Falciforme . و
A strictum می باشند.
علائم کلینیکی هیالوهایفومیکوز ناشی از آکرومونیوم شامل آرتریت استئومیلیت پریتونیت اندوکاردیت ،پنومونی التهاب مغز و عفونت زیر جلدی است.
تصویر شماره 141
یک آلرژن و آلوده کننده فضاهای داخل خانه ها می،باشد کلنی آن شبیه مراحل اولیه رشد کتومیوم است تصویر شماره 141 گونه های آن از خاک و گیاهان مرتبط با خاک - بویژه سیب زمینی جدا شدهاند روی دیوارهای - نقاشی شده ایجاد نقاط صورتی و ارغوانی می نماید. برخی از آنتی ژنهای آن با آنتی ژنهای گونههای آلترناریا واکنش متقاطع نشان میدهد روی ،کره سیمان و لاستیک نیز رشد می.کند ممکن است باعث بیماری سیستمیک یا زیر جلدی فئوهایفومیکوز شود. در تصویر شماره 142 و 143 دستگاه اسپورزایی (fruiting body مشاهده میشود
ص: 188
تصویر شماره 142

تصویر شماره 143
ص: 189
از قارچهای زیگومیستی میباشند در میزبانان مستعد از نظر سیستم ایمنی میتواند عفونتهای منتشره و ریوی ایجاد نماید میسیلیومهای سفید ،کرکی به قطر 6-3 میکرون و سنوسیتیک دارد و بتدریج تیغه میانی در آنها ظاهر میشود گاهی اوقات ریزوئیدهای اولیه ای در آن داخل سوبسترا پیدا می.شود .اسپورانژیوفورها دارای انشعابات مستقیم هستند و در انتهایشان به یک سر کروی شکل متورم که توسط زائده های خار مانند پوشیده شده ختم میشوند این زوائد محل یا نقطه تماس و اتصال اسپورانژیولا می.باشند. دیواره اسپورانژیولها اغلب بوسیله کریستالها پوشیده شده است. اغلب کلامیدو کونیدیایی صاف دیده میشود. کونیدیای غیر جنسی شفاف بوده و بطور انفرادی بر روی وزیکولهای صاف که بر روی کنیدیوفورهای ساده یا منشعب قرار گرفته است پدید می آیند در بعضی از گونه ها مانند C. echinulate و elegans . کونیدی خاردار میباشد ولی در سایر گونه ها کونیدیا صاف .است در خاک مناطق گرم وجود دارد تصویر شماره 144 کلنی و تصاویر شماره 145 و 146 تصاویر میکروسکپی کانینگهاملا را نشان میدهند.
تصویر شماره 144

تصویر شماره 145
تصویر شماره 146
ص: 190
قارچی است خاکزی با رشد کند و تدریجی، سطح کلنی صاف مخملی یا پرزی که مدتهای طولانی سفید یا نخودی رنگ باقی میماند و سپس در اثر پیدایش کونیدیا نقاط زرد رنگ در آن بوجود می آید . رنگ پشت کلنی قهوه ای تیره رنگ است. کونیدیا به صورت کلامیدوسپورهای داخل رشته ای است که ممکن است منفرد و یا به صورت زنجیره و یا گاهی در روی شاخه های جانبی تولید شود کونیدیا کروی یا بیضوی است باجدار کلفت ناصاف و خاردار و قسمت رأسی میسیلیوم در انتهای آزاد آن به صورت رشته های باریک و شفاف باقی می ماند استطاله رأسی در مواردی از عفونتهای مغزی جدا شده است. همچنین گزارشهایی از جداسازی آن از زخم روی قوزک پا یا از ندولهای زیر جلدی وجود دارد.
قارچ آسکومیست بزرگی که پری تیشا تولید می.کند پری تشیا در واقع مجموعه آسک و آسکوسپورها می باشند و قمقمه ای یا گلابی شکل هستند. روی سوبستراهای متنوعی که حاوی سلولز هستند مثل کاغذ و کود گیاهی رشد می.کند. در روی محیط کشت قارچ حالت شبیه آکرومونیوم تولید میکند و آلرژیک است بسرعت توسعه می یابد در مرکز متراکم تر است و در اطراف پرمانند و خرمایی یا خاکستری رنگ میشود (تصویر شماره 147 پشت کلنی عموماً نارنجی تا قرمز میباشند برخی از گونه های آن نظیر فانی کولوم و کوچلیودیس را بعنوان عوامل ایجاد کننده فئوهایفومیکوز نام برده اند پری تشیای بزرگ و بیضوی قهوه ای تیره بویژه در محیط PDA تعداد آن فراوان است و تعداد زیادی رشته ها یا فیلامنتهای بلند و زیتونی تا قهوه ای از آن بیرون آمده و گاهی اوقات منشعب میباشد. کونیدیهای این قارچ در تصویر شماره 148 نشان داده شده است.
ص: 191
تصویر شماره 147
تصویر شماره 148
ص: 192
اهمیت شناخت گونه های کرایزوسپوریوم بطور عمده مربوط به شباهت کلنی آنها به قارچهای پاتوژنی مانند درماتوفیتها هیستوپلاسما و بلاستومایسس و یا به دلیل خاصیت کراتینوفیلی (Keratinophilie) آنها می باشد به علت همین کراتین دوست بودن گونه های کرایزوسپوریوم قادرند ایجاد ضایعات ناخن اونیکومایکوزیس را بنمایند. علاوه بر خاصیت فوق الذکر کر ایزوسپوریوم، ترموفیل (Thermophile) و سلولولیتیک (Cellulolytic نیز می باشد.
این جنس یک گروه بزرگ از خویشاوندان در ماتوفیتها میباشد و همانطور که گفته شد شکل کلنی آن با شکل کلنی بعضی از درماتوفیتها رویندگان پوست قارچهای بیماریزای پوستی ) مشابهت دارد. اسپورهای آن مشابه میکروکونیدی اما بزرگتر (12-5) میکرون می باشد اغلب آنها کلنیهای سفید کرم یا نارنجی کم رنگ ایجاد میکنند کلنی آنها مسطح و بافت آن جیر مانند میباشد گونههای شایع آن عبارتند از deratinophilum که با اسپورهای با دیواه نازک بزرگ چماقی (گرزی و صاف مشخص میشود و C.tropicum که اسپورهای ،کوچکتر بیضوی و کمی خشن دارد
رشد اکثر گونه های آن متوسط است کلنیهای کرایزوسپوریوم به شکل پودری دانه ای کرکی و یا پشمی بوده و به رنگهای متنوعی چون سفید ،زرد خرمایی صورتی و خاکستری کم رنگ مشاهده می گردند فاقد كونيديوفور مشخص بوده کونیدیاهای آنها تک سلولی ،شفاف بی رنگ و یا با رنگی روشن می باشند که توسط زائده یا دنباله ای در قاعده به کونیدیوفور متصل میگردند (Aleuriospore) محل اتصال پهن بوده و به صورت یک اسکار (Scar) در قاعده کونید یا مشاهده می گردد. با تجزیه و یا شکسته شدن سلولهای کونیدیازا آلئوریوسپورهای کرایزوسپوریوم آزاد میشوند.
این گروه جزء قارچهای خاکزی است. برخی از آنها قادر به هضم کراتین میباشند و برخی بر روی سلولز بطور اختصاصی عمل می.کنند عفونت در انسان بطور محدود یا نادر مربوط به ناخن ها (انیکومایکوز) باشد.
می کلنیهای این قارچ از حالت ،مومی ،مخملی پودری سفید تا خرمایی رنگ زرد ،بنفش ارغوانی قهوه ای و ... کاملا متغیر است رشد متوسط دارد و گاه رنگدانه منتشر در محیط ایجاد میکند بسیاری از سوشها محیط Dermatophyte test Medium مانند درماتوفیتها تغییر رنگ ایجاد می.کنند
ساختمان میکروسکپی کونید یوفور از هیفهای رویشی غیر قابل تشخیص هستند کونیدیها آلوریوکونیدی گرد یا بیضی شکل اند و بطور منفرد یا به فرم زنجیره های کوتاه به قطر 10-2 میکرون دیده می.شوند کونیدیهای بزرگتر گاهی واجد دیواره عرضی میباشند تصویر شماره (149). در محل آزاد شدن
ص: 193
،کونیدی گاهی نشانه پهن باقی میماند آرتروکونیدی و فیالوکونیدی در برخی از گونه ها وجود دارد برخی از گونه ها ، ترموفیلیک کراتینوفیلیک یا سلولیتیک هستند. مرحله تلئومرف شامل کتنومایسس آرترو درما و غیره است.
تصویر شماره 149

تصویر شماره 150
قارچی است که بطور بسیار شایع از هوا جدا می.شود در زمستان تعداد اسپورهای آنها کاهش می یابد و اغلب در تابستان بسیار زیادتر هستند. در فضای داخل خانه ها و ساختمانها به تعداد کمتری نسبت به فضاهای بیرون یافت میشوند یک آلرژن شایع است. گونههای کلادوسپوریوم جدا شده از فضاهای داخلی ممکن است از انواعی که از فضای خارجی جدا میشوند متفاوت باشند این قارچ گنده رو بعلت قابلیت تحمل به سرما در دمای یخچال و تا دمای 8 درجه زیر صفر نیز قادر به رشد و ادامه حیات میباشند. اغلب از آلوده کنندههای مواد گوشتی حتی گوشت یخ زده کنسرو ماهی و کالباس هستند عفونتهای چشمی از قبیل کونژکتیویت و نیز بیماری قارچی زیر جلدی موسوم به کروموبلاستومایکوزیس در اثر گونه هایی مثل کلادوسپوریوم ،کاریونی کلادوسپوریوم ترایکوئیدس و کلادوسپوریوم بانتیانوم ایجاد میشوند کلنی کلادوسپوریوم دارای
ص: 194
رشد آهسته تا متوسط است و منظره پودری یا مخملی دارد و ممکن است شیارهای ضعاعی شکل داشته یا نداشته باشد. رنگ کلنی ها زیتونی تیره قهوه ای تا قهوه ای متمایل به سیاه است تصویر شماره (152)
دسته وسیعی از گیاهان منبع غذایی برای این قارچ می.باشند. روی گیاهان ،مرده گیاهان ،چوبی غذا کاه و حصیر ،خاک نقاشیها و منسوجات یافت میشوند بیش از 10 آنتی ژن تولید میکند عامل شایع آسم اکستر نزیک میباشد از علائم ،حاد ادم و برونکو اسپاسم و از جمله علائم مزمن ،آن آمفیزم ریوی می باشد.
رشد کلادوسپوریوم ها آهسته تا متوسط است. کلنی آنها پودری و یا مخملی بوده و ممکن است با یا بدون شیارهای شعاعی شکل باشند رنگ کلنیها زیتونی تیره قهوه ای تا تقریبا سیاه رنگ میباشند. میسیلیومهای رویشی منشعب بوده و دارای تیغه های میانی هستند تیغه های میانی کاملا سیاه رنگ میباشند (تصویر شماره 151 در تصویر شماره 150 و 154 اسپورهای تک و یا دو سلولی که دارای تنوع در اندازهی خود میباشند مشاهده میشود
تصویر شماره 151

تصویر شماره 152
ص: 195
ابعاد کونیدی 10-474-12 میکرون است روی برگهای گوجه فرنگی یافت میشود
ابعاد کونیدی 38 523 میکرون است روی گیاهان مرده گیاهان ،چوبی غذا کاه و حصیر ،غذا کاه و ،حصیر ،خاک نقاشی ها و منسوجات رشد می کند
تصویر شماره 153

ابعاد کونیدی 13 - 5×29-9 میکرون است روی گیاهان ،مرده گیاهان ،چوبی غذا کاه و حصیر خاک، نقاشیها و منسوجات رشد میکند
روی کاغذهای مختلف دیده میشود و در دمای بالا و پائین و نیز در pH مختلف حتی در حضور غلظتهای بالایی از مواد قارچ کش رشد میکند
تصویر شماره 154
ص: 196
ابعاد کونیدی 4/5-3 میکرون است به عنوان عامل مهاجم ثانوی در ،گیاهان ،غذا ،خاک نقاشیها و منسوجات در نظر گرفته میشود
اسپورهای آن آلرژیک است باعث عفونتهای قرنیه چشم مایستوما و عفونتهای عمقی در افرادی که سیستم ایمنی آسیب دیده دارند میشود از دسته فئوهایفومیستها بوده دارای میسیلیومهای قهوه ای رنگ و اسپورهای چند سلولی قهوه ای تا قهوه ای متمایل به سیاه میباشند از ویژگیهای اسپور این قارچ این است که یکی از سلولهای مرکزی اسپور بزرگتر از سایر سلولهای آن است و همین مسئله موجب خمیدگی و انحراف در محور طولی اسپور میگردد تصویر شماره 155 در تشخیص افتراقی با قارچهای دیگری نظیر بایپولاریس درکسلر ا و هلمنتوسپوریوم مطرح می.شود منظره کلنی کوروولاریا در تصاویر شماره 156 و 157 مشاهده میشود
تصویر شماره 155

ص: 197
تصویر شماره 156
تصویر شماره 157
تصویر شماره 158
قارچی است با رشد آهسته ) در 14 روز قطر کلنی به 22 میلی متر میرسد) تولید کلنی گچی سفید و چین و چروک دار (wrinkled) میکند که بعدا با
میسیلیوم هوایی مخملی شکل پوشانده می.شود انشعابات ،طویل بلند و باریک (slender) ظریف تولید کونیدیهای کوچک نخودی شکل یا گلابی شکل بصورت دسته ای یا خوشه ای از انتهای متورم شده مینماید که برآمدگی در محل نقطه اتصال جایی که کونیدی جدا میشود نشان میدهد تصویر شماره 158 و 159 بعضی کونیدیها جوانه میزنند کونیدیها نیز به صورت خوشه ای در اطرافهایفا تولید میشوند که یا به صورت Sessile یا روی ساختمانهای رگهای شکل و یا روی انشعابات جانبی کوتاه است
این جنس فرم ناقص یا غیر جنسی گونه های
ص: 198
تصویر شماره 159

Ceratostomella میباشد و یک جنس پلی مورفیک است بطوریکه چندین نوع اسپور در کشتهای آن دیده شده است که به اسامی زیر خوانده میشوند
زنجیره های منشعب اسپور مانند کلا دوسپوریوم اسپورهای انتهایی به صورت خوشه ای مانند سفالوسپوریوم و اسپورهای جانبی و خوشههای انتهایی مانند اسپورتریکوم
قارچی است که از نظر شکل ساختمانی شبیه گونه های پنیسیلیوم می.باشد به عنوان یک قارچ آلرژن گزارش شده است قارچی است با سرعت رشد ،زیاد ،بطوریکه در مدت یک هفته تمام پلیت را اشغال می کند. رشد آن از آسپر جیلوسها و پنیسیلیوم ها سریعتر است کلنی آن دارای سطح صاف و کرکی بوده، در ابتدا سفید رنگ و سپس که به تدریج کونیدیاها ظاهر میشوند سبز رنگ یا صورتی رنگ میشود ابتدا یک رنگ سبز تیره در مرکز آن بوجود می آید که بتدریج تمام سطح کلنی را فرا می گیرد پشت کلنی بی رنگ است. ساختمان اسپورزایی آن به شکل پنی سیلیوس است که تمام طبقات زایای آن در یک سطح نمی باشد و کونیدی ها به شکل توده ای به هم فشرده در رأس آن قرار دارد. کونیدیوفورها به شکل شاخه های جانبی مستقیم با سطح صاف نقطه ای یا خاردار است چندین تیغه میانی داشته و اندازه آن 3×100-50 میکرون است و در رأس خود به چندین شاخه تقسیم میشود شاخه ها به تعداد 4-3 عدد در این کونیدیوفور قرار میگیرند متولا کوتاه و در محور اصلی شاخه قرار گرفته و به شکل دستجات 4-3 تایی در رأس هر شاخه ظاهر میشوند .استریگما قمقمه ای شکل میباشند و کونیدی ها
ص: 199
تخم مرغی شکل یا بیضی کشیده اند که تک تک از دهانه استریگما خارج شده و به صورت توده ای بهم فشرده در رأس کونیدیوفور مجتمع میشوند و توسط یک ماده چسبنده و لزج به یکدیگر چسبیده اند. کونیدی ها شفاف هستند اما به صورت توده و تجمعی دیده میشوند و توده آنها رنگی به نظر می رسند بیضوی شکل بوده و در کنار یکدیگر شبیه توپ دیده میشوند.
قارچی است با رشد نسبتاً کند 35 میلیمتر در 12 روز و دارای کلنی فشرده خاکستری روشن با مرکزی به رنگ خاکستری تیره و تعدادی خطوط شعاعی چین خوردگی میباشند کونیدی به مقدار زیادی تولید می.شود کونیدیها ممکن است Sessile یا گلابی شکل باشند کونید یوفور دیده نمیشود و یا کونیدیها در انشعابات بسیار کوتاه هایفا بوجود آمده باشند و گلابی شکل تا کروی شکل هستند کونیدیها به رنگ زرد قهوه ای دیده میشوند و دیواره خارجی آنها ضخیم تر است اسپورهای گلابی شکل شباهت سطحی با اسپورهای مربوط به Monosporium دارند اما از آن ،کوچکترند sessile هستند یا روی کونیدیوفورهای خیلی کوتاه ایجاد شده اند و درهایفا هایی که در سطح محیط کشت است نیز دیده میشوند (تصویر شماره 160).
تصویر شماره 160

ص: 200
یک قارچ آلرژن .است در میوه های درختی ایجاد آسیب لکه نرم soft rot) می نماید. گاهی اوقات باعث گرفتاری قرنیه چشم می.گردد تصاویر شماره 161 و 162 مناظر میکروسکپی این قارچ را نشان میدهند
تصویر شماره 161

تصویر شماره 162
کلنی رشد سریعی دارد و در مدت چند روز تمام سطح آگار ( 4-3 روز را می پوشاند. در ابتدا سفید رنگ است اما به سرعت تبدیل به رنگ لیمویی میگردد و سطح آگار را به صورت یک لایه نازک می پوشاند نواحی کرکی یا پرمانند که مربوط به تولید انبوه اسپور است در آن پدید می آید.
کونیدیوفور از میسیلیوم رویشی جدا شده و بلافاصله زنجیرهای منشعبی را پدید می آورد
ص: 201
(ovate conidia که در آنها کونیدیای بیضوی و همواره با جوانه دیده میشوند این نحوه تولید اسپور و جوانه زدن آنها باعث پدید آمدن توده های بزرگ از اسپورهای بیضوی شکل شده که با جریان هوای بسیار ملایم پراکنده می.شوند در نواحی قدیمیتر مربوط به میسیلیوم رویشی سلولها شکسته و تشکیل آرتروسپورهایی با دیواره ضخیم می.نمایند
اغلب در خاک مواد گیاهی مرده فضولات ،اسب میوه ها و عصاره میوه ها و همچنین در چرم گوشت محصولات لبنی و موی حیوانات یافت میشود گونه های مختلف موکور قادر هستند با رشد و تکثیر بر روی مواد غذایی مانند نان ،لبنیات ،مربا، ترشیجات ،کنسروها انواع کمپوت شیرینی ها صیفیجات و میوه ها، باعث آلودگی و فساد آنها شوند.
تصویر شماره 163 موکور پوسیلوس

تصویر شماره 164
ص: 202
اسپورهای این قارچها نه تنها به آسانی از هوا و خاک جدا میشوند بلکه گونههای آن قادرند با رشد و تکثیر بر روی مواد غذایی همچون ،نان لبنیات ،مربا، ترشیجات ،کنسروها ،کمپوتها شیرینی ها، صیفی جات و میوه ها باعث آلودگی و فساد آنها گردند. بعضی از گونه های این جنس نظیر موکور راموسیسیموس
(M. ( ramosissimosus ، سیرسینه لوییدس (cricinelloides ) ایندیکوس Midicus راسموسوس (M.racemosus) قادرند در افراد مستعدی چون مبتلایان به کتواسیدوز دیابتی، ایجاد بیماریهای متعدد ریوی ،جلدی مغزی و به طور کلی احشایی را بنمایند. همچنین اسپورهای این دسته از قارچها آلرژن بوده و درصورت وجود زمینه ،مستعد توانایی ایجاد حساسیت در انسان را دارا میباشند . موکور با ایجاد سقط جنین در گاوها نیز میتوانند باعث زیانهای اقتصادی گردند. رشد این عوامل سریع بوده و ایجاد کلنی خاکستری روشن تا تیره و یا قهوه ای رنگ را می کنند (تصویر شماره 163 به علت داشتن انبوه میسیلیومهای ،رویشی هوایی و زایشی کلنی آنها به سرعت به حالت پشمی و یا پنبه ای در میآید پشت کلنی بیرنگ .است. از نظر ریزبینی از میسیلیوم هایی فراخ و بدون تیغه میانی تشکیل یافته ولی در کشت های قدیمی ممکن است میسیلیومها دارای تیغه های میانی نامنظم و کامل نشده ای باشند دستگاه زایشی از میسیلیومهای ساده و اغلب منشعبی تشکیل یافته که چون در انتها به جسمی کروی به نام اسپورانژیوم ختم میشوند به آنها اسپورانژیوفور میگویند در داخل اسپورانژیوم و در محل اتصال به اسپورانژیوفور جسم مخروطی شکلی به نام کلوملا (columella دیده میشود (تصویر شماره 164 باگذشت زمان و ،بلوغ اسپورانژیوم تیره رنگ گشته و تعداد زیادی اسپور در فاصله بین کلوملا و دیواره آن ایجاد میگردند اسپورها گرد یا بیضی با جدار نازک و صاف و معمولا بدون رنگ بوده و از آنجایی که در داخل اسپورانژیوم جدار آن نازک گشته و با پاره شدن آن اسپورها آزاد میشوند در واقع در این نوع از تکثیر غیر جنسی اسپورها تک تک ساخته نشده بلکه با تکثیری که بی شباهت به تکثیر شیزوگونی انگل مالاریا ،نیست به یکباره صدها اسپور در داخل اسپورانژیوم ساخته شده و آزاد می.گردند علاوه بر این تکثیر غیر جنسی گونه های موکور قادرند به طریق جنسی نیز تکثیر یافته و ایجاد سلول باروری به نام زیگوسپور ( zygospore را بنماید همچنین با نامساعد شدن شرایط ،زندگی در وسط و انتهای میسیلیومها کلامیدوکونیدیاها ایجاد میشوند که برخلاف میسیلیوم و اسپورانژیوسپورها، دارای دیواره ضخیم و کلفتی هستند اگر چه ممکن است کلنی موکور از نظر ظاهری با کلنی رایزوپوس اشتباه ،شود ولی با عدم مشاهده گره (nude)، ریشک (Rhizoid) و استولون (Stolon ) در مطالعه ریزبینی به راحتی جنسهای موکور و رایزوپوس را میتوان از یکدیگر تشخیص داد.
ص: 203
کلنی آن دارای رشد سریع و به رنگ خاکستری دودی و به ارتفاع تا 2 سانتیمتر میرسد. پشت کلنی زرد یا کرم رنگ و دارای بوی معطر میباشد. اسپورانژیوسپورها دو نوع هستند یک نوع طویل که اسپورانژیوم بزرگ قهوه ای ،رنگ پر از اسپور ایجاد مینماید و شاخه شاخه میشود و در نوع دوم که اسپورانژیوفورها کوتاه بوده و اسپورانژیوم کوچک به اندازه تقریبی 25 میکرون از آن خارج میشود. اسپورانژیومهای بزرگ ابتدا سفید رنگ و سپس قهوه ای متمایل به سبز کروی و به اندازه 40 تا 84 و گاهی تا 108 میکرون بوده و اغلب آنها دارای سرهای حبابی شکل مشخصی می.باشند اسپورانژیومهای کوچک دارای دیواره بی رنگ و صاف هستند کلوملا بیرنگ و به اشکال مختلف و به اندازه 35 میکرون میباشند اسپورها کوتاه، بیضی و به اندازه 4 تا 7 میکرون میباشند و ممکن است به شکل مخمرهای جوانه زننده دیده شوند. ممکن است تعداد اندکی کلامیدو کونید یا دارای دیواره ضخیم دیده شوند که معمولا در اسپورانژیوفورها مشاهده می گردند. قطر کلامیدو کونید یا معمولاً کمتر از 21 میکرون است. موکورسیرسینه لوئیدس زیگوسپور ندارد و در دمای 37 درجه سانتیگراد رشد میکند
دارای کلنی پرزی و به رنگ دارچین یا خاکستری زیتونی رنگ است. این قارچ دارای اسپورانژیومهایی به قطر 15 تا 70 میکرون میباشد اسپورانژیومها کوچک و فاقد کلوملا بوده و اسپورها بیضی یا کروی شکل میباشند (تصویر شماره 165 و 166)
تصویر شماره 165

ص: 204
تصویر شماره 166

تصویر شماره 167
بعنوان یک قارچ آلرژن گزارش شده است. دارای رشد سریع بوده و کلنی آن در مدت چند روز تمام سطح محیط کشت را میپوشاند (تصویر شماره 167 کلنی در ابتدا سفید و سپس بتدریج خاکستری یا سیاه رنگ است و منظره پشت کلنی نیز سیاه می.شود در منظره ،میکروسکپی میسیلیومهای منشعب با تیغه میانی در ابتدا شفاف دیده میشوند ولی بعد از مدتی سیاه رنگ می گردند کونیدیوفور ،شفاف کوتاه و دندانه دار بوده و سلول کونیدی را دارای ساقهای کوتاه با پایهای متورم میباشند. کونیدی ها تک سلولی، سیاه کروی تا بیضی با سطحی صاف هستند (تصویر شماره 168)
ص: 205
تصویر شماره 168

تصویر شماره 169
کلنی های نازک و ،کرکی با رشد سریع دارد کلنی ابتدا سفید رنگ و سپس بتدریج به رنگ ،زرد، صورتی سبز و یا عنابی روشن در می آید کونیدیوفورها مستقیم ساده یا منشعب و عمود بر میسیلیومهای رویشی هستند. سلولهای کونیدیازا بصورت فیالید و با انتهایی پهن دیده میشوند این سلولها نیز بصورت عمود بر کونیدیوفورها قرار می.گیرند کونیدیاها ،شفاف، تخم مرغی شکل و یا استوانه ای بوده و به وسیله ماده چسبنده ای به یکدیگر متصل شده اند و ایجاد توده های توپ مانندی در رأس فیالید میکنند در صورت عدم ،دقت منظره میکروسکپی آن قابل اشتباه با آکرومونیوم و اسپوروتریکس میباشد (تصاویر شماره 169 و 170)
ص: 206
تصویر شماره 170

قارچ خاکزی است و به عنوان قارچ آلرژن گزارش گردیده است. در مواردی از خلط و پوست جدا شده است. از دسته دیماتیاسئوسها است بنابر این دارای میسیلیومهای قهوه ای و کونیدیهای چندین سلولی قهوه ای تا قهوه ای تیره میباشد در تشخیص افتراقی با در کسلرا مطرح است (تصویر شماره 171)
تصویر شماره 171
ص: 207
کلنی این قارچ رشد آهسته ای دارد (11) میلیمتر در 8 روز ،برجسته برآمده شکننده و ترد است و رنگ قهوه ای تیره ای دارد. در انتهای انشعابات هایفای کوتاه زنجیره های کونیدی پدید می آیند. تیغه های عرضی نزدیک بهم محتویات داخل لوله را به سگمانهای تیره رنگ با دیواره ضخیم و کروی شکل تقسیم می.کند این ها بوسیله قطعات جدیدی که تشکیل میشوند به جلو رانده می.شوند اسپورها نهایتاً به صورت کونیدیهای کروی شکل با دیواره ضخیم و خم شده آزاد میگردند بدین ترتیب چند زنجیر جانبی تشکیل میشود تصاویر شماره 172 و 173)
تصویر شماره 172

تصویر شماره 173
ص: 208
روی مواد و محصولات با محتوای سلولز زیاد رشد میکند این قارچ در خاک و باقیمانده های گیاهان یافت میشود کلنی آن رشد سریعی داشته و دارای قوام ،کرکی نازک و به رنگ خاکستری تا قهوه ای تیره است. کونید یوفور آن به سختی قابل تشخیص است و بصورت ساده یا بندرت به شکل شاخه های کوتاهی دیده میشود. کونید یا تک سلولی ،بوده ،تیره کروی و یا نیمه کروی میباشند. کونیدیاها بصورت منفرد بر روی دندانه هایی (pedicule) قرار دارند که از انتهای میسیلیومها منشاء گرفته اند تصاویر شماره 174 و 175) گونه های مختلف هومیکولا تحت شرایط محیطی خاصی وابسته به دما و میزان تابش نور ممکن است کونیدیاهای ثانویه ای مانند فیالوکونیدیا و سیمپودولوکونیدیا (sympoduloconidia) ایجاد نمایند این نوع کونیدیاها معمولاً کوچکتر بوده و بصورت گروهی از فیالایدها سرچشمه میگیرند
تصویر شماره 174

تصویر شماره 175
ص: 209
ادیب فر ،پرویز میکروب شناسی ،پزشکی نشر ،ایران ،1375 صفحات 275 و 276
ملک زاده ،فریدون میکروب شناسی انتشارات دانشگاه تهران ،1374 صفحات 397 و 398
ترجمه دیار اعتمادی ،هرمز باکتری شناسی پزشکی انتشارات جهاد دانشگاهی، 1372، صفحه 278
تاج بخش، حسن : باکتری شناسی عمومی، انتشارات دانشگاه تهران چاپ دوم، صفحه 252 و 253
زینی فریده امامی مسعود مهبد امیر سید علی قارچ شناسی پزشکی ،جامع انتشارات دانشگاه تهران 1383 چاپ دوم.
Microbial Enzymes and Biotechnology ,2nd Edition, William M.Fogarby and therine T. Kelly, 1991, 45-47.
Bergey's manual of systematic Bacterialogy, volum 2, peter.H. A.sneath et al, 1986, 1108-1112.
Microbial enzymes and biotechnology 2 ND Edition, Edied by : willam M. Fagarty and Cathrine T. Kelly
www.doctorfungus.org
Medical Mycology. Rippon
Anaissie, EJ. Clinical Mycology. CHURCHILL LIVINGSTONE.2003
Evans, EGV. Medical Mycology a practical approach. IRL press at Oxford University Press. 1989
www.mycologyonline.org
BIODETERIORATION OF CULTURAL PROPERTY 3 .Proceedings of the 3rd International Con-
ference on Biodeterioration of cultural property July 4-7 1995. P:630-42, 202
Caring for Books and Documents : A.D.Baynes-cope, Research Laboratory, British Museum, British
Museum Publications
Disinfection of paper using Gamma Rays, Electron Beam,and Microwaves. Flieder,F. et al.: Biodeterio-
ration of cultural property 3 Bangkok,Thailand 1995,P:283-97
Fogarby W.M., Kelly T.T.: Microbial enzymes and biotechnology, 2nd edition, 45-7, 1991
Kowalik R.: Microbiodeterioration of library materials part 2, Microbiodecomposition of basic organic
library materials chapter 4, Restaurator 4:135-219,1980
Microbiodeterioration of Library materials part 2 Microbiodecomposition of basic organic Library
Materials chapter 4, Ronuald Kowalik, Restaurator 4: 135-219: 1980
Preserving Library materials- A manual: Swartzburg,S.G., The Scarecrow Press, London, 1980
ص: 210
قارچ ها
خانواده موکوراسه 130
(خانواده) کتومیاسه 74
،اپیکو،کوم ،51، 79، 120، 121، 132
اپیکوکوم نیگروم 50
ادییوئیلیا ، 133
اسپورتریکوم، 199
اسپوروتریکس، 206
آسپرجیلوس ،28 ،37 ، 36 ، 39، 44، 49، 56، 74، ،120 ،91 ،90 ،88 ،84 81 80 79، 78، 76 199 ،145 ،134 ،133 ،121
آسپر جیلوس ،اوستوس 65
آسپر جیلوس اوکراسئوس 145
آسپرجیلوس پارازیتیکوس 29 ، 133، 145
آسپر جیلوس پنی سیلوئیدس، 146
آسپرجیلوس ترئوس 65 91، 139
اسپر جیلوس رستریکتوس 91
استاکی ،بوتریس ،28 ، 51، 74، 81، 88، 122، 148
استاکی بوتریس آترا 50، 65 81
استاکی بوتریس چارتاروم 59
استرپتومایسس، 126
استمفیلیوم ،50 51 ،74، 120، 122، 148
اسکلرو کلیستا، 133
اسکوپولاریوپسیس 51، 74، 120، 121، 149
اسکوپولاریوپسیس برویکالیس 49، 74، 151
اکسروهیلوم (اگزروهیلوم)، 90، 159
اکرواستالاگموس سینا بارینوس 49
انتوموفتورا، 121
امرسیلا، 133
،اورئو بازیدیوم 74، 79 ، 120، 122
اورئوبازیدیوم پولولانس 156
اولو کلادیوم، 120 ، 122، 158
اید املا ،اسپینوزا 49، 51
آبسیدیا 120، 121، 130
آبسیدیا کورولا، 130
آبسیدیا کوریمبیفرا، 130
آسپرجیلوس کاندیدوس 142
آسپرجیلوس کلاواتوس، 91، 140
آسپر جیلوس گلوکوس، 141
آسپرجیلوس فلاوس، 28، 65، 75، 88، 91،
138 ،137 ،133
آسپرجیلوس فومیگاتوس، 49، 51، 81، 84، 138 ،135 ،134 ،133 ،91 ،88
آسپرجیلوس ،نیجر ،49 51، 65، 74، 75، 91، 185 ،135 ،133
آسپرجیلوس نیدولانس، 75، 91، 143
آسپرجیلوس نیوئوس 91
آسپرجیلوس ،ورسیکالر 85، 147
اسپرجیلوس ،ونتی 49 آسکو ،میست، 48،26، 191،85
آکروتشیوم، 51،50
آکرومونیوم نگا سفالوسپوریوم
آکرومونیوم 121 151 152، 153، 154، 164، 206 ،191 ،188
ص: 211
پسیلومایسس (ادامه) آلترناریا ،36 37 ، 50 51، 56، 74، 79، 81، 90،
188 ،155 ،154 ، 122 ، 120
آلترناریا ،آلترناتا، 155
پسیلومایسس واریوتی 49
پلیکولاریا، 51
پنیسیلیوم ،28 36 37 39، 44، 49، 51، 56،
آلشریا بویدی ،ای 182
بازیدیوبولوس 121
بازیدیو میست، 25 26 27، 48
بایسو کلامیس 163
بایپولاریس، 90، 159، 197
بایپولاریس اسپیسیفرا ، 159
بایپولاریس استرالینسیس 159
بایپولاریس ، هاوائینسیس 159
بلاستومایسس 193
بلاستومایسس درماتیتیدس، 120، 121
بوتریتیس 51، 121، 160
بوتریتیس سینرا 49
بوتریوتریکوم 51
بوتریوتریکوم آترو گریزوئوم، 49
بوتریوسپوریوم 120
بیوریا، 121
بیوریا باسیانا 161 ،121 ،120 ،90 ،81، ،79، 76 75 74 ،65، 63
،167 ،166 ،165 ، 164 ،162 ،149 ،145 ،134 199 ،173
پنیسیلیوم اکسپنسوم 169
پنیسیلیوم پاتولوم 167
پنیسیلیوم پورپوروژنوم 170
پنیسیلیوم ،روبروم 170
پنیسیلیوم سیکلوپیوم 169
پنیسیلیوم فرکوئنتنس 167
پنیسیلیوم فونیکولوزوم، 65
پنیسیلیوم کازی کولوم 168
پنیسیلیوم ،کرایزوژنوم 75
پنیسیلیوم لوتئوم 75
پنیسیلیوم نوتاتوم 168
پنیسیلیوم وروکوزوم، 165
بیوریا براسیکانا، 161
بیوریا ،دنساء 161
پتریلیدیوم بویدی ای نگا آلشریا بویدی ای
پترومایسس، 133
پستالوشیا 48، 51
پنیسیلیوم ،ورو کولوزوم 169
پیتوسفالیس 121
پیتومایسس، 122، 170
پیتومایسس چارتاروم 28
پیتومایسس کارتاریوم 171
پیلایرا 121
پسیلومایسس 51، 49، 76، 120، 121، 151، 162،
پیلوبولوس، 121 166 ،164 ،163
تورولومایسس، 163، 175
ص: 212
تامینه ،یوم 121
ترموآسکوس، 163
تریکوتشیوم 51، 120، 121، 171
تریکوتشیوم ،روزئوم 50، 172
،زیگومیست ،48، 121، 180، 190
ژئوتریکوم 120 ، 175
ژئوتریکوم کاندیدوم 76، 175
،سپدونیوم 49، 51، 121، 181
سرپولا لاکریمنس، 182
تریکودرما، ،39 ،49، 51، 63 65، 74، 110، 120، 174 ،172 ،166 ،121
تریکودرما ریسه ای 110
تریکودرما ویریده، 64، 65، 174
تریکودرما هاریزیانوم 173
تریکو کلادیوم 5150
تورولا، 50، 51، 122
تورولومایسس، 175
چائتوسارتوریا، 133
چتو کونید یوم نگا کتوکونیدیوم
جئومایسس ،پانوروس، 176
درکسلرا ،90، 122 ، 159 ، 176، 177، 197، 207
سفالوتریکوم، 122
سفالوسپوریوم ،48، 51، 120، 199،151
،سیرسینلا، 120 ، 121، 184
سین سفالاستروم، 120 ، 121 ، 185
سیتالیدیوم، 26
سدوسپوریوم آپیوسپرموم نگا آلشریا بویدی ای
سودوآلشریا بویدی ،ای 182
فائائروکت کرایزوسپوریوم 26
فنليا 133
فوزاریوم ،28 ، 50 51، 63، 74، 79، 81، 90، 188 ،184 ،154 ،153 ،126 ،121 ،120
درماتوفیت، 193
دوترومیست 48، 74
دیكلائنا، 133
دیماتیوم 120
فوزاریم ،سولانی 187
،فوما، 120 ، 121 ، 188
فوما هومیکولا 48
فيكومايسس 121
کانینگهاملا، 120، 121، 190
كتوفوما، 120
کاندیدا 90 ،رایزوپوس، 36، 37 ،39، 74، 75، 79، 120، 121، 203 ،179 ،130،178
رایزوپوس استولونیفر، 178، 179
رایزوموکور، 180
رایزوموکور پوسیلوس، 131
رینو کلادیا، 122
زیگومایکوتینا 130
کتوکلادیوم 121
کتوکونیدیوم، 191
کتوملاهوریدا، 48
ص: 213
کتومیوم فانی کولوم 191
کتومیوم ،48 ،51 ،74 ،76، 120، 121، 188، 192 ،191
گلیوماستیکس (ادامه)
گلیوماستیکس کونوولته 50
مایستیسموس 28
،مایکوگون، 51
منوسپورا، 200
منوسپوریوم آپیوسپرموم، 120
مورتیرلا، 121
کتومیوم کوچلیوریس 191
کتومیوم گلوبوزوم، 26، 63، 65، 85
،کرایزوسپوریوم 120، 121، 181، 193
کریپتوکوکوس نئوفرمنس، 81
موکور ،74، 75، 79، 90، 120، 121، 178، 202،
کلادوسپوریوم ،36 37 ،39، 51، 56، 57، 74، 203 199 ،195 ،194 ،122 ،120 ،90 ،82 ،81،79
کلادوسپوریوم اسفرواسپرموم 196
کلادوسپوریوم بانتیانوم 194
کلادوسپوریوم ترایکوئیدس 194
کلادوسپوریوم فولوم 196
کلادوسپوریوم ،کاریونی 194 کلادوسپوریوم کلادوسپوروئیدس 88
کلادوسپوریوم ماکروکارپوم 196
موکور ایندیکوس 203
موکور پوسیلوس 202
موکور راسموس، 203
موکور راموسیسیموس، 203، 204 موکور سیرسینه ،لوئیدس، 203، 204
موکورو میکوز، 180
مونيليا، 201
کلادوسپوریوم ،هرباریوم، 50، 74، 84، 196
کواندفورا، 121
مونیلیا سیتوفيلا، 201
مونیلیال ، 74
کوچلیوبولوس 159
میروتشیوم و روکاریا، 65
میکروسپوروم فولووم 74 کوروولاریا، 51، 74 ، 90، 120، 122،197، 198
کوروولاريا لوناتا 50
کوکسیدیوئیدس ایمیتیس 120 ، 123
گرافیوم 198
،گلیوکلادیوم 120، 121، 166 ،199
گلیو کلادیوم ،روزئوم 50
گلیوکلادیوم ویرنس 26
گلیوماستیکس، 51
میکسوتریکوم، 48
میکوریزا، 42، 44
میکوفیلا 42
نئوسارتوریا، 133
نیگروسپورا، 120، 122، 205
ورتیسیلیوم 121، 164، 206
هستروسپوریوم 120
ص: 214
هلمنتوسپوریوم 198 ،197 ،177 ، 122 ،120 ،90 ،79 ،50
هلیکوستیلوم، 121
همی سپورا، 208
همی کارپنتلز 133
هو ميكولا، 122 ، 209
هیستوپلاسما، 193
هیستوپلاسما کپسولاتوم 121، 181
هیفومیست 121
يومايكوتا 130
يورتيوم، 133
باکتری ها
(خانواده باسیلاسه، 104
باسیلوس 95، 100، 104، 105، 106 ، 109، 110، 111
بلسیلوس استئارو ترموفیلوس 48، 109،108،106،100
باسیلوس اسفریکوس 106
باسیلوس آلکالوفیل، 109
باسیلوس آنتراسیس، 48، 105، 106
باسیلوس برویس 106
باسیلوس ،پاستئوری 109
باسیلوس ،پومیلوس، 106 ، 108 ، 109
باسیلوس سرئوس، 38 ، 43 ، 48، 100، 105، 106
باسیلوس سوبتیلیس ،39، 63،43، 110،107،106
باسیلوس سیرکولانس، 39، 43، 106
باسیلوس ،کوآگولانس ،48 ، 100، 106 ، 108، 109
باسیلوس لیکنیفورمیس، 48، 100، 108، 109
باسیلوس مگاتریوم 106
باکتروئید، 47، 95، 102
اسپروسارسینا، 104
اسپورولاکتو باسیلوس ، 104
استافیلوکوک،88
استرپتومایسس ،47 ،66، 85، 95، 98، 99
استرپتومیست 38، 43
استوویبریو، 95، 102
استرویبریو سلولولیتیکوس 02
اسیدو ترموس، 47، 95، 97
اسیدو ترموس سلولیتیکوس 97
اسیلوسپیرا، 104
باکتروئیدس سلولوزولانس، 38
باکتروئیدس فراجیلیس 102
ترمومنوسپورا، 47، 95، 98، 99
دسولفوتوماکولوم، 104
رومینوکوکوس، 47، 95، 104
سایتوفاگا، 38، 43، 51
سرانگیوم 38، 43
سل ،ویبریو 24، 47، 51، 95، 101
سل فاسیکولا، 51
سلولوموناس، 24، 47، 95، 100، 101
اکتینومیست ،25 ،37 ،47 ،48، 54، 63، 95، 96، 99 ،98 ،97
انتراکوئید 105، 106
سودوموناس، 47، 95، 101
سودوموناس فلورسنس واریته سلولزا، 102
ص: 215
کلدوسلوم، 95، 102 ، 103
کلستریدیوم، 47، 95، 103، 104
کلستریدیوم ،ترموسلوم 38، 109
مایکوباکتری، 38، 43
میکروبیسپورا، 47، 95، 98، 99
یوباکتری، 38، 43
(راسته) آکارینا، 33
حشرات
(راسته) کولئوپترا، 31
آکاروس سیرونگا مایت آرد بید انبار استوائی 30
بید انبار 30
بید آرد مدیترانه ای نگا بید آسیاب بید آسیاب 30
بید برنج 31
بید بلغور هندی 30 31
بید غذای هندی نگا بید بلغور هندی
حشره چوبخوار، 63
سوسک آرد، 32 33
سوسک بیسکویت 32
سوسک عنکبوتی استرالیایی 31
سوسک مبلمان نگا کرم چوب
کارپوگلیفوس لاکتیس نگا مایت آلو
کرم چوب، 27، 32
کرم کشتی، 28
کنه غبار، 34
مایت آرد 33
مایت آلو، 33، 34
مایت خانه، 34، 35
مایت مبلمان، 34 35
مایت 33 34
موریانه، 27، 63
مواد شیمیایی ، بیوشیمیایی و داروها
1و3 بتا دی ،گلوکان 77، 80 82 83 84
1 و 8 دی هیدروکسی نفتالین ، ملانین 82، 85
2 و 7دی کلرودی هیدروفلوئورسئین 60
1 و 4 بتا دی گلیکوپیرانوز 23
4 و 6 دی آمیدینو 2
فنیل ایندول 60
B- ماناناز، 110
اتانل، 38، 70، 102
اتیلن اکساید 62 63 64
ارتوفنیل فنل 67، 68
ارگوتامین 43
اریترومایسین 96
،ازت ،38 ،48 49 50 51، 58، 151، 172
اسپرادسمین، 28
استرپتومایسین 96
استریگماتوسیستین، 88، 159،148،147،143،142
الاستین، 74
اسید تئوکوئیک 114
اسید کلرانیلیک، 67
ص: 216
اسید گلوکونیک 96
اسید استیک 38، 96
اسید اگزالیک 39، 96
اسید پنی سیلیک، 145، 169
اسید تنازوئیک، 155
اسید دی آمینوپیملیک، 114
اسید سوکسینیک 39
اسید سیتریک، 39، 96
اسیدسیکلوپیاکسونیک 147
اسید لاکتیک 38، 39، 167
اسید مورامیک 114
اکسید آهن، 76
اگزو گلوکاناز، 24، 39، 98، 101
آمفوتریسین B،
96 آمونیاک، 76
آمونیوم، 111، 151
آمیتات، 24
آمیلاز ،24، 39 ،75، 96، 98، 103، 109، 167
آمینواسید 108،105
،آهن 35، 36، 48، 76، 108
باسیتراسین، 105
بتاگلوکوزید از نگاسلوبیاز
بنزوات 101
بی کربنات سدیم 70
،پاتولین ،28، 139، 140، 142، 167
پارادی کلرو بنزن 64، 65
پاراکلر ومتاگزایلنول، 68 اندو گلوکاناز ،24 ، 39، 98 ، 99، 101، 109، 110
اولیگوساکارید، 98
ایزومالتوز، 102
آدنوزین تری فسفات 60
آرابینوز، 98
آرسنیک، 149
آرسین، 149
آرگون، 58
آسپاراژین، 49
،پپتون 49
پپتیدو گلیکان، 111
پپتیدومانان، 114
پراکسید هیدروژن 26
پروپیلن اکساید 63
پروتئاز 24، 109، 110
پکتیتاز 24، 98، 103
،پکتین، 47، 102 ، 107
پلی ان استیل گلوکزامین 114
پلی اورتان 75
پلی استر، 75
آفلا توکسین ،28، 29، 88، 122، 133، 145، 167
آکراتوکسین، 28، 145
آکریدین اورنج 60
آلبومین، 74
آلدئید فرمیک، 68
پلی پپتید گلوتامیل 108
پلی ساکارید، 23
ص: 217
پلی میکسین، 105
پلی هگزا متیلن گوانیدین 65
پنتا کلروفنات سدیم 75
پنتاکلروفنل، 67
پنی سیلین 43، 86
پیرووات 98، 102
تانن، 47، 167
تری متیل آمین 140
سلوبیوز ،38 ، 39 98، 99، 101، 102
سلوتریوز، 99
سلولاز ،12 ، 24 ،27، 48، 75، 97، 98، 99، ،110 ،109 ،106 ،104 ، 103 ،102 ،101 ،100 111
سلولز ، 12 ،15 ، 23 ، 24، 25، 27، 36، 37، 38 ،78 ،76 ،75 ،74 ،66 ،50 ،49 ،48 ،47 ،39، ،103 ،102 ،101 ،100 ،99 ،98 ،97 ،95 ،89 ،191 ،165 ،122 ،115 ،114 ،110 ،109 ،104 209 ،193
188 ،186 ،171 ، 167 ،147 ،145 ،143 ،142
تریکوتسن، 28، 81، 86، 151 ، 171، 186، 187، 188 ،
توکسین ،78 ، ،81، 88، 133، 138، 139، 140،
تیمول، 66، 67
جئوسمین، 85
جوش شیرین نگا بی کربنات سدیم چاپکس ،آگار 140
دکستروز، 124
دی اکسید کربن 38 87
دی کلروفن 68
زانتو مگنتین 145
زرالنون 28
ژلاتین 35، 109
سابرو دگستروز آگار 129، 183
ساکارز، 49 سالسیلات، 101
سالیسیلانیلید، 67
سفالوسپورین، 43، 86، 96
سوفوروز، 102
سولفات آمونیوم 49
سیترات، 98
سیترینین 139
سیکلوسپورین، 43، 86
سیکلوهگزامید 166
فتیل پروپان 23
فرمالین نگا آلدئید فرمیک
فروکتوز، 102
فسفات آمونیوم، 49، 50، 172
فسفولیپید 60
فوکوز، 114 فومیگاتین 43
کالوز، 114
کراتین، 42، 74، 193
کربوکسی متیل سلولز 24، 98
سلوبیاز 24، 39، 98
کروم، 75
ص: 218
کلاژن، 36، 74
کلرید جیوه، 67
کلسترول، 111
کیتین، 85، 114، 115
کیتیناز، 75
گالاکتوز، 49، 102
مانیتول، 102
مایستوما 151
مایکوتسیوم 28
مایکوتوکسیکوز، 28
مایکوتوکسین ،28 ، 77، 81 ،86، 87، 122، 132، 166 ،165 ،159 ،145 ،133
گریزئوفولوین 43، 86، 96، 167
متان 122
گزیلوز، 38، 49
متیل بروماید 62، 69
گلبولین، 74
ملانین، 77، 85
گلوتامات گلیسرول ،آگار 108
نشاسته ،29، 32 35، 48، 109
گلوکان، 114
نیترات 111
نیترات آمونیوم 49
گلوکز، 24، 38 ،39 ،49، 84، 96، 98، 99، 102، 124 ،108 ،107 ، 106
گلوکز اکسیداز، 96
گلوکوموناز، 110
گلیسرول، 49، 114
گلیوتوکسین، 84
لاکاز، 26
لاکتوز، 102
لاکتوفنل کاتن بلو، 127، 128، 129
لیستاتین، 96
لیگنین 23 ،25، 26، 42، 47، 99، 122
لیگنیناز 26
مازو، 35
مالات، 98
مالتوز، 49، 102
مانوز، 49، 102
نیترات سدیم 49
نیترات سلولز 24
،نیتروژن 21، 25، 50، 102 ، 107 ، 108، 111، 115
نئون 58
واریوتین 162
ویومیلین، 145
هلیم 58
همی سلولاز 75
همی سلولز، 47
هیپوکلریت سدیم 69
هیدروژناز ، 59
،هیدروفوبین، 77، 82، 84، 85
هیدروکسید آهن، 36
هیدرولاز سلولز، 75
ص: 219
ص: 220
Absidia sp., 130
Fungi
Absidia corymbifera, 130
Absidia glauca, 130
Absidia orchidis, 130
Absidia ramose, 130
Absidia spinosa, 130
Acremonium sp., 151
Acremonium collarette, 154
Acremonium falciforme, 151, 188
Acremonium kiliense, 151, 188
Acremonium recifei, 151, 188
Acremonium restrictum, 151
Acremonium strictum, 188
Acrostalagmus cinnabarinus, 49
Alternaria sp., 154, 156
Alternaria alternata, 74
Alternaria Tenuissima, 75
Aspergillus sp., 75, 133
Aspergillus amstelodami, 66
Aspergillus candidus, 142 Aspergillus clavatus, 140
Aspergillus fisheri, 135
Aspergillus flavus, 28, 66, 74,137
Aspergillus glaucus, 141 Aspergillus nidulans, 143
Aspergillus niger, 49, 66, 135
English Index
Aspergillus(continue)
Aspergillus ochraceus, 145 Aspergillus parasiticus, 145 Aspergillus penicilloides, 146 Aspergillus terreus, 66, 139
Aspergillus versicolor, 147
Aspergillus wentii, 49
Aureobasidium, 75
Aureobasidium pullulans, 75, 122, 156, 157
Beauveria sp.
Beauveria bassiana, 161
Beauveria densa, 161
Bipolaris sp., 159
Bipolaris australiensis, 159 Bipolaris hawaiiensis, 159
Bipolaris spicifera, 159
Botryotrichum atrogriseum, 49
Botrytis sp., 160
Botrytis cinerea, 49
Byssochlamys, 163
Cephalosporium, 48
Chaetoconidium sp.,191,192
Chaetomella horida, 48
Chaetomiaceae, 74
Chaetomium sp., 48,191
Chaetomium globosum, 26, 66
Chaetosartorya sp., 133
Chrysosporium sp., 193
ص: 221
Chrysosporium (Continue)
Chrysosporium keratinophilum, 193
Chrysosporium tropicum, 193
Circinella sp., 184
Cladosporium sp., 194
Cladosporium cladosporoides, 74, 88
Cladosporium curvularia, 75
Cladosporium fulvum, 196
Cladosporium herbarum, 50, 196
Exserohilum, 159
Fennellia sp., 133
Fusarium sp., 28, 75,154,186
Fusarium solani, 187
Geomyces pannorus, 176
Geotrichum, 75, 175
Gliocladium sp., 199
Gliocladium roseum, 50
Cladosporium macrocarpum, 196
Cladosporium sphaerospermum, 197
Cochliobolus, 159
Cunninghamella sp., 190
Cunninghamella echinulate, 190
Cunninghamella elegans, 190
Curvularia sp., 197,198
Curvularia lunata, 50
Dematiaceous fungi, 121
Dendrophoma, 75
Drechslera, 176
Dichlaena sp.,133
Edyuillia sp., 133
Eidamella spinosa, 49
Emericella, 75,133
Epicoccum sp., 132
Epicoccum nigrum, 50
Epicoccum purpurascens, 66
Eurotium sp., 133, 141
Gliocladium virens, 26
Gliomastix convolute, 50
Graphium sp., 198
Helminthosporium, 50, 75, 207
Hemicarpenteles sp., 133
Hemispora sp., 208
Humicola sp., 209
Hyaline hyphomycetes, 121
Microsporum sp.,
Microsporum fulvum, 74
Monilia sp., 75, 201
Monilia sitophila, 201
Monospora sp., 200
Mucor sp., 202
Mucor cricinelloides, 203
Mucor indicus, 203
Mucor racemosus, 203
Mucor ramosissimosus, 203
Mycetism, 28
Mycogone nigra, 50
ص: 222
Mycophylla, 42
Mycorrhiza, 42
Myrothecium, 75
Myxotrichum deflexum, 66
Myxotrichum sp., 48
Neosartorya sp., 133
Nigrospora sp., 205, 206
Paecilomyces sp., 162
Paecilomyces lilacinum, 164
Paecilomyces varotii, 49, 162, 164
Penicillium sp., 75
Penicillium caseicolum, 168
Penicillium comemberti, 168
Penicillium cyclopium, 66, 169
Penicillium expansum, 168
Penicillium frequentance, 167
Penicillium griseofulvum, 167
Penicillium marneffei, 167
Penicillium notatum, 168
Penicillium purpurogenum, 66, 170
Penicillium roquefortii, 66
Penicillium vermiculatum, 66
Penicillium verruculosum, 169
Pestalotia, 48
Petromyces sp., 133
Phaeohyphomycetes, 121
Phanaerochaete chrysosporium, 26
Phialophora, 154
Phithomyces sp., 170
Phithomyces chartarum, 28
Phoma sp., 188
Phoma humicula, 48
Pseudallescheria boydii, 182
Rhizomucor sp., 180
Rhizopus sp., 178
Rhizopus nigricans,
66 Rhizopus stolonifer, 75
Schizophyllum, 75
Sclerocleista sp., 133
Scopulariopsis sp., 149
Scopulariopsis brevicalis, 49, 151
Scytalidium sp., 26
Sepedonium, 49, 181
Serpula lacrymans, 182
Sporotrichum bombycinum, 66
Stachybotrys sp., 28, 75
Stachybotrys atra, 50, 66
Stamphylium, 148
Stachybotrys chartarum, 59, 66
Syncephalastrum, 75, 185
Talaromyces, 163
Thermoascus, 163
Torula, 50
Torulomyces, 175
Trichocladium, 50
Trichoderma sp., 75, 172
ص: 223
Trichoderma (Continue)
Trichoderma harzianum, 173
Trichoderma reesei, 99,110
Trichoderma viride, 49, 66, 174
Trichotecium roseum, 50
Trichotecium, 171
Bacillus (Continue)
Bacillus subtilis, 106, 110
Caldocellum saccharolyticum, 103
Cellvibrio, 24
Cellvibrio gilvus, 101
Cellulomonas sp., 24
Cellulomonas biazotea, 100
Verticillium sp., 206, 207
Verticillium tenerum, 66
Zygomycetes, 121
Bacteria■
Acetovibrio cellulolyticus, 102
Acidothermus cellulyticus, 97
Actinobacillus succinogenes, 102
Bacillaceae, 104
Bacillus, 104
Bacillus anthracis, 105
Bacillus brevis, 106
Bacillus cereus, 105
Bacillus circulans, 106
Bacillus coagulans, 106, 108, 109
Bacillus licheniformis, 106, 108, 109
Bacillus megaterium, 106, 110
Bacillus pasteurii, 109
Bacillus pumilus, 106, 108, 109
Bacillus spharicus, 106
Bacillus stearothermophilus, 106, 108, 109
Cellulomonas firmi, 100
Cellulomonas uda, 100
Clostridium, 104
Clostridium -
thermohydrosulfuricum,103
Clostridium stercorarium, 103
Clostridium thermocellum, 103, 109
Desulfotomaculum, 104
E.coli, 110
Microbiospora bispora, 99 Osillospira, 104
P. fluorescens var. cellulose, 102
Ruminococcus, 104
Sporolactobacillus, 104
Sporosarcina, 104
Steroptomyces flavogriseus, 99
Steroptomyces lividans, 99
Steroptomyces thermovulgaris, 98
ص: 224
Insect
Acarus siro, 33
Anobium punctatum, 27 Carpoglyphus lactis, 33
Corcyra cephalonica, 31
Dermatophagoides pteronyssimus, 34
E. kuehniella, 30
E.cautella, 31
Dendrochin, 43
Geosmin, 85
Glutamate glycerol agar, 108
Glutamyl, 108
Lovastatin, 86
Meso diamino pimelic acid, 99
Mycothecium, 28
Mycotoxin, 28
Ephestia elutella, 30
Glycyphagus domesticus, 34
Living dust, 33
Plinus tectus, 31
Plodia interpunctella, 30
Stegobium paniceum, 32
Teredo spp, 28
Tribolium confusum, 32
Medicin, Chemical
Biochemical Material
2-methyl isoborneol, 85
Acridine orange, 60
Aflatoxin, 28
Antiamoebin, 43
Calvacin,43
cellutraose, 109
Corn meal Agar, 153
Czapekdox Agar, 135,166
Ochratoxin, 28, 29, 145,
Patulin, 43
Poricin, 43
Potato Detrose Agar, 127, 153,166
Sesquiterpen, 86
Shikimic acid, 86
Sodium Penta chloro phenate, 75
Sparassol, 43
Sporodesmin, 28
Statolon, 43
Strigmatocystin, 88, 142
Tannin, 167
Trichodiene, 86
Trichothecenes, 28, 86
Trimethylamine, 140
Vomitoxin, 186
Xanthomegnin, 145
Zearalenone, 28
B- mannanase, 110 B-1,4 glucanase, 109
ص: 225